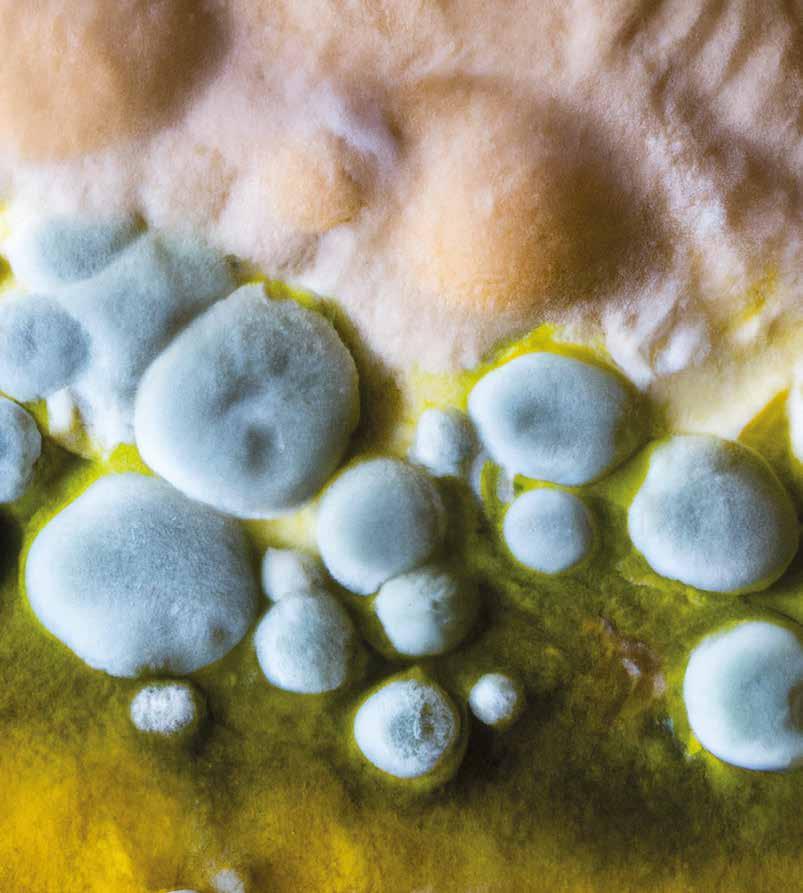
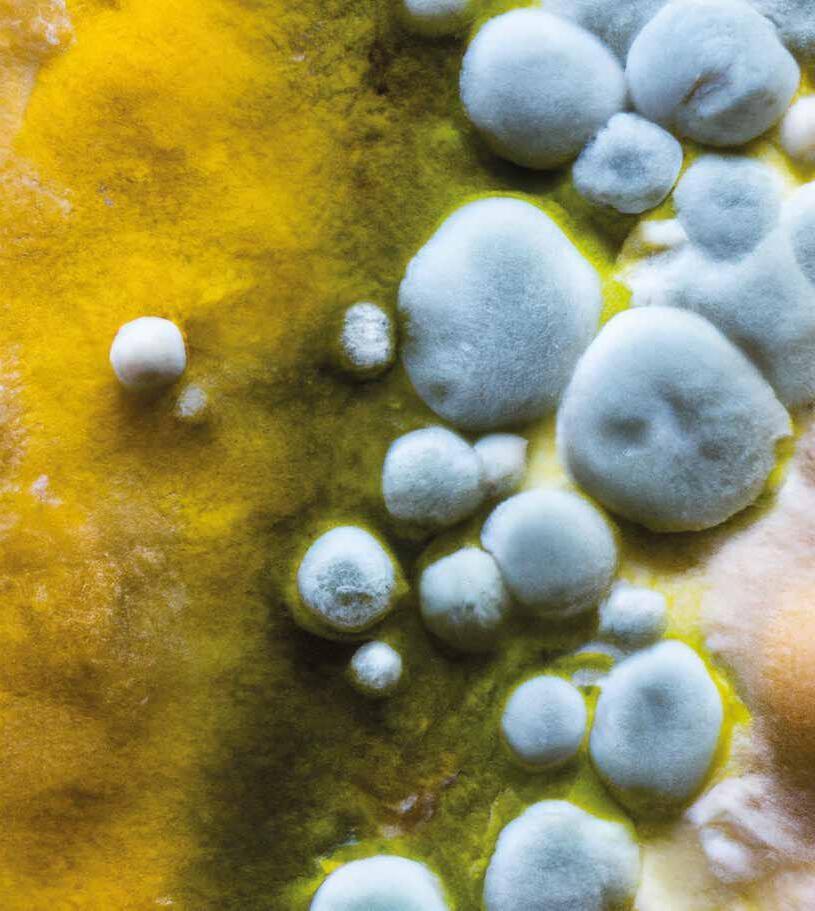
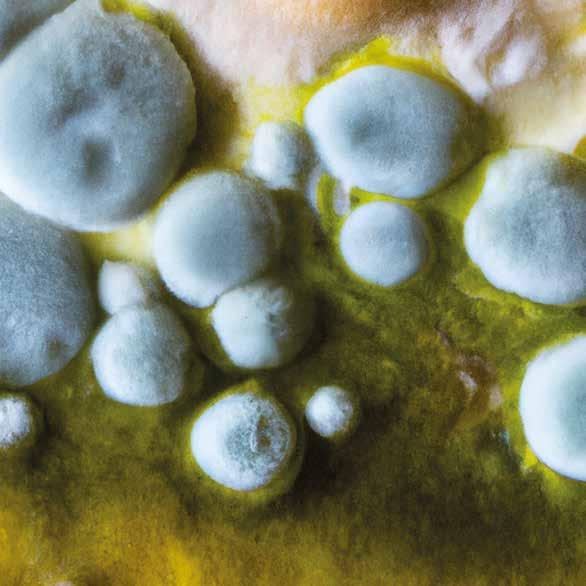
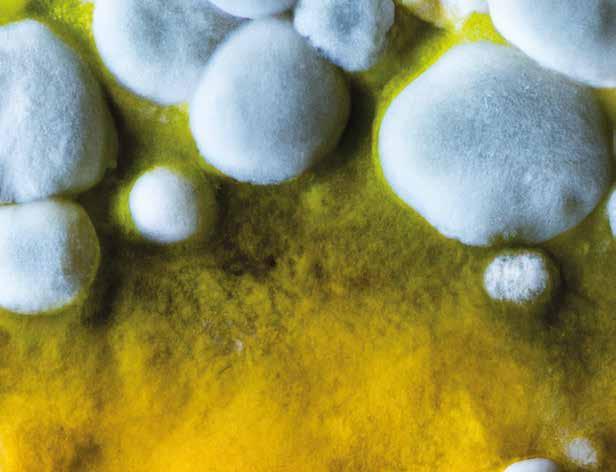

venice city guide







venice city guide






Josef Albers / James Lee Byars / Maurizio Cattelan / Étienne Chambaud / Edith Dekyndt
Sergej Eisenstein / Lucio Fontana / Theaster Gates / David Hammons / Arthur Jafa / Donald Judd
On Kawara / Kimsooja / Joseph Kosuth / Sherrie Levine / Francesco Lo Savio / Agnes Martin
Paulo Nazareth / Camille Norment / Roman Opałka / Lygia Pape / Michel Parmentier
Philippe Parreno / Robert Ryman / Dineo Seshee Bopape / Dayanita Singh / Rudolf Stingel
Andrej Tarkovskij / Lee Ufan / Danh Vo / Chen Zhen

editoriale (p. 13 ) Un altro abitare incontri (p. 14 ) Roberto Cicutto | Giulia Foscari architettura (p. 34 ) Lesley Lokko, Il Laboratorio del Futuro | Demas Nwoko, Leone d’Oro | Partecipazioni Nazionali: Arabia Saudita, Italia, Cina, Estonia, Uzbekistan, Kuwait, Finlandia, Santa Sede, Uruguay | Not Only Biennale: European Cultural Centre | Umbau | Building a Creative Nation | DNA Ucraino | Venezia Fabrica
Futura | Kengo Kuma | Sacred Landscapes | 100 progetti x 100 identità | DoorScape |

PRIX W 2023 | RADIALS | Vetro Boemo | Sam Baron | Venice Design Biennial | Frank&Frank | Intervista a Paolo Lucchetta storie (p. 62 ) Storia dell’Arsenale arte (p. 70 ) Vedova | Intervista Luca Massimo Barbero e Arthur Duff | Intervista Barbara Casavecchia | Carpaccio | ICÔNES | Donazione Gemma De Angelis Testa | Everybody Talks About The Weather | Edmondo Bacci | Artemisia a Palazzo | CHRONORAMA | Ugo Mulas | Art Night | Ego | Giovanni Soccol | Chiara Bertola, Conservare il futuro | Nicolò Manucci | Hans Ulrich Obrist e Gianluigi Ricuperati, A che cosa serve l’arte | Galleries | Intervista Olga Shishko | Not Only Venice biennale teatro festival guide (p. 105 ) musica (p. 136 ) Uri Caine | Laura Pausini | Juraj Valcˇuha | Paolo Conte | Damien Rice | Pinguini Tattici Nucleari | James Senese | Marco Mengoni | Bruce Springsteen | Peter Gabriel | Centrodarte2023 | The Cult | Rammstein classical (p. 147 ) Intervista a Franco Bolletta, Lac | Robert Trevino | Alpesh Chauhan | Markus Stenz | Der fliegende Holländer | Musikamera | Sulle ali del secolo | Uto Ughi | 30. Festival Galuppi | Arena Opera Festival | Settimane Musicali al Teatro Olimpico cinema (p. 156 ) 76. Festival di Cannes | Intervista Domenico Monetti | 80. Mostra del Cinema di Venezia | Citto Maselli | Sbatti la verità in prima pagina etcc... (p. 164 ) Intervista Giulio De Vita | Intervista Alberto Toso Fei | Intervista Roberto Nardi | Festival dei Matti | Parole: Sorriso menu (p. 174 ) Intervista Massimiliano Alajmo | Ca’ Select | Le Monde Wine | Hotel Heureka | Palazzina G | AMO Restaurant citydiary (p. 183 )
Africa according to Lesley Lokko for a Biennale where research for sustainable solutions pairs effectively with other stories and other experiences from a continent that is used to counter extreme weather and environments.


i ncontro p. 14 | a rchitettura p. 34
A pictorial and spatial revolution – Vedova’s amazing art lights up the M9 Museum. Fondazione Prada, in Venice, shows an exhibition of pure research, with the weather acting as the thread for a bird’s-eye view on modern (and older) art. arte p. 70 / 81
Laura Pausini, Beethoven’s Ninth in a Fenice production, Paolo Conte. With Piazza San Marco at the centre, music conquers the city for a live dimension we thought we’d forgotten. musica p. 138


«Ci siamo resi conto che l’evoluzione umana è in essere, sempre, ed è questa che bisogna alimentare. Non possiamo credere di essere arrivati alla fine della storia, è innaturale e non serve a migliorare la nostra esistenza, le relazioni tra gli uomini, una diversa idea di comunità fatta di persone sensibili e il futuro della nostra terra. L’homo sapiens è solo una fase, dobbiamo lavorare per guadagnarci l’homo felix, dobbiamo far crescere in noi la ricerca della libertà, dell’amore, della felicità. Dobbiamo ricominciare a sognare un nuovo uomo e imporlo alla realtà» (Armando Punzo).

A Venezia Naturae sarà modellato sullo spazio storico delle Tese cinquecentesche all’Arsenale.
We realized that human evolution is unremitting, always, and that is what we must nurture. We cannot believe that we have come to the end of history, it is unnatural and does nothing to improve our existence, the relations between people, a different idea of community based on mindful people and the future of our earth. Homo sapiens is only a phase, we must work to achieve homo felix, we must cultivate the search for freedom, love and happiness within ourselves. We must begin dreaming of a new man again and impose him on reality”. (Armando Punzo)
In Venice Naturae will be shaped around the historic space of the sixteenth-century Tese in the Arsenale. BIENNALE TEATRO festival guide p. 105


Choreographer Jean-Christophe Maillot takes to Fenice a reading of Swan Lake with an extra touch of magic and mystery and the talent of Ballets de MonteCarlo. Art director Franco Bolletta shows us how one of the most anticipated events in the Ballet Season comes to be. classica l p. 146

In praise of simple kitchen, ipso facto more precious, reflective, and intimate. Face to face with a star of cuisine and his genius: season, tradition, food. menu p. 174

eIl Laboratorio del futuro. Questo il titolo che Lesley Lokko, prima, storica curatrice africana della Biennale Architettura, ha dato alla sua attesissima esposizione che ha preso il via sabato 20 maggio. Un titolo semplice, diretto, che si potrebbe definire sin troppo didascalico, sentito e rimasticato in mille occasioni a definire attività e progetti in divenire di qualsiasi settore della nostra società, sia esso culturale, industriale, scientifico. Eppure tale nettezza, tale semplicità nel qualificare questa straordinaria sfida al futuro attraverso architetture realizzate e visioni progettuali in divenire in larga parte espressione di quel macro-mondo da sempre considerato “terzo”, in particolare di quell’Africa per secoli colonizzata, sfruttata e frustrata nei suoi fondamentali espressivi, restituiscono meglio di qualsiasi altro giochetto linguistico autoreferenziale l’urgenza di una sfida che fa dell’autentica emancipazione da schemi ingessati da troppo tempo, codificati comodamente dal verbo occidentale, il suo cuore più vivo e vero. Lokko è un’intellettuale a dir poco poliedrica: architetto, ricercatrice, docente, direttrice di scuole, scrittrice. E in questa ultima sua veste, indossando la quale ha pubblicato negli anni svariati, convincenti romanzi, sarà certamente stata tentata una sola volta almeno in questi lunghi mesi di fermare l’identità progettuale della sua Biennale con un’istantanea, con una sequenza breve di parole a costruire un titolo buono per ammiccare alle aspettative di una comunicazione mediatica sempre più concentrata sulla brevità stringente, sullo spot cool. Figuriamoci se una intellettuale poliglotta, non solo in termini strettamente linguistici, ma più estesamente dei linguaggi espressivi, come lei queste strategie non le conosce. Ma proprio perché le conosce troppo bene innesca asciuttamente il suo contropiede, una ripartenza secca e vincente, perlomeno nei suoi presupposti, che riporta l’attenzione sulla fitta sostanza del nostro abitare il mondo, rifuggendo decisa da pose e proclami di pura autoreferenzialità mediatica o accademica.
Laboratorio del futuro, sì, che altro? Che altro trovare per definirsi nel momento in cui ci si rivolge con uno sguardo mai così antropologicamente aperto al mondo, accogliendo, ricercando soprattutto esperienze inedite, consumate e in fieri, della pratica architettonica in una prospettiva di distesa, pacificata insofferenza verso i dettami strettamente disciplinari del fare architettura? Non servono giochetti linguistici quando è nelle cose, matericamente, la sfida da giocarsi. La grande attesa di questa Biennale mai così spostata verso il grande con-
tinente nero, quello in cui il futuro non è ancora scritto e si va velocemente, nel suo infinito delta espressivo a dispetto del nostro sin qui comodo sguardo restringente “ad estuario”, scrivendo, riposa naturalmente sulla fame di inedito che questa nostra fetta di mondo sempre più senza segreti possiede, alimentata da una tensione viva nel confrontarsi con esperienze altre, in tutti i sensi, disciplinari, culturali, geografiche, politiche. Però sarebbe sterile, direi irritante assai, individuare in questa chiave ancora una volta occidentale-centrica dell’attesa di un chissà quale supposto nuovo proveniente da un qualche altrove, magari ancora una volta esotico…, la cifra prevalente di questo progetto espositivo che nasce invece da ben altre radici ed attese. E allora quali sono le vere direzioni, i valori fondanti della ricerca che sottende questo straordinario appuntamento globale? Naturalmente moltissime, a partire dal comune verbo, sin troppo usato e spesso abusato in ogni dove e per ogni minima cosa, della sostenibilità, certo, della cura intelligente del Pianeta in piena crisi ambientale, cercando di dare risposte concrete e plausibili alla trasformazione climatica, all’aumento preoccupante delle temperature attraverso la disciplina che più di ogni altra le contiene tutte, perché accompagna e accoglie ogni secondo delle nostre vite, l’architettura per l’appunto. Bene, tutto bene. Direi correttissimo, sin troppo. Quale laboratorio del futuro non metterebbe al centro delle sue ricerche tutto questo? Una chiave di lettura dovuta e prevedibile quindi, come il titolo della mostra stessa. E allora dove individuare lo scarto, la direzione autentica e fondamentalmente libera da condizionamenti accademici e disciplinari di questo Laboratorio di Lesley Lokko? Probabilmente nella storia diversamente vissuta, e ai più di noi ignota o perlomeno dai più ignorata, in spazi infiniti di mondo che occupati per secoli dal verbo unico occidentale hanno silenziosamente, quasi sempre per ragioni di pura sopravvivenza, concesso di esplorare altre modalità di vita il più delle volte comunitarie, con soluzioni abitative e di “servizio” che fino a ieri, ma anche ad oggi, bene che andasse potevano essere oggetto di qualche corretto e “premuroso” doc di National Geographic o della BBC e niente più, con tutto il rispetto per l’indubbia qualità dei prodotti di questi colossi mediatici. Sì, ci pare proprio che indagando in quella storia materiale, concreta del (soprav) vivere in condizioni climatiche ed ambientali spesso estreme si possa individuare quel deposito di sapere, di “mestiere”, in grado di fornire in questo nostro presente mediaticamente e psicologicamente allarmato direzioni
più sostenibili di convivenza urbana nel segno dell’adattamento intelligente ai mutamenti perpetui del Pianeta. Una chiave di lettura per una nuova architettura espressione di uno sguardo dinamico, niente affatto meccanicamente conservativo, sulle radici, sulle culture e la storia di quella parte di mondo che per ragioni determinate da istanze eminentemente ambientali hanno definito nel tempo una propria grammatica, un proprio alfabeto della sopravvivenza, finendo per restituire oggi all’opulento mondo del benessere sfibrato dal consumo acritico di suolo e risorse, quell’Occidente che spingendo la tavoletta dell’acceleratore a velocità insostenibili si ritrova ora chiuso in una dimensione da videogame, con esistenze prevalentemente spese in un quotidiano di puro artificio digitale, una teoria di possibili risposte al nostro angosciato anelito a rifare propria una relazione più intelligente e virtuosa con madre Natura. Non si tratta di una disposizione retoricamente pauperistica, meramente rivolta in chiave compensativa, restitutiva, a valorizzare modi di vita, di condivisione collettiva di quella parte di mondo da sempre costretta ad arrangiarsi in condizioni di oggettiva indigenza. No. Si tratta piuttosto di un invito ad allargare gli orizzonti visuali fuori dalle nostre superstrade astratte e digitali, conchiuse in sé e per sé, attingendo ad esperienze vitali in qualche modo primarie che ci parlano di una possibile, per

noi nuova relazione con un ambiente che la nostra sino ad ora falsa coscienza nel predicare un doveroso rispetto nei suoi confronti fa sì che poi, girato il giorno, lo si continui a violare chiusi nelle nostre bolle di acciaio e cemento.
È quindi l’invito a misurarsi con un altro approccio, dettato da ragioni basilari di adattamento e sopravvivenza a una natura soverchiante, probabilmente la vera chiave di lettura di questa 18. Biennale di Architettura firmata Lesley Lokko. Una Biennale in cui, certo, questo percorso esperienziale “altro” si dispone e compone di proposte di forte concretezza, di solida sostenibilità, di progetti e soluzioni architettoniche che da queste radici di pura sussistenza prendono linfa per oggi disegnare direzioni percorribili utilizzando le conoscenze, il sapere accumulato dalla ricerca, dall’evoluzione tecnologica. Ed è quello che con grande curiosità ci accingiamo a vedere ai Giardini e all’Arsenale. Eppure la cifra di questa sfida, di questa Biennale, più che nelle soluzioni in sé, ripeto, ci pare essere l’invito per nulla rivendicativo di volgere lo sguardo alla profondità di un deposito di esperienze figlie di un’altra disposizione verso il mondo, verso l’ambiente, quell’approccio più umano e contenuto che ci predichiamo di dover abbracciare nel nostro sazio vissuto e che altrove è da quasi sempre urgenza quotidiana.

Le scelte più lontane dal politicamente corretto possono per certi aspetti essere paradossalmente anche quelle più vicine al politicamente corretto
Roberto Cicutto, presidente della Biennale di Venezia, ha le idee chiare e ha messo in campo per il 2023 le migliori personalità dell’architettura, del teatro, della danza, della musica, e naturalmente del cinema e dell’arte, per formare una squadra di direttori che possa farsi interprete privilegiato del nostro tempo. Scelte mai scontate, di nicchia, ma al contempo à la page, che suscitano va da sé forti attese per le prossime Mostre e Festival. La visione del Presidente è attenta, insieme allargata e laterale, rivolta sì al cuore vivo della Biennale quale filtro tra le ricerche più avanzate nel campo dei linguaggi dell’arte, ma soprattutto intenta a contribuire e a fornire al pubblico delle risposte immediate e convincenti a imperativi urgenti della società. La sua è una consapevole responsabilità di avere a disposizione un immenso patrimonio di conoscenza in continua evoluzione che si forma e ri-forma attraverso il bagaglio professionale e personale dei singoli direttori delle diverse discipline in dialogo attivo con gli esiti creativi del passato, aprendo e sviluppando dibattiti, rispondendo a domande e formulandone altre. Roberto Cicutto è tenacemente impegnato a rendere vivo e vitale questo giacimento di cultura e sapere con pochi eguali nel mondo, riaprendo incessantemente il confronto e il dibattito sulla contemporaneità verso nuovi orizzonti temporali e spaziali. Un esempio eloquente a riguardo la scelta di Lesley Lokko, prima curatrice africana di una Biennale Architettura della storia. La Biennale di Venezia diventa così luogo di osservazione globale toccando con un occhio al futuro tutti i problemi del presente.
Geografie sempre più allargate e inclusive. Mai come in questa Biennale Architettura lo sguardo sarà spinto oltre la comfort zone occidentale verso una definizione di una nuova ri-globalizzazione. Da dove nasce la scelta di Lesley Lokko e quali elementi del suo percorso curatoriale l’affascinano di più?
Ci troviamo al cospetto di un’architettura che nella contemporaneità, e di riflesso nel contesto disciplinare della Biennale, si sta facendo sempre più onnicomprensiva. Sembra infatti che questa disciplina debba farsi carico dei grandi problemi del Pianeta e di conseguenza farsi portatrice di soluzioni a ogni livello ben oltre i propri tracciati settoriali, come già da poco accaduto, ad esempio, alla ricerca farmaceutica in epoca di pandemia. Adesso all’architettura viene chiesto di risolvere emergenze globali come la siccità e le crisi climatiche con soluzioni pratiche e veloci.
La scelta di Lesley Lokko nasce da una riflessione profonda e dall’aver considerato come delle vere e proprie “scuole” le mostre curate da Hashim Sarkis prima e Cecilia Alemani poi, che hanno fin qui scandito il mio mandato e che mi hanno insegnato molto in termini di esperienza. Avendole vissute dall’interno, pur con due curatori che non avevo nominato io, ho avuto la possibilità di analizzare soprattutto le reazioni dei diversi pubblici nei confronti di queste due esposizioni, ovviamente diverse per tematiche e contenuti, ma ugualmente capaci di arricchirmi in maniera davvero significativa. Ho potuto concentrarmi sull’impatto che hanno avuto sul mondo degli addetti ai lavori, su quello dei ricercatori o di chi si occupa di formazione, con occhio attento al forte aumento di giovani visitatori che si è registrato in entrambe le esposizioni internazionali.
President Roberto Cicutto knows what he wants for the Biennale: the greatest personalities in the field of architecture, theatre, dance, music, and obviously art and cinema. His managerial team will be the finest interpreter of our times. Cicutto’s choices are never banal; they are niche, modern choices that always make us look forward to the next Festival or Exhibition. His vision is precise, at once comprehensive and acute. It is our filter into the avant-garde of art research and it delivers clear, convincing answers to the most urgent questions we have as a society. The immense cultural heritage he is responsible for shapes and re-shapes in continuous evolution thanks to the professionality of the directors of the individual sections. Each is part of an active dialogue with artistic creation from the past, opens and develops debate, answers questions and asks further questions. Roberto Cicutto is thoroughly committed to keeping this unparalleled treasure of culture and knowledge alive and vital by constantly reopening confrontation and debate on modernity.
A perfect example is his choice of Lesley Lokko, the first ever African curator of the Architecture Biennale. The Venice Biennale thus becomes a global point of observation that is able to use the future to shed some light on the present.
A geography which is more and more inclusive. In this Architecture Biennale we will be invited to go beyond the Western comfort zone towards a new re-globalization as it never happened before. Where did the choice of Lesley Lokko come from and what elements of her curatorial path fascinate you the most?
I think that Architecture is becoming increasingly an all-inclusive discipline. It looks like this discipline is asked more and more to take on all the big issues of our planet and to look for solutions which go beyond its own field. At present Architecture is being asked to solve global emergencies such as droughts and climate crises suggesting practical and fast solutions.
Lesley Lokko’s choice is the result of a deep reflection as well as of the last two exhibitions curated respectively by Hashim Sarkis and Cecilia Alemani that she has considered as real schools and which have taught me a lot in terms of experience. Having experienced them from the inside, even if I hadn’t appointed myself the two curators, I had the opportunity to analyze the reactions of the different audiences towards these two exhibitions which were very different in themes and contents, but equally capable of enriching me in a significant way. I was able to focus on the impact they had on the world of insiders, researchers or those involved in training and in particular on the strong increase in young visitors in both international exhibitions. Sarkis’ exhibition strengthened my conviction that it was important to turn to professionals who, in their role of curators, regardless of their real or supposed status as “starchitects”, could deeply question the needs of our contemporary world and bring artifacts or models of buildings as a concrete expression of their reflections and beliefs. The contemporary world has shown us in a very short time many different critical issues, starting from the pandemic, then passing through the outbreak of a tragic war like the one still underway in Ukraine and thus
La mostra di Sarkis ha rafforzato in me la convinzione che, a prescindere dal loro status vero o presunto di ‘archistar’, fosse importante rivolgersi a professionisti che nel ruolo di curatori si interrogassero profondamente sulle esigenze del mondo contemporaneo, naturalmente portando poi manufatti o modelli di edifici come espressioni tangibili delle proprie riflessioni e convinzioni.
Il mondo contemporaneo ci ha mostrato in brevissimo tempo tante e diverse criticità, partendo dalla pandemia, passando poi per lo scoppio di una guerra tragica come quella ancora in corso in Ucraina e sfociando dunque in un inasprimento della crisi climatica in tutti i suoi drammatici e sempre più evidenti risvolti energetici.
Il contesto mondiale attuale sembra quindi averci dato parecchi spunti per poter agilmente individuare quali siano i temi sui quali dovremmo focalizzarci prioritariamente.
Prima di scegliere la nostra curatrice abbiamo steso una lunga lista di architetti, sentendo diverse persone e guardandoci bene attorno. Avevo avuto già modo di conoscere di persona Lesley Lokko, essendo stata membro della Giuria Internazionale proprio della Biennale diretta da Sarkis. Tra il novero dei potenziali candidati compresi nella lista che avevamo stilato è stata quella che certamente mi ha convinto di più. In lei ho trovato una professionista capace di occuparsi di architettura in maniera teorica ma non ideologica, con una mentalità aperta, con una visione precisa sul senso più profondo del fare architettura oggi nella quale ho ritenuto che il mondo, in primis la comunità dell’architettura internazionale, avrebbe trovato molti stimoli vivi nell’atto di confrontarsi con essa.

Portando alla ribalta il contesto africano Lesley ci mette in contatto con la parte del mondo anagraficamente più giovane, ma che paradossalmente ha già affrontato nella propria storia le criticità che il mondo occidentale oggi ritrova drammaticamente nella propria agenda quotidiana. Quando mi ha raccontato quello che avrebbe voluto fare mi sono reso conto di come le materie trattate nel suo racconto si sarebbero dimostrate universali, trasversali, stimolanti per diversi pubblici e assolutamente doverose di attenzione e risalto su un ideale tavolo di discussione e confronto.
Credo che la cosa più interessante in questo momento sia proprio avere una posizione chiara e definita su cui potersi confrontare, oltre che fornire una panoramica su quello che nel mondo sta succedendo.
È netta la sensazione che le ultime Biennali abbiano prodotto un deciso balzo in avanti sul terreno del confronto diretto, onesto, a volte acceso con il presente, in dialogo stretto e ravvicinato con i temi più scottanti e aggrovigliati dell’attualità, non costringendosi nel rassicurante recinto della disciplinarità. Scelte radicali, figlie dei tempi. Quale direzione di fondo sta percorrendo la ‘sua’ Biennale nell’indagare le complesse e intriganti vie della contemporaneità?
La Biennale intercetta, a prescindere da chi la dirige, l’aria del tempo. Le Mostre di architettura si sono già poste il problema della consapevolezza come tematica centrale all’interno del dibattito e del progetto espositivo; quelle di arte, a modo proprio e a seconda delle specifiche dinamiche curatoriali e di allestimento seguite volta per volta, hanno fatto lo stesso, ponendo anch’esse questo tema al centro del proprio percorso espositivo.
Credo al contempo che si debba sempre cercare di salvaguardare il
DNA dei diversi progetti che si vanno a definire e costruire. Ciò detto, il clima che tutti noi viviamo non può non connotare fortemente anche i nostri progetti, per quanto profondamente diversi gli uni dagli altri per contenuto e visioni curatoriali. Insomma, per essere chiari, nessuno ha pensato di dedicare un festival al Covid, ma la sua presenza si è riflessa praticamente in ogni singolo lavoro che abbiamo potuto vedere nelle diverse mostre, di arte come di architettura, e nei diversi festival di cinema, di teatro, musica o danza.
Il peso della contemporaneità si sente tutto, pervade ogni millimetro dell’attività de La Biennale. Il tratto nuovo, lo scarto deciso che quei drammatici due anni pandemici hanno prodotto rispetto al pre-Covid è rappresentato indubitabilmente dall’esigenza di confrontarsi oggi più che mai con il concetto di responsabilità: non ci troviamo più impegnati a mettere in piedi macchine straordinarie, ma siamo in un contesto in cui il bello e il nuovo superano i propri confini per mettersi al servizio di uno scopo più alto e più responsabile. Si spiega in quest’ottica un’iniziativa come Piazza Ucraina, realizzata nello Spazio Esedra in occasione dell’ultima Biennale Arte, a cura di Borys Filonenko, Lizaveta German, Maria Lanko, curatori del Padiglione Ucraina: una contemporaneità che incontra La Biennale in maniera ragionata, coerente, non in una modalità fine a se stessa, autoreferenziale e decontestualizzata.
Già con Ralph Rugoff e i suoi “tempi interessanti”, May You Live in Interesting Times, e con il richiamo di Cecilia Alemani all’elemento materno, radicale, Il latte dei sogni, credo sia chiaro come La Biennale non segua il politicamente corretto, disponendosi con il proprio sguardo verso la più stretta attualità senza filtri e deformazioni.
Adriano Pedrosa, prossimo curatore della Biennale Arte 2024, viene dal Brasile non perché con questa scelta intendevamo colmare chissà quale mancanza seguendo il mero bilancino delle geografie di provenienza, ma perché ci sembrava doveroso che sotto i riflettori finisse un altro pezzo di quel “Sud del mondo” troppo spesso dimenticato, quando non addirittura stravolto nei racconti, nelle narrazioni come si dice oggi, del nostro presente.
Se si volesse portare avanti oggi ancora l’idea di curatore duro e puro, ben trincerato dietro a dogmi propri e inscalfibili, credo che si finirebbe per non vedere, non ascoltare, e quindi non rappresentare una larga parte di vita e di pensiero della contemporaneità che in questo presente non può davvero più essere trascurata. Una pluralità di sentire, di vivere, un insieme esperienziale caleidoscopico che oggi deve obbligatoriamente fare da substrato ai nostri dibattiti. Per alcuni sarà la scoperta dell’acqua calda, per noi è semplicemente un’esigenza che dalle ultime Biennali è emersa fortissima e che non può in alcun modo essere ignorata.
È decisamente tempo che parole come “laboratorio” e “sostenibilità” vengano riempite di significato, soprattutto a Venezia, dove le sentiamo nominare tanto, sin troppo. La mia concezione della Biennale è di un laboratorio, un luogo di verifica di tante ipotesi, nucleo di pensiero da cui è nata l’idea che ha portato alla creazione del Centro Internazionale della Ricerca sulle Arti Contemporanee. Le Mostre rappresentano le tappe di un percorso iniziato 130 anni fa, costituito da diversi momenti di riflessione, tutti necessari e funzionali l’uno all’altro. La Biennale, quindi, non si conclude di certo il 27 novembre: tutto ciò che è stato detto e fatto deve entrare in un circuito in cui tutto viene recuperato, portando avanti una riflessione infinita.
Il tema della sostenibilità di anno in anno occupa sempre di più il centro dei programmi a breve, medio e lungo termine di governi nazionali, di istituzioni internazionali, di interi settori industriali. Seppur quasi fuori tempo massimo, come sempre purtroppo accade, l’attenzione verso questa drammatica criticità del nostro esistere sul pianeta terra sta finalmente caratterizzando i comportamenti dei più, perlomeno nelle società ad alto tasso di industrializzazione e di benessere. Naturalmente il tutto ha un riflesso immediato anche sui processi di elaborazione culturale, anzi, sono essi stessi i motori più attivi al servizio di un simile cambiamento di prospettiva esistenziale del nostro stare al mondo nell’era digitale. Il rischio è che questa attenzione, questa accresciuta sensibilità si faccia maniera, moda, mera tendenza cool, come direbbero gli anglosassoni. Oggi chi non si dice green è out insomma. In che modo, con quale visione e disposizione la Biennale si confronta con questa emergenza planetaria evitando facili allineamenti al verbo della mera comunicazione mediatica? Come questo tema viene affrontato anche da un punto di vista concretamente pratico, nella cura degli allestimenti ad esempio?

Penso che le scelte più lontane dal politicamente corretto possano per certi aspetti essere paradossalmente anche quelle più vicine al politicamente corretto. Da Presidente non ho pensato di affidare la curatela a Lesley Lokko in quanto “donna africana”, designazione che potrebbe essere facilmente etichettata come politicamente corretta, ma ho scelto quello che una donna africana come Lesley Lokko mi ha trasmesso. Da subito si è preoccupata di definire che il tema su cui avrebbe invitato partecipanti alla mostra e visitatori a confrontarsi non sarebbe potuto essere circoscrivibile al problema pur rilevantissimo del risibile spazio che alcune parti del mondo avevano guadagnato anche negli ultimi decenni nel dibattito non
resulting in an exacerbation of the climate crisis in all its tragic and increasingly evident energy implications. The current world context therefore seems to have helped us to identify quite easily the priority issues to focus on. Before choosing our curator, we drew up a long list of architects, listening to different people. I had already had the opportunity to meet Lesley Lokko in person, as she was a member of the International Jury of the Biennale directed by Sarkis. She was the one who certainly convinced me the most among the potential candidates included in the list we had drawn up as, in my opinion, she is a professional capable of dealing with architecture in a theoretical but not ideological way. I found open mindedness in her, and a precise vision on the meaning of making architecture today. By bringing Africa to the fore, Lesley puts us in contact with the youngest continent in the world which paradoxically has already addressed in its history many of the big issues the Western world is facing today. When she told me what she wanted to do, I soon realized that the subjects she was dealing with would be universal, transversal, stimulating for different audiences and absolutely deserving the attention of all the participants to the table of discussion. I think the most interesting thing right now is to have a clear and defined position open to discussion, not only to give an overview of what is happening in the world.
It feels like the latest editions of the Biennale have taken a decisive leap forward in the field of a direct, honest and sometimes heated debate with the present, in close dialogue with the current hottest topics. What direction is “your” Biennale taking in its investigation into the complex and intriguing paths of contemporaneity?
The Biennale always captures the air of the time, whoever the director is.
Architecture exhibitions have already raised the issue of awareness as a central theme within the debate and exhibition project. Art exhibitions, each in its own way depending on its specific curatorial and installation dynamics, have done exactly the same. At the same time, I believe that we must always try to safeguard the authentic DNA of the different projects. That said, the present situation has a strong impact on our projects, although they are very different for their contents and their curatorial visions. Just to be clear, no one has thought of devoting a festival for instance to Covid, although it was present in every single work on display within art and architecture exhibitions as well as within cinema, theater, music and dance festivals.
The weight of contemporaneity can be felt in every infinitesimal part of La Biennale production. The new trait, the major difference from the pre-Covid period the two dramatic pandemic years brought about, is represented by the need to deal with the concept of responsibility more than ever. We are no longer committed to setting up extraordinary machines based on beauty and on something new, but we are in a context in which the beautiful and the new go beyond their own boundaries to serve a higher and more responsible purpose. This explains an initiative such as Piazza Ucraina, realized in the Spazio Esedra on the occasion of the last Art Biennale, curated by Borys Filonenko, Lizaveta German, Maria Lanko, curators of the Ukrainian Pavilion. This contemporaneity meets La Biennale in a reasoned, coherent way.
solo architettonico, ma culturale nel senso più esteso del termine. Dal primo momento ha sottolineato quanto questa fotografia del contemporaneo fosse incompleta, palesando l’intenzione di concentrare i suoi sforzi in questo ambizioso progetto di dare luce viva e nuova a vaste zone d’ombra meritevoli di attenzione sia nell’ambito settoriale dell’architettura, che nel più vasto alveo della società civile. E questo fuori da ogni logica di appartenenza, per così dire, meramente “continentale”.
Credo che un ruolo come quello che ho la fortuna di rivestire in questi anni, ossia quello di Presidente di un’istituzione culturale di respiro internazionale quale è La Biennale di Venezia, debba di per sé indurre ad aiutare chiunque si dimostri teso a ricercare nuovi scenari, nuove prospettive di ricerca nell’ottica di arricchire la conoscenza culturale, antropologica, ambientale di questo nostro vasto mondo, al fine di favorirne al meglio la comprensione e lo studio. Se esistono lacune, La Biennale si deve sforzare di colmarle.
Le idee portate avanti da Lesley Lokko partono dall’esperienza, non da granitiche convinzioni ideologiche slegate dalla realtà. Credo sia doveroso fare in modo che al dibattito architettonico internazionale si aggiungano voci alternative a quelle che per secoli hanno dettato legge, cosa che Lesley Lokko è determinata a fare con una mentalità aperta e connettiva.
Per quel che concerne il nostro impegno concreto, diretto e quotidiano sul fronte della tutela ambientale, innanzitutto mi preme dire che stiamo già da tempo portando avanti il progetto sulla neutralità carbonica. Credo che anche in questo caso la credibilità che abbiamo guadagnato sul campo negli anni abbia giocato un ruolo chiave nel permetterci di ottenere importanti finanziamenti a riguardo. Tutti i fornitori Biennale utilizzano oggi energia green e i curatori affrontano il proprio lavoro secondo la logica del riutilizzo. Lesley Lokko riutilizzerà per gli allestimenti oltre l’80% del materiale impiegato per la mostra di Cecilia Alemani; Pedrosa già ci ha chiesto di poter visionare quello che si sta utilizzando quest’anno, per impostare la propria attività in vista della Biennale 2024 seguendo la stessa logica di riutilizzo.
La neutralità carbonica è un’iniziativa in cui crediamo fermamente. Un progetto costoso che riusciamo comunque a sostenere senza far ricadere sul visitatore gli oneri, evitando quindi di ricorrere a maggiorazioni sul prezzo dei biglietti.
Sin dai suoi primi passi da Presidente – certo nel non fortunato anno primo dell’età pandemica, il 2020, in particolare con la mostra Le Muse Inquiete che ha visto coinvolti tutti i direttori coordinati da Cecilia Alemani – ha inteso dare un segnale forte ed eloquente circa la necessità, l’opportunità unica che la Biennale ha proprio costitutivamente di accelerare nel dialogo, nel confronto ravvicinato tra i diversi linguaggi artistici che i vari settori sviluppano con i propri festival e le proprie mostre. Contestualmente a questo segnale importante di contaminazione, di dialogo vivo tra le varie arti, sta finalmente prendendo sempre più corpo il nuovo ASAC, l’Archivio Storico delle Arti Contemporanee, che tutela, conserva e valorizza il patrimonio documentale della Biennale di Venezia raccolto in più di un secolo, dal 1895 a oggi. Come sta procedendo questo ambizioso percorso?
Non si deve pensare che questo dialogo tra settori differenti sia
With Ralph Rugoff’s May You Live in Interesting Times, and with Cecilia Alemani’s reference to the maternal, radical element, The Milk of Dreams, La Biennale has already shown it doesn’t want to follow political correctness but just to look at the present as it is.
Adriano Pedrosa, the next curator of the Art Biennale 2024, is from Brazil and by choosing him we didn’t intend to fill any geographical gap, but we just wanted to add another piece of that “Southern part of the world” which is too often forgotten or often distorted in the stories of our present.
Today it is no more possible to carry on the traditional idea of the curator who hides behind his own and unshakeable dogmas, as this would mean not seeing, not listening, and therefore not representing a large part of life and thought of our contemporary world that we cannot neglect. This plurality in our way of feeling, of living the present must be at the base of our debates. For us it is simply a need that has emerged very strongly from the last Biennials and that can in no way be ignored.
It is definitely time for words like “laboratory” and “sustainability” to be filled with meaning, especially in Venice, where we hear them mentioned so much, too much. My idea of Biennale is a laboratory, a place where you can test many hypotheses. The International Center for Research on Contemporary Arts was born exactly from this idea. The Exhibitions represents the different steps of a journey which began 130 years ago consisting of different moments of reflection, in a tight relationship the one to the other. The Biennale, therefore, certainly does not end on November 27th, everything that has been said and done must enter a cycle where everything is recovered, pursuing an endless reflection.
The theme of sustainability is more and more at the center of short, medium and long-term programs of national governments and international institutions. The attention to this dramatic issue of our existence is eventually having an impact on the behavior of most people, at least in societies with a high rate of industrialization and well-being. This affects as well the cultural field which indeed plays a major role from this point of view. The risk is that this increased sensitivity towards sustainability may turn into a mere fashion. Today it is almost an obligation to be green, if you are not green you are out. How does the Biennale confront this planetary emergency? How is this theme being addressed to also from a practical point of view, considering for instance the setting-up of the exhibition? I think that the choices which may seem the furthest from political correctness may in some respects paradoxically also be the ones which are the closest to it. I did not think of entrusting the curatorship to Lesley Lokko as an “African woman”, a designation that could easily be labeled as politically correct, but I just chose what an African woman like Lesley Lokko conveyed to me. She has immediately wanted to underline that the point was not to put at the center of the debate the small space that some parts of the world had gained in recent decades not only in architectural field but in the cultural world in general. From the very first moment she has emphasized how such a picture of the contemporary was incomplete, showing her willing to concentrate her efforts in this ambitious project, giving a new light to multiple and vast shady areas absolutely worthy of attention.
un confronto automatico, meccanico. Può esserlo stato per un breve periodo all’inizio del mio mandato, ma perché c’era un vuoto da riempire determinato dal Covid che fece saltare la Biennale Architettura, un impulso da cui era necessario partire per avviare un processo di ricerca e di espressione culturale il più articolato possibile. Da lì, certo, la mia convinzione in questa direzione di dialogo attivo tra i diversi linguaggi espressivi si è acuita e consolidata, pur consapevole del fatto che mentre si aprono nuovi vasi comunicanti è anche importante non travalicare alcuni confini che necessariamente ancora delimitano le differenze vocative, identitarie delle diverse arti. Su certi terreni, ad ogni modo, il confronto e il dialogo è già pratica quotidiana. Per esempio sul piano comunicativo, di condivisione dei temi sviluppati dai diversi settori tra i direttori e i loro rispettivi gruppi di lavoro. Poco tempo fa abbiamo organizzato una call online con il direttore Pedrosa al fine di introdurlo ai componenti dei diversi settori della Biennale e allo staff che dovrà lavorarci assieme.
Ancor più in questa prospettiva di condivisione, l’ASAC sarà l’epicentro in cui dovranno convergere tutti i vari settori. Quando ho iniziato il mio mandato il progetto di rilancio dell’ASAC con il suo spostamento all’Arsenale era già stato tracciato. Non è arrivato con il PNRR, era già stato finanziato dal Ministero della Cultura: si era stabilito il luogo e diversi aspetti logistici erano già stati accuratamente definiti. Insomma, noi abbiamo solo completato il progetto, grazie allo stanziamento dei Fondi Europei per gli operatori culturali. Credo che questa nuova fase del nostro archivio determinerà lo sviluppo di nuove attività e progetti di ricerca. La creazione stessa del Centro Internazionale della Ricerca sulle Arti Contemporanee e lo sviluppo vissuto in questi anni dalle diverse attività di College sono segnali di una rinnovata vivacità espressiva che deve essere assecondata. Da una recente ricerca dell’ASAC, che mi sento di definire a tutti gli effetti “la Settima Arte della Biennale”, è risultato che ciò che interessa di più ai 120 studenti che si sono spesi nelle nostre attività è proprio l’interazione con studiosi di altri settori, il confronto diretto con esperti di altre materie, con colleghi di Università: della Sapienza con lo IUAV, del Conservatorio Benedetto Marcello con lo IULM, e così via.
Pensiamo al progetto Erasmus e all’incalcolabile arricchimento culturale che ha portato a generazioni di studenti di tutto il mondo: noi non abbiamo la presunzione di rappresentare un Erasmus della cultura, ma di sicuro attingiamo allo stesso spirito quando organizziamo le nostre attività. Ovviamente se i ragazzi sono incentivati al dialogo, la cosa può e deve valere anche per i curatori. Un dialogo che deve essere sostanzioso e radicale, in una parola ingegnoso.
La Biennale è in continuo movimento anche sul fronte dei nuovi spazi espositivi. Quali novità si registrano e si registreranno a riguardo?
Di recente sono stato al Casinò del Lido per un sopralluogo ai lavori di restauro e ridefinizione degli spazi di quello straordinario edificio, rimanendo sorpreso dal cantiere aperto in pieno divenire. La Sala Perla non esiste più: gli spazi sono stati completamente rimontati, ri-arredati e tecnologicamente ri-attrezzati con poltrone e un palcoscenico che potrà essere utilizzato al meglio grazie a tecnologie di proiezione all’avanguardia. Prosegue la costruzione delle torri con ascensori per dare maggiore accessibilità ai disabili e si sta lavorando alle uscite di sicurezza. Insomma, lavori in corso
che finalmente daranno nuova funzionalità a un edificio di enorme valenza storica che chiedeva da anni un adeguamento per rispondere alle esigenze di servizio di un grande festival internazionale quale è la Mostra del Cinema.
Riguardo alla nuova sede dell’ASAC, stanno arrivando i progetti degli architetti per la riqualificazione degli spazi e posso affermare che si tratterà di soluzioni di livello altissimo, in linea con le migliori progettazioni internazionali di spazi per la ricerca culturale.
Oltre a questi lavori di ristrutturazione, stanno partendo altre gare che ci vedono affiancati al Comune, che interessano lavori sulle infrastrutture dell’Arsenale, tra cui anche l’iconica gru che sta davanti alle Tese. La collaborazione con il Comune in questa direzione è di vitale importanza e sta funzionando davvero molto bene.
Fondamentale per noi è che non un singolo mattone venga posizionato senza sapere quali attività si porteranno avanti nello spazio che si sta creando; dobbiamo evitare assolutamente di erigere cattedrali nel deserto, ripetendo errori fatti nel passato a cui stiamo ancora faticosamente cercando di porre rimedio.
Il ruolo in divenire della Biennale nella costruzione di un sistema città ancora troppo fragile e a tinte contrastanti. Quale contributo crede e si augura che la vostra istituzione possa dare nei prossimi anni per un futuro qualitativamente più vivibile, in termini di sostenibilità e di qualità di contenuti del vivere quotidiano, di Venezia? Cosa pensa invece di poter ricevere in questo rapporto con la città?
Vorrei che la Biennale non solo generasse ricchezza indotta, ma che contribuisse alla creazione di lavoro generativo, in una dinamica sociale capace di camminare sulle proprie gambe, producendo residenzialità e posti di lavoro nei luoghi in cui ci troviamo ad operare con le nostre iniziative. Penso al personale necessario al funzionamento dell’Archivio o alla residenzialità per frequenta i nostri College.
Alla città non faccio nessuna richiesta particolare. Vorrei solo si smettesse di dire che la Biennale utilizza Venezia come scenografia per portare avanti i propri affari perché credo che, molto semplicemente, questo non corrisponda alla realtà delle cose.
In ottica di neutralità carbonica, ormai da diversi anni siamo felici di condividere con il Comune e altri soggetti l’enorme quantità di dati che siamo riusciti a raccogliere con i questionari online che devono essere compilati da chi acquista biglietti per le nostre mostre. Dati molto preziosi per analizzare le abitudini di trasporto e di fruizione della città da parte di una sempre più ampia quantità di turisti che vengono a Venezia in maniera responsabile e consapevole, persone che hanno un rispetto profondo per la città e sulle cui esigenze dobbiamo sintonizzare il nostro lavoro.
Il dialogo con gli enti culturali cittadini è costante e fruttuoso, con Ca’ Foscari come con lo IUAV, con l’Accademia di Belle Arti come con il Conservatorio o con la Fondazione Cini; proseguono poi le attività d’acquisizione dei diversi Fondi, come quello Ronconi e Nono, oltre a quello di Lorenzo Cappellini.
Manca ancora al sistema culturale della città tutta uno strumento di ricerca digitale che metta in comunicazione tutti i nostri siti. Ma si tratta di una temporanea lacuna tecnica; le linee di principio per lavorare in questo senso ci trovano d’accordo, siamo tutti tesi verso questo comune obiettivo.
I believe that the role I have been called to play in the last few years, namely that of President of an international cultural institution such as the Venice Biennale, should help anyone who is willing to look for new scenarios, new research perspectives with a view to enriching cultural, anthropological and environmental knowledge of our world in order to better promote its understanding and study. La Biennale must strive to fill any possible gaps. The ideas pursued by Lesley Lokko come straight from experience, they are rooted in reality. I believe it is vital to ensure that alternative voices are invited to the table of architectural debate and this is exactly what Lesley Lokko, thanks to her open mind, is determined to do. As far as our concrete, direct and daily commitment to environmental protection is concerned I would like to underline that we have been pursuing the project on carbon neutrality for some time. I believe that the credibility we have gained over the years has played a key role in obtaining important funding for this project. All the Biennale’s suppliers today use green energy and the curators develop their work following the logic of reusing. Lesley Lokko will reuse for the Biennale installations more than 80% of the material used for Cecilia Alemani’s exhibition, while Pedrosa has already asked us to view what we are using this year, to develop his activity in view of the 2024 Biennale following the same logic of reuse. Carbon neutrality is an initiative we firmly believe in. An expensive project that we are able to support without increasing the price of tickets.

Since your first steps as President, in the unlucky first year of the pandemic, 2020, in particular with the exhibition The Disquited Muses which involved all the directors coordinated by Cecilia Alemani, you intended to give a strong and eloquent signal about the need, the unique opportunity

that the Biennale has to speed up the dialogue, the close interaction between the different artistic languages that the various sectors develop with their festivals and exhibitions. At the same time the new ASAC, Archivio Storico delle Arti Contemporanee - Historical Archive of Contemporary Artsis finally taking shape to protect, preserve and enhance the documentary heritage of the Venice Biennale collected in more than a century, since 1895. How is this ambitious path progressing?
I’d like to underline that this dialogue between the different sectors is not an automatic and mechanical one. It may have been so just for a short period at the beginning of my term, but this was mainly due to the pandemic that prevented the Architecture Biennale from taking place that year. This has undoubtedly enhanced a process of research and cultural expression and has also consolidated my conviction of the importance to develop an active dialogue between the different art languages always keeping in mind the need of not going beyond the boundaries of each different art. The dialogue between the different art languages is already a daily practice: for instance, the different directors and their respective working groups share the themes each of them has developed within his own art sector. Not long ago we organized an online call with the director Pedrosa to introduce him to the members of the different sectors of the Biennale and to the staff he will have to work with. In such a context ASAC is to be more and more the converging point of all the different sectors. At the beginning of my term at the Biennale, the project to relaunch the ASAC and to move it to the Arsenal had already been sketched out. It had already been financed by the Ministry of Culture before the NRRP: the place as well as several logistical aspects had already been decided. In short, we have completed a project thanks to the allocation of European funds for cultural operators. I believe that this new phase of our archive will help developing new research activities and projects. The creation of the International Centre for Research on Contemporary Arts and the development experienced in recent years by the various activities of the “College” are clear signs of a renewed vivacity of expression that must be supported. A recent research by ASAC, which I believe can be considered as “the Seventh Art of the Biennale”, has shown that the most important elements for the 120 students who took part in our activities are the interaction with scholars from other sectors and the direct contact with experts in other subjects and with colleagues from other Universities: those from Sapienza with those from IUAV, those from Benedetto Marcello Conservatory with those from IULM, and so on. Let’s think of the Erasmus project and the huge cultural enrichment it has given to generations of students from all over the world: we don’t expect to represent an Erasmus of culture, but we follow the same idea when we organize our activities. If young people are encouraged to dialogue, this can and must also apply to curators. Obviously, we are talking about a substantial, smart dialogue.
The Biennale is expanding more and more its exhibition areas. Can you tell something about the new exhibition spaces for this Biennale?
I was recently at the Lido Casino for an inspection of the restoration works under way of that amazing building, and I was surprised by
this construction site in full evolution. The Sala Perla no longer exists: the spaces have been completely reassembled, re-furnished and technologically re-equipped with armchairs and a stage that can be used at its best thanks to cutting-edge screen technologies. The construction of the towers equipped with elevators is under way in view of easing the access of people with disabilities. Works on the emergency exits are under way as well. In short, works in progress that will finally give new functionality to a building of high historical value that has been asking for years for important works to be able to meet the needs of a very important international festival such as the Venice Film Festival.
As for the ASAC headquarters, we are now receiving the architects’ projects for the redevelopment of spaces and I can say that these will be solutions of the highest level, in line with the best international designs of spaces for cultural research.
In addition to these renovations, many other tenders in collaboration with the Municipality are about to start involving works on the facilities of the Arsenal, including the iconic crane that is in front of the Tese. This collaboration with the Municipality is of vital importance and is working very well indeed.
We don’t want any single brick to be placed without knowing what activities will be carried out in that specific space that is being created. We must absolutely avoid erecting cathedrals in the desert, repeating the same mistakes made in the past that we are still hardly trying to remedy.
What is the contribution you hope your institution can give Venice in the coming years for a qualitatively more livable future, in terms of sustainability and everyday life quality? What do you think you can get from this special relationship with the city?
I would like the Biennale not only to generate induced wealth, but to help as well creating residency and jobs where we are working to carry out our initiatives. I am thinking of the staff necessary for the Archive or the residence for those who come to study at our College projects. I am not asking anything special to the city. I would just like people to stop saying that the Biennale exploits Venice as a scenography to better carry out its business because I believe that, quite simply, this does not correspond to reality. As far as carbon neutrality is concerned, we are happy to have been sharing with the Municipality for many years the huge amount of data that we have been able to collect thanks to the online forms that people who buy tickets for our exhibitions have to fill in. These very important data allow us to know more about the means of transport used by an increasingly large number of tourists who come to Venice in a responsible and conscious way. Our work has to take care of the needs of these people who have a deep respect for the city. Our dialogue with the cultural institutions of the city is constant and rewarding, in particular with Ca’ Foscari, IUAV, the Academy of Fine Arts, the Conservatory and the Cini Foundation. As always, we carry out some activities such as the acquisitions of the Ronconi, Nono, and Lorenzo Cappellini’s funds.
Maybe what the cultural system of the whole city misses at the moment is a digital research tool able to connect all our sites. But this is just a temporary technical gap. We all agree to work together towards this common goal.

Intervista Giulia Foscari
di Mariachiara Marzari
Prima ancora di essere un architetto, è una cittadina (per nascita e per scelta) di Venezia, una città unica per bellezza e architettura, ma allo stesso tempo fragile e sensibile, che forse prima di tutte le altre città subisce quotidianamente, tangibilmente le criticità derivanti dalla crisi ambientale e climatica. Un esempio unico ed emblematico che in qualche modo è il rovescio della medaglia dell’Antartide, il “settimo” continente anch’esso fragile e conteso da cui dipende la sopravvivenza globale. Giulia Foscari ha percorso la distanza che separa Venezia dall’Antartide colmandola di interrogativi, ricerche, esperienze, soluzioni e progetti, al confine labile tra disciplina e attivismo. È con questa coscienza, determinazione e convincimento che ci spiega quanto sia urgente riappropriarsi della dimensione etica e politica della disciplina architettonica per partecipare alla costruzione di un futuro sostenibile.
Nata a Venezia, al tempo la più giovane iscritta all’Ordine degli Architetti in Italia, fondatrice dello studio di architettura UNA e del suo alter ego UNLESS, ha lavorato in grandi studi internazionali quali Zaha Hadid Architects, Foster & Partners e OMA/AMO di Rem Koolhaas. Cosa l’ha spinta a fare esperienze così importanti? E quale di questi architetti l’ha influenzata maggiormente?
La curiosità. Un profondo desiderio di capire e di imparare ad osservare da prospettive profondamente diverse quella che Buckminster Fuller ha chiamato la nostra “Spaceship Earth”, coltivando un atteggiamento critico che secondo me è essenziale sia per formare un pensiero architettonico, che per affrontare qualsiasi progetto. Tra gli architetti che lei ha annoverato con cui ho avuto il privilegio di collaborare, senza dubbio Rem Koolhaas è stato, ed è tuttora, per me un riferimento molto importante.
Partiamo da UNLESS, una piattaforma no-profit che supera le barriere della scienza e dei generi per rappresentare un sapere universale e condiviso su problemi d’importanza globale. Cosa si intende comunicare con il termine UNLESS e come il risultato del vostro progetto pilota, Antarctic Resolution, costituisce ora la base di una reale azione di tutela dell’Antartico in particolare e del cambiamento climatico globale più in generale?
UNLESS, in italiano, si traduce in “a meno che”. È un termine che trasmette un senso di urgenza: invoca la necessità di agire immedia-
tamente per scongiurare che qualcosa di grave si avveri. Al contempo è intriso di ottimismo, della coscienza che l’azione – individuale e collettiva – ha il potenziale di invertire la rotta su «l’autostrada che porta all’inferno climatico» (per citare l’espressione del Segretario Generale delle Nazioni Unite alla recente assemblea di COP27, tenutasi a Sharm El Sheik). Sulla base di questo convincimento ho fondato UNLESS, un “agency for change” interdisciplinare con cui ci impegniamo ad assumere le responsabilità sociali che la professione dell’architetto dovrebbe sempre fare proprie, coscienti che l’industria in cui siamo coinvolti contribuisce al 40% delle emissioni e determinati a lavorare per garantire la difesa della giustizia inter-generazionale. La missione di UNLESS è quella di catalizzare l’attenzione globale sui Beni Comuni dell’Umanità, ovvero territori estremi quali l’Antartide, l’Oceano, l’Atmosfera e lo Spazio, che appartengono all’umanità intera ma che, essendo privi di popolazioni indigene, non hanno una loro circoscrizione che possa rivendicare la definizione di una governance appropriata che ne garantisca la salvaguardia. Con il nostro primo progetto, Antarctic Resolution, ci siamo prefissati di mettere in luce il “problema antartico”, che è trascurato dalla coscienza collettiva e in parte sottaciuto da chi il sapere lo detiene per soddisfare interessi geopolitici, ma che deve essere invece urgentemente affrontato.
La ricerca è un elemento fondativo della sua pratica come architetto. Una passione che l’ha portata ad avere cattedre universitarie sia a Hong Kong University che all’Architectural Association di Londra, e che si è poi espressa anche attraverso la pubblicazione di importanti volumi, tra cui appunto Antarctic Resolution, che recentemente è stato premiato dalla Commissione Europea. Qual è il messaggio chiave racchiuso nelle mille pagine di questo libro e come si è evoluto il progetto?
Antarctic Resolution è un libro scritto a 300 mani. Sono infatti 150 gli esperti mondiali multidisciplinari che hanno collaborato in

questo sforzo collettivo finalizzato a costruire un’immagine ad alta risoluzione del nostro settimo continente – un territorio conteso che rappresenta il 10% della superficie terrestre, il 70% dell’acqua dolce della Terra e il 90% dei suoi ghiacci. Il volume enciclopedico enfatizza il ruolo dell’Antartide nell’ecosistema globale, evidenziandone il potenziale distruttivo (in uno scenario in cui lo scioglimento dei suoi ghiacciai proceda al ritmo attuale, pari al volume di 200 piscine olimpioniche al minuto, rischiando di sommergere le coste del mondo intero) e costruttivo – in quanto l’Antartide rappresenta il più importante archivio planetario della storia climatica del nostro Pianeta, offrendo dati scientifici che sono essenziali per la definizione di politiche ambientali. Ma Antarctic Resolution – da poco accessibile in versione integrale online sulla piattaforma Open Access che abbiamo lanciato nel convincimento che si debba perseguire una democratizzazione dei dati – non si prefigge ‘solo’ di produrre e diffondere sapere sull’Antartide, ma deve anche essere intesa come una un call to action, in quanto delinea “risoluzioni antartiche” a mio giudizio improrogabili.
Ovvero? Può farci qualche esempio di cosa concretamente si intenda quando si parla di “risoluzioni antartiche”?
In primis la necessità di promuovere un cambio di paradigma radicale nella gestione dell’Antartide che porti alla modifica degli statuti di governance del continente, imponendo agli stati membri del Trattato Antartico (sottoscritto nel 1959) l’obbligo di far confluire gli esiti delle loro ricerche scientifiche e i dati raccolti nel continente in un Antarctic Data Center transnazionale accessibile a studiosi del mondo intero. Credo davvero che nella condizione di poli-crisi che stiamo vivendo la definizione di una governance transnazionale per i Beni Comuni dell’Umanità sia un imperativo morale verso le future generazioni cui non possiamo, e non dobbiamo, sottrarci. Con lo stesso spirito di collaborazione e condivisione globale, ritengo sia urgente definire un masterplan per il continente che promuova la realizzazione di stazioni scientifiche internazionali,
She is an architect, but first, she is a citizen of Venice, a city that is unique in beauty and architecture, but is also fragile and sensitive. More than any other city, Venice endures in tangible fashion the environmental and climate crisis. A single example that, in some way, is the opposite of Antarctica, the seventh continent. Antarctica is as much fragile and contended, and global survival depends on it. Giulia Foscari traced the distance between Venice and Antarctica with questions, research, experience, solutions, and projects: work that is midway between professional practice and activism. Thanks to conscience, determination, and conviction, she will explain how urgent it is to reappropriate the ethical and political dimensions of architecture and participate to the building of a sustainable future.
Born in Venice, at the time the youngest member of the Order of Architects of Italy, founder of the architectural office UNA and its alter ego UNLESS, you worked in international architectural firms such as Zaha Hadid Architects, Foster & Partners and Rem Koolhaas’ OMA/AMO. What drew you to such profoundly different experiences? And which of these architects influenced you the most?
Curiosity. A deep desire to understand and learn how to observe what Buckminster Fuller called our “Spaceship Earth” from profoundly different perspectives, cultivating at all times a critical attitude that in my opinion is essential both to form an architectural thought and to inform any project. Amongst the architects you mentioned, with whom I had the privilege of working, unquestionably Rem Koolhaas has been, and still is, a very important reference for me.
Let’s start with UNLESS, a non-profit organisation that crosses the barriers of science and disciplines to represent a universal, shared knowledge on issues of global importance. What does UNLESS mean, and how does the result of your pilot project, Antarctic Resolution, now form the basis for real action to protect the Antarctic in particular, and global climate change more generally?
UNLESS is a term that conveys a sense of urgency: it invokes the need for immediate action to avert something severe from happening. At the same time, it is a term imbued with optimism, with the consciousness that action - individual and collective - has the potential to subvert our trajectory on “the highway to climate hell” (to quote the UN Secretary General’s opening statement at the recent COP27 assembly held in Sharm El Sheik). On the basis of this conviction, I founded UNLESS, an interdisciplinary “agency for change” in which, conscious that the industry in which we operate contributes to 40% of the global emissions, we embrace the

arrestando il processo in corso che induce la proliferazione di stazioni-ambasciate che antepongono interessi geopolitici a interessi scientifici, che sono gli unici essenziali da esercitare per la sopravvivenza delle specie, umane e non, del Pianeta.
Come concilia il lavoro di UNA, lo Studio impegnato ad assolvere commissioni pubbliche e private, con le azioni di UNLESS?
Beh, umanamente è un’impresa piuttosto intensa in quanto sono due realtà totalizzanti cui vorrei dedicare più tempo di quanto ne abbia a disposizione. Ma da incurabile ottimista quale sono e da amante delle sfide credo vivamente che debbano essere perseguite entrambe, obiettivo possibile solo grazie all’incessante lavoro del fantastico team di colleghi con cui ho la grande fortuna di lavorare, tra i quali ci tengo in particolar modo a ricordare Federica Zambeletti. Ideologicamente, per quanto UNA e UNLESS siano per natura due organizzazioni diverse, sono intrinsecamente legate dal convincimento che sia urgente riappropriarsi della dimensione etica e politica della disciplina architettonica per partecipare alla costruzione di un futuro sostenibile. Questo implica, per UNA, la scelta consapevole di lavorare prevalentemente su progetti di preservation, ovvero interventi anche radicali sul patrimonio costruito esistente.
A proposito di interventi radicali, lei è capo progetto della Fondazione Anish Kapoor qui a Cannaregio. Può parlarci di questo straordinario intervento su uno storico edificio da molti anni abbandonato quale è Palazzo Manfrin e delle ambizioni progettuali della Fondazione del grande artista anglo-indiano?
Il palazzo scelto da Anish Kapoor come sede del Manfrin Project è il risultato di uno processo metamorfico durato cinque secoli. Concepito dapprima come un edificio gotico di ridotte dimensioni, cui sono stati progressivamente annessi volumi limitrofi, il palazzo è stato trasformato nel corso del ‘700 dall’architetto Andrea Tirali, il quale ha introdotto nella fabbrica antica due grandi vuoti (un inaspettato salone a doppia altezza e un cortile alla romana) e ha anteposto all’edificio una facciata protorazionalista. Così è apparso al pubblico colto della Galleria di Girolamo Manfrin il palazzo prima di cadere nell’oblio collettivo per un rapido susseguirsi di proprietari, con conseguenti anni di abbandono. Quando siamo stati chiamati a progettare entro queste mura un laboratorio di sperimentazione ed esposizione d’arte per Anish abbiamo deciso di avviare una nuova fase di metamorfosi, che al contempo lasciasse in evidenza le tracce di degrado della storia del palazzo introducendo delle innovazioni architettoniche che possono assecondare le particolari esigenze espositive di questo grande artista contemporaneo, favorendo il dato della flessibilità nella programmazione. A tal fine, come Tirali, abbiamo lavorato per sottrazione, liberando il piano terreno da ogni superfetazione o impedimento al fine di creare una permeabilità con il tessuto urbano circostante, così da indurre i cittadini a ritenere questi spazi come elementi qualificanti della loro quotidianità, violando così la natura ermetica con cui il palazzo si è presentato alla città per secoli. Per enfatizzare la porosità del piano terreno e favorire l’accesso di opere di grandi dimensioni abbiamo introdotto anche una galleria autonoma di inaspettate proporzioni e rafforzato la portata della pavimentazione, connettendo questo intervento alla
social responsibilities of the architect in defence of inter-generational justice. The mission of UNLESS is to catalyse global attention to our Global Commons, namely extreme territories such as Antarctica, the Ocean, the Atmosphere and Space, which belong to humanity at large, but which, in absence of any indigenous population, have no constituency of their own that can demand the establishment of appropriate governance models to ensure their preservation. With our first project, Antarctic Resolution, we set out to highlight the “Antarctic problem” which is neglected by the collective consciousness, partly silenced by those who withhold the knowledge to fuel geopolitical interests, but which needs to be urgently addressed.
Research is a foundational element of your practice. It is a passion that led you to hold prestigious teaching positions both at the University of Hong Kong and the Architectural Association of London, and which has since led into the publication of important volumes, including Antarctic Resolution recently awarded also by the European Commission. What is the key message contained in the thousand pages of this book and how did the project evolve?
Antarctic Resolution is a book written by 150 multidisciplinary global experts, who collaborated in a collective effort to build a high-resolution picture of our seventh continent – a contested territory that accounts for 10% of the landmass of Planet Earth, 70% of its fresh water and 90% of its ice. The encyclopaedic volume emphasizes Antarctica’s role in the global ecosystem, highlighting its destructive potential (in the scenario in which the melting of its glaciers proceeds at the current rate, equal to the volume of 200 Olympic-size swimming pools per minute, threatening to submerge the world’s coastlines) and its constructive one, most evident if one considers that Antarctica represents the greatest archive of our planet’s climate history, offering scientific data that is essential to inform environmental policymaking. But Antarctic Resolution – newly accessible online on the homonymous Open Access platform that we launched to promote data democratization – does not “only” set out to produce and disseminate knowledge about Antarctica, but it should be understood as a “call to action”, in that it outlines imperative “Antarctic resolutions” that in my view are undeferrable.
Could you give us some examples of Antarctic resolutions?
Firstly, the need to promote a radical paradigm shift in the management of Antarctica that induces changes in the governance statutes of the continent, by imposing on the Member States of the Antarctic Treaty (signed in 1959) the obligation to share the outcomes of their scientific research and especially the data collected on the continent, into transnational Antarctic Data Center, accessible to scholars from around the world. I truly believe that in the poly-crisis condition we are experiencing, the definition of innovative transnational governance models for the Global Commons is a moral imperative that needs to be embraced for future generations.
In the same spirit of global collaboration and sharing, I argue that it is urgent to define an actual masterplan for the continent that promotes the establishment of international scientific stations,



realizzazione di un sistema di protezione dalle cosiddette acque alte fino a una quota di 2,10 metri sul medio mare. Raggiunti questi primi obbiettivi abbiamo allestito una mostra nel cantiere in occasione della Biennale Arte 2022 – un’esposizione in cui abbiamo voluto esaltare la condizione di work in progress dell’edificio – e ci stiamo accingendo ora a riavviare il cantiere e procedere alla realizzazione del progetto per piani successivi al primo.
Il processo di metamorfosi sembra connotare in maniera spiccata il suo fare architettura, non a caso è questo uno dei temi ricorrenti in Elements of Venice, il libro che ha pubblicato nel 2014 e che di fatto può essere letto come una sorta di visione/versione contemporanea di The Stones of Venice di John Ruskin. Come è nata l’idea di questo catalogo di elementi fondamentali dell’architettura della città e quali risvolti operativi offre per una migliore comprensione della città stessa?
L’idea di analizzare singolarmente gli elementi fondamentali dell’architettura è stata proposta da Rem Koolhaas, che ha dedicato a questo tema il Padiglione Centrale della Biennale Architettura 2014. All’epoca vivevo a Buenos Aires in quanto ero responsabile della piattaforma sudamericana di OMA/AMO e collaboravo strettamente con Rem quale membro del suo curatorial team per la Biennale. In quel contesto mi era parso interessante testare la sua tesi a scala urbana, prendendo come caso-studio la città che ospita la Biennale stessa, Venezia. Confesso che questa intuizione era anche dettata da un desiderio intimo di studiare finalmente in modo sistematico l’architettura della mia città natale, da cui mi ero allontanata a 17 anni per coltivare la mia indipendenza. Elements of Venice è dunque stato concepito in questo contesto, ma ben presto ha rivelato il suo potenziale in quanto ha favorito una lettura unica della città, dimostrando quanto scelte architettoniche introdotte nella Serenissima nei secoli fossero sempre una trasposizione diretta, fisica direi, di volontà politiche, ideologiche, sociali e non fossero solo frutto di una ricerca formale come si potrebbe pensare. La ricerca ha svelato anche la natura metamorfica di Venezia, una città all’avanguardia, liberale, che è stata per secoli un epicentro culturale, la cui forma urbana e architettonica ha subito profonde trasformazioni. Una lettura quasi forense, anatomica dell’architettura di Venezia non solo permette di leggere la storia della Repubblica, per ricollegarmi a Ruskin, sulle sue pietre, ma soprattutto trasmette, quantomeno a me, un sentimento di ottimismo che legittima architetti contemporanei a immaginare un futuro per Venezia che esuli dalla mera immagine di città-museo a cui viene spesso associata la città lagunare.
La sua presenza con svariati progetti alle molte Biennali di Architettura di Venezia sancisce un suo legame stretto con la più importante Istituzione culturale veneziana e probabilmente italiana. C’è in vista una nuova sua presenza o collaborazione?
In occasione dell’imminente Biennale curata da Lesley Lokko sono stata invitata a contribuire ad un Evento Collaterale promosso dalla New European Bauhaus (NEB). Si tratta di una conferenza di due giorni che si terrà allo IUAV alla presenza di Ursula von der Leyen, Presidente della Commissione Europea. In questo contesto contribuirò alla tavola rotonda The Global Commons and Climate Change:
Venice reporting from the front e a un laboratorio trimestrale dal titolo Radical NEB Lab, che culminerà in proposte progettuali sviluppate da studenti multidisciplinari che verranno esposte al New European Bauhaus Festival nel 2024.
Si è appena trasferita a Venezia con tutto il team di UNA e UNLESS dopo aver trascorso 25 anni tra Londra, Hong Kong, Buenos Aires e Amburgo. Cosa l’ha spinta in maniera particolare a ritornare a vivere e a lavorare nella sua città natale? Quale ruolo riveste Venezia nel suo DNA esistenziale e professionale? Quale oggi la sua idea, la sua visione di una città a un tempo ingessata nella sua dimensione univocamente turistica e oggetto di un profluvio di ipotetici progetti di riqualificazione fermi sulla carta?
Venezia è una città imprescindibile. Se si ha avuto la fortuna, come ho avuto io, di nascere qui e di essere stata educata a riconoscere in un quadro, in un’architettura, o semplicemente in un dettaglio il pensiero ideologico, culturale e politico di una Repubblica che sola, nello scenario mondiale, promuoveva e difendeva i valori di giustizia, inclusione, libertà di parola e stampa che ancora oggi tristemente non possiamo dare per assodati, è inevitabile poi che uno risenta forte il “richiamo della foresta”. E il riferimento al testo di Jack London non è certo casuale, poiché l’unicità di Venezia, e dunque il suo potere catalizzatore, non è riconducibile ‘solo’ ai suoi artefatti millenari che incorporano valori etici imprescindibili, ma anche al suo essere indissolubilmente compenetrata dalla natura e compatibile con essa, immersa com’è nelle acque salmastre della laguna da secoli. Questa capacità intrinseca di Venezia di coesistere con l’ecosistema lagunare senza metterne a rischio l’esistenza – con un approccio che oggi si può riscontrare quasi esclusivamente in insediamenti indigeni da cui possiamo solo imparare – è un aspetto su cui è il caso ancora e più che mai di riflettere attentamente. Ma questa sua condizione la rende unica quanto vulnerabile. In modo non dissimile da tutte le altre aree costiere mondiali (dalle Marshall Islands a città come Giacarta), l’esistenza futura di Venezia è minacciata dal cambio climatico antropogenico. Ma contrariamente ad altri insediamenti costieri globali che rischiano di essere sommersi da decine di metri d’acqua (basti pensare che uno scioglimento dell’Antartide porterebbe ad un innalzamento del medio mare globale di 60 metri) Venezia ha un’ineguagliabile capacità mediatica che dobbiamo assolutamente saper mobilitare verso finalità giuste. Credo pertanto che, oltre a continuare a investire culturalmente (e con incentivi finanziari) affinché si insedino in città fondazioni d’arte, Venezia – barometro del cambio climatico per eccellenza – dovrebbe diventare il centro mondiale per gli studi sul cambio climatico, creando infrastrutture transnazionali che catalizzino qui in laguna le migliori menti interdisciplinari del settore in grado di raccogliere efficacemente i dati scientifici globali essenziali per informare improrogabili politiche ambientali. Un progetto di questa natura, che se visto dalla prospettiva europea è perfettamente allineato alle ambizioni espresse nel Green Deal, permetterebbe a Venezia, storicamente “regina dei mari”, di essere ancora una volta un riferimento mondiale a riguardo, ma non più in quanto temuta Repubblica con aspirazioni di dominio, bensì in qualità di ‘protettrice’ di quegli stessi mari – oggi surriscaldati, acidificati, con ridotta biodiversità – e, con essi, promotrice della salvaguardia del nostro intero Pianeta.
halting once and for all the ongoing practice that encourages the proliferation of embassy-like station in support geopolitical ambitions to the detriment of science – the very science that is crucial to inform policies that can ensure the survival of human and non-human species on our planet.
How do you reconcile the work of UNA, the firm engaged in fulfilling public and private commissions, with the actions of UNLESS?

Well, on a personal level it is indeed quite intense, as both are totalizing realities to whom I would like to devote more time that what is realistically and physically possible. But I am an incurable optimist addicted to challenges, I feel strongly that both need to be pursued, and I manage to do this, it is thanks to the unwavering work of the fantastic team of colleagues with whom I have the great fortune to work, amongst whom I would like to mention Federica Zambeletti.
On a conceptual level, although UNA and UNLESS are by nature two different organizations, they are intrinsically connected by the underlying conviction that there is an urgent need to reclaim the ethical and political dimension of the discipline of architecture in order to participate in the construction of a sustainable future. This implies, for UNA, a conscious choice to work primarily on preservation projects, and favour interventions - often radical ones - on the existing built heritage.
On radical interventions, you are project leader of the Anish Kapoor Foundation here in Venice. Could you tell us about the palace and the design ambitions of the project?

The palace chosen by Anish Kapoor as the home of the “Manfrin Project” is the result of a five-century metamorphic process. First conceived as a small-scale Gothic building, to which neighbouring volumes were progressively annexed, the palace was transformed during the 1700s by architect Andrea Tirali, who introduced two large voids (an unexpected double-height hall and a Roman-style courtyard) within the historic building and cladded its main front with a protorrationalist stone facade. This is how the palace appeared to the educated public of the renowned gallery of Girolamo Manfrin, before falling into collective oblivion through a rapid succession of owners and years of neglect. When we were called upon to design within these walls a laboratory for experimentation and art exhibitions for Anish, we decided to launch a new phase of this metamorphosis, one that would at the same time leaves ample evidence of the traces of decay in the palazzo’s history and introduces architectural innovations that reflect the particular exhibition needs, encouraging flexibility in programming. To this end, like Tirali, we worked by subtraction, removing all impediments included within the ground floor to create a permeability with the urban fabric that induces citizens to consider these spaces as qualifying elements of their everyday life, thus violating the hermetic nature with which the palace has presented itself to the city for centuries. In order to emphasize the porosity of the ground floor and to facilitate the access of large-scale artworks, we also introduced an autonomous gallery of unexpected proportions and strengthened the load-bearing capacity of the pavement, connecting this intervention to the construction of a system of protection from the


so-called high waters that protects the building from floodings up to 2.10 meters above the mean sea level. Having achieved these initial goals, we designed an exhibition – in which we wanted to exalt the condition of “work in progress” – within the construction site itself on occasion of the Biennale Arte 2022; at present we are about to recommence the construction site and proceed with the works on the floors subsequent to the first.
It is interesting that you talk about metamorphosis, considering that it is one of the recurring themes in Elements of Venice, the book you published in 2014, and which could be interpreted as the contemporary vision of John Ruskin’s The Stones of Venice. How did the idea of this catalogue of fundamental elements of the city’s architecture come about, and what operational implications does it offer to the understanding of the city itself?
The idea of analysing independently the fundamental elements of architecture was launched by Rem Koolhaas, who dedicated the Central Pavilion of the 2014 Architecture Biennale to this theme. At the time I was living in Buenos Aires as I was responsible for the South American platform of OMA/AMO while working closely with Rem as a member of his curatorial team for the Biennale. In that context it seemed interesting to me to test his thesis at an urban scale, taking as a case study the city that hosted the Biennale itself: Venice. I confess that this idea was also informe by an intimate desire to finally study in a rigorous way the architecture of my hometown, from which I had moved away at age 17 to cultivate my independence. Elements of Venice was thus conceived in this context, but it soon revealed its potential in that it fostered a unique reading of the city, demonstrating how architectural elements and styles introduced in the Serenissima over the centuries were always a direct transposition, physical I would say, of political, ideological, and social shifts, and not just the result of formal decision as one might suspect. The research also revealed the metamorphic nature of the city of Venice, an avant-garde, liberal city that was a cultural epicentre for centuries, and whose urban and architectural form underwent profound transformations. An almost forensic, anatomical reading of Venice’s architecture not only allows to read the history of the republic on its stones – to reconnect to your reference of Ruskin – but above all it conveys (at least to me) a feeling of optimism that legitimizes contemporary architects to imagine a future for Venice that is beyond the image of a city-museum mostly associated with the lagoon city.
Your presence with a variety of projects at multiple editions of the Venice Architecture Biennials establishes your close connection with the Venetian institution. Is there a new presence or collaboration of yours in sight?
On the occasion of the upcoming Biennale curated by Lesley Lokko, I have been invited to contribute to a Collateral Event promoted by the New European Bauhaus (NEB). It is a two-day conference held at the IUAV University in the presence of Ursula von der Leyen, President of the European Commission. In this context, I will contribute to the panel discussion The Global Commons and Climate Change: Venice reporting from the front and lead a Radical NEB Lab
You just moved to Venice, with the whole team of UNA and UNLESS, after spending twenty-five years between London, Hong Kong, Buenos Aires, and Hamburg. Why did you decided to come back to your birth city? What role does Venice play in you existential and professional DNA? What is today your idea, your vision for a city at once entangled in its uniquely tourist dimension and the subject of a proflux of hypothetical redevelopment paper-projects?
Venice is unavoidable. If one has the fortune, as I had, to be born here and to have been educated to recognize within a painting, an architecture, or simply in a detail, the ideological, cultural and political thought of a republic that alone for centuries promoted and defended the values of justice, inclusion, freedom of speech and press that today we still sadly cannot take for granted, it is inevitable that at some point of one’s life, however nomadic one might be by nature, one feels the “call of the wild.” And the reference to Jack London’s text here is not coincidental because Venice’s uniqueness, and thus its catalytic power, is not traceable “only” to its millennia-old artifacts that embody essential ethical values, but also to its being inextricably entangled and compatible with nature, immersed as it is in the brackish waters of the lagoon since centuries. This inherent ability of Venice to coexist in the lagoon’s ecosystem without endangering its existence – with an approach that today can be found almost exclusively in indigenous settlements from which we can only learn – is something to reflect upon carefully. But this condition renders it as unique as vulnerable. Not unlike all other coastal areas of the world (from the Marshall Islands to cities like Jakarta), Venice’s future existence is threatened by anthropogenic climate change. But unlike other global coastal settlements that are in danger of being submerged by tens of meters of water (suffice it to say that a melting of Antarctica would lead to a rise in the global mean sea of 60 meters) Venice has an unparalleled media potential that we should absolutely mobilize. With this in mind, I believe that while we should certainly continue to invest (by means of strategies that include financial incentives) to attract cultural art foundations, Venice – the barometer of climate change par excellence – should become the world epicentre for studies on climate change by creating transnational infrastructures that catalyse here in the lagoon the best interdisciplinary minds in the field and global scientific data. A project of this nature, which when viewed from the European perspective is perfectly aligned with the ambitions expressed in the Green Deal, would allow Venice, historically the “Queen of the seas”, to once again be a world reference but no longer as a feared republic with aspirations of domination, rather as the “protector” of those same seas – now overheated, acidified, and with threatened biodiversity – and, the promoter of the preservation of our Blue Planet.



La svolta narrativa dell’architettura è un affare recente. A dire il vero c’era già stato qualcuno a occuparsene più o meno intorno agli anni ‘60, in un mondo perlopiù europeo, con Roland Barthes a farne persino una semiologia. Ma poi, vuoi per il rigurgitante postmodernismo dell’epica Strada Novissima alla Biennale-numero-uno (1980), vuoi per l’urgenza di far fronte a territori sempre più sul baratro di crisi incipienti, vuoi per un crescente, disincantato neo-formalismo materiale, questa idea della Narrazione in architettura si è fatta via via meno percorribile.
A me pare che la forza della Biennale di Lesley Lokko stia tutta qui: affermare che «la mostra è una storia», per poi però dire anche che la storia non è una sola, ma è «un insieme di racconti», perché – ed è qui il punto – «la storia dell’architettura è incompleta. Non sbagliata, ma incompleta». La “svolta nera” di questa mostra è sia
The breakthrough of narrative in architecture is quite a recent phenomenon. However, in the 1960’s there had already been someone dealing with it in a mostly ‘European world’, with Roland Barthes even making a semiology of it. But then this idea of narration in Architecture proved less and less feasible over time, either for the regurgitant postmodernism of the epic Strada Novissima at the Architecture Biennale-number-one (1980), or for the urgency of facing territories increasingly on the brink of incipient crises, or for a growing, disenchanted, material neo-formalism. It seems to me that the strength of Lesley Lokko’s Biennale lies all in this concept: to maintain the “exhibition as a story”, to later still affirm that “there isn’t just one story, but multiple stories”, because – and here is the point – “the history of architecture is incomplete. Not wrong, but incomplete.” The ‘Black shift’ of the current Biennale is both an exploration and a listening to voices that multiply narratives and positions, broaden horizons instead of focusing on
un’esplorazione che un ascolto: di voci che moltiplicano narrazioni e posizioni, che allargano orizzonti anziché focalizzarsi su una sola prospettiva, che fondono territori di comunanza che prevalgono su appartenenze geografiche e su egemonie culturali. Anzitutto va detto che ascoltare queste molte voci significa rivedere la nostra idea di esploratori, ribaltare Marco Polo, per così dire. Per cui invece di andare a raccontare a Kublai Khan, da viaggiatore veneziano, le città invisibili del suo impero, l’esploratore resta a Venezia e lascia che siano le città del mondo a diventare visibili e a raccontarsi a lui, ciascuna con la propria voce. Città e voci che si narrano da sé, in racconti fatti di differenze e comunanze. Prima su tutte, l’idea di Blackness. Sia che rileggiamo Gilroy o Fanon, sia che osserviamo l’African Future Institute fondato ad Accra dalla stessa Lokko – da cui arrivano anche molti practitioner, tra cui l’icona Sir David Adjaye – il “Black” emerge non come alternativa, non come rifiuto o rivendicazione, ma come un oceano comune, indifferente a etnie e nazionalismi, capace di ridefinire l’identità dell’essere donne o uomini contemporanei entro un territorio contro-geografico.
I modi di queste storie hanno in genere a che fare con un ‘progetto minore’. Ben lontani dall’idea che i practitioner siano una minoranza, giacché sono anzi attori di trasformazione collocati ben al centro del dibattito architettonico contemporaneo, va però detto che hanno un modo di costruire lo spazio che è proprio quello di cui parlava Kafka. Perlomeno quando propendeva per una letteratura minore; vale a dire quel che accade quando si prende una lingua maggiore, (la “storia incompleta” di cui sopra), per farne un “altrimenti”, un otherwise. È una “maggioranza minore”, come nel 2017 la stessa curatrice definiva la sua esperienza pedagogica alla Graduate School of Architecture di Johannesburg. E i practitioner altro non sono che “funamboli” in equilibrio tra chi sono realmente e chi altri si aspettano che essi siano, tra egemonia culturale e alterità, tra lo sguardo su se stessi e lo sguardo altrui – con il coraggio di esprimere l’autenticità della propria voce. Metafora, quella della fune tesa, che è già propria dell’architettura da tempo, complice l’importante lavoro di Léopold Lambert (fondatore e direttore della rivista «The Funambolist») che la Lokko indaga e attraversa in più passaggi. Ed è per questo funambolismo “fuggitivo”, vale a dire non staticizzato nel pubblico mainstream, che in Biennale si trovano forme narrative preconizzate: virtuali, digitali e fantascientifiche, come la magia di certa vulgata afrofuturista forse presumerebbe. Ma c’è anche l’“inatteso” espresso in modelli, sezioni, disegni (persino a mano, in modo ormai controcorrente). Installazioni in cui immergersi è necessario. Tappeti come progetti, processi e app. Sono pratiche, prima che spazi.
C’è infine una questione che riguarda il tempo, che è anche lo spazio della speranza che Lesley Lokko ci offre. Nel suggerire l’opportunità di rendere più complesso il racconto dell’architettura, questa Biennale si confronta inesorabilmente con l’urgenza della crisi climatica e con la fine della Storia. Eppure, mentre una narrazione solastalgica ci porterebbe ad esacerbare i conflitti politici e sociali della lotta contro il tempo per la salvezza dell’umanità, le molte narrazioni in mostra sembrano invece dire che il tempo è dalla nostra parte, perché affidarsi alla più giovane generazione del Pianeta per indagare il futuro significa scommettere su qualcuno che ha ancora tutto il tempo di esplorare, di fare errori, di provare e riprovare. È il “diritto all’opacità”; che è quel che protegge l’esistenza del diverso, quello in cui risiede la speranza. Perché, ci sembra dire Lesley Lokko insieme a Édouard Glissant, per vivere o per costruire un futuro con l’altro non è più necessario “comprenderlo”, ossia ridurlo al modello della mia stessa trasparenza. Ma serve, piuttosto, lasciare che racconti la propria storia e ci mostri la propria città.
a single perspective, and establish common grounds that prevail over geographical belonging and cultural hegemonies. Firstly, it should be said that listening to these multiple voices requires a re-evaluation of our concept of explorers. In a sense, it involves overturning Marco Polo. Rather than meeting the Kublai Khan, as a Venetian traveller, to tell him about the invisible cities in his empire, the explorer stays in Venice and allows the cities of the world to reveal themselves and tell their stories, each with their distinct voice. These cities and voices speak for themselves, in stories made up of both differences and common grounds. The idea of Blackness is among the foremost of these stories. Whether we revisit the works of Gilroy or Fanon or look at the African Future Institute founded in Accra by Lokko herself (the alma mater of several practitioners, including icon Sir David Adjaye) – Blackness emerges not as an alternative, nor as a denial or claim, but as a common ocean that transcends ethnic groups and nationalisms. It has the potential to redefine the identity of being contemporary women or men within a counter-geographic territory. The modes of this stories have generally to do with a ‘minor project’. Far from the idea that practitioners are a minority –they are, in fact, agents of change who are central in contemporary architectural practice – we must also add that they have a way to build space that is exactly what Kafka wrote about, at least when he postulated a minor literature, which is what happens when you take a major language (the ‘incomplete story’ mentioned above) and make an otherwise out of it.
It is a “minor majority”, as in 2017 the curator herself defined her pedagogical experience at the Graduate School of Architecture in Johannesburg. And practitioners are nothing more than ‘tightrope walkers’ balancing who they really are and who others expect them to be, between cultural hegemony and otherness, between their own vision and everyone else’s – only, summoning the courage to express their own authentic voice. A metaphor, the tightrope, that has long been associated with architecture, thanks to the remarkable work of Léopold Lambert (founder and editor-in-chief of magazine The Funambolist ), which Lokko investigates and engages with in several instances.
This ‘fugitive’ (not crystallised in the mainstream) walking on a tightrope is what turns, at the Biennale, into unconventional narrative forms, such as virtual, digital, science fiction modes, which may be regarded as an Afro-futurist vulgate. Nonetheless, the Biennale also features the unexpected, manifested through models, sections, drawings (even hand-drawn, which is now a counter-current approach). Installations that require immersion. Projects, processes, and apps. They all are practices, before being spaces. Finally, there is a question about time, which also constitutes the space of hope that Lesley Lokko presents to us. By proposing the possibility of making the story of architecture more complex, this Biennale is inevitably grappling with the urgency of the climate crisis and the notion of the end of history.
And yet, while a solastalgic narrative would lead us to exacerbate the political and social conflicts of the struggle against time for the salvation of humanity, the numerous narratives on display seem to suggest that time is on our side, since relying on the younger generation of the planet to explore the future means betting on someone who still has plenty of time to experiment, make mistakes, and try again.
The “right to opacity” is what protects the existence of the different, and it is where hope resides. What Lesley Lokko and Édouard Glissant seem to say is that to live or to build a future with others no longer requires us to “understand” them, that is, reduce them to the model of our own transparency. Instead, we need to let them tell their own story and show us their own city.
LEONE D’ORO ALLA CARRIERA


Artista, designer, scrittore, scenografo, critico e architetto nigeriano, classe 1935, Demas Nwoko è la perfetta incarnazione del “pratictioner”, definizione che Lesley Lokko introduce in questa Biennale per definire i partecipanti del suo Laboratorio del Futuro. Nwoko è una figura che si è mossa con estrema agilità tra una serie di diverse discipline creative e che per questo rappresenta l’emblema dell’architetto poliedrico. «Oggi poco più che ottantenne – spiega Lokko – “Baba” Demas appartiene ad un periodo molto particolare della storia dell’Africa Occidentale. Se fosse nato in epoca più recente molto probabilmente sarebbe stato accolto da un pubblico più vasto e il suo lavoro avrebbe suscitato un interesse molto più forte. Purtroppo, non è stato così». In un continente in cui l’architettura è spesso vista come una questione di modernizzazione e occidentalizzazione, i progetti di Demas Nwoko sono diventati un modello di sviluppo sostenibile che ha ispirato una nuova generazione di architetti e designer africani. Riguardo alla vivacità e all’unicità dell’architettura africana, Nwoko sottolinea che «la differenza tra le nostre città e quelle europee è che quest’ultime sono in qualche modo più fossilizzate. Tornare a Parigi adesso a distanza di 50 anni dalla prima volta è come se nulla fosse cambiato. Qui in Africa invece stiamo costruendo ora le nostre città, per cui abbiamo maggiori possibilità di scegliere in qualunque momento i modelli offertici dal resto del mondo». La reinterpretazione di modelli occidentali declinati in una visione non convenzionale, artistica e sostenibile si manifesta in tutta la produzione di Nwoko, e in particolare in alcuni edifici i cui progetti saranno esposti nel Padiglione Stirling ai Giardini durante la Biennale. Fra questi il New Culture Studio, un edificio contemporaneo che da galleria d’arte ha assunto la funzione di centro di formazione per le arti dello spettacolo e del design, e la Cappella del Dominican Institute di Ibadan, una costruzione realizzata con materiali locali che accosta elementi architettonici tradizionali, quali il sistema di ventilazione, con altri riguardanti l’aspetto più intimo del culto stesso. L’eredità di Demas Nwoko rappresenta nel suo complesso un’imponente testimonianza della bellezza e dell’importanza della cultura e delle tradizioni africane. Ma l’attribuzione del Leone d’Oro alla sua carriera non è dovuta solo alla volontà di aggiungere un capitolo fondamentale alla storia incompleta dell’architettura. La scelta ha anche motivazioni più personali. Dice Lokko: «Mio padre mi ripeteva sempre: “Ci reggiamo sulle spalle di qualcun altro”, vale a dire che dobbiamo essere sempre consapevoli che i nostri risultati non sono solo il frutto del nostro lavoro individuale, ma anche del lavoro di chi ci ha preceduti. Ed è così che ho pensato a lui. Per me si è trattato essenzialmente di una combinazione di due elementi: da un lato sentire la voce di mio padre e dall’altro lato vedere la poliedricità di una produzione che spazia dalla pittura al disegno, dalla costruzione di edifici alla religione, dalla tradizione culturale alla contestazione». Marisa Santin
Nigerian artist, designer, writer, set designer, critic, and architect Demas Nwoko, born in 1935, embodies the term “pratictioner” perfectly, a definition that Lesley Lokko introduces at this year’s Biennale to describe the participants in her Laboratory of the Future. “He is 80 something now – says Lokko – and he’s from a very particular period of Western African history. But for me, he is the original Renaissance architect.” In a continent where architecture is often seen as a matter of modernization and westernization, Demas Nwoko’s works have become a model of sustainable development that has inspired a new generation of African architects and designers. Regarding her choice to award Demas Nwoko with the Golden Lion for Lifetime Achievement, Lokko said: I was reminded of something that my father used to say to me: “You always stand on the back of somebody else”. So for me it was a combination of two things. On the one hand hearing my father’s voice and on the other hand seeing this body of work that moved between painting and drawing and making and building and religion and culture and protest in really interesting ways.”


«“Irth”– dichiarano le curatrici Basma e Noura Bouzo – è la traslitterazione di una parola araba che può significare tanto eredità quanto possedimento prezioso, e che racchiude il senso della nostra visione curatoriale per il Padiglione dell’Arabia Saudita. All’interno di un contesto architettonico, i materiali contengono in sé delle narrazioni che molto ci raccontano degli abitanti di un Paese o di un’area geografica e di come hanno risposto al mondo intorno a loro. Allo stesso modo, ci rendiamo conto che è in gioco un’eredità dinamica su cui è possibile costruire partendo da uno sforzo collettivo e continuo sia da parte delle istituzioni che dei professionisti locali». Il Padiglione, ideato dall’Architetto AlBara Saimaldahar, fondatore e direttore creativo dello studio di design Dahr, propone negli spazi delle Sale d’Armi dell’Arsenale una riflessione su questo concetto di “irth” inteso come ricchezza tangibile e intangibile da tramandare alle generazioni future, chiamate a formulare ipotesi e ad esporre narrazioni libere da condizionamenti culturali. Attraverso l’osservazione di diversi materiali di costruzione disposti in un ambiente dal design essenziale, il visitatore può sperimentare la visione curatoriale da molteplici prospettive ed entrare in contatto con la storia di un’area geografica e di una popolazione che si è da sempre adattata al territorio, rispettandone profondamente esigenze e peculiarità e creando soluzioni e componenti strutturali spiccatamente caratteristiche. Un viaggio interattivo nell’architettura saudita che usa la terra come punto di partenza per questa esplorazione, affiancandola alla sperimentazione con materiali organici. M.M.
ENG The Saudi project reflects on the concept of irth in its meaning of patrimony to bequeath to future generations, who will push forward their hypotheses and narratives free of cultural conditioning. By observing different construction materials in a minimalistic environment, visitors will get in touch with the story of a geographical area and a population that always resorted to adapt to territory, respecting its needs and peculiarities.
Sale d’Armi, Arsenale
Fosbury Architecture, gruppo curatoriale costituito da architetti nati tra il 1987 e il 1989, porta al Padiglione Italia all’Arsenale le istanze di una nuova generazione di progettisti “nativi sostenibili”, cresciuta e formatasi in uno scenario di crisi permanente (economica, ambientale, scarsità di risorse e di opportunità). Spaziale. Ognuno appartiene a tutti gli altri nasce da questi presupposti e si fonda sulla nozione espansa del campo dell’architettura come pratica di ricerca multidisciplinare al di là dei manufatti e della progettazione, risultato di un lavoro collettivo e collaborativo, che supera l’idea dell’architetto-autore per intervenire nello spazio operando su quel tessuto di relazioni tra persone e luoghi che è alla base di ogni progetto. In questa visione, lo spazio è inteso come luogo fisico e simbolico, area geografica e dimensione astratta, sistema di riferimenti conosciuti e territorio di possibilità. Fosbury Architecture ha individuato e invitato a collaborare nove pratiche spaziali – nove gruppi di progettisti under 40 rappresentativi di ricerche originali, attivi in Italia e all’estero –, chiamate a sviluppare altrettanti progetti pionieri per il Padiglione Italia. Le nove stazioni sono siti rappresentativi di condizioni di fragilità o trasformazione del nostro Paese, nelle quali ciascun gruppo transdisciplinare è stato chiamato a intervenire, collaborando con una serie di incubatori – attori locali come musei, associazioni, festival culturali – con l’obiettivo di radicare ciascun progetto nel territorio di riferimento. In questo modo le nove stazioni vanno a configurare le tappe di un’inedita geografia, diventando mete simboliche di un rinnovato Viaggio in Italia M.M.
ITALIA
SPAZIALE: Ognuno appartiene a tutti gli altri Tese delle Vergini, Arsenale www.fosburyarchitecture.com

The project is based on the vision that architecture is a research practice beyond the construction of buildings and that design is always the result of collective and collaborative work that goes beyond the idea of the architect-author. According to this vision, space is understood as a physical and symbolic place, a geographical area and abstract dimension, a system of known references and a territory of possibilities. Fosbury Architecture identified and invited nine spatial practices to collaborate, designers – Italian architects or groups, aged under 40, representative of original research, active in Italy and abroad – called upon to develop nine pioneering projects for the Pavilion. Nine stations were then pinpointed, sites that are representative of situations of fragility or in transformation in our country, where each transdisciplinary group was called upon to intervene. Each design group has collaborated with a series of incubators – local actors such as museums, associations, and cultural festivals – with the aim of rooting each project in its territory of reference. In this way, the nine projects shape the stages of a new geography, becoming symbolic destinations of a renewed Italian Journey.
Che cosa significa “rinnovamento” nel contesto culturale cinese? È uno stato d’animo. Il cambiamento è costante. La stessa tradizione culturale determina questa disposizione verso la continuità sostenendo il “mutamento all’interno dell’immutato”. Attraverso il prisma del cambiamento avvenuto nel mondo costruito negli ultimi 40 anni, il Padiglione cinese racconta il rinnovamento simbiotico della Cina tra vita, architettura, città e natura. Percorrendo gli spazi cosiddetti di “visione”, “scoperta”, “contemplazione” i visitatori possono cercare risposte ai problemi del nostro tempo e immaginare il futuro. Un colonnato formato da più di 50 enormi colonne, che occupano completamente e scenograficamente il Magazzino delle Vergini all’Arsenale, accoglie la narrazione del rinnovamento civile cinese attraverso tre diversi approfondimenti: LIVEABILITY_wonder: Portraits of Plurality (Meraviglia della vivibilità: Ritratti di Pluralità) analizza come l’alta concentrazione di persone diverse stimola a ripensare una formula dell’abitare ultra dinamico, i rapporti sociali quotidiani e la vita culturale delle metropoli, mentre la simbiosi tra persone e natura crea una reimmaginazione della vita rurale, rimodellando il senso di “casa”. LIVEABILITY_renewal: Stories of Shanghai (Rinnovo della vivibilità: Storie di Shanghai) pone Shanghai, “metropoli fantastica”, una delle città più densamente popolate della Cina moderna, dove la vivibilità emerge miracolosamente dall’urbanistica quotidiana e dove fiorisce la diversità, al centro della riflessione. SYMBIOSIS_ future: Rejuvenation (Simbiosi - Futuro: Ringiovanimento) sposta l’interesse sul futuro di ringiovanimento ecologico. Con l’innovazione tecnologica nel campo dell’energia pulita, delle auto e delle città elettriche, della realtà virtuale e altro ancora, i cambiamenti nell’ambiente costruito potrebbero risuonare con un’ecologia urbana ringiovanita nelle città post-industriali, portando a un equilibrio simbiotico tra città e natura.

Il rinnovamento diventa un enigma architettonico.
ENG What does ‘renewal’ mean in the Chinese cultural context? It is a state of mind. Change is constant, and Chinese cultural tra- dition itself determines its continuousness in the doctrine of ‘change within the unchanged’. Under the point of view of what has changed in architecture over the last forty years, the Pavilion shows the peculiar symbiotic renewal of China of life, architecture, city, and nature. Through the ‘viewing’, ‘unfolding’, and ‘contem- plating’ of the Pavilion, visitors may use to find answers to modern problems and to imagine the future. Renewal is an architectural enigma.

La Partecipazione nazionale dell’Estonia stravolge i consueti canoni espositivi della Biennale svolgendosi all’interno di un vero appartamento veneziano, in Salizada Streta 96, vicino all’uscita e seconda entrata dell’Arsenale – Giardino delle Vergini.
La mostra, a cura di Aet Ader, Arvi Anderson, Mari Möldre (b210 Architects), ha come titolo Home Stage e intende esplorare la contraddizione insita nello spazio abitabile inteso come casa e come valore economico di scambio. Diversi performer estoni si alterneranno, vivendo per un mese nell’appartamento. Lo spazio diventa così sia casa che palcoscenico. «Il Padiglione prende vita in una durational performance, in cui le ordinarie mansioni domestiche e le discussioni, sia sceneggiate che non, hanno luogo sotto gli occhi del pubblico». Vengono fatte emergere situazioni domestiche quasi grottesche, dove i sogni si scontrano con la realtà, i proprietari con gli inquilini, i venditori con gli acquirenti, l’intimità con l’alienazione. Ogni performance, della durata di un’ora e mezza, si tiene nell’arco della giornata, mattina e pomeriggio, nelle diverse stanze dell’appartamento. Alcune situazioni vedranno coinvolti i visitatori, altre li spingeranno a godersi il riposo e gli ambienti domestici. F.M.

ENG With their presence, visitors will involuntarily turn into a nosy neighbour and, at the same time, into an explorer of architecture. All action takes place within a real apartment. Each room is the set for domestic situations that border the grotesque, shown as ninety-minute performances throughout the day. We will see episodes where dreams clash with reality, tenants with landlords, sellers with buyers, homely intimacy with alienation. Only one door is shut, and will be open according to the whim of a performer…
«Guardando al futuro – ha dichiarato Gayane Umerova, Direttore Esecutivo della Art and Culture Development Foundation (ACDF) del Gabinetto dei Ministri della Repubblica dell’Uzbekistan –, il nostro antico patrimonio può aiutarci a riconsiderare il cammino dell’umanità e il ruolo che l’architettura svolge nel modellare il destino collettivo. Analizzando i resti architettonici delle società del passato, possiamo comprendere i valori, le credenze e le tecniche che hanno plasmato i loro mondi. Tutto questo, a sua volta, può influenzare le nostre scelte progettuali e i nostri processi decisionali, mentre lavoriamo per costruire un futuro migliore».
La Repubblica dell’Uzbekistan partecipa alla Biennale Architettura con il progetto Unbuild Together: Archaism vs. Modernity, curato dallo studio KO, basato a Parigi e Marrakech, che si occupa di architetture pubbliche e residenziali contemporanee in tutto il mondo, ispirandosi significativamente all’intelligenza dei luoghi.

Il punto nodale nell’indagine del Padiglione è dato dai differenti orizzonti del patrimonio architettonico che divengono utili strumenti per immaginare il futuro, sfidando il concetto di modernità. Al centro di tutto il mattone, prendendo le mosse dalle rovine delle Qalas, antiche fortezze della regione di Karakalpakstan, patrimonio della civiltà di Khorezm.
La terra offre questo materiale di costruzione universale, il cui utilizzo affonda nella notte dei tempi. «I mattoni tradizionali uzbeki, realizzati con tecniche in uso da secoli, sono duraturi, sostenibili ed esteticamente belli. Prodotti con materiali naturali, sono ancora resistenti e in grado di durare millenni, caratteristica che li rende un’ottima scelta per progetti di opere edilizie pensate per resistere al trascorrere del tempo» (Gayane Umerova). Alcuni mattoni nell’ambito dell’installazione sono smaltati dell’artista e ceramista uzbeko Abdulvahid Bukhoriy, uno degli ultimi depositari della tecnica di lavorazione ceramica Blue Bukhara. F.M.
ENG In the Uzbek project, the brick is shown as the fundamental element of local architecture, taking inspiration in its usage as seen in the ruins of the Qalas, ancient fortresses in the Karakalpakstan region. This study focuses on the materiality of bricks – earth, clay – to reinterpret more generally the several ways this elemental architectural component comes to be, as well as the building techniques and finishes it is used in. On exhibition, some pieces enamelled by Uzbek ceramic artist Abdulvahid Bukhoriy, one of the few remaining craftsmen who excels in the blue Bukhara technique.
Repubblica dell’UZBEKISTAN
Unbuild Together: Archaism vs. Modernity Tese Cinquecentesche, Arsenale www.instagram.com/uzbekistan_national_pavilion
Kuwait City – dall’arabo “kut” che significa “forte”, ovvero il fortino costruito con mura di fango nel 1612 dalla tribù dei Banu Khaled – era un tempo un insieme di strutture organicamente aggregate e intrecciate con varie forme di apertura. Le case a corte, tipiche delle architetture del Medio Oriente, erano collegate da una rete di percorsi con passaggi pubblici che ne interrompevano la densità, creando spazi di scambio culturale, politico ed economico. Un tempo fulcro di numerosi aspetti della vita civile e sociale kuwaitiana, l’antica città fortificata dalla fine degli anni Cinquanta è stata in gran parte sradicata per far posto alla modernizzazione: appartamenti di lusso, autostrade, sofisticati centri finanziari ed eleganti parchi. Ne nasce un nuovo paesaggio di strutture moderne, dissociate dalla tradizione e progettate da importanti studi di architettura internazionali e regionali dell’epoca.
«Recupera, rivisita, ripensa la Storia» è l’imperativo del Padiglione del Kuwait. Nella filosofia collettiva kuwaitiana, anziché un segmento lineare di tempo, la Storia è considerata come una spirale, nella quale ricercare nel passato quei momenti che possano informare lo sviluppo futuro, altrimenti disgiunto in un flusso di lavoro lineare convenzionale.
Rethinking Rethinking Kuwait, servendosi di Kuwait City come prototipo, investiga i nuovi metodi di progettazione architettonica e urbana che emergono dalle intersezioni di spazio e tempo, con particolare riferimento ai mezzi di trasporto e all’accessibilità. Il titolo della mostra riflette il ripensamento come sforzo per decolonizzare e decarbonizzare l’architettura: “ripensare il ripensamento” significa infatti rivalutare i processi esistenti, andando oltre i principi e i valori colonialisti che tipicamente guidano lo sviluppo dei progetti architettonici. L’approccio esamina le convenzioni e i precedenti, lasciando spazio alle spinte locali per generare un nuovo processo. L’obiettivo è migliorare la dimensione umana della città, valorizzando gli spazi urbani di transizione e interstiziali e privilegiando il trasporto di massa rispetto alle singole modalità di spostamento veicolare. C.S.

ENG To recover, revisit, rethink Kuwait – by analysing instances of decolonization and decarbonization, Rethinking Rethinking Kuwait investigates new ways to design architecture and cities, with particular attention on transit and accessibility. Taking Kuwait City as a prototype, studies on different scales and scopes explore transition spaces within the city, trying to limit the effect of the modernist urbanism that is responsible for the disappearance of a large part of the architectural heritage in the country. The exhibition looks at history not as a linear segment, but as a spiral, looking into the past for moments that can influence the future.
La Partecipazione della Finlandia con il progetto Huussi – Imagining the future history of sanitation, realizzato dal gruppo The Dry Collective, dimostra di essere tra le nazioni capofila verso i temi ambientali.

L’huussi – una tradizionale toilette compostante comunemente usata dai finlandesi, specie negli ambienti rurali – viene utilizzata come punto di partenza per la discussione sul tema del trattamento delle acque reflue. Ad accogliere i visitatori all’esterno del Padiglione progettato da Alvar Aalto l’installazione raffigurante lo “scavo archeologico” di un water con sciacquone. All’interno un immaginario documentario ambientato nel futuro, anno 2043 con il racconto dell’evoluzione dei servizi igienici. Con sottile ironia la mostra riporta l’assurdità del nostro attuale uso di acqua e fertilizzanti.
«Il mondo non può più permettersi di continuare a sprecare la scarsa acqua potabile, a inquinare fiumi e oceani con rifiuti a rischio biologico e a continuare a produrre fertilizzanti artificiali estrattivi che inondano l’ecosistema di azoto e fosforo. La toilette compostabile finlandese è un buon punto di partenza per la discussione sulla necessità di un cambiamento» (The Dry Collective). F.M. ENG
To proclaim the end of the toilet flusher, The Dry Collective produced a mockumentary set in the not-too-distant future (2043), when toilets will look quite different. At the centre of the Pavilion is a huussi, the traditional Finnish composting toilet, surrounded by plants growing on human waste-fed compost. The Finnish project challenges us to develop new solutions in terms of sanitation, using irony to present the absurdity of the current use of water and fertilisers.
18 maggio - 26 novembre 2023
Mostra a cura di | Exhibition curated by AMDL CIRCLE e Michele De Lucchi
Esposizione dei 10 progetti finalisti del Concorso Internazionale per l’Architettura d’Ingresso DoorScape Exhibition of the 10 finalist projects of the Entrance Architecture International Contest DoorScape


Seconda partecipazione alla Biennale Architettura per la Santa Sede, che con il titolo Amicizia Sociale: incontrarsi nel giardino presenta il suo Padiglione sull’Isola di San Giorgio e precisamente negli spazi del giardino e dell’Abbazia di San Giorgio Maggiore.
A fare da guida ideale e spirituale dell’intero percorso espositivo sono le parole di Papa Francesco tratte dalle encicliche Laudato si’ (2015) e Fratelli tutti (2020).
Protagonista del Padiglione è l’architetto portoghese Álvaro Siza, già Leone d’Oro alla carriera nel 2012, che insieme al collettivo italiano Studio Albori (Emanuele Almagioni, Giacomo Borella, Francesca Riva), ha creato all’interno delle sale espositive alcune installazioni site-specific. Il cardinale José Tolentino de Mendonça, prefetto del Dicastero per la Cultura e l’Educazione e commissario del Padiglione, afferma: «All’età di novant’anni Siza si presenta come una riserva di giovinezza per il mondo, egli scommette su un’architettura che non si fissa tra quattro mura, ma si disloca. È un’architettura viva, figurale, ‘in uscita’. Un intenso manifesto politico e poetico su cosa sia o possa diventare l’incontro tra gli esseri umani».
La prima parte del percorso si sviluppa all’interno del Monastero benedettino, accedendovi direttamente dalla Darsena Grande. La seconda parte si apre nel giardino dell’Abbazia e propone l’orto come modello del rapporto con il Creato. Si tratta di una pratica frugale e modesta, ma soprattutto di un omaggio all’enciclica Laudato si’, alla quale Studio Albori si è ispirato per realizzare la nuova conformazione. Si cammina tra orti, pollaio, deposito semi e zone di riposo, in una pratica di riconoscimento e contemplazione. Tutto il legno utilizzato vive una seconda vita, come la seconda occasione che si vuole dare ai luoghi, alle culture e agli esseri viventi. F.M.

ENG The Benedictine monastery in San Giorgio Island, lying in front of Piazza San Marco across a short stretch of water, is the stage of the Holy See’s Biennale participation. The protagonist of the exhibition is the intervention by Portuguese architect Álvaro Siza which accompanies visitors onto the garden, the place of contemplation.
The orchard is a model of our relationship with God’s creation, a representation apparently frugal and modest, though in fact revealing an homage to Pope Francis’ encyclical Laudato si’, a source of inspiration for the project carried out in the abbey’s garden. This living, figural, outpouring architecture represents a strong political and poetic message on what is, or what could be, the encounter among human beings.
Da Paese con “quattro mucche per abitante”, l’Uruguay sta vivendo un cambiamento epocale, con l’esportazione di cellulosa che nel 2023 supererà quella di carne per la prima volta, salendo in testa alle vendite all’estero. Partendo da questa notizia, il Padiglione racconta un Paese che dall’approvazione della Legge Forestale, nel 1987, ha visto crescere la superficie boschiva di oltre 30 volte, un’espansione destinata ad ampliarsi nel prossimo futuro con la destinazione alla silvicoltura di ben quattro milioni di ettari di terreno. Una situazione che porta dunque alla ribalta il Diritto Forestale come ecosistema in fase di realizzazione, in grado di aprire un dialogo tra diverse territorialità e spazialità, rendendo possibili scenari che immaginano l’Uruguay come laboratorio equo e inclusivo per il futuro del legno. Nel Padiglione, trasformato in una insolita sala teatro, l’avatar di una giovane Legge Forestale ansiosa di essere rispettata si guarda allo specchio, dialogando con immagini e irruzioni musicali, che introducono le visioni di una nuova generazione di artisti afrouruguaiani. C.S.
ENG Long gone are the days of Uruguay as the ‘four-cows-per-person’ country. In 2023, cellulose exports are predicted to surpass meat for the first time in the country’s history. At the Biennale, Uruguay tells the story of its forests, thirty times larger than they used to be in 1987, when specific legislation was enacted. This goes to show how forestry law is an ecosystem in itself, and can engender dialogue between different spaces and territories, thus making Uruguay an equitable, inclusive laboratory for the future of wood. Young African-Uruguayan artists give their interpretation of the topic.
URUGUAY In Opera. Future Scenarios of a Young Forest Law Giardini
 Gerber Architekten
Gerber Architekten
A variety of interrelationships have always existed between architecture and outdoor space. There is no boundary between inside and outside when architecture is not seen as a rigid structure, but open and flowing as a whole with landscape and urban space. This close connection between open space and the built environment creates a kind of symbiosis to form an interwoven unity, a landscape image. www.gerberarchitekten.de
A wide range of art forms and media including paintings, photography, mapping, and architectural models showcase the diversity of Palestinian artistic production as well as its many influences. The overriding theme is the issue of temporality: how the artworks deal with the past, present, and future of Palestine. Overall, these works offer us an understanding of the state of contemporary Palestinian art and culture. www.palestinemuseum.us
Natural and manmade disasters create a continuous exodus of people seeking instant shelter. Traditionally tents or variations on them are the primary response, offering scant protection from the elements. How can we do better? In partnership with Holcim, Norman Foster Foundation designed essential housing to provide safety, comfort and wellbeing for displaced communities. Holcim built the project with a range of low-carbon, energy-efficient and circular solutions to make sustainable building accessible to all.
A real-size prototype will be displayed in the Marinaressa Gardens, supported by an exhibition hosted in Palazzo Mora.
www.normanfosterfoundation.org
www.holcim.com
La sesta edizione di Time Space Existence, ampia e composita mostra collettiva, affronta i temi dell’abitare su diversa scala – casa, ambiente naturale e sociale, Pianeta –, posti al centro di una progettualità comune per trovare nuove vie sostenibili da seguire e sviluppare. I 217 progetti internazionali presentati nelle tre sedi dell’European Cultural Centre, Palazzo Bembo, Palazzo Mora e Giardini della Marinaressa, disegnano una mappa delle proposte più innovative ed espressioni emergenti nell’ambito della sostenibilità nelle sue molteplici forme e declinazioni, che vanno dall’attenzione all’ambiente e al paesaggio urbano, con metodi di costruzione e materiali che riducono il consumo energetico, alle proposte in discussione su innovazione, riuso, design circolare, comunità e convivenza, giustizia sociale e inclusione. Architetti, designer, ricercatori, accademici, creativi, fotografi, provenienti da 52 Paesi e che lavorano in diverse discipline, offrono un dialogo coinvolgente che restituisce voci e prospettive differenti ad ampio spettro, focalizzando l’attenzione internazionale sulle questioni fondamentali dell’architettura contemporanea.
ENG The sixth edition of large collective exhibition Time Space Existence deals with the theme of living on different scales – home, natural and social environment, planet – set at the centre of communal planning to identify new sustainable approaches to follow and develop. The 217 international projects presented in the three locations of the European Cultural Centre, Palazzo Bembo, Palazzo Mora and the Giardini della Marinaressa constitute a map of the most innovative proposals and emerging concepts in the field of sustainability in its multiple forms, ranging from attention to the environment and the urban landscape through construction methods and materials that reduce energy consumption to proposals regarding innovation, reuse, circular design, community and coexistence, social justice and inclusion. Architects, designers, researchers, academics, creatives and photographers from 52 countries and working in various disciplines offer an engaging dialogue that foregrounds alternative voices and perspectives across a broad spectrum, focusing international attention on the fundamental issues of contemporary architecture.
European Cultural Centre
Time Space Existence
20 maggio-26 novembre
Palazzo Bembo, Riva del Carbon, San Marco 4793 Palazzo Mora, Strada Nuova, Cannaregio 3659 Giardini della Marinaressa, Riva dei Sette Martiri, Castello www.timespaceexistence.com

Umbau, dal tedesco “conversione”, rimanda all’idea di una continua trasformazione delle strutture esistenti. Considerando gli attuali obiettivi climatici, questa sostenibile pratica architettonica progressivamente passerà nei prossimi anni dalla sua attuale condizione di eccezione allo status obbligato di regola. La mostra Umbau. Nonstop Transformation, curata da von Gerkan, Marg and Partners Architects (gmp), tratta recenti casi studio relativi a pratiche di conversione del XXI secolo che si occupano del patrimonio architettonico del Movimento Moderno. Ciò che accomuna i progetti è un approccio concettuale alla conversione/ Umbau che, partendo da un inventario completo dell’esistente, continua e sviluppa il preesistente come un’evoluzione architettonica. L’Umbau non è un’azione unica, si muove incessantemente verso il futuro in una Nonstop Transformation, in una logica di collaborazione che coinvolge le diverse generazioni, legando il passato al futuro. La conversione fa parte della pratica di gmp Architects da oltre quarant’anni. Sette dei sessanta progetti portati avanti negli anni da gmp Architects sono ora presentati nella mostra realizzata in occasione della Biennale, che ripercorre i processi della continua trasformazione degli edifici dall’originale all’Umbau. Gli edifici analizzati – progetti completati, in costruzione e in fase di progettazione – sono esempi di architetture del XX secolo presenti in Germania oggetto di conversione, quali la Biblioteca di Stato al Kulturforum di Berlino (1978), lo Stadio Olimpico di Berlino (1936), il Kulturpalast di Dresda (1969), costruzioni di gusci di cemento come l’Hyparschale di Magdeburgo (1969) e l’Alster-Schwimmhalle di Amburgo (1973). Altri esempi testimoniano processi di trasformazione industriale come la più grande fabbrica di acciaio inossidabile di Shanghai in Cina (1986) diventata l’Accademia di Belle Arti e la conversione di un ex edificio di trasformatori a Monaco (1929) nell’Isarphilharmonie al Gasteig HP8.
ENG Umbau (german for “conversion”) means the continuous transformation of existing structures. Considering today’s climate goals, Umbau will move from being the exception to becoming the rule. The exhibition by von Gerkan, Marg and Partners Architects (gmp) discusses recent case studies of conversion practices from the 21st century dealing with the architectural heritage of the Moderne movement. What the projects have in common is a conceptual approach to Umbau, which, starting from a comprehensive inventory of the existing, continues and develops the old as an architectural evolution. Umbau is not unique, but continues into the future as a Nonstop Transformation, as a collaboration spanning generations.
La costruzione di una identità nazionale per uno Stato passa attraverso la sua storia, la sua cultura e soprattutto la sua idea di futuro. Building a Creative Nation è una mostra che offre l’anteprima internazionale della prossima generazione di istituzioni culturali del Qatar.
Qatar Creates, ente nazionale per la promozione culturale, ha affidato allo studio newyorkese 2x4 la realizzazione dell’esposizione a Palazzo Franchetti, ponendo l’accento su cinque nuovi spazi culturali concepiti per il Qatar da studi di architettura di fama internazionale quali: ELEMENTAL, Herzog & de Meuron, OMA, Philippe Starck e UNStudio. Rendering, fotografie, bozzetti, studi preparatori, maquette, video e contenuti immersivi restituiscono ciascun progetto architettonico come una risposta ragionata all’impegno del Qatar per la creazione di una identità nazionale che favorisca, attraverso gli investimenti nelle industrie creative, lo sviluppo di una società innovativa e plurale.
Diretto da Alejandro Aravena, ELEMENTAL S.A. è chiamato a realizzare l’Art Mill Museum, museo del Qatar di arte moderna e internazionale e arte contemporanea, che sarà inaugurato nel 2030. Herzog & de Meuron hanno ideato il progetto per il Lusail Museum, un nuovo spazio culturale i cui lavori prenderanno avvio nel 2023 sull’isola di Al Maha a Lusail, appena a nord di Doha. Office for Metropolitan Architecture (OMA) di Rem Koolhaas e Samir Bantal realizzerà il Qatar Auto Museum, non solo un contenitore dove esporre auto da collezione anzi, concepito alla fine dell’era del petrolio, sarà un hub tecnologico dedicato al design, alla ricerca, all’ispirazione e all’innovazione delle


nuove forme di mobilità. Philippe Starck ha ridisegnato il Qatar Preparatory School, attualmente in fase di sviluppo a Doha, la prima scuola professionale a disposizione delle industrie creative del Paese, un campus sostenibile e interattivo. UNStudio sta realizzando il progetto del Dadu Children’s Museum of Qatar, un luogo unico per l’apprendimento e la crescita attraverso il gioco inclusivo, votato all’esplorazione e alla sperimentazione.

ENG The building of national identity, for a country, is a matter of history, culture, and, above all, its idea of future. Building a Creative Nation is an exhibition that anticipates the next generation of Qatari cultural institutions. Qatar Creates, the national office for cultural promotion, entrusted New York-based 2x4 studio the production of the exhibition, which will highlight five upcoming projects of modern museums to be built in the Gulf country. Renderings, photographs, sketches, designs, maquettes, videos, and AR content will display each piece of future architecture and Qatar’s commitment to the creation of a national identity that supports innovation and creativity.
Il progetto espositivo DNA Ucraino si concentra sulla ricerca del genius loci della cultura e del territorio ucraino al fine di delineare un futuro programma di ricostruzione dei territori distrutti dal conflitto in corso, capace di conservare le caratteristiche identitarie della Nazione, una sintesi culturale che includa architettura, artigianato tradizionale, storia, musica, arte e vita vissuta. Il Paese è al momento un “laboratorio tragico e pericoloso”, un campo di battaglia per la società del futuro. Gli ucraini sono uniti dalla volontà di essere liberi, legati ai loro antenati e alle generazioni future dalle sottili radici dell’identità. Nella Sala del camino dell’ex Convento di Cosma e Damiano alla Giudecca le opere in mostra sono un racconto per immagini che crea la scenografia dello spazio, protagonista dal 18 maggio al 20 giugno di incontri e dialoghi tra artisti, curatori, storici e architetti ucraini, italiani e internazionali. L’allestimento è stato realizzato grazie al lavoro curatoriale di Design4Ukraine e alla collaborazione tra le artiste Darya Alyoshkina, Diana Bilchenko, Ornella Ostapenko. Lace of Centuries è una serie di 12 grandi pannelli di carta di Vytynanka, che ospitano le opere realizzate con le radici del grano denominate “rizome”, icone grafiche basate sulla storia dell’Ucraina. Olga Neshta, architetto e storica dell’architettura, ha lavorato sull’identità ucraina a partire dall’epoca bizantina, con i valori e i codici che questo incontro ha portato all’evoluzione del costruire chiese e più in generale per la storia dell’arte in Ucraina. La mostra si conclude con Humanless, anatomia di un tavolo di Nùevù Studio e con Qui e Ora / “ ТУТ ” /, un breve ma significativo video che raccoglie le voci degli architetti ucraini.

L’iniziativa è promossa da Foundation of Ukrainian Architectural Chamber e Design4Ukraine Association, con il sostegno di National Union of Architects of Ukraine e di Roberto Bianconi.
ENG The exhibition project focuses on the search for the genius loci of Ukrainian culture and territory in order to outline a future recon- struction program for those territories levelled by the ongoing conflict capable of preserving the nation’s characteristic identity. The country is currently a “tragic and dangerous workshop”, a battlefield for the society of the future. Ukrainians are united by their desire to be free and are linked to their ancestors and future generations by the subtle roots of identity. The project envisages the creation of a cooperation platform between Ukrainian and Italian architects for the development of new architectures conceived and designed by focusing on the pri- orities of the community’s experience.
Il coraggio del futuro
Una prospettiva rovesciata, non utopica, ma futuristica, che ricerca – e trova – la via per la rinascita di Venezia nella sua parte sommersa, nell’acqua e nella Laguna, riuscendo a restituire attraverso uno sguardo assolutamente lucido, aperto e libero da pregiudizi e condizionamenti un futuro possibile per la città. Un gruppo di giovani ricercatori internazionali in residenza a Fabrica Research Centre approda al Complesso dell’Ospedaletto con una live-exhibition, un interessante laboratorio di ricerca eco-critica sulla città lagunare e il suo complesso ecosistema, curata dall’artista visivo e regista Carlos Casas, program director di Fabrica. Il laboratorio multimediale esplora futuri alternativi già presenti in Laguna e propone una riflessione su ecologie di coesistenza locali in un’epoca segnata da crisi politiche, economiche e ambientali a livello globale. Asuka Akagawa (1998, Giappone), artista interdisciplinare, compositore, chitarrista e ricercatore, attraverso l’installazione sonora No, amaro è il tormento porta in superficie le preoccupazioni legate all’inquinamento della Laguna. Grazie ad un sistema sonoro quadrifonico, l’installazione cerca di esprimere metaforicamente l’inquinamento fisico e sonoro causato dalle attività antropiche nell’ecosistema lagunare. Il processo si sviluppa attraverso la registrazione del suono subacqueo mediante un idrofono e lo sviluppo di un algoritmo generativo che utilizza i dati sul traffico dei motoscafi. Riccardo Androni (1996, Italia) ha studiato fotografia alla LA BA, a Firenze e frequentato un master di I livello in MOV IES - Moving Images Arts allo IUAV a Venezia. Attualmente è iscritto a Scuola Cònia. In ( spazi esclusi ), questo il titolo del suo progetto, la materia definisce sé stessa attraverso un processo di autorivelazione e manifestazione, creando sinestesie lagunari. Giorgia Burzio (1995, Italia) è una designer e ricercatrice. Attualmente lavora come Research Fellow presso il Dipartimento di Design del Politecnico di Milano. Ha conseguito un Master in Design
presso la Konstfack University of Arts (Svezia) e collabora con FAYD, una piattaforma editoriale digitale. Gardenotopia propone una visione multisensoriale e speculativa di un rapporto ecologico VeneziaLaguna più equilibrato. In un futuro ipotetico, possibile (o un presente alternativo?), le piante e gli organismi che prosperano in laguna danno vita a nuovi immaginari di adattamento alla esasperante profezia: Venezia affonderà? Stefano Dealessandri (1998, Italia) ha studiato presso l’HAW Hamburg specializzandosi in New Media (Prof. Aram Bartholl) e alla Bezalel Academy of Arts and Design di Gerusalemme. L’installazione/videogame eco-critica e multimediale J’adore Venise indaga l’intersezione tra iperturismo, capitalismo di sorveglianza e simulazioni, concentrandosi sulla complessa socio-ecosfera di Venezia. Cosa succede quando il turismo diventa il narratore principale?

Venezia Fabrica Futura è uno spin off del centro di ricerca di ispirazione rinascimentale con un approccio che si basa sull’imparare facendo del Gruppo Benetton, situato a Villorba, a 30 chilometri da Venezia, in una villa del Settecento restaurata e “ridefinita” dall’architetto giapponese Tadao Ando. Ogni semestre circa 20 talenti creativi under 25 vengono selezionati da tutto il mondo per sperimentare su un tema specifico, attraverso una costante contaminazione tra discipline. L’obiettivo? Promuovere il cambiamento attraverso un approccio interculturale.
ENG Fabrica Research Centre brings to Venice an eco-critical research laboratory concerning the city and its complex ecosystem. The laboratory explores alternative futures already present in the lagoon and promotes reflection on local ecologies of co-existence in an era marked by global political, economic and environmental crises. A group of young international researchers in residence at Fabrica propose multimedia research projects, including interactive video games, bio-fabrications using mussels from the lagoon, experiential tastings, experimental herbariums dedicated to underwater flora and aural re-elaborations of wave motion and pollution data from Venetian canals.

Una casa aperta alle comunità, dove la storia aiuta a leggere il presente e offre strumenti per entrare nel futuro. A house open to communities, where history helps read the present and offers tools to step into the future.


Un’originale retrospettiva dedicata all’innovativo architetto giapponese e ai suoi progetti realizzati in tutto il mondo: è la mostra Kengo Kuma. Onomatopeia Architecture, curata da Chizuko Kawarada e Roberta Perazzini Calarota a Palazzo Franchetti. Partendo dall’onomatopea, che è l’atto di creare o usare parole che includono suoni simili ai rumori ai quali si riferiscono, Kengo Kuma dà forma a una sensazione fisica che esprime la sua idea di architettura sostenibile, dove i materiali sono di recupero e le persone e le cose si ricongiungono. Riscoprendo le tradizioni giapponesi e i suoi materiali più utilizzati – legno, carta e metallo – l’architetto decide di reimpiegarli in modo più contemporaneo. Nella sua visione, le superfici non coinvolgono solamente la vista, ma anche i sensi di olfatto e tatto. Attraverso l’esposizione di 22 maquette dei suoi edifici più celebri e di un’installazione alta oltre 5 metri in alluminio nel giardino esterno, i visitatori sono incoraggiati a scoprire i suoni dei diversi materiali.
«A Palazzo Franchetti – racconta Kengo Kuma – vorrei mostrare come io creo il dialogo con i materiali. In questo dialogo non faccio quasi mai uso di un linguaggio influenzato dalla logica. E quando lo uso, è impossibile farmi capire. Ecco perché uso sempre l’Onomatopea. La materia e il corpo parlano tra loro e risuonano quando usano questo linguaggio primitivo».
Gli edifici progettati da Kuma, divenuti iconici, hanno spesso una leggerezza inaspettata o un tipo di movimento che lui stesso attribuisce al suo processo di concetto musicale. Evitando il più possibile l’utilizzo del cemento, realizza opere che sembrano posarsi delicatamente sul terreno, talvolta sembrando evanescenti o addirittura ambigue. Il suo approccio progettuale si ispira spesso al passato, perché è nel passato che si nascondono gli indizi per costruire un futuro migliore.
ENG An original retrospective on Kengo Kuma – Kengo Kuma. Onomatopeia

Architecture shows projects the innovative Japanese architect built around the world. Onomatopoiea means to make a word that sounds like what it means. Kuma shapes physical feelings that is the expression of sustainable architecture, making use of recycled materials (mostly lumber, paper, and metal). His icononic designs are unexpectedly light, and follow a kind of motion that is almost musical. Avoiding the use of cement as much as possible, these buildings seem to tread lightly on the ground. In his words: «In this exhibition at Palazzo Franchetti in Venice, I would like to show how I create a dialogue with materials. In this dialogue, I don’t often use a language influenced by logic. And when I use it, it is impossible to make people understand me. That is why always use Onomatopoeia. The material and the body are talking to each other, and they resonate when using this primal language».
Kengo
14 maggio-26 novembre ACP | Palazzo Franchetti, Campo Santo Stefano, San Marco 2842 www.acp-palazzofranchetti.com
Una mostra collettiva pensata per raccontare la relazione tra spiritualità e natura: un percorso espositivo che nasce dall’esperienza del suo curatore, Marco Delogu, alle Vatican Chapels nel Bosco dell’Isola di San Giorgio. Un luogo verde e silenzioso nella laguna, tra acqua, cielo e terra, ideale per condurre alla riflessione e all’esperienza spirituale. Per raccontare questo viaggio introspettivo sono stati riuniti i lavori di dieci grandi nomi della fotografia mondiale – Don McCullin, Tim Davis, Marco Delogu, Graciela Iturbide, Sally Mann, Martin Parr, Annie Ratti, Guy Tillim, Paolo Ventura, Francesca Woodman – ciascuno posto in relazione con le architetture di una cappella. Prima Partecipazione Nazionale della Santa Sede alla Biennale Architettura 2018, le Vatican Chapels sono state progettate da architetti di fama mondiale come Andrew Berman, Francesco Cellini, Javier Corvalan, Eva Prats e Ricardo Flores, Norman Foster, Teronobu Fujimori, Sean Godsell, Carla Juacaba, Smiljan Radic, Eduardo Souto de Moura, Francesco Magnani e Traudy Pelzel, restituendo un repertorio contemporaneo di indagine sui luoghi della spiritualità. Il progetto delle Vatican Chapels, curato da Francesco Dal Co, è stato ispirato alla Cappella del Bosco di Gunnar Asplund costruita nel 1920 nel cimitero di Stoccolma.
ENG A collective exhibition to display the relationship between nature and spirituality. A green, silent place between lagoon, sky, and earth, conducive to reflection and spiritual experience. Ten great photographers participated with images that relate to the architecture of each chapel. The chapels were the first participation of the Vatican to the Venice Architecture Biennale, back in 2018, and have been designed by internationally-renowned architects. The current exhibition has been curated by Francesco Dal Co, who took inspiration from the Gunnar Asplund’s Wood Chapel installed in Stockholm in 1920.

Un progetto espositivo, ideato da Arte e Design Venezia e Venice Design Week in quattro parti, che nasce dalla volontà di esplorare come l’opera architettonica abbia la capacità di rappresentare chi la vive e allo stesso tempo di diventare simbolo per il contesto urbano. All’interno di Palazzo Contarini Polignac, negli spazi del Magazzino Gallery, quattro mostre si alterneranno lungo tutto l’arco della Biennale, cioè da maggio a novembre: l’architettura per la comunità, l’architettura per il lavoro, l’architettura per l’ospitalità e interior design, l’importanza del dettaglio. Cento progetti selezionati da tutto il mondo danno identità ai luoghi. Edifici, realizzati negli ultimi anni o ancora in fase di cantiere, dove le persone si identificano e scelgono di abitare, lavorare, condividere il tempo libero. L’architetto è chiamato a interpretare le necessità per sviluppare spazi che saranno funzionali e allo stesso tempo diverranno landmark per il contesto urbano. Fotografie, progetti, rendering e plastici trasportano il visitatore all’interno di ambienti suggestivi e funzionali, punti nevralgici delle nostre vite.

ENG A project in four parts produced by Arte e Design Venezia and by Venice Design Week on how architecture can represent both the dweller and the urban context. At Magazzino Gallery, staggered over several months, the four exhibitions will each focus on community architecture, worksite architecture, hospitality architecture, and interior design. One hundred projects from all over the world come together to give places their identities. People choose to identify and live in these buildings, and share their free time in them. Architects must respond to interpret existing needs and make buildings functional and iconic in the urban context.
La prima edizione di DoorScape, il concorso internazionale ideato da Oikos Venezia e Fondazione Querini Stampalia propone una riflessione sullo spazio di ingresso nei suoi molteplici collegamenti, accezioni e funzioni, avviando una riflessione inedita in questo ambito di ricerca. «Siamo sulla porta, nel luogo che filtra l’incontro tra l’interno e l’esterno –spiega l’architetto Michele De Lucchi, che con il suo studio AMDL CIRCLE ha presieduto la giuria e curato la mostra di progetti ospitata ora nell’area Scarpa della Fondazione Querini Stampalia – È un confine, un passaggio attraverso due aree che proprio in quel punto si combinano e si avvolgono tra loro. Il tema del concorso mette insieme un concetto psicanalitico e al tempo stesso architettonico. Tradizionalmente il confine in architettura è una linea netta contro cui si sbatte, dove incomincia qualcos’altro. Se invece fosse un settore nel quale un po’ si sovrappongono cose che arrivano da una parte e dall’altra, si darebbe luogo a un territorio comune che non appartiene né all’uno né all’altro e che proprio per questo potrebbe diventare il luogo dell’incontro [...]».
I dieci progetti selezionati sono: The Space Beyond the Threshold di Setion Branko, The Cut di Matheus Cartocci, Il giardino dell’Utopia di Emanuele Cipolla, Soglia da Segno a Luogo di Filippo Garau, Prélude di Isabelle Gomez, Viride di Anna Loggia e Alice Fantino, Instrument Door di Sara Simoska, Doorscape di Maria Grazia Spirito, Hypostyle di Victor Catalin Tanasa, La soglia come approdo di Antonella Trusgnach.
ENG The first edition of DoorScape, the international competition founded by Oikos Venezia and Fondazione Querini Stampalia which examines entrance spaces in their multiple connections, meanings and functions, undertaking an unprecedented reflection in this field of investigation. Its goal is to examine a wider range of spaces than a purely technical approach would permit: the door as a meeting place of inside and outside, as a fluid border, as passageway between two intersecting spaces. Of the 150 projects submitted, the ten which were selected by the jury chaired by AMDL CIRCLE and Michele De Lucchi are now on display in the exhibition.
DoorScape | Lo Spazio oltre la Soglia
18 maggio-26 novembre Fondazione Querini Stampalia, Campo Santa Maria Formosa, Castello 5252 www.querinistampalia.org | doorscape.eu

Per la sua decima edizione, il Premio W di architettura under 30, promosso da Fondation Wilmotte, ha scelto come tema progettuale tanto stimolante quanto essenziale: «Un tetto per tutti!». I tetti modellano il paesaggio delle città e delle campagne, modellano l’orizzonte.

Un tetto è una protezione, un riparo, una promessa di una rinnovata vita familiare e sociale. Di fronte all’attuale crisi di alloggi inadeguati, i partecipanti hanno immaginato soluzioni originali al fine di progettare moduli abitabili che si inseriscono sotto coperture esistenti e inutilizzate (tetti di capannoni agricoli, industriali, ferroviari o del patrimonio militare, tetti di edifici da riutilizzare, locali commerciali di grandi dimensioni dismessi, ecc.).
Tra i 57 progetti ricevuti, sono stati menzionati 10 progetti e premiati 4, che sono ora protagonisti della mostra alla Gallery della Fondation Wilmotte a Venezia.
I progetti vincitori sono: 1Prix - Vanni Renzini (24) & Silvia Roseto (25), Università degli Studi di Firenze, con il progetto Al Traverso ; 2Prix - Brieuc de Norre (24), Faculté d’Architecture La Cambre Horta de l’Université libre de Bruxelles, & Phan Dang Khoa (26), École Nationale Supérieure Paris Malaquais, con Un héritage industriel au profit de logements sociaux; 3Prix ex aequo - Viet Thai Dang (26), École Nationale Supérieure Paris La Villette, con Laneway Village ; Théo Bienvenu (26) & Claire Romsée (25), l’Ecole Nationale Supérieure d’Architecture de Nantes, con Le Toit du quartier - Vivre dignement ensemble sous les nefs de la Rapée
ENG For its tenth edition, the Prix W for architects under 30, promoted by Fondation Wilmotte, chose an essential, stimulating theme: A roof over everybody’s head! Roofs model the landscape of cities and country – the shape the horizon. Roofs protect, shelter, and promise family and social life. Seeing the current housing crisis, participants imagined original solutions to build housing modules to be installed below existent, unused coverage, including hangars, industrial sites coverings, hollowed-out buildings, etc…
PRIX
18 maggio-27 novembre Fondation Wilmotte, Gallery Fondaco degli Angeli
Fondamenta dell’Abbazia, Cannaregio 3560
Fondaco dei Tedeschi ha affidato a Sbagliato – progetto artistico fondato nel 2011 da tre architetti e designers romani – l’ideazione di due diverse installazioni “visionarie” sulla facciata e all’ultimo piano dell’edificio cinquecentesco restaurato da Rem Koolhaas. Il progetto nasce dal desiderio di generare un’interferenza, di creare ‘varchi’ all’interno dell’ordine composto dalle architetture.


Le cinque grandi arcate a tutto sesto, che chiudono il vasto portico sul Canal Grande, vengono riprodotte e moltiplicate, generando una prospettiva ‘infinita’: una vertiginosa mise en abyme degli elementi architettonici della loggia disorienta lo spettatore, lo stupisce, stravolge la sua percezione dello spazio, riuscendo a fondere i confini tra finzione e realtà. Inoltre, alterando i pieni e i vuoti su una parte della facciata, l’intervento inventa nuovi passaggi, attraverso i quali il passato consegna il testimone al presente, e viceversa.
Nello Spazio Eventi invece una porzione della Corte interna viene estrapolata, moltiplicata e ricollocata, decontestualizzata, sulle quattro pareti. Gli archi colorati di blu si muovono sinuosi come sommersi dall’acqua e i riflessi del cielo attraverso il velario ne mettono in risalto la potenza cromatica. In questo modo il visitatore rimane sospeso tra ciò che esiste e ciò che potrebbe essere.
ENG Fondaco dei Tedeschi has entrusted Sbagliato – an artistic project founded in 2011 by three Roman architects and designers – with the creation of two “visionary” installations on the façade and on the top floor of the building. The project stems from the desire to generate interference and to create ‘gaps’ within the architectural orderliness. In the Loggia on the Grand Canal, the multiplication of the arch on the external façade creates an ‘infinite’ perspective while the installation in the Spazio Eventi extrapolates a portion of the internal courtyard by decontextualizing it and relocating it onto the four walls, the blue arches moving sinuously as though submerged in a dialogue between architecture and water.

Le opere di sei artisti pionieri della scultura contemporanea, nati in Boemia nelle prime decadi del secolo scorso, costituiscono il percorso della mostra Vetro boemo: i grandi maestri, a cura di Caterina Tognon e Sylva Petrová, in collaborazione con il Museo di Arti Decorative di Praga, nuovo capitolo espositivo de Le Stanze del Vetro sull’Isola di San Giorgio Maggiore. A partire dalla presa del potere da parte del Partito Comunista nel 1948 e con l’imposizione in Cecoslovacchia di un modello estetico basato sul realismo socialista, un folto gruppo di artisti si dedicò allo studio di caratteristiche e potenzialità del medium-vetro, a cui vennero applicati procedimenti tecnologici innovativi, forme evolute, ma soprattutto concezioni artistiche contemporanee: questa nuova forma d’arte ebbe un ruolo estremamente significativo in Boemia per tutto il Novecento. Il racconto dell’emancipazione dopo la Seconda Guerra mondiale del vetro in Boemia dalla tradizionale categorizzazione di arte applicata e decorativa a un utilizzo per la realizzazione di sculture astratte, vetrate, architetture, installazioni e lavori site-specific, vede protagonisti in mostra Václav Cigler, Vladimír Kopecký, Stanislav Libenský e Jaroslava Brychtová, René Roubícˇek e Miluše Roubícˇková.
ENG Art by six modern sculptors born in what is now Czechia in the early 1900s will introduce us to Bohemian glass art in an exhibition curated by Caterina Tognon and Sylva Petrová in cooperation with the Prague Museum of Decorative Arts. The exhibition is part of the Le Stanze del Vetro cycle. Since the Communist Party took power in Czechoslovakia in 1948 and imposed real socialism as the state-sponsored art canon, a large group of artists dedicated to the study of the features and potential of glass. They applied modern technology, new forms, modern art concepts, and gave glass art a place of prominence in twentieth-century Bohemia. The current exhibition comprises abstract art, glass windows, architecture pieces, installations, and site-specific work.
Un nuovo progetto conferma la visione creativa di Adriano Berengo e la sua straordinaria capacità di innescare un dialogo senza confini con il mondo dell’arte contemporanea e del design: Sacrum Unguentum di Sam Baron trasforma in un laboratorio lo spazio di un ex-Farmacia del XVI secolo in Piazza San Marco. Il lavoro del grande creativo francese è un poetico equilibrio fra estremi, che conferma la capacità di mescolare, unire elementi che solitamente non si parlano; qui disegna un insieme di “pezzi singoli” in vetro bianco, nero e oro, che popolano gli scaffali, il bancone e le vetrine, tra fiori, foglie, spine e veleni che seducono e inquietano al tempo, lasciando aperta la domanda sulla natura amica e nemica, amena e terribile, preziosa e fragile come il vetro.
«Per tanto tempo ho guardato con interesse al lavoro di Sam Baron – afferma Adriano Berengo – e mi fa particolarmente piacere che abbia tratto ispirazione dallo spazio della Berengo Collection e creato questa mostra unica. Il buon design, come la buona arte, rafforza i sensi e questa installazione nella vecchia farmacia fa proprio questo, accende curiosità». Con questa mostra, curata da Mariapia Bellis e Isabelle Valembra, Sam Baron getta uno sguardo contemporaneo sull’arte ancestrale del vetro, mettendo in discussione l’aspetto decorativo della sua produzione per recuperare i dettagli ornamentali e i riferimenti culturali di un’arte antica, arricchendo l’immaginario estetico di genere. Una selezione di sue sculture è esposta anche presso l’hotel The St. Regis Venice. M.M.
ENG A new project that confirms Adriano Berengo’s creative vision and extraordinary ability to prompt a free-ranging dialogue with the world of contemporary art and design: Sam Baron’s Sacrum Unguentum transforms the interior of a historic former pharmacy into a laboratory. A set of “one-off pieces” in glass populate the shelves, the counter and the windows, among flowers, leaves, thorns and poisons that simultaneously seduce and disturb, highlighting nature’s ambiguous role as pleasant and terrible, precious yet as fragile as glass. Baron’s contemporary gaze on the ancestral art of glass interrogates the decorative aspects of its production in order to take up the ornamental details and cultural references of this ancient art. A selection of sculptures will also be displayed at The St. Regis Venice.

Il tradizionale concetto di esotismo, intriso di stereotipi, viene ripensato attraverso la lente del design. Dal 19 maggio al 18 giugno torna, in concomitanza con il primo mese della Biennale di Architettura, la quarta edizione di Venice Design Biennial dal titolo Auto-Exotic. Francesca Giubilei e Luca Berta hanno invitato designer da tutto il mondo a ricercare l’esotico, l’altrove, nelle pieghe più o meno nascoste della nostra stessa cultura.
La sfida per i designer è come indagare questa alterità, vicina e lontana, in modo depurato da pregiudizi stantii, ma non senza la radicalità di chi vuole abbattere i pregiudizi.
Una mostra principale, Auto-Exotic – part I allo SPARC* in campo San Stefano e tre spin off ( part II alla Giudecca spazio SPUMA, part III alla Bocciofila San Sebastiano e part IV al Des Bains Beach Club al Lido) formano il programma espositivo di Venice Design Biennial, con altri progetti satelliti dove protagonisti sono studi, gallerie e singoli designer con installazioni in spazi indipendenti. L’obiettivo è coniugare il design con l’esperienza del vissuto quotidiano della città che a Venezia significa innanzitutto muoversi a piedi, o in barca (ancora di più nell’edizione di quest’anno). Nuovi orizzonti vengono, dunque, offerti allo sguardo e all’immaginazione applicata a un altrove oltre i limiti dell’esperienza conosciuta. M.M.


ENG The traditional concept of exoticism, steeped in stereotypes, is re-examined through the lens of design. As in previous editions, the Venice Design Biennial will explore the various declinations of this theme through the Main Group Exhibition Auto-Exotic, curated by Francesca Giubilei and Luca Berta, and a series of collateral projects organized by design firms, galleries and individual designers who will present their installations in independent spaces. Once again, the aim is to combine the discovery of carefully curated design projects with the every- day experience of life in the city, which in Venice means first and foremost moving on foot or (especially in this year’s edition) by boat. The Main Group Exhibition will also present the outcome of the Venice Design Biennial Residency, awarded this year to Australian designer Trent Jansen.

Partendo da storie antiche di viaggio, il progetto flying city leather maps si ispira al mito del tappeto volante di tradizione indo-persiana, in cui tempo e spazio sono l’unione mistica tra finito e infinito. Le mappe Frank&Frank hanno la forza evocativa, il colore, le forme dei tappeti: la trama delle città diventa intreccio geometrico decorativo, ordito misterioso, spazio circoscritto in cui liberare la fantasia. Realizzate in pelle conciata al vegetale, le mappe sono realizzate con un processo artistico di riduzione dall’immagine della città reale a una struttura quasi astratta. Il risultato è un labirinto tridimensionale dove tempo e spazio amplificano gli orizzonti delle città del mondo, creando inedite e bellissime geografie urbane. Frank&Frank sono Marcella Molinini e Roberto De Gregorio, artisti e designer torinesi; la loro curiosità è la chiave fondamentale del progetto. Per tutta la durata della Biennale Architettura due interventi site-specific offrono la possibilità di conoscere da vicino le mappe Frank&Frank. Il primo avvolge le pareti del Baglioni Hotel Luna, dove le mappe sono quadri in rilievo che rompono la linearità classica e sorprendono lo sguardo; il secondo, occupa un intero muro dell’Aeroporto Marco Polo, 13 metri lineari, in cui le mappe si susseguono come le continue partenze e arrivi. L’iniziativa è frutto della sinergia tra Venice Design Week e Baglioni Hotel Luna.
ENG Taking as its starting point ancient stories of travel, the flying city leather maps pro- ject is inspired by the myth of the flying carpet of Indo-Persian tradition, where time and space represent the mystical union between the finite and the infinite. In the Frank&Frank maps, a pro- ject by designers Marcella Molinini and Roberto De Gregorio, the evocative power, the colour, the shapes, and the texture of cities become both a geometric pattern and a way of telling stories. Drawing the cities is an artistic process that reduces the real image to an almost abstract structure: the result is a three-dimensional mosaic obtained through manual intervention on vegetable-tanned leather.
Non un catalogo di lavori, ma un dialogo creativo per riflettere sul vivere comune attraverso il design e l’architettura è Lo spazio, il luogo e le possibilità di Paolo Lucchetta, pubblicato da poco per Marsilio Arte. Per consuetudine amicale di lunga data, oltre che come nostro consulente-scrittore di architettura, conosciamo il lavoro di Lucchetta attraverso i suoi racconti scritti e parlati sempre pieni di entusiasmo e rivolti al plurale. La curiosità verso i fermenti del nuovo, l’attenzione e l’importanza data ai collaboratori, rappresentano una costante del modus operandi del suo studio Retail Design. Il viaggio intrapreso nelle pagine del volume attraversa i territori di una progettualità che si indaga e si mette costantemente in discussione per trovare nuove soluzioni ed estetiche sempre più appaganti. La scelta professionale di riqualificare il commercio attraverso la restituzione di spazi urbani a favore non del mero consumatore, ma in primis del cittadino, è per Lucchetta il motore primo del suo lavoro: luogo, oggetto e persona in costante dialogo tra loro rappresentano la stella polare della sua navigazione architettonica. Lucchetta con il suo lavoro di equipe – multiforme, multiculturale, multigenerazionale – pone il focus sulla relazione tra spazio e abitante. Ne scaturisce un’architettura inclusiva, risultato di un costante lavoro di investigazione in cui Paolo Lucchetta diventa un “detective selvaggio”.

Amo i libri e gli scrittori; forse avrei voluto essere io stesso uno scrittore. Mi piace scrivere, mi piace raccontare, però la passione per l’architettura vince, quindi credo davvero di avere compiuto professionalmente la scelta giusta. Questo è il mio secondo libro; il primo, Paolo Lucchetta + RetailDesign: works 1999/2006, edizione Electa, è di una una decina d’anni fa. Le mie resistenze a pubblicare un libro nascono proprio dal mio amore per essi: non mi interessano i libri regesto delle opere, mi piace, anzi, direi proprio che mi intriga, la narrazione. Avevo in mente da tempo, quindi, di scrivere un libro “narrativo”. Casualmente vari fattori hanno concorso a far sì che tutto ciò si concretizzasse, in primis un incontro ludico: durante una partita di calcio del Venezia allo Stadio Penzo, invitato da un amico che mi aveva detto che si sarebbe unito a noi uno scrittore, ho conosciuto Gianni Montieri, rivelatosi da subito una persona molto interessante.
Quindi il Penzo come stimolo di riflessioni extra calcistiche?
Il Penzo è un luogo meraviglioso, capace di generare relazioni amicali. Andrebbe rivalorizzato il ruolo degli stadi all’interno delle città, perché sono equiparabili alle piazze, ai teatri. Bisognerebbe sempre confrontarsi con il fascino degli stadi urbani; a Londra ce ne sono ben sette e tutti in attività!
Quel giorno, nel corso della partita, abbiamo iniziato a parlare di molti temi, spaziando dal calcio alla letteratura. Mi è venuta così l’idea: ho pensato che probabilmente proprio a Gianni Montieri avrei potuto consegnare tutte le foto dei miei lavori scattate da Marco Zanta nel corso degli anni, dopo avergli spiegato la mia idea di un volume in cui il testo di uno scrittore e non di un architetto avrebbe dovuto rappresentare la chiave della narrazione. Montieri ha accettato entusiasta di scrivere questo testo, paragonando il nostro lavoro a quello dei Detective selvaggi di Roberto Bolaño, che è uno dei miei libri favoriti. Si è quindi subito immerso nell’osservazione dei progetti realizzati attraverso il mio abituale metodo operativo, ossia quello di costruire dei percorsi elaborativi concentrati sulla collaborazione, cercando ove possibile quelle affinità elettive, non necessariamente nello stretto ambito della disciplina, che possono favorire il miglior sviluppo delle idee.
Cavalcando questa idea di ‘detective’ delle nostre attività, non ho potuto che coinvolgere poi anche Marco Zanta, che da vent’anni chiamo a fotografare i miei lavori. Zanta è il mio occhio, il mio sguardo, ha la capacità critica di saper leggere i lavori. È un fotografo molto conosciuto in Italia per l’utilizzo della luce naturale; le sue foto dei luoghi dell’abbandono, come per esempio quelle dedicate a Marghera, sono delle descrizioni meravigliose. In questo progetto editoriale, quindi, lui doveva assolutamente esserci.
Serviva infine un grafico che sapesse interagire virtuosamente con questo gruppo di lavoro eterogeneo. Ho quindi coinvolto Riccardo Baggio, grande talento di formazione IUAV che lavora con noi in studio. Con Riccardo ho potuto trasmettere l’identità profonda del lavoro e al contempo lui ha saputo offrire un grande contributo di lettura all’insieme dei progetti presentati nel libro. Ho coinvolto infine alcuni amici appassionati di architettura, come Vincenzo Casali, un architetto veneziano con cui condivido il supporto a iniziative di arte indipendente, e Giorgio Camuffo, un vero agitatore culturale dalla visione allargata, a cui sono legato da tempo anche per percorsi professionali condivisi.
Naturalmente il ringraziamento più forte e sentito va a tutti i ragazzi che hanno lavorato e lavorano in Studio, che sono i veri protagonisti
della creazione condivisa di tutti questi progetti e delle tante storie legate a ogni singolo lavoro. Il libro nasce e si concretizza in questo stimolante percorso di condivisione, dopo aver preso la sua prima scossa di energia dalle buone vibrazioni scaturite dal Penzo quel fortunato giorno.
Un libro in dialogo, un libro aperto insomma.
Un libro non solo costruito in una concreta logica di collaborazione, ma un libro che cerca condivisione anche fuori dal suo percorso di realizzazione, con tutti i suoi potenziali lettori. Penso all’immagine di un messaggio in una bottiglia gettata in mare perché qualcuno possa recuperarla e leggerne il contenuto...
Quale la definizione di retail design?

Il retail, nella mia storia personale, ha rappresentato il pretesto per scegliere la professione di architetto. Essere “figlio d’arte” – mio padre ha lavorato per molti anni con i grandi maestri milanesi degli anni ‘50 e ‘60, in un periodo in cui la Rinascente creava il Compasso d’Oro, accompagnando una vicenda italiana di cultura applicata agli oggetti quotidiani –, quindi con quel tipo di propensione e di esperienza fin dalla prima giovinezza, mi ha portato a vedere e ricercare nel mondo della quotidianità una forte possibilità di esprimere dei valori e dei concetti. Quella generazione ha creato il design, ha generato un valore di cui ancora si investiga la matrice. Porto un esempio pratico che ho vissuto direttamente quando mi è stato commissionato da Grandi Stazioni un lavoro per Napoli Centrale. Ho trovato un filmato, un cortometraggio per Carosello per la pasta Barilla realizzato da Pietro Gherardi, vincitore dell’Oscar per i migliori costumi con Otto e mezzo e La Dolce Vita di Fellini, la cui canzone di sottofondo è Se telefonando, testo di Maurizio Costanzo, musica di Ennio Morricone, con alla voce l’inarrivabile Mina. Gherardi sceglie per girare il suo filmato pubblicitario un set emblematico dell’Italia di
quegli anni: la stazione di Pier Luigi Nervi a Napoli, allora, siamo nel 1966, appena inaugurata. Attorno ad un fattore quotidiano semplice come la pasta Gherardi riunisce tutti questi nomi, questi autori ed artisti incredibili. L’esempio aiuta a spiegare in modo molto chiaro come ci siano dei significati nella vita quotidiana che rendono il retail molto interessante. C’è sempre una grande domanda di qualità attorno alla vita delle persone, domanda che personalmente mi ha spinto a ricercare questi concetti anche all’interno dell’università. Sovente a una richiesta di siffatta progettualità corrisponde spesso un’astensione; ci sono progettisti, architetti che per principio non si dedicano agli elementi, siano essi oggetti o quant’altro, concreti del nostro vivere quotidiano. Pare incredibile come in Italia ancora oggi, più diffusamente di quanto sia dato superficialmente pensare, venga in qualche modo, per usare un verbo deciso, demonizzato il retail design, inteso da alcuni ideologicamente come area di “peccato”, come una sorta di supposta resa al peggior capitalismo. Difficilmente si ritrova una posizione di neutralità nel comprendere come anche attraverso questi luoghi pubblici passi la qualità della vita delle persone. In un bellissimo saggio Marc Augé, inventore della parola “non luoghi”, afferma che il livello di civiltà di una società passa attraverso la qualità dei suoi luoghi pubblici. Questo assunto è da sempre il grande motore che muove il mio lavoro. Ho potuto nel tempo, per storie e vicende talvolta ricercate talaltre casuali, trovarmi a fare degli incontri molto fortunati. Ho lavorato con Calvin Klein, ho girato il mondo, questo mestiere mi ha fatto vedere e conoscere molte cose. Per me il retail design è una disciplina in cui si possono leggere vari aspetti della vita di tutti i giorni con l’impegno di migliorarli. Da qui nasce l’idea identitaria di retail design, lemma composto da due polarità che esprimono due culture forti, entrambe leggermente autoreferenziali. Alcuni parlano solo di commercio, altri parlano solo di progetto; quando le due parole e le idee che sottendono ad entrambe si incontrano integrandosi, nascono delle innovazioni a favore delle persone.
PAOLO LUCCHETTA
Credo molto a questo connubio potenzialmente virtuoso: in questa direzione il mio lavoro creativo e produttivo, forse ammantato di idealismo, spende tutte le proprie energie, cercando di tenere insieme efficacemente queste due culture. Attraverso i miei progetti cerco di promuovere questa disciplina considerandola come una possibilità concreta di incidere nel quotidiano anche socialmente, promuovendo e sostanziando, oggi più che mai ineludibili, dei valori quali la transizione ecologica e digitale e la rigenerazione urbana. Temi di stringente attualità che proprio attraverso progetti di retail design trovano delle proprie, tangibili risposte.

Nei suoi progetti è chiamato ad intervenire in luoghi caratterizzati da una intrinseca, forte storia, dove quindi assume un ruolo rilevante, diremmo sostanziale, la capacità di costruire un dialogo con un vissuto di lunga profondità. Sfide, queste, in cui più che mai il segno, il lavoro di chi interviene deve essere al servizio del progetto, ponendo davvero in secondo piano l’ego autoreferenziale del progettista. Ma come si crea e si costruisce un progetto?
Personalmente, ma come me molti altri colleghi, cerco di interpretare la professione come se fosse una costruzione di narrazioni.
Creiamo degli ambienti narrativi raccontando la storia di quello che si sta progettando attraverso i luoghi, utilizzando anziché le parole, come si usa in letteratura, le spazialità. Questo esercizio professionale ridimensiona necessariamente l’espressione del proprio ego, a partire, ma non solo, dagli aspetti formali che vai ad utilizzare per raccontare, a prescindere da ciò che fai, la tua storia. Mi è capitato di confrontarmi e di lavorare con archistar e di discutere di questa disposizione con loro. Uno in particolare mi ha detto: «Guarda è molto strano, perché quando parlo con te mi sembra sempre che tu racconti delle cose che noi non possiamo raccontare, perché veniamo chiamati solo per raccontare la nostra storia. Ci sono persone a cui chiediamo cosa dovremmo fare in questo progetto e ci rispondono di fare un progetto “alla”, quindi dando una denominazione».

È normale che nel mondo della progettazione ci siano questi due differenti approcci, uno fortemente “griffato” e uno più narrativo. Noi apparteniamo a questo secondo modo di raccontare le cose: la nostra capacità è di entrare all’interno dei progetti. C’è una prima fase che chiameremmo istruttoria, con questo linguaggio vagamente poliziesco, quella fase in cui noi non prendiamo posizione sul progetto cercando di acquisire indizi. E’ il tempo, questo, in cui dimentichiamo la matita, se non per assecondare mere necessità

descrittive. Mi piace gustare quel momento in cui vedo una cosa senza ancora averla interpretata, lasciando che nascano, che si formino liberi dei pensieri; è il divertimento di acquisire, rispetto alle condizioni date, difficoltà, vincoli... Poi c’è una seconda fase, una volta raccolte tutte queste informazioni, che rappresenta senz’altro il versante più motivante del nostro lavoro, ossia quello di prendere posizione. Io tengo sempre in mente la frase bellissima di Enzo Mari che alla domanda degli studenti: «Che cosa dovremmo disegnare?», risponde: «Aprite la finestra, guardate quello che vi fa indignare e che non vi piace o che vorreste semplicemente cambiare, quello è il progetto che dovrete fare».
Dopo alla fase istruttoria, quindi, ciò che dobbiamo fare è precisamente questo: non tanto prendere una posizione personale, quanto quella che ci è stata indicata, assegnata, rispondendo a dei valori o a delle rivelazioni attraverso degli elementi sorprendenti e narrativi che rendano quella storia ancora più forte, ancora più importante. E’ una fase questa molto creativa, la più importante per me, che si esprime attraverso schizzi e riunioni del nostro gruppo di lavoro, dove si raccolgono tutti gli indizi a disposizione e si elabora la possibile azione. Da qui si passa alla terza fase, in cui dispieghiamo concretamente il lavoro, facendo in sostanza il nostro mestiere. Congeliamo la parte istruttoria, la parte creativa, e ci mettiamo alla caccia del maggior numero di dettagli di qualità possibili. Questa è una fase che svolgiamo dentro il nostro studio, spesso coinvolgendo dei partner per svolgere ulteriori approfondimenti. La qualità è fondamentale; l’importanza delle scelte, dei materiali, la compatibilità dei costi e dei dettagli rende forte il progetto. Vi è infine, ultima, conclusiva fase progettuale, la parte della rappresentazione, dove si tratta di costruire una narrazione efficace per raccontare il progetto indispensabile per consentire di raccogliersi attorno ad esso tutte le persone che concorreranno poi alla sua realizzazione. Noi creiamo delle condizioni per cui le persone debbano e possano continuare da sole a costruire il senso di un luogo in cui siamo intervenuti. Un metodo di lavoro consolidato negli anni che si è arricchito di molti dettagli per merito delle grandi esperienze che abbiamo fatto. Dal punto di vista metodologico la collaborazione con Calvin Klein è stata una scuola maestosa: noi eravamo responsabili della parte europea dei negozi del brand, per questa ragione una volta all’anno venivamo convocati a New York. Ci chiedevano di non guardare gli spazi retail, ma di incontrare artisti, curatori, scrittori, perché l’arte è la parte più sensibile della società. Loro sarebbero stati, quindi, i nostri interlocutori capaci di intercettare e anticipare le tendenze prossime e future. Dopo questa parte più concettuale, ne seguiva una molto più razionale, che per Calvin Klein era quella davvero fondamentale: l’identità dei valori del marchio doveva essere sempre riconoscibile sia che si trattasse del negozio di Madison Avenue di 300 metri, sia di uno scaffale in un aeroporto qualsiasi.
La vita è la fortuna delle persone che incontri e con cui entri in contatto. La frase di Achille Castiglioni «Se non siete curiosi, lasciate perdere» rimane la quintessenza di questo mestiere.
Spesso opera in contesti a dir poco particolari, soggetti non di rado a forti vincoli. Quale la sua opinione relativamente alla conservazione e come instaurare un equilibrio tra storia, persone e contemporaneità?
David Grossman scrive: «Se vuoi raccontare una storia, devi leggere
cento storie». In un Paese come il nostro in ogni progetto c’è una traccia che merita di essere ascoltata e che non basta rivelare. È una traccia che può già di per sé sufficientemente comunicare dialetticamente quello che potrà essere il potenziamento delle possibilità future di rivalorizzazione di un dato luogo, oggetto, edificio. Questa lettura della storia non equivale mai per me semplicemente ad un accontentarsi di riproporla in modo pedissequo: la sfida a mio avviso è quella di rendere compatibile la lettura con una visione del futuro che fa parte del nostro modo di essere, quindi anche del senso primo di una professione. Nel volume si possono vedere spazi che sono stati un tempo absidi, mercati, cinema, case di ambasciatori, oppure spazi monumentali ed istituzionali dell’arte come ad esempio le Gallerie dell’Accademia a Venezia, con quegli inserti meravigliosi di Carlo Scarpa. Si possono ripercorrere a Roma le visioni immaginifiche di un Paolo Sorrentino attraverso la nostra interpretazione della romanità per la nuova Rinascente, o entrare nella la stazione di Torino Porta Nuova dove la negazione dell’esistenza di un monumento nazionale come la navata di una grande stazione ottocentesca, totalmente abbandonata, viene rivalutata e riqualificata. O ancora, ritornando a Venezia, l’intervento minimo fatto per interpretare il senso di una Confraternita, quella di San Rocco, nel portare avanti una Scuola per le future generazioni, mantenendo il grado di responsabilità che si ascrive ad essa. Tutti questi esempi tengono in considerazione il patrimonio dei beni culturali, quindi la peculiarità somma dell’identità storico-artistica del nostro Paese, offrendo la possibilità di interventi eseguiti in maniera sostenibile senza consumare del suolo, potendo rieditare, rileggere, riprendersi cura, riconsiderare i luoghi dell’abbandono.
Questo è un tema, quello della progettazione dei luoghi costruiti, in cui credo moltissimo, un fronte a dir poco fondamentale della progettazione contemporanea in un territorio come quello italiano, ma non solo naturalmente. Oggi le attività di nuova architettura rappresentano solo l’1% degli interventi complessivi; il 99% sono azioni di riconversione, rigenerazione. Saper dialogare con le Soprintendenze, che svolgono un ruolo cruciale, a volte non semplice, in questa direzione, imbattendosi e talvolta scontrandosi con tante interpretazioni a cui dare coerenza in rapporto alle aspettative complesse dei nostri tessuti urbani, è fondamentale. Tuttavia bisogna cercare al contempo di lavorare sul valore dell’architettura contemporanea come possibilità di rigenerazione di nuovi valori. È necessario ricercare un nuovo punto di equilibrio.
Come si relaziona con il territorio con cui e in cui va ad interagire?
Per me è un tema cruciale, fondamentale, l’ascolto dei luoghi, delle comunità, delle cose che accadono: è la linfa da cui scaturisce l’idea di progetto. Quindi pensare di non ascoltare o di non leggere le intrinseche caratteristiche di un territorio da un punto di vista sociale, produttivo, paesaggistico, non avere insomma curiosità verso questi orizzonti interpretativi equivale, in una parola, ad indebolire il progetto. La parte istruttoria deve necessariamente partire da questo approccio, a partire da una forte attenzione da riservare ai processi partecipati, i quali possono produrre esiti fruttuosi nel momento in cui riescono ad individuare delle sintesi davvero condivise dalle parti in gioco. La corretta lettura dei contesti sociali è un’azione fondamentale oggi più che mai.







Quale edificio dal punto di vista architettonico e sentimentale sintetizza meglio il suo senso di architettura?
Ci sono certamente progetti in cui riconosco la felicità di essere riuscito ad esprimere i valori in cui credo di più. Uno tra questi è la Libreria Ambasciatori a Bologna, nata nel 2008 da un progetto innovativo che ha visto riuniti Librerie.coop e Eataly. Lo spazio si sviluppa in 1.450 mq su tre piani; offre cibo, libri ed esperienze di socialità e cultura per i diversi momenti della giornata. È aperto tutti i giorni dalle 8 alle 24. L’edificio che lo ospita conserva tracce architettoniche di vari secoli (XIV, XVIII e XIX) che il progetto ha integrato in chiave moderna. Per me è stato un passaggio fondamentale del mio percorso professionale, perché mi ha permesso di approfondire come meglio non avrei potuto chiedere il rapporto complesso che sussiste da sempre tra architettura e città. Io ho studiato con Aldo Rossi, quindi l’architettura della città per me è fondamentale: un luogo abbandonato, con tre vincoli di sovrintendenza, in una città come Bologna. Abbiamo restituito questo spazio alla città! Quando Oscar Farinetti è entrato in Ambasciatori in pieno cantiere con i piedi a calpestare un metro di fango, in una freddissima giornata di gennaio in uno spazio allora quindi del tutto inospitale, dopo la nostra presentazione alla fine ha detto: «Siamo da tre ore in questo luogo, io leggo i luoghi di pancia, voglio fare un Eataly qui dentro». C’è un tratto carismatico di alcuni luoghi che fanno parte della città che bisogna saper leggere: da qui nascono i progetti. Posso dire senz’altro che Ambasciatori per me ha rappresentato in qualche modo la somma che racchiude tutto. Un’iniziativa voluta da un sindaco forse poco amato a Bologna, Sergio Cofferati, il quale bandì il concorso affermando di non volere solo uno spazio commerciale, ma un luogo dove alle ore 18 di ogni giornata ci fosse la presentazione di un libro o di una ricetta gastronomica, un polmone culturale, insomma, capace di dare un respiro aperto alla città tutta. Se metto insieme Romano Montroni che di Librerie.coop è stato per anni direttore, proveniente dalla scuola dei librai di Venezia, Oscar Farinetti, Sergio Cofferati e i tre vincoli della Sovrintendenza, beh, capite bene che non possa che concludere che tale articolatissimo progetto abbia svolto un ruolo fondamentale, direi addirittura determinante, per la maturazione professionale mia e del mio studio.
Lei è protagonista di una parte tutt’altro che secondaria del nuovo progetto de Le Stanze della fotografia, da poco inaugurate all’Isola di San Giorgio Maggiore. Ci parli un po’ di questo suo importante intervento nella nostra città.
Un’iniziativa collettiva molto forte, nata da un editore, Marsilio, da molto tempo non solo protagonista centrale dell’industria editoriale italiana di qualità, ma anche soggetto tra i più qualificati del Paese nella produzione di importanti mostre d’arte. Fondazione Cini ha reso l’Isola di San Giorgio un teatro di attività e di rappresentazione di altissimo livello. Luogo caratterizzato da una storia a dir poco enorme, la cui suggestione così intensa non è davvero facile vivere altrove, con quella stratificazione tra stili e funzioni che lo contraddistingue costitutivamente proprio. Tra edifici palladiani e inserti espressione delle visioni architettoniche degli anni ‘50 del Novecento, tra la secolare vocazione monastica, innervata nel contemporaneo dalle straordinarie cappelle erette nel bellissimo parco dell’isola in occasione del Padiglione del Vaticano alla Biennale 2018 e ora in lì lasciate permanentemente, e l’attività archivistica e di ricerca,
tra la crescente offerta espositiva e le qualificate rassegne concertistiche, si vive immersi in un incredibile contesto tra la città e la Laguna, dimensione di tale pregnanza emotiva che non può non produrre in chi è impegnato in progettualità creative come le nostre degli stimoli vivi, forti. Stimoli che già mi avevano portato felicemente a intervenire qui con il progetto della Compagnia della Vela. In questo lavoro per le Stanze della fotografia ho espresso compiutamente la mia passione per i libri e, per estensione progettuale, segnatamente per i bookshop. Essi rappresentano una forma, una tappa fondamentale dell’esperienza culturale di un luogo; la qualità di un bookshop contribuisce a lasciare nella memoria del visitatore un messaggio composito fatto di libri, di memorabilia, di souvenirs che sintetizza e restituisce, quando costruito in maniera corretta ed accattivante, in maniera straordinaria la visione di una mostra o di un museo. Credo che i libri continueranno ad essere il modo migliore per trattenere un’esperienza quale quella di un’immersione in un’esposizione d’arte.
È un progetto, questo, che contiene molteplici tratti del mio percorso professionale ed umano, non ultimo il fatto di aver iniziato l’attività espositiva con Ugo Mulas, quindi con le radici di una generazione che in questo Paese ha lasciato dei segni straordinari. E’ stato perciò un grande piacere da parte mia fare parte di questa nuova, grande sfida di innovazione e valorizzazione di una parte così significativa della nostra città, sì.
Lei è riuscito a trasmettere la propria passione per via genetica a sua figlia Virginia. Come sta gestendo questo passaggio di trucchi del mestiere da padre in figlia?
È una domanda alla quale rispondo con vivo piacere. Considero questo passaggio come molto importante nello sviluppo prospettico del mio lavoro. Nella vita capita spesso di avere la sensazione che qualcuno ti abbia consegnato un testimone; è bello e stimolante ora per me fare altrettanto a ruolo invertito.
Quando ho iniziato a fare questo mestiere sono stato assistente di un amico di mio padre, che purtroppo è venuto a mancare durante il mio percorso di studi: questa persona mi spiegò allora quanto mi sarebbe stata utile un’esperienza al suo fianco, nonostante lui stesso riconoscesse di aver imparato moltissime cose da mio padre. Non importava cosa avrei poi fatto nella vita, se parchi o grattacieli; lui era convinto che un’esperienza del genere mi avrebbe aiutato. Questa esperienza passata mi conforta e mi accompagna in tutti i discorsi che sto oggi facendo a Virginia e agli altri ragazzi che frequentano il mio studio: non so cosa faranno nella vita, questo lo decideranno loro, ma cerco con la mia esperienza di trasmettere delle considerazioni, delle idee irrobustitesi negli anni con l’esperienza, che qui decido di condividere con chi si affaccia solo oggi al mestiere. Mi sembra giusto, direi doveroso, condividere quello che so con i giovani; ritengo altrettanto giusto, però, che la persona che mi trovo di fronte faccia ciò che crede di quello che io le trasmetto, con la massima serenità.
Mi definirei un soggetto “open source”, caratterizzato però da radici profonde, con una forte fiducia nel concetto di “affinità elettive”, che esistono assolutamente anche tra persone appartenenti a generazioni differenti.
Quindi distribuii gli Originali del più eccellente lavoro in uno coi rimasugli della più pregevole antichità dissotterrata dal lezzo dei Magazzini come in Museo nella Piazzola dell’Elaboratorio principale dell’Arsenale.
Sopra le Sale dell’Armamento distribuii tutte l’Armi usate da un solo Uomo nella non meno vaga che utile comparsa che ancora si osserva. Stesi alla scoperta sopra altri sedimenti tutte le Artiglierie di ferro che prima deperivano rinchiuse nei depositi
Domenico Gasperoni



Tra le protomi leonine degli archi in pietra d’Istria del lungo edificio delle Artiglierie all’Arsenale, è leggibile una lapide dedicata a Jacob Patisson, inglese, Soprintendente Generale alle Artiglierie, che nel 1772 in quei luoghi istituì un museo che raccoglieva canne di cannoni di ogni calibro, mortai e colubrine, per consegnarli alla memoria dei posteri, esempi dell’evoluzione tecnologica e della abilità nell’arte fusoria della Repubblica Serenissima:

«TORMENTA BELLICA/ PARTIM LONGA AETATE DESUETA/ PARTIUM AD POMPAM CONFLATA/ NE EORUM FORMA ET ELEGANTIAM/ POSTERI DESIDERARENT/ S.C./ ANNO R.S. MCCCLXXII/ JAC. PATISSON ANGLO PUB. PYROTECHNIAE/ PREAF»

Tra questi oggetti di uso militare, progettati per la devastazione del nemico in campo aperto e nel mare a bordo delle navi veneziane, vi erano pezzi di pregevolissima qualità artistica, veri capolavori usciti dalle officine degli Alberghetti, Conti, Mazzaroli, Camozzi, celebri famiglie di artigiani in continua competizione tra loro nel realizzare bocche da fuoco efficienti e precise nei tiri, ma anche impreziosite da raffinatissime decorazioni a rilievo sotto l’insegna del leone di san Marco.

Il meritevole progetto di conservazione e valorizzazione di questi materiali in ferro e in bronzo iniziato da Patisson venne proseguito e sviluppato da Domenico Gasperoni, veneziano, suo successore e ultimo nella carica di Soprintendente alle Artiglierie fino alla fine della Repubblica. Questi, contro il decreto del Senato che ne destinava l’eliminazione, sottrasse alla fusione molti pezzi, oramai obsoleti per efficacia balistica, ma pregevolissimi per bellezza di forma, per la perfezione del lavoro e per il gusto nel decoro. «Mi sentii trasportato dall’amore della Patria – questa la sua testimonianza in uno dei suoi diversi manoscritti intitolati Artiglieria Veneta antica e moderna ( Foto 1) – a farne universalmente conoscere il pregio e non poca fu l’afflizione dell’animo mio, quando l’Ecc.mo Senato, seguendo il consiglio dei suoi Generali, stabilì la rifusione di tutti i pezzi di Bronzo, anche del più egregio lavoro, e la vendita di quelli che ricordavano l’epoca della loro introduzione primiera […], implorai ed ottenni la preservazione dei più stimabili Capi d’opera” […]. Quindi distribuii gli Originali del più eccellente lavoro in uno coi rimasugli della più pregevole antichità dissotterrata dal lezzo dei Magazzini come in Museo nella Piazzola dell’Elaboratorio principale dell’Arsenale ( Foto 2 ) . Sopra le Sale dell’Armamento distribuii tutte l’Armi usate da un solo Uomo nella non meno vaga che utile comparsa che ancora si osserva ( Foto 3 ) . Stesi alla scoperta sopra altri sedimenti tutte le Artiglierie di ferro che prima deperivano rinchiuse nei depositi. Così tutti gli altri corpi ferrei nella gran Corte detta del Brusà ( Foto 4 ) Finalmente disposi tutti gli altri infiniti e vari generi di ogni qualità, spezie e figura nei rispettivi loro depositi nei modi più vantaggiosi alla loro preservazione e che presentò all’occhio dei Forestieri più illustri ed illuminati il Dipartimento Artigliere come il Giardino dell’Arsenale» ( Foto 5 ) . Accompagnavano questa descrizione quattro piccole stampe che oggi rendono facile l’identificazione e l’uso dei luoghi con la loro destinazione e l’allestimento delle Sale d’Armi con le rastrelliere affollate di lance e altre armi da taglio, intramezzate da preziose armature e carte geografiche militari.

L’impegno del Gasperoni si completava con la pubblicazione a sue spese di stampe al tratto di ottima fattura incise su rame da Giuliano Zuliani. Qui erano riportati i disegni di 130 canne di cannone, le opere più meritevoli d’essere ricordate: tra loro reperti delle prime sperimentazioni in artiglieria, oggetti di particolare pregio artistico, memorie di bottini di guerra, esemplari unici fusi in occasione di visite all’Arsenale di importanti ospiti stranieri come quella del Re di Danimarca nel 1711 e quella dell’Imperatore Francesco II nel 1796. Un repertorio di eccellenze balistiche che voleva essere l’orgogliosa dimostrazione della capacità e della forza militare della Serenissima, al tempo oramai inevitabilmente destinata verso la fine della sua parabola storica ( Foto 6-7 )
Dell’Artiglieria Veneta sono state rintracciate una decina di copie, ognuna nella parte manoscritta diversa dall’altra, distribuite nelle biblioteche delle pubbliche istituzioni veneziane e una acquistata dalla Wallace Collection di Londra e consultabile in rete. La più antica è quella del 1779 che Gasperoni dedica al doge Polo Renier con l’aspettativa di un suo intervento per la pubblicazione delle incisioni e dei testi manoscritti con la storia dell’artiglieria veneziana e delle sue più recenti invenzioni. La più recente è quella del 1798, pochi mesi dopo la caduta della Repubblica, che Gasperoni presenta al Feldmaresciallo Conte Oliver Remigius von Wallis, al comando delle milizie austriache a Venezia dopo Campoformido, nella quale il Soprintendente oramai ottuagenario e “giubilato” dal servizio lamenta il saccheggio dell’Arsenale da parte delle truppe francesi durante il loro breve governo della città, operato con la complicità dei militari e delle maestranze locali. Giovanni Casoni, ingegnere presso l’Arsenale e che ne fu autore della prima guida, contava all’epoca 5293 bocche da fuoco, delle quali 2518 in bronzo e altre 2775 in ferro.
Anche gli austriaci non furono da meno e quando nel 1866 lasciarono la città, caricarono sulle loro navi con destinazione Trieste e Pola quanto di ancora riutilizzabile rimaneva della ricca raccolta di artiglierie veneziane.
Oggi qualche pezzo lo si può ancora trovare nel Museo Navale di Venezia, a Parigi, a Copenaghen e al Heeresgeschichtliche Museum di Vienna. Molte altre, censite di recente, sono le bocce da fuoco uscite dalle fonderie dell’Arsenale e ancora rintracciabili nelle fortezze veneziane dello Stato da terra e in quelle dello Stato da mare lungo le coste e le isole dell’Adriatico, dello Jonio e dell’Egeo. Gli edifici che ospitavano il reparto dell’Artiglierie in Arsenale, invece, subirono la sorte di lenta e continua decadenza di tutto il grande complesso storico. Solo alla fine del primo decennio del Duemila, quando la Biennale li prese in carico, tornarono a nuovo uso dopo un rispettoso e funzionale restauro degli spazi e dei materiali per ospitare esposizioni d’arte e architettura di alcuni paesi stranieri e le attività di College dei settori Musica, Danza, Teatro, Cinema.
Ultimo tassello di questo impegnativo progetto è la riqualificazione degli edifici del vicino comparto delle Officine e Magazzino del Ferro, finanziata con 40 milioni di euro dal PNC, Piano Nazionale Complementare al Pnrr, dove dal 2026 saranno trasferiti i materiali dell’Archivio Storico delle Arti Contemporanee (ASAC), ora conservati al Parco scientifico e tecnologico VEGA a Porto Marghera, e realizzati spazi per la loro consultazione, digitalizzazione e catalogazione, unitamente ad attività espositive e del College.

G. CASONI, Guida per l’arsenale di Venezia, Venezia, Antonelli 1829. Ristampa 2011.
G. CASONI, Nota sull’artiglieria veneziana, in Venezia e le sue lagune, Antonelli 1847, Vol. I.
G. DE LUCIA , Le sale d’armi nel Museo dell’Arsenale di Venezia, Artiglierie, Roma, “Rivista Marittima”, 1908.
M. NANI MOCENIGO, Il Museo Storico Navale, in “Rivista mensile della Città di Venezia”, 1922.
M. NANI MOCENIGO, Il reparto artiglieria dell’Arsenale di Venezia, in “Rivista mensile della Città di Venezia”, 1926.
M. NANI MOCENIGO, Storia della Marina veneziana, 1935. Ristampa 2010.
M. MORIN, Alcune note sui fonditori veneziani d’artiglieria del XVI secolo e sulle loro opere, in L’industria artistica del bronzo del Rinascimento a Venezia e nell’Italia Settentrionale, Atti del Convegno Internazionale di Studi. Venezia Fondazione Cini, 23, 24 ottobre 2007. Ship & Gun. Navi e Cannoni. Le artiglierie navali a Venezia e in Europa tra XV e XVII sec. Atti del Convegno, Università di Ca Foscari, 11-12 dic, 2008.
M. MORIN - C. BELTRAME, I Cannoni di Venezia. Artiglierie della Serenissima da fortezze e relitti, 2014.
DEPOSITI DI CANNONI SALE D’ARMI
OFFICINE DEL FERRO



EX MUSEO DELLE ARTIGLIERIE


ARTIGLIERIE
GIARDINO DI FERRO BOMBARDE
Una vera rivoluzione negli spazi espositivi del terzo piano di M9 – Museo del ‘900 di Mestre, in piena sintonia col titolo della mostra Rivoluzione Vedova aperta all’inizio di maggio e che accompagnerà tutta la durata di Biennale Architettura, fino a fine novembre. Questa nuova, importante, anzi fondamentale, mostra all’M9 conferma in maniera inequivocabile quanto questo spazio museale possa rappresentare una chiave di volta per il destino culturale di un intero territorio. Ideata e progettata in pochi mesi da Fondazione Emilio e Annabianca Vedova e coprodotta con M9, curata da Gabriella Belli e allestita in maniera sorprendente dallo Studio Alvisi Kirimoto, la mostra convince anche il visitatore più allenato, perché combina in maniera perfetta gli spazi di oltre 1300 metri quadri liberi da colonne, con le opere esposte, creando una sintesi ideale tra Vedova, il territorio che lo vide cittadino attivo e l’esperienza museale immersiva nella storia del Novecento offerta da M9. Uno spazio pieno per un raffinato percorso espositivo in cui il visitatore può interagire con le opere di Vedova in maniera completamente nuova, rovesciando la fissità museale a favore di una gioiosa vicinanza col genio pittorico di un artista assurto all’olimpo dei grandi del Novecento. Le opere in mostra abbattono l’eresia del limite invalicabile tra la città d’acqua e la terraferma, Vedova è il testimone della scelta possibile di una cultura alta anche in un luogo inusuale in cui le opere non si limitano a un pendolarismo da T1 (la linea tranviaria che conduce da Venezia al centro di Mestre), ma si offrono a una lettura del tutto nuova e sorprendente, quasi fossero delle opere site-specific, perfettamente contestualizzate nel Museo del ‘900.
Come scrive Gabriella Belli nell’introduzione della mostra: «[...] L’attualità di Vedova sta negli universali della sua pittura o, più semplicemente, nel suo messaggio. Valori radicati nel suo esistenziale in dialogo con la storia, intesa come vivere nel presente, “esserci dentro”, misurarne i conflitti e le contraddizioni in una quotidiana dialettica […]. La storia come respiro e vampate della sua pittura, che ha agito all’unisono con le sue battaglie per i diritti civili, il pacifismo, contro l’inganno delle ideologie e la violenza delle dittature, per incalzare il cambiamento, per la difesa di Venezia, la cura dei suoi luoghi più antichi, e molto, molto altro ancora». Luca Molinari, direttore scientifico di M9, aggiunge: «Se il terzo piano di M9 è il luogo di un’esperienza eccezionale, la parte introduttiva – posta al secondo piano – lega idealmente la mostra all’esposizione permanente del Museo. Nei materiali audiovisivi presentati in questa sezione è possibile contestualizzare l’opera e il pensiero di Emilio Vedova dentro il tormentato sviluppo storico novecentesco. Nella storia dell’umanità le rivoluzioni non sono mai accadute per caso, ma sono piuttosto il risultato di una serie di condizioni che trovano le migliori occasioni per esprimersi e raccontare un tempo nuovo. Questo è per noi il senso di Rivoluzione Vedova, un’esperienza eccezionale in un museo innovativo che attraverso le arti persegue nella sua missione di interrogare la storia per meglio comprendere la ricchezza del tempo presente». Un invito a conoscere oppure rivedere con altra luce questo incredibile nuovo approfondimento su Vedova, che dimostra come la sua arte, legata profondamente al suo pensiero e al suo essere persona, sia incredibilmente storia e attualità al contempo, così come lo è M9.
storia come respiro e vampate della sua pittura, che ha agito all’unisono con le sue battaglie...
Averitable revolution at the M9 Museum: its protagonist – art by painter Emilio Vedova in an exhibition co-produced by Fondazione Emilio e Annabianca Vedova and M9 Museum and curated by Gabriella Belli. The beautiful exhibition uses all the 1300 square metres on the museum’s third floor to allow visitors to interact with the art in novel way. The art invites joy and sharing, and will work wonders to join Vedova’s beloved city of Venice with the Mestre, which maintains a growing place of importance in the world of art and architecture exhibitions. Rivoluzione Vedova is itself concurrent with the Architecture Biennale, and will be open until late November. Says Belli: “The
third floor at M9 is a place of amazing experience. The introductory part at the second floor is an ideal link between the Museum’s permanent collection and the current exhibition. Using audio and video resources, we will learn about the art’s context and the artist’s place within the history of twentieth-century art. No revolution ever took place for no reason, rather, they result from conditions that look for the best chances to express and tell the story of a new epoch. This is, for us, the meaning of Rivoluzione Vedova”.

Attraverso il linguaggio dell’arte l’unicità di ciascuno di noi può essere espressa attraverso forme irripetibili che, nell’incontro con gli altri, danno luogo a combinazioni sorprendenti. È questa l’idea da cui parte e si sviluppa The Hungriest Eye. The Blossoming of Potential, la nuova opera dell’artista Arthur Duff che accoglie i visitatori dell’Art Studio, lo spazio dove l’arte dialoga con il sociale nella Casa di The Human Safety Net alle Procuratie Vecchie in Piazza San Marco. L’Art Studio, curato da Luca Massimo Barbero, è uno spazio creativo pensato per accogliere le opere di artisti che interpretano i temi inerenti ai programmi di The Human Safety Net e i valori espressi nella mostra permanente A World of Potential, un’esperienza interattiva e immersiva per comprendere e connettersi con il proprio potenziale, esplorando i punti di forza e scoprendo le qualità migliori in noi stessi e negli altri. Nell’installazione di Arthur Duff ogni visitatore diventa un’opera d’arte: i suoi punti di forza si trasformano in una rappresentazione artistica attraverso l’utilizzo di un sistema laser che crea forme uniche in un caleidoscopio di luci e colori. L’ispirazione sono le straordinarie xilografie giapponesi del XIX secolo raffiguranti fuochi d’artificio che Duff rielabora digitalmente con risultati sorprendenti. Un mondo di meraviglie come ci raccontano Luca Massimo Barbero e Arthur Duff.
Come è nata l’idea di un’opera come The Hungriest Eye?
Luca Massimo Barbero_Tra il 1860 e il 1877 alcuni creatori di meraviglie, qualcuno li chiamava anche “parti di faville”, “occhio”, “porta di fuoco”, arrivando e passando dalla Cina, raffinano una sorta di curiosa scienza percettiva che non nasce però come scienza, ma come qualcosa di meraviglioso. Accade in Giappone e l’opera viene stampata da inglesi; ora rimangono sei volumi conservati nella biblioteca di Fujiyama, nei quali sono raccolte delle xilografie di “schemi delle meraviglie”, o meglio, un vero e proprio catalogo di vendita per dei fuochi d’artificio. Sono delle immagini straordinarie che Arthur Duff, grazie alla sua capacità di usare prima le costellazioni come nodi, poi come riferimento di viaggio, poi ancora come navigazione, infine come viaggio fisico, ha ritrovato e iniziato a studiare proprio quando cominciavamo a pensare a questo progetto. The Hungriest Eye in realtà è un possibile fuoco d’artificio, una fioritura
THE ART STUDIO
The Hungriest Eye. The Blossoming of Potential by Arthur Duff
Fino 10 marzo 2024
The Human Safety Net, Procuratie Vecchie, Piazza San Marco 105 www.thehumansafetynet.org
del potenziale di ognuno di noi. Il tema dell’occhio è sempre stato affrontato da me in maniera aperta, fuori dalle sue strette funzioni primarie; in genere si è portati a pensare sia un organo che serva solo per guardare, ma in realtà sappiamo che l’occhio è sollecitato e deve essere perciò “affamato”.
Perché la scelta di Arthur Duff per la realizzazione di questo particolarissimo progetto?

L.M.B._Duff è americano, nasce in Germania, cresce in Corea, poi di nuovo negli Stati Uniti, a seguire in Italia, poi ritorna all’estero e finalmente lo ritroviamo in Italia. Questo viaggio molto curioso è lo stesso viaggio che sollecita i vari immaginari di questo progetto: l’idea di avere un immaginario giapponese, pensato da un artista internazionale per la città che fa dei fuochi d’artificio uno dei suoi momenti civici e di gloria più grandi. La meraviglia non è soltanto occupare l’occhio; l’occhio deve essere un organo responsabile ed è il motivo per cui siamo qui.
Quale legame si instaura tra l’Art Studio e la Casa che lo ospita, The Human Safety Net?
L.M.B._L’Art Studio è all’interno di un grande ‘naviglio’, come lo chiamo io, restaurato da Chipperfield che si sviluppa in straordinaria lunghezza e con oblò, aperti su Piazza San Marco, che ricordano curiosamente la forma dell’occhio e dell’iride come nell’opera di Duff. Siamo dunque legati all’idea del viaggio; pensiamo a Generali e a The Human Safety Net, a quanti Paesi, quante famiglie, quanti ragazzi, quanti rifugiati sono toccati da questo importante progetto, alla molteplicità dello sguardo come alla molteplicità di questo occhio. The Hungriest Eye. The Blossoming of Potential non è una mostra, è una sorta di “agitatore di pensiero” che va a creare un ponte tra l’arte contemporanea, troppo spesso conchiusa in una curiosa bolla di cristallo meravigliosa ma sospesa in una dimensione a sé e per sé, e ciò che accade qui nella Casa di The Human Safety Net. Non è un’opera che vive eminentemente per farsi contemplare grazie al fascino indubitabile suscitato da questi meravigliosi schemi pirotecnici; è piuttosto un “agitatore”, perché l’opera è essa stessa agitata dal potenziale dei visitatori. Ogni visitatore la costruisce, compiendo l’esperienza lungo tutto questo ‘naviglio’ della potenzia-
lità, dell’incontro, della condivisione. L’idea di base è poter creare la tua stessa visione, la tua stessa opera, di poter occupare il tuo stesso occhio, ma non come succede ora nella contemporaneità: non è l’immagine che ‘mangia’ te, sei tu che la costruisci grazie all’espressione del tuo potenziale. Il potenziale nell’opera d’arte sei tu e più visitatori costruiscono, sommano, vedono questa immagine, più tu vivi. Duff ha dovuto compiere un procedimento complesso per arrivare a questo risultato, trovando infine i punti di incontro e quelli dissonanti tra i nostri mondi.
Quale l’effettiva dinamica relazionale innescata dal progetto?
L.M.B._The Human Safety Net con A World of Potential ha lo scopo di stimolare come dicevamo il potenziale umano, così come fa l’opera di Duff. Mi trovo in un luogo in cui accade veramente qualcosa, un luogo proattivo, dove la gente può sperimentare, mettersi in gioco e dove può anche incontrare un’opera d’arte, certo, la quale però vive perché sei tu che la crei. L’opera è un dispositivo, un agitatore, un motivo non una scusa; non è una didascalia, è un punto di domanda. Questo spazio, una sorta di vera meraviglia in questa città, non esclude l’antico ma ce lo mostra ancora meglio, invitandoci a non avere paura del contemporaneo.
Come e dove nasce l’ispirazione per la realizzazione di quest’opera?


Arthur Duff_Il progetto è un’opportunità unica per investigare gli aspetti invisibili degli oggetti d’arte come sistemi interconnessi fisici e non fisici. Ho sempre desiderato, come credo tutti del resto, guardare direttamente il sole, ma questo non è possibile. Questa grande attrazione e desiderio verso il sole da un lato e il timore a guardarlo dall’altro rappresentano insieme il punto di partenza di questo progetto. Volevo dare al visitatore la possibilità di osservare qualcosa che avesse un’intensità unica, con delle frequenze di luce e di saturazione di colore che noi probabilmente non avevamo mai visto prima, perché non possediamo fonti di luce di questo genere. L’opera utilizza un sistema laser per creare forme uniche in un caleidoscopio di luci. L’ispirazione nasce dalle xilografie giapponesi ottocentesche raffiguranti i fuochi d’artificio, emblema di un ideale di bellezza effimera e transitoria, pensati per sbalordire e sorprendere


l’occhio di chi guarda. L’opera quindi nasce dall’esigenza di generare stupore, ma anche di sfruttare tale stupore. Lo stupore diventa un modo per unire e creare comunità. Una delle cose più importanti e una delle sfide maggiori di questo lavoro è stato proprio cedere qualcosa come artista, perché stavo entrando in uno spazio non neutrale, con una mission assolutamente dichiarata quale è quella della Casa di The Human Safety Net.

Mi sono trovato come artista di fronte alla necessità di andare incontro e di includere alcuni degli aspetti che sono presenti nel percorso permanente e interattivo della mostra A World of Potential. È un dare e ricevere. La parte più complessa, ma anche la più costruttiva di tutto il processo creativo, è stata quella di riuscire a coinvolgere attivamente il pubblico nel percorso che abbiamo messo in atto, permettendogli di interagire con il lavoro, di esserne realmente parte integrante. In questa precisa direzione si è rivelato necessario utilizzare ciò che era già presente nelle installazioni permanenti.
Quale significato assume il titolo?
A.D._“L’occhio affamato” è un occhio che sa vedere, sa osservare, non si ferma mai perché è fatto per fare quello, è costruito e generato come organo per assorbire e ‘digerire’ e nell’atto di digerire dare anche energia e vitalità; non è mai passivo. Un occhio che ambisce non solo ad essere il punto di passaggio di uno stimolo percettivo, ma che vuole anche essere partecipe dell’elaborazione dell’esperienza.
Uno sguardo che sembra sollecitare dinamicamente la relazione tra individuo e collettività.
A.D._Il passaggio tra l’esperienza individuale, che in termini pratici si svolge esplorando il proprio potenziale grazie al percorso della mostra interattiva e la compilazione di un questionario finale, e la produzione di un punto di forza personale, che viene introdotto nel sistema che abbiamo generato, produce un’immagine basata sugli schemi dei fuochi d’artificio. Il visitatore produce un’immagine estremamente individuale; il resto del pubblico lo testimonia, partecipa, osserva, interagisce e assorbe. Il progetto è volutamente costruito per permettere all’individuo di attuare uno scambio con l’altro, con il resto del pubblico. The Hungriest Eye è quindi un’esperienza individuale e al tempo stesso collettiva.

Intervista Barbara Casavecchia di Mariachiara Marzari
Ocean Space è letteralmente un oceano, o meglio, tanti mari che si espandono al ritmo delle onde, contaminando la città di Venezia, la sua Laguna, il Mediterraneo, anzi, i Mediterranei, luoghi plurali e policentrici di produzione della conoscenza. TBA21–Academy ha da poco inaugurato Thus waves come in pairs (Le onde vengono a due a due), il cui titolo è tratto dal poema Sea and Fog (Mare e nebbia) di Etel Adnan. Questa nuova mostra di Ocean Space nell’ex Chiesa di San Lorenzo sottolinea la necessità di riflettere con e attraverso la pluralità e gli scambi, elementi distintivi del terzo ciclo della fellowship curatoriale The Current III (2021-23), a cura di Barbara Casavecchia.
Due nuove commissioni affidate all’artista americanolibanese, residente a Parigi, Simone Fattal e al duo artistico berlinese Petrit Halilaj & Álvaro Urbano (quest’ultima co-commissionata da TBA21–Academy e Audemars Piguet Contemporary) raccontano storie di futuri immaginari in cui la nostra comprensione del mondo è trasformata dall’incontro con altre specie, invitando ad ascoltare la molteplicità di intelligenze.
Simone Fattal occupa l’ala Est della Chiesa con l’installazione Sempre il mare, uomo libero, amerai! dalla poesia L’uomo e il mare di Charles Baudelaire. Un percorso dove singole opere creano una narrazione a più livelli di interpretazione. Qui lo spazio monumentale sembra quasi sovrastare l’intervento artistico, in realtà amplificandone il significato. Una parte poetica, riflessiva, concettuale. L’ala Ovest è invece ‘occupata’ dall’installazione avvolgente di Petrit Halilaj & Álvaro Urbano che accoglie il visitatore appena entrato in Ocean Space. La bellissima performance dell’inaugurazione ha amplificato l’identità progettuale di questo lavoro collettivo, nell’intento programmatico di manifestare il comune legame che lega tutti noi attraverso un percorso composito fatto di storia, vissuto personale, arte, musica. Questa parte della mostra è fantastica, mitologica, ancestrale e futuristica al contempo. Mostra che abbiamo avuto il privilegio di visitare con Barbara Casavecchia, curatrice indipendente, scrittrice e docente, che vive tra Venezia e Milano.
Thus waves come in pairs è un verso del poema Sea and Fog di Etel Adnan. Quale ispirazione ha tratto da questo poema? E quale significato assume nel definire il carattere della mostra?
Thus waves come in pairs è il titolo che ho scelto non solo per la mostra, ma per l’intero ciclo triennale di The Current III, la fellowship curatoriale promossa da TBA21–Academy e incentrata sui Mediterranei che ho avuto l’onore di curare a partire dal 2021. Quel verso di Etel Adnan ha ispirato una metodologia di lavoro e di ricerca fondata sulla molteplicità, le collaborazioni e le condivisioni con artisti, scienziate e attivisti, a partire dalle riflessioni sulla crisi climatica in atto e le narrazioni troppo spesso univoche (e occidentali) che utilizziamo per descriverla. Se è vero come è vero che il bacino del Mediterraneo è la zona del Pianeta dove i cambiamenti in atto si stanno manifestando a una velocità del venti per cento superiore rispetto ad ogni altra area, perché allora, per esempio, non ascoltiamo più spesso le voci e le esperienze di quanti convivono da tempo con una condizione di aridità e di aumento estremo delle temperature? Con quanti Mediterranei passati, presenti e futuri abbiamo la necessità di confrontarci per trovare delle soluzioni condivise? Riguardo allo specifico della mostra, quel verso è stato importante anche per dialogare con l’architettura particolarissima che ospita Ocean Space, vale a dire la ex Chiesa di San Lorenzo a Venezia, edificata in pianta quadrata divisa a metà da un grande altare bifronte così che lo spazio risulta composto da due metà gemelle e speculari. Invitando ad occupare questi straordinari spazi Simone Fattal, compagna di Etel Adnan da tutta la vita, insieme a Petrit Halilaj e Álvaro Urbano, anch’essi partner nel lavoro e nella vita, ho desiderato sottolineare come sia solo attraverso la pluralità che possiamo intervenire sugli immaginari.


Questa mostra è la terza parte di un progetto più ampio, anzi di un programma triennale di fellowship curatoriale che TBA21 sta sviluppando qui a Venezia e che pone l’Oceano, ma più nello specifico il mar Mediterraneo, come fulcro di riflessioni contemporanee attraverso i linguaggi dell’arte. Cosa ha inteso perseguire con The Current e quali sono le evidenze finali di questo percorso?

The Current III ha assunto molte forme: dalle conversazioni itineranti, che ci stanno portando in giro per la città e la laguna di Venezia da tre anni al fine di sviluppare e affinare le nostre capacità di percepire i cambiamenti in atto, entrando in contatto diretto con le barene, le correnti, le dune, le altre specie animali, a due cicli semestrali di conferenze e dibattiti della Ocean/UNI, piattaforma digitale ad accesso libero promossa da TBA21–Academy, intitolati Immagina l’oceano secco come lavanda (da una poesia di Andrée Chedid), o ancora alle commissioni ad artisti quali il veneziano Giorgio Andreotta Calò, che nel 2021 ha coperto a piedi l’intero perimetro della laguna nell’arco di una decina di roventi giorni estivi, provando a percorrere – e quindi marcare, registrare – con il proprio corpo la linea di separazione tra terra e acqua che muta costantemente con il ciclo delle stagioni e delle maree, ma anche per effetto delle azioni entropiche e della distruzione dell’ecosistema. Tra i tanti esiti di questi tre anni di lavoro c’è anche un libro a mia cura: Thus Waves Come in Pairs. Thinking with the Mediterraneans (edito da TBA21 insieme a Sternberg Press), che raccoglie una conversazione inedita tra Etel Adnan e Simone Fattal e testi realizzati per l’occasione da autori e autrici con i quali abbiamo collaborato e che hanno qui risposto in modo inedito ai temi
Ocean Space is an ocean – literally. Or multiple, as many as are the waters that touch Venice, its Lagoon, the Mediterranean(s) that are plural, polycentric loci of the culture industry. TBA21–Academy has recently opened Thus waves come in pairs, a title taken from Etel Adnan’s poem Sea and Fog. The exhibition shows the need to reflect on, and with, plurality in our exchanges.
Ocean Space commissioned Lebanese-American artist Simone Fattal and Berlin-based art duo Petrit Halilaj & Álvaro Urbano the installation of art and stories of imaginary futures where our understanding of the world is shaped by our encounters with other species, inviting us to listen to a plurality of intelligence.
Fattal’s art occupied the Church’s east wing. Several pieces will define a narrative that can be interpreted at multiple levels. Monumental spaces seem to dominate the art, but in fact, they amplify its message.

The west wing houses Halilaj’s and Urbano’s installation. The beautiful inauguration performance amplified the identity of this collective art, with the intent of showing the common ground we share, a common ground of history, stories, art, music. This par of the exhibition is fantastic and mythical, ancestral and futuristic all at once. We discussed it with curator, author, and teacher Barbara Casavecchia.
Thus waves come in pairs is the title I picked not only for the exhibition, but for the whole three-year cycle of The Current III, the curatorship programme sponsored by TBA21–Academy that I have been managing since 2021. That verse by Etel Adnan inspired my work and my research with the concept of plurality: collaboration and sharing with other artists, scientists, activists, starting with reflection on the climate crisis and the narratives we use to describe them, which are all too often one-sided – too western. If change takes place in the Mediterranean at a speed 20% higher than in other parts of the world, why don’t we give more weight to the voices and the experience of those who fought for a longer time with dry weather and extreme temperatures? How many past, present, and future Mediterraneans do we need to confront before we find a shared solution? Specifically, the exhibition will take place at the San Lorenzo Church in Venice, a square church divided in two twin halves. These spaces have been entrusted to Simone Fattal, Etel Adnan’s partner in work and life, and to Petrit Halilaj and Álvaro Urbano, again, partners in both life and work. My goal is to show how plurality is the only way art can affect us.


di quella prima riflessione a due voci. La grafica è dello studio Bruno, con sede a Venezia, come del resto Grafiche Veneziane, che lo ha stampato, perché è importante lavorare in situ.
La Chiesa di San Lorenzo con la sua storia e la sua importante monumentalità si fa spazio di dialogo con gli artisti Simone Fattal e Petrit Halilaj & Álvaro Urbano. Da un lato un dialogo netto con l’altare, dall’altro la citazione dell’uovo sospeso all’interno dell’arco della chiesa, che ricorda immediatamente Piero della Francesca. Come gli artisti sono stati chiamati a confrontarsi in maniera viva con lo spazio?
Per me è stato importante invitare gli artisti a misurarsi con il tema della narrazione dei Mediterranei e dei loro mutamenti in corso, ancor prima che con l’architettura. Simone ha scelto di farci riflettere sulla stratificazione delle culture e dei passati, inclusi quelli coloniali: il testo del Contrasto della Zerbitana, inciso sottilmente sulle sfere rosa perlacee che l’artista ha realizzato a Murano, inscena la disputa tra una donna dell’isola di Gerba, lungo la costa tunisina, e il marinaio occidentale che ha abusato di sua figlia perché protetto dalla flotta di occupazione e che minaccia di conciare anche lei per le feste, se oserà cacciarlo di casa. Risale alla fine del Duecento, ribadendo eloquentemente il riproporsi invariato di queste forme di violenza, ed è scritto in “lingua franca”, una lingua meticcia parlata per secoli lungo tutte le coste mediterranee e in particolare nei porti, utilizzata nel commercio di beni di ogni genere, compreso quello di esseri umani.
La schiavitù ha avuto un ruolo determinante nello sviluppo della modernità europea e non, anche se spesso si preferisce eludere l’argomento. Un titolo come Sempre il mare, uomo libero, amerai! apre la porta a tante interpretazioni. Creando un gruppo di creature animali metamorfiche che usano il suono per comunicare, gravitando attorno a una grande ‘Luna’ sospesa – è così che si intitola la scultura ovoidale che pende dal soffitto di Ocean Space –, Petrit e Álvaro hanno lavorato sulla costruzione di forme di vita in evoluzione e trasformazione, dalle quali possono emergere futuri queer e alternativi. L’uovo è non solo il mezzo attraverso cui moltissime specie di vita si riproducono sul nostro Pianeta, negli oceani come sulle porzioni terrestri, ma anche il simbolo alla base di tante cosmologie e miti della creazione. Nella performance iniziale gli artisti hanno invitato musicisti e danzatori ad animare le sculture, rendendone percepibile il grido di protesta, che non è solo dolente, ma anche gioioso e carico di energia. L’aver distribuito la melodia di Ay mi pescadito su due strumenti/pesci/sculture diversi fa sì che la si possa ricostruire appieno solo coordinandone i movimenti. Imparare a sintonizzare le azioni comuni è necessario se vogliamo cambiare le cose.
Un’ultima annotazione: l’allusione al nuotare, alla incredibile sensazione di essere parte del mare e in particolare del Mediterraneo. Questo atto assume un forte valore simbolico e poetico, ma allo stesso tempo drammatico se rapportato alla realtà quotidiana del nostro tempo. Cosa rimane oggi dell’identità, dell’essenza profonda dei mondi mediterranei?
È una domanda alla quale credo sia impossibile rispondere. Non tutto si muove allo stesso ritmo, non tutti i racconti dei mondi mediterranei e delle condizioni geopolitiche che ne informano il presente ricevono pari ascolto. L’identità individuale e quella collettiva sono in costante mutazione, movimento e trasformazione, come ci insegnano le onde.
The Current III is a diverse programme of itinerant conversations that will take us around Venice and its lagoon to fine-tune our perception of change and establish a direct contact with all the natural phenomena that occur here. It also includes two six-month programmes of meetings and debates at Ocean/ UNI, our digital platform, called Immagina l’oceano secco come lavanda (lit. ‘imagine if oceans were dry as lavander’), from a poem by Andrée Chedid, and commissions to artists. In summer 2021, artist Giorgio Andreotta Calò walked around the Venetian lagoon – he marked, he recorded, using his body, the separation line between land and water, which changes constantly with the rhythm of seasons and tide, though also as a consequence of human activity and the destruction of the ecosystem.
I curated a book, Thus Waves Come in Pairs. Thinking with the Mediterraneans, that includes a conversation between Edel Adnan and Simone Fattal as well as contributions with other authors. The book has been edited, illustrated, and printed in Venice.
For me, it has been very important to invite the artists to confront the narratives of the Mediterraneans and the ongoing change that affects them, more so than the architecture. Simone Fattal chose to make us reflect on the stratification of cultures, including colonial cultures: her story, written on pink glass beads made in Murano, is the story of a woman from the island of Djerba, Tunisia, and the western sailor who raped her daughter, protected by the occupation contingent. The story dates back to the thirteenth century, which sadly shows how often such events keep happening, and is written in lingua franca, the pidgin language once spoken in the Mediterranean basin. Slavery has always conditioned the development of European modernity, even though we often gloss over the issue. A title such as Sempre il mare, uomo libero, amerai! (lit. ‘forever the sea, you free man, will love!’) is open to interpretation.
A set of metamorphic animal sculptures use sound to communicate, gravitating around a suspended ‘Moon’ – that’s what we call the oval sculpture hanging from the ceiling at Ocean Space. Halilaj and Urbano worked on evolving, transforming life forms that foster queer, alternative futures. The egg is not only the way so many life forms reproduce on earth, but a symbol of cosmology and creation myth. In the inauguration performance, the artists invited musicians and dancers to animate the sculptures, allowing their cry of protest to be heard. It is not merely an aching cry, it is also joyful and energetic. A melody, Ay mi pescadito, forces all motions to coordinate. We must learn how to work together if we want things to change.
What remains, today, of a common Mediterranean identity
I don’t believe this question has, or can have, an answer. Not everything moves at the same pace, not all Mediterranean stories and histories are received in the same way. Individual and collective identities never stop changing. They move and transform, like waves.


Se non l’avete ancora fatto, vi consigliamo di visitare la mostra Vittore Carpaccio. Dipinti e disegni, aperta fino al 18 giugno a Palazzo Ducale. Pur con qualche importante mancanza, l’occasione è certamente imperdibile. Da parte nostra è un pretesto e uno stimolo per indagare e approfondire attraverso alcune opere emblematiche (nello scorso numero le celebri Due Dame ) le innumerevoli sfumature di un Maestro assoluto della pittura veneziana. In particolare, la nostra attenzione si sofferma ora sull’ultima stagione pittorica di Carpaccio, documentata nella mostra da un’opera straordinaria e grandiosa (190x134 centimetri): il San Paolo apostolo, firmato e datato 1520, proveniente dalla Chiesa di San Domenico a Chioggia. La tensione nell’imponente figura del Santo trova il suo culmine nel volto segnato e cotto dal sole, carico di una nuova e realistica espressività, testimone della piena maturità del Maestro. L’iconografia, interessante e inedita nel repertorio di questo Santo, è l’argomento della nostra indagine grazie alla lettura del soggetto fatta da Augusto Gentili (e a noi gentilmente concessa) nel catalogo della mostra Carpaccio. Vittore e Benedetto da Venezia all’Istria, Conegliano 2015.
 Franca Lugato
Franca Lugato
«[...] Paolo, collocato in un prato moderatamente fiorito ma anche attraversato dagli aridi sentieri della vita virtuosa e difficile dell’apostolo, si presenta con i consueti attributi del libro e della spada. Il libro è però insolitamente aperto e la pagina ben leggibile riporta due versetti della lettera ai Galati (2, 20: Vivo ego jam non ego vivit vero in me Christus; 6, 17: Stigmata Jesu Christi in corpore meo porto ), interpretati in immagine con l’eccezionale dettaglio del crocifisso piantato nel cuore di Paolo. Il pittore, per quel che gli compete, dichiara la sua adesione al dettato paolino scegliendo come cartellino una lettera accuratamente piegata. Questo San Paolo che porta nel suo corpo le ferite di Cristo, con l’immagine del crocifisso e le parole del libro, rimanda a una storia importante di politica della devozione, di lontana origine ma di infinita attualità: l’impegno dei domenicani per sottrarre a Francesco e ai francescani l’esclusiva delle stimmate, rivendicando per Paolo le mistiche piaghe – proprio sulla scorta di Galati 6, 17 – in modo da creare un precedente “giuridico”, autorevole quanto neutrale, per quelle presunte di Caterina da Siena. Il “processo castellano”, che negli anni 1411-
1416 avvia il percorso di canonizzazione di Caterina, gloriosamente concluso nel 1461, è così denominato perché si tenne in Venezia nel convento dei domenicani osservanti di San Domenico di Castello. Ne fu protagonista il frate Tommaso Caffarini, senese anche lui, che tra le altre cose si preoccupò di riassumere in una Legenda minor la biografia cateriniana di Raimondo da Capua – ovviamente Legenda maior (1398) – integrandola inoltre con un Supplementum; la sua minuziosa deposizione al processo diventò un vero e proprio trattato sulle stimmate. Il nodo della faccenda sta in un paio di distinzioni prevedibilmente cavillosissime: Francesco riceve le stimmate, Paolo – è lui stesso a dichiararlo – le porta; le stimmate di Francesco sono visibili, quelle di Paolo sono invisibili. Le stimmate di Caterina sono portate e invisibili come quelle di Paolo. È possibile che il San Paolo di Carpaccio si trovasse in origine nel luogo più appropriato, San Domenico di Castello, e che passasse poi in San Domenico di Chioggia, presidio anche questo dell’osservanza domenicana; come è possibile che fosse pensato fin dall’inizio per quest’ultima sede. Nessuna di queste possibilità è peraltro sostenuta da prove documentarie, anche se una di esse è senza dubbio quella buona. Resta che l’ultimo e tanto maltrattato Carpaccio è ancora al massimo dell’impegno di invenzione e di esecuzione – come ormai dovremmo aver capito – quando è chiamato a lavorare in un contesto di dibattito culturale ad alto livello, e sollecitato a dir la sua, non come testimone passivo ma come interprete consapevole».

Il titolo Icônes evoca mondi lontani e straordinariamente vicini, mettendo in relazione l’idea mistica e contemplativa del passato bizantino, splendente, orientale e ieratico, con il tema dell’immagine nella contemporaneità. Preziosità, smaterializzazione, luce, divinità, ricchezza, meditazione, bianco e nero, luci e ombre, l’Oriente e Venezia: tutte dimensioni che si incontrano e si intrecciano intrigantemente in questa riuscitissima mostra, curata da Emma Lavigne, direttrice della Pinault Collection, e Bruno Racine, direttore e amministratore delegato di Palazzo Grassi – Punta della Dogana. L’immagine – la sua capacità di rappresentare una presenza, tra apparizione e sparizione, ombra e luce, e di generare un’emozione – è al centro dell’indagine degli artisti selezionati. Un percorso che vede le meravigliose icone antiche trasfigurarsi idealmente nei linguaggi dell’arte contemporanea e moltiplicate l’orizzonte aperto e vibrante della nostra percezione. Le 80 opere degli artisti contemporanei poste ad una ad una nei magnifici spazi di Punta della Dogana sono i capisaldi della Pinault Collection. Queste opere poste in dialogo in modo impeccabile con le architetture, emozionano e trasportano il visitatore in una dimensione “altra”, meditativa, onirica, dai mille e più riferimenti. Assolutamente da vedere.
ENG With a title evoking worlds distant yet extraordinarily close, an exhibition that contrasts the mystical, contemplative idea of the Byzantine past resplendent, oriental and hieratic –with the theme of the image in the modern world. Preciousness, dematerialization, light, divinity, wealth, meditation, black and white, lights and shadows, the Orient and Venice: dimensions that meet and intertwine intriguingly in this wonderful exhibition along an itinerary that sees splendid ancient icons find space and multiply in the open and vibrant horizons of modernity. The 80 works by the selected artists from the Pinault Collection interact flawlessly and movingly, transporting the visitor into an “other” dimension, meditative, dreamlike and evocative.
ICÔNES
Fino 26 novembre Punta della Dogana, Dorsoduro 2 www.pinaultcollection.com

«L’arte mi ha donato molto – racconta Gemma De Angelis Testa – e con essa la mia vita è stata felice. Mi sono sempre adoperata nel promuovere gli artisti affinché avessero una loro visibilità, e negli ultimi anni ho pensato fosse arrivato il momento di dare loro un futuro». Il futuro per Gemma De Angelis Testa è un’eccezionale donazione a Ca’ Pesaro, che arricchisce, completa e integra in senso contemporaneo e consistente la collezione della Galleria d’Arte Moderna, a partire dal 1950 fino alla scena artistica contemporanea nazionale e internazionale.
Le scelte e i percorsi della collezionista si sono sviluppati in dialogo continuo con la produzione del marito, Armando Testa. «“Ogni attrazione è reciproca” scrive Goethe nel famoso romanzo Le affinità elettive, un libro di iniziazione all’esperienza sentimentale fondata sull’alchimia dell’amore: in tutte le relazioni, crede Goethe, l’assonanza fisica e spirituale agisce come un potente aggregatore delle differenze, annullando ogni barriera. Ed è così che possiamo raccontare al pubblico la collezione di Gemma De Angelis Testa» afferma Gabriella Belli, curatrice della mostra e del catalogo con Elisabetta Barisoni. Stiamo parlando di opere di artisti quali Kiefer, De Dominicis, Clemente, Cucchi, Schifano, Cragg, Spalletti, Rauschenberg, Twombly, Merz, Pistoletto, Calzolari, Zorio, Abramovic, Beecroft, Hofer, Mori, Neshat, Kentridge, Ofili, Paci, Do-Ho Suh, Chen Zhen, Vezzoli, Viola, Ai Weiwei e molti altri. Lavori che abbracciano tecniche, culture e geografie diverse, restituendo a Ca’ Pesaro un posto centrale nella contemporaneità. M.M.
ENG “Art gave me so much – says Gemma De Angelis Testa – and my life is better with it. I worked hard to sponsor artists and give them visibility, and I have been thinking it’s time to give them a future.” The future, thanks to Gemma De Angelis Testa, looks like a generous donation to the Venice International Gallery of Modern Art at Ca’ Pesaro that enriches and integrates the collection with pieces ranging from the 1950s to the present day. The collector’s choices developed in continuous dialogue with her husband’s own art production. In the words of curator Gabriella Belli: “All attraction is mutual, said Goethe. In all relationships, physical and spiritual concord acts as a powerful aggregator of differences, and tears all walls down. A beautiful legacy of an enlightened collector.”
Angelis Testa Fino 17 settembre Ca’ Pesaro, Galleria Internazionale d’Arte Moderna, Santa Croce 2076 capesaro.visitmuve.it

Il tempo è diventato un tema unificante e globale: accomuna le azioni e i destini di tutte le persone che abitano il mondo a ogni latitudine e longitudine. “Parlare del tempo” significa, oggi, parlare e avere cura del futuro dell’intera umanità. Parte da qui il nuovo originale progetto di Fondazione Prada a Venezia, un’indagine che segue le tracce delle precedenti mostre per affrontare ad ampio raggio le sfide culturali e sociali della contemporaneità attraverso gli strumenti integrati della scienza e della creazione artistica. Everybody Talks
About the Weather è una mostra di ricerca, ideata dal curatore-filosofo Dieter Roelstraete, che esplora i significati del tempo meteorologico nell’arte visiva, prendendo le condizioni atmosferiche come punto di partenza per esaminare l’emergenza climatica in corso. Il tempo e il clima sono normalmente l’argomento di due discipline scientifiche distinte: la meteorologia e la climatologia. Al contrario, la mostra stabilisce volutamente un’equazione empirica tra i due oggetti di studio, utilizzando la doppia lente dell’arte visiva e della scienza. Più di 50 opere di artisti contemporanei e una selezione complementare di lavori storici tracciano i vari modi in cui il clima e il tempo hanno plasmato le nostre identità culturali e come l’umanità ha affrontato la nostra esposizione quotidiana agli eventi meteorologici.
A creare l’allestimento è stato chiamato lo studio newyorkese 2x4, che ha creato un intreccio tra la dimensione artistica del progetto e una serie di approfondimenti scientifici sviluppati in collaborazione con il New Institute Centre For Environmental Humanities (NICHE) dell’Università Ca’ Foscari di Venezia. Everybody Talks About the Weather si sviluppa su due livelli, il piano terra e il primo piano di Ca’ Corner della Regina, intrecciando le due dimensioni della ricerca: la mostra apre con un grande ledwall che trasmette in loop le previsioni del tempo estratte da media tradizionali e online di tutto il mondo. Al primo piano opere d’arte storiche e contemporanee rivelano la costante attenzione degli artisti nel “parlare del tempo”, dai dipinti allegorici e le pitture en plein air alle recenti installazioni multimediali e all’attivismo transnazionale. Una selezione delle opere in mostra è accostata a testi e informazioni grafiche che includono brevi introduzioni agli artisti e ai loro lavori associate a grafici, immagini e dati scientifici. Questa seconda lettura alternativa offre una visione approfondita dei fenomeni fisici e dei processi ambientali evocati o esplicitamente affrontati dagli artisti e relativi a diversi periodi della storia umana (dalla piccola era glaciale, dal XVI al XIX secolo, al futuro di Venezia alla fine del XXI secolo) e ad aree geografiche e culture lontane (dalla desertificazione e l’espansione del Sahara all’impatto del ritiro dei ghiacci artici sulla vita degli Inuit).
Una serie di “stazioni di ricerca” riuniscono più di 500 libri, pubblicazioni scientifiche e articoli, oltre a una selezione di materiali video e interviste con studiosi e attivisti. Questi materiali permetteranno al pubblico di consultare liberamente le varie fonti bibliografiche della vasta ricerca alla base di questo progetto e di approfondire le questioni scientifiche e culturali affrontate dalla mostra.
Weather became a unifying, global topic. To talk of the weather, today, means to talk of the care and future of the whole mankind. This is the basis for Fondazione Prada’s new project in Venice, an investigation that, following their earlier exhibitions, focuses on the cultural and societal challenges using the integrated tools of science and artistic creation. Everybody Talks about the Weather is a research art project curated by philosopher Dieter Roelstraete that explores what the weather means to art. Over fifty pieces from modern and older artists blend into one scientific view on climate and weather. The exhibit has been produced by New York-based studio 2x4 in cooperation with the New Institute Centre for Environmental Humanities (NICHE) of Venice’s Ca’ Foscari University. A collection of 500 books, publications, and articles complements the project.
Venezia vista attraverso i graticci delle fabbriche di Marghera. Una visione rovesciata, inattesa, rispetto all’immagine patinata da cartolina; dalla terraferma grigia, fumosa degli altiforni e delle ciminiere, ai campanili e ai tetti veneziani che si stagliano in cieli ariosi, tersi e luminosi. Bianchi e neri dove è riconoscibile una sagoma industriale appena accennata, ma dove anche si respira la fatica del lavoro; sono i Cantieri e le Fabbriche, opere realizzate dal 1950 al 1953, da cui parte la mostra Edmondo Bacci. L’energia della luce, in corso alla Collezione Peggy Guggenheim. Uno straordinario viaggio che la curatrice Chiara Bertola propone quale doveroso, meritato, omaggio ad un artista che alla tradizione della sua città ha legato la sua pittura. Un’ottantina tra tele e disegni, raffinatissimi e in parte inediti, un vero e proprio tuffo nel colore, provenienti da collezioni private e prestigiosi prestiti da oltreoceano. Edmondo Bacci (1913–1978) dopo la scuola d’arte ai Carmini, si formò all’Accademia di Belle Arti con Virgilio Guidi che frequentò dal 1933 al ‘35 prima che il maestro romano, veneziano d’adozione, si trasferisse a Bologna; da lui apprese la concezione della luce come immanente alle cose, pervasiva dall’interno sulle forme, una luce che diviene mentale e che costruisce lo spazio. Non riconoscendosi nelle espressioni figurative di quei difficili anni a cavallo della guerra, che non aiutavano a capire i disastri che si stavano vivendo, partecipò all’azzeramento dei linguaggi introdotto dal Fronte Nuovo delle Arti tra il 1945 e ‘53. E mentre Venezia era il centro mondiale dell’arte, fu assorbito dalle atmosfere fuligginose della zona industriale, così quelle sagome ortogonali, giocate inizialmente nei toni a carboncino a suggerire proprio la traccia del fumo del carbone, arrivano a prendere fuoco fino ad accendersi, divenendo fiammate di colore che stempera e scioglie ogni residuo compositivo; quasi ad attrarre lo sguardo verso una fonte di calore interna al quadro, via via sempre più sfumato ed evanescente. «Dalla città operosa della fabbrica, alla città lagunare da cartolina», come scrisse Giuseppe Marchiori. Ma in quegli anni avvenne un incontro che si rivelò fondamentale nella sua vita.
«I suoi quadri sono la bomba atomica su tela... la sua pittura è un’esplosione che mette un fuoco lirico nel mondo». Peggy Guggenheim, straordinaria e lungimirante talent scout, aveva colto la forza espressiva della pittura di Edmondo Bacci e, seppur non fosse riuscita a scalfire la timidezza di quel “misterioso, piccolo uomo” che abitava ad un ponte di distanza da casa sua, le sue opere, quelle sì, le aveva capite e sapeva leggerle. «Scoppiano di luce, di energia e colore... c’è una veggenza nel colore il quale esplode in tutta la sua gioiosa ebrezza... potrei suggerire Kandinsky per un’eguale potenza poetica». Con queste parole lo presentò nel catalogo della XXIX Biennale del 1958, momento topico nella carriera dell’artista; per il suo palazzo sul Canal Grande Peggy Guggenheim acquistò sue opere in continuazione, rimpiazzando ogni volta i quadri che vendeva ai collezionisti americani di passaggio in Laguna e che da lei si facevano consigliare.
Di fronte alle sue opere via via lo sguardo si tuffa nel colore che invade la tela; nelle Albe e negli Avvenimenti si apre allo spazio
sfaldandosi come fosse esploso, incontrollato al solo tocco del pennello. In realtà nel suo espandersi irruento e materico rappresenta trasfigurata la fenomenologia dell’evento. E a svelare come Bacci fosse perfettamente inserito nel dibattito di quegli anni lagunari, che non prescindeva da quello internazionale e milanese portato avanti da Fontana sulle righe del Manifiesto Blanco, resta a testimoniarlo il confronto tra lo spazio-luce di Guidi, lo spazio-energia di Vedova e lo spazio-tempo di Deluigi; laddove per Bacci invece si poteva intuire come fosse spazio-colore. Fiammate che nelle Albe diventano esplosioni “piene di luce, di aria e sole”, mentre negli Avvenimenti riportano sulla tela quelle sfumature atmosferiche dei tramonti veneziani rosso-acceso che si specchiano nel blu-verde della laguna. Dunque, anni magici di un successo straordinario – poi purtroppo, come è avvenuto per altri artisti veneziani, inspiegabilmente non replicato anzi totalmente disperso – che lo vide nel 1956 approdare nel cuore di New York con quindici opere in una mostra voluta da Alfred Barr, all’epoca direttore del MoMA; museo che oggi ha prestato alla mostra Avvenimento #13, capolavoro fondamentale tornato straordinariamente a Venezia per quest’occasione. Intorno alla metà degli anni ‘60 Bacci si dedicò alla sperimentazione di nuove tecniche che portò sulle tele in chiave cinetica e programmata, con l’introduzione dal 1968 di nuovi materiali come polistirolo, acciaio, carte bruciate, legno, stoffa, opere in cui l’esperienza spaziale si offre a una diversa tattilità visiva tanto che il calore della pittura diviene mentale, ragionata freddezza. Suggestiva la ricreazione in mostra di una sorta di percorso espositivo documentaristico con cataloghi d’epoca, inviti, chicche tra le quali un menù del Ristorante La Colomba, dove un sole giallo si perde in uno scoppio pulviscolare di colori primari, e rassegne stampa usciti dall’archivio del pittore, a ricostruire quell’epoca d’oro per Venezia e per i suoi più proficui maestri, appoggiati da critici, collezionisti e galleristi che ne valorizzarono i talenti: da Marchiori ad Ambrosini, da Carrain a Deana, ai fratelli Cardazzo alla stessa Peggy. A chiudere questo straordinario viaggio nello spazio del colore è Avvenimento #31- Esplosione, un’opera che sembra inghiottire un cielo tiepolesco: in un vortice di luce bianca, trasparente tanto da sembrare liquida, lo sguardo viene risucchiato dal sottinsù in una pluralità di punti mobili. Omaggio al Maestro del Settecento veneziano di cui da ragazzo Edmondo Bacci aveva restaurato il grandioso affresco distrutto nella chiesa degli Scalzi. Lui stesso, nel ricordare i suoi anni da chierichetto, raccontava di come amasse in quei luoghi perdersi con lo sguardo, rapito nell’infinito di quei cieli chiari e luminosi. Non a caso Toni Toniato lo definì “arcangelo del colore” e le sue opere “un’odissea della visione”. Michela Luce ENG The first and most extensive retrospective dedicated to Venetian artist Edmondo Bacci (1913 – 1978), this exhibition focuses primarily on the 1950s, the most lyrical and creative period of the artist’s career during which he achieved international success. It was during this time that Bacci, an established exponent of Spatialism and among the most innovative artists of the Italian art scene, came to the attention of Peggy Guggenheim, who soon began to promote his work, and critics soon acknowledged the novelty of his painting, the generative force of his color, his rupturing of spatial planes, and the circular rhythm of his brushstrokes.
La nuova stagione della Galleria di Palazzo Cini a San Vio (che rimarrà aperta fino al 15 ottobre) vede protagonista di un Ospite a Palazzo il dipinto Cleopatra di Artemisia Gentileschi della Collezione Cavallini Sgarbi. L’opera, trionfo del primo Barocco, è stata attribuita alla mano di Artemisia dopo esser stata a lungo considerata di Guido Cagnacci. Cleopatra mostra in maniera netta il passaggio di Artemisia dalla lezione della piena maturità artistica del padre Orazio al vero e proprio innamoramento per Caravaggio.
Se il corpo nudo e lascivo di Caravaggio è di regola maschile, Artemisia traduce quella ispirazione al femminile e l’impatto è ancora più forte. Il suo realismo è assoluto, stringente, senza nessuna concessione lirica o intimistica. Cleopatra emerge dall’ombra attraverso un possente gioco di luci, una donna di carne, di sangue, dai fianchi pronunciati ancora tardo rinascimentali e ben poco incline ai nuovi dettami dell’immagine voluta dalla Controriforma. Un dipinto pagano, arcaico e come ogni opera d’arte antica, diventando un classico, si attualizza in una contemporaneità per molti impensabile, che dialoga con il visitatore in maniera diretta e intima. L’opera offre lo spunto per rievocare il soggiorno della pittrice romana a Venezia, documentato dal 1626 al 1630, e riflettere sul ruolo e i rapporti intrattenuti da Artemisia nel panorama culturale e storico artistico lagunare.

Al contempo, l’opera conferma la fama della pittrice, incredibilmente vasta alla sua epoca e, a causa della sua vita tormentata e coraggiosa (denunciò lo stupro da parte del suo Maestro), considerata da sempre una eroina femminista ante litteram. Tuttavia l’altezza stilistica raggiunta da Artemisia va oltre gli aspetti drammatici della sua esistenza, confermando come le sue stesse opere pongono con evidenza il tema del conflitto sia sotto l’aspetto tematico che figurativo, sia sotto l’aspetto formale che quello poetico, come si vede bene nelle sue “Giuditte”, che non lesinano concretezza né ai personaggi che mette in scena, né alle ferite che esse mettono in atto. Artemisia affronta la pittura “alta”, soggetti sacri e storici, impianti monumentali, con una totale padronanza, abbandonando i moduli iconografici convenzionali e drammatizzando il rapporto con lo spettatore. Da sicura professionista dell’arte, e vorremmo aggiungere al femminile, sa di poter esplorare toni più lirici, atmosfere più intime in piena sintonia con la vastità del sentire barocco. M.M.



Ogni fotografia è un atto giornalistico. Parte da qui Chronorama. Tesori fotografici del 20° secolo, la prima grande mostra dedicata ai capolavori provenienti dagli archivi Condé Nast, in parte recentemente acquisiti dalla Pinault Collection. Il curatore, Matthieu Humery, è entrato letteralmente in questi immensi giacimenti uscendone con una selezione di oltre 400 incredibili scatti che riportano in vita il Novecento attraverso eventi, fenomeni sociali e personaggi storici che lo hanno segnato. Frammenti di passato offrono un saggio sociologico visivo che racconta in modo incalzante – le fotografie invadono letteralmente lo spazio espositivo – l’evoluzione del gusto e dell’estetica, nonché la nascita, l’affermazione e la trasformazione della fotografia come linguaggio di comunicazione di massa prima dell’avvento della cultura digitale.

Nonostante le fotografie fossero destinate a comparire nelle riviste, le immagini prodotte sono trattate come opere d’arte a pieno titolo: la mostra compie un passo in più, invitando il visitatore ad osservarle fuori del loro contesto editoriale per ricomporre un mosaico visivo in cui si collocano sia rinomati capolavori dell’arte fotografica che immagini inedite.
Un vero e proprio invito all’introspezione da parte di un mondo occidentale che non ha solo intuito la potenza delle immagini, ma ne ha anche inventato il linguaggio.
ENG Every photograph is an act of journalism. This is the idea behind the first major exhibition dedicated to masterpieces from the Condé Nast archives, parts of which were recently acquired by the Pinault Collection. Curator Matthieu Humery entered its immense deposits physically and emerged with a selection of over 400 incredible shots that bring the twentieth century back to life through the events, social phenomena and historical figures that marked it. Fragments of the past which offer an urgent visual sociological essay, the photographs literally invading the exhibition space, that details the evolution of taste and aesthetics, as well as the birth, affirmation and transformation of photography as a language of mass communication before the advent of digital culture.
Più di 300 immagini, documenti, libri, pubblicazioni e filmati offrono una sintesi in grado di restituire una lettura che si apre alle più diverse esperienze affrontate da Ugo Mulas (1928–1973) nel corso della sua straordinaria e troppo breve carriera, fotografo trasversale a tutti i generi precostituiti e capace di approfondire tematiche le più varie, cercando sempre la profondità della “quantità umana”.
Le 14 sezioni della mostra Ugo Mulas. L’operazione fotografica, alle nuove Stanze della Fotografia a San Giorgio ripercorrono tutti i suoi campi d’interesse: dal teatro alla moda, con i ritratti di amici e personaggi della letteratura, del cinema e dell’architettura fotografati come “modelli in posa”, dai paesaggi e dalle città alla sua esperienza con la Biennale di Venezia e con gli artisti della Pop Art.

Tra le figure più importanti della fotografia internazionale del secondo dopoguerra, Mulas capisce subito come essere fotografo voglia dire fornire una testimonianza critica della società, osservata senza preconcetti e sovrastrutture mentali. L’attenzione al mondo dell’arte e alla produzione artistica diventa ben presto uno dei principali ambiti di interesse del fotografo lombardo. Fondamentale, tra le altre, la collaborazione con Marcel Duchamp, capace di rivelare qualcosa di più profondo e generale nella concezione di Mulas dei ritratti d’artista.
ENG More than 300 images, documents, books, publications and films constituting a summary that provides an insight into the various experiences undertaken by Ugo Mulas (Pozzolengo, 1928 – Milan, 1973), a photographer who worked in all the pre-established genres and who was capable of investigating a range of themes, always seeking the depth of “human quantity”. The 14 sections examine all of Mulas’ fields of interest, from theatre and fashion, portraits of friends and personalities from the worlds of literature, cinema and architecture photographed as “posed models” and landscapes and cities to his experience with the Venice Biennale and the artists of Pop Art.



sabato 17 giugno 2023 www.artnightvenezia.it



sabato 17 giugno 2023
















Puntuale verso il solstizio d’estate, torna Art Night, edizione numero 12, la notte veneziana dell’arte, che nel corso di più di un decennio, ha saputo coinvolgere un numero sempre crescente di partecipanti entusiasti di potersi creare un percorso personale e fuori dal consueto orario di visita tra musei, gallerie e mostre, aperte per l’occasione gratuitamente fino a mezzanotte e oltre. Art Night nasce da una felice intuizione della docente di Ca’ Foscari Silvia Burini, coadiuvata dalla ricercatrice Angela Bianco, che non hanno mai fatto venire meno anche nei periodi più difficili legati alla pandemia il loro impegno ed entusiasmo verso questo impegnativo compito, in cui si tratta di mettere a regime decine e decine di istituzioni culturali veneziane, grandi e piccole (119 nella scorsa edizione), coordinando un calendario fittissimo e complesso che si esaurisce nel giro di poche ore. La manifestazione è da tempo entrata nel calendario ufficiale delle Notti dell’arte europee ed è realizzata in collaborazione con il Comune di Venezia e patrocinata dalla Regione Veneto. L’edizione 2023 si prospetta ancora più ricca, con oltre 124 sedi sparse tra Venezia, Isole e Mestre. Tra le new entry ci sono la Fornace Orsoni, e due librerie per bambini: Sulla Luna e La casa di Leo. Va altresì segnalata l’importante collaborazione con l’Università di Padova e VIU per la mostra Cercando il cuore a San Sebastiano, con opere di Alberto Biasi, Giancarlo Signoretto, Agnese Tegon e Biancarosa Volpe.
Anche quest’anno è possibile servirsi della mappa digitale scaricabile tramite QR code presente in tutti i manifesti e locandine dell’evento. Realizzata da Venezia News in collaborazione con Ca’ Foscari si è rivelata una preziosa bussola per l’arte, con circa 65.000 visualizzazioni nel giro di poche ore nella passata edizione. La mappa è intuitiva e facilmente consultabile sia da desktop, per preparare in anticipo da casa un itinerario in città, sia live dal telefonino con geo-localizzazione, per sapere in ogni momento cosa accade ‘a portata’ di piedi o battello. Inoltre, la funzione di prossimità permette di visualizzare gli eventi vicini al punto in cui ci si trova in quell’esatto momento, notificando la distanza da ciascuna sede espositiva. Per una volta, superando la nostra abituale ritrosia, ci auto-citiamo, soltanto per registrare con soddisfazione la forza del richiamo di arte e cultura quando vengono veicolati ed offerti nella giusta maniera. Poter contare su di un pubblico bulimico di arte, desideroso di farne una scorpacciata in una sera di inizio estate, depone a favore della brillante idea dell’ineffabile duo Bu-Bi.
L’amore per l’arte non può far scordare l’importanza di temi sociali primari quali l’inclusione. Art Night ha deciso di trasformare la tradizionale e fortunata colazione in blu vestendo i colori dell’arcobaleno, per sostenere e divulgare la cultura dei diritti civili, promuovendo il principio dell’uguaglianza. Le petit déjeuner Arcobaleno in collaborazione con Malìparmi si svolgerà quest’anno per la prima volta a San Sebastiano, con l’intento anche di far conoscere alla città una sede universitaria piena di interessanti sorprese, grazie a visite guidate organizzate con il coinvolgimento degli studenti di Ca’ Foscari. Marzio Fabi

Ego come sé, letteralmente dal latino “io”, prima persona singolare; ego come soggetto pensante, mediatore tra conscio e inconscio. L’ego che per l’artista diventa eroe, mano creativa, colui che decide sulla bellezza. Su questo tema sono stati invitati a riflettere quattro artisti, immersi in una Venezia che è la massima espressione di bellezza fragile ed eterna. Carles Valverde, Didier Guillon, Vangelis Kyris & Anatoli Georgiev sono i protagonisti della nuova stagione espositiva di Fondation Valmont. Una visione sull’arte contemporanea allargata e rivolta verso il futuro, che intreccia arte e bellezza in uno sguardo questa volta tutto al maschile, ma che riesce a toccare i vertici di una sensibilità alta, dove Ego è la mano creativa. Valverde compone nello spazio due elementi modulari; Guillon colloca dieci sculture che rappresentano busti di uomini urlanti; infine, il duo Kyris & Georgiev, con dei grandi ritratti tra fotografia e ricamo. Dipinti e sculture dialogano negli spazi di Palazzo Bonvicini in una armonia perfetta che risalta l’architettura e il decoro delle sale espositive, l’allestimento della mostra offre l’atmosfera di un museo ma al contempo restituisce il piacere di una intima relazione con le opere. Non vogliamo svelare troppo, solo invitarvi a visitare Fondation Valmont: ne vale veramente la pena. ENG Ego as self, from the Latin “io”, first person singular; ego as thinking subject, mediator between conscious and unconscious. The ego that becomes hero and creative hand for the artist – he who decides about beauty. Immersed in a Venice that is the most extreme expression of fragile and eternal beauty, four artists were invited to reflect upon this theme: Carles Valverde, Didier Guillon, Vangelis Kyris and Anatoli Georgiev are the protagonists of the new exhibition season of Fondation Valmont. A wider, forward-looking vision of contemporary art, interweaving art and beauty in a gaze which this time is entirely male.
Un’architettura veneziana che sorge dall’acqua, dove riflettendosi si dissolve. Giovanni Soccol, pittore, architetto e scenografo, ha scelto dieci architetture-simbolo di Venezia che si affacciano sul Canal Grande, a partire dalla Dogana de Mar fino alla Chiesa di San Simeone, ognuna delle quali ha suscitato in lui un interesse particolare, che ci restituisce sotto forma di dialogo formale e spirituale con la città. Soccol ha voluto, infatti, rappresentare il fascino di un’apparizione che può svanire, appartenendo più al sogno che alla realtà. Le tele, tutte della stessa dimensione (200x150cm), dipinte a tecnica mista, ossia base a tempera magra, corpi ad emulsione acqua in olio, velature oleo-resinose, compongono un unico ciclo inedito, allestito come installazione nella mostra Riflessioni notturne in corso fino al primo ottobre al piano terra di Palazzo Fortuny. I rapporti geometrici legano gli elementi compositivi in una visione non prospettica, ma proiettata ortogonalmente alla tela per non alterare la geometria delle forme. Una luce notturna raccorda e unisce tra di loro gli elementi, conferendo alle architetture un’atmosfera metafisica, non nuova nella ricerca dell’artista veneziano in quanto costituisce il fil rouge che sottende la sua ricerca negli ultimi decenni. Ci troviamo così davanti ad architetture note, ma che assumono una grande potenza onirica, dove il tessuto pittorico sovrasta la forma per ottenere effetti di luminosità nel contrasto chiaroscurale delle masse. M.M.

ENG Venetian architecture rises from the water to reflect on it, and dissolve. Giovanni Soccol is a painter, architect, and photographer: he picked ten iconic pieces of architecture in Venice, all facing the Grand Canal, that piqued his interest and reproduced each on a mixed media (tempera, oil emulsion, resin) painting. The art is part of cycle Riflessioni notturne, at Palazzo Fortuny until October 1. The geometries of the compositional elements are arranged in a non-perspective vision that is orthogonal to the canvas so that the proportions are left unchanged. Nightly light harmonizes and blends together the several elements, giving a touch of metaphysical atmosphere to the art.

Viaggi leggendari e vite avventurose. Il titolo della mostra, Nicolò Manucci, il Marco Polo dell’India. Un veneziano alla corte Moghul nel XVII secolo, svela in maniera diretta ed eloquente il cuore narrativo di questa straordinaria avventura umana e culturale. L’esposizione ripercorre le tappe salienti della vita del viaggiatore veneziano, restituendo lo sguardo prezioso, diremmo quasi unico per durata ed intensità del vissuto, di un testimone privilegiato della storia e della ricchezza culturale dell’India Moghul. Nicolò Manucci (1638 – 1720), di umili origini, figlio di un “pesta spezie”, spinto dal desiderio di esplorare il mondo, a soli 14 anni, nel novembre del 1653, si imbarcò a Venezia alla volta dell’Oriente, nascosto nella stiva di una tartana, senza fare più ritorno. Un’avventura davvero esaltante in tutte le sue contraddizioni di percorso da ripercorrere a fiato sospeso. L’eccezionalità della storia sta proprio nel suo desiderio di tramandarla consapevole di essere stato un reporter ante litteram. Il corpus del lascito di Nicolò Manucci, composto dal Libro Rosso e dal Libro Nero, restituisce come una vera enciclopedie delle Indie, attraverso le parole e le eccezionali testimonianze visive consistenti in incredibili miniature, diversi aspetti politici, militari, religiosi, sociali e culturali. Riservandovi all’interno, sparsi tra le pagine, non pochi momenti ed episodi della sua autobiografia.

La Fondazione dell’Albero d’Oro offre una vera immersione totale – con tanto di profumo di spezie – nella vita di Nicolò Manucci, una sensazione di avventura leggendaria e di mondi affascinanti che permane anche usciti dalla mostra, naturalmente con in mano una copia del libro che racconta la sua vita (che troverete al piccolo ma monografico bookshop).
ENG Legendary journeys and lives of adventure. The title of the exhibition – Nicolò Manucci, the Marco Polo of India – directly and eloquently communicates what is at the heart of this extraordinary human and cultural adventure. The exhibition traces the various stages in the life of the Venetian traveler, offering us the precious - we might almost say unique in terms of duration and intensity of experience – gaze of a privileged witness to the history and cultural richness of Mughal India. At only 14 years of age and driven by a desire to explore the world, in November 1653, Nicolò Manucci (1638 – 1720), of humble origins and the son of a “spice grinder”, boarded a ship bound from Venice to the East, hidden in the hold of a tartan, never to return. A truly exhilarating adventure in all its contradictions, to be experienced with bated breath.

Fino
Chiara Bertola nel suo Conservare il futuro, libro uscito da un mese e ora protagonista di una serie di incontri e presentazioni, racconta il lavoro di curatore e lo fa trasmettendo nelle pagine la stessa passione, anzi direi “magnifica ossessione” che la spinge da anni ad affrontare l’arte contemporanea non come ricerca fine a sé stessa, spinta verso sempre nuove sfide e linguaggi, ma come confronto con il passato, in un dialogo fitto senza tempo dove gli artisti sono artisti, le opere sono opere e la bellezza e la caducità sono sempre immanenti. Tutte le mostre che ha costruito passo a passo e realizzato alla Fondazione Querini Stampalia hanno lasciato una traccia indelebile e costruito una riflessione fondante sul contemporaneo. Ne sono testimonianza nel libro proprio le diverse collaborazioni, gli artisti, che sono poi diventati amici, le opere stesse che hanno trovato la strada per importanti collezioni. Ovviamente protagonista al fianco di Chiara, la Fondazione Querini Stampalia con la sua capacità inclusiva di dialogare trasversalmente con artisti, architetti, studiosi e critici, certamente un punto fermo di Venezia per tutti.
Un libro da leggere e da sottolineare per riflettere su cosa significa “conservare il futuro”.

Sulle tracce di una curatrice
Il nuovo libro di Chiara Bertola, un catalogo di passione e arteNicolò Manucci, il Marco Polo dell’India Un veneziano alla corte Moghul nel XVII secolo 26 novembre Fondazione dell’Albero d’Oro, Palazzo Vendramin Grimani, San Polo 2033 www.fondazionealberodoro.org Fondazione Querini Stampalia Luigi Ghirri, Andrea Zanzotto, Giuseppe Caccavale, Un’evidenza fantascientifica, 2021 Kiki Smith, Homespun Tales, 2005
Di seguito, riportiamo l’incipit del libro di Chiara Bertola: «Ventitré anni di cura dell’arte contemporanea sempre nello stesso luogo: la Fondazione Querini Stampalia di Venezia. Un lungo tempo in cui ho potuto osservare le metamorfosi di quell’antica struttura, le sue rinascite, attraverso le differenti visioni degli artisti proiettate nei suoi spazi che, di fatto, l’hanno resa ogni volta molti luoghi. Da questa prospettiva, vedo il mutamento di un lavoro, il mio, che si è principalmente nutrito di elementi instabili ed effimeri, di intelligenze, e di sensibilità, le quali hanno saputo riconoscere e indicarmi cose mai viste nelle nostre storie, strade di senso mai percorse.

Questo libro è l’occasione per cercare di capire quale siano stati gli interrogativi, i pensieri e le scoperte fatte prima che l’attività della cura trovasse casa».
A cosa serve l’arte contemporanea? E quali cambiamenti può instillare nella società e in chi la abita? Sono solo alcune delle questioni affrontate dal vulcanico e instancabile Hans Ulrich Obrist (1968) nel libro A che cosa serve l’arte, scritto con Gianluigi Ricuperati, in uscita a maggio per la collana Cartabianca di Marsilio Editori.

Autore di oltre tremila interviste, Hans Ulrich Obrist si svela in questo volume raccontando incontri, personaggi, libri e mostre che lo hanno formato, contribuendo a farlo diventare l’attuale curatore di fama mondiale. Nel nostro tempo pochi hanno affinato l’arte di fare domande come Hans Ulrich Obrist. Fin da quando all’età di 17 anni è partito per il suo primo grand tour in Europa, il curatore e critico non ha mai smesso di conversare con architetti, scienziati, filosofi, artisti, musicisti e scrittori. Ogni incontro è sempre sfociato in un dialogo che aggiunge un tassello in più alla sua appassionante ricerca su quale sia il ruolo dell’arte contemporanea e mostra come, in un’epoca caratterizzata da fenomeni estremi, tecnologici e sociali, gli artisti siano a tutti gli effetti sismografi viventi. Il libro, scritto insieme a Gianluigi Ricuperati (1977), scrittore, saggista e curatore, costituisce il racconto di un originale approccio all’arte, tracciando la biografia intellettuale di un uomo «giovane e antico, elegante e dinoccolato, distratto e attratto da tutto ciò che emerge come invenzione assoluta». Obrist si sofferma sugli incontri con quelle figure e quegli autori che hanno contribuito a formare la sua identità in continua evoluzione: da Francis Bacon a Michelangelo Pistoletto, da Gustave Metzger a Hélène Cixous, da Félix Fénéon a Dominique Gonzalez-Foerster, da Fischli e Weiss a Édouard Glissant, fino all’ultimo capitolo dedicato alla sua compagna, l’artista Koo Jeong A. Dagli aneddoti personali alla riflessione sul suo lavoro, Obrist accompagna il lettore in un coinvolgente cammino fatto di progetti capaci di portare alla luce gli aspetti più latenti del panorama artistico degli ultimi decenni.

Luminance
Fino Until 29 luglio July
Mel Douglas (Burnie, Tasmania, Australia 1978; vive e lavora a Canberra) indaga il vetro attraverso l’estetica del tratto e arriva a concettualizzare la forma stessa come segno, trattando le sue sculture come fossero tela o foglio di carta. L’artista si serve delle proprietà uniche del vetro – trasparenza, traslucenza o opacità – per collegare e sovvertire lo spazio, sviluppando sculture bi e tridimensionali che fondono spazialmente superficie e segno, dove la forma non è più solo un supporto ma un disegno tridimensionale a tutti gli effetti. La sua pratica consiste infatti in un lento e deliberato processo di incisione manuale, a punta di diamante, sulla superficie delle sue opere in vetro. Qualità, rigore e bellezza in ogni fase del processo trovano nelle sue opere la sintesi perfetta, il perfetto equilibrio tra esplorazione, processo e precisione. Con il titolo della mostra, Luminance, l’artista ci racconta l’impressione di luminosità di una sorgente luminosa da un lato e di una superficie dall’altro, che dipende in larga misura dal grado di riflessione e dal colore della superficie. La luminanza è una grandezza fotometrica vettoriale definita come il rapporto tra l’intensità luminosa emessa da una sorgente nella direzione dell’osservatore e l’area apparente della superficie emittente, così come vista dall’osservatore.

ENG Mel Douglas (Burnie, Tasmania, Australia, 1978) investigates glass through the aesthetics of the mark, conceptualizing the form itself as mark and treating her sculptures as if they were canvases or sheets of paper. The artist uses the unique properties of glass – transparency, translucency or opacity – to connect and subvert space, developing two- and three-dimensional sculptures that spatially blend surface and mark, and where form no longer represents a mere support but becomes to all intents and purposes a three-dimensional drawing. Her practice consists in fact of a slow and deliberate process of manual engraving with a diamond point on the surface of her glass pieces.
Ca’ Nova di Palazzo Treves in Corte Barozzi, San Marco 2158 www.caterinatognon.com
de Retiro Espiritual
Da From 18 maggio May Esposta al MoMA di New York nel 2005 e mai proposta prima in Italia, la serie di fotografie di Michele Alassio è un’analisi visiva delle architetture di Emilio Ambasz e in particolare della sua Casa de Retiro Espiritual, situata nel cuore di un’immensa tenuta in Andalusia. Due alti muri bianchi e ruvidi stuccati si incontrano ad angolo retto per annunciare l’ingresso della casa, che per il resto è contenuta da pareti sinuose. L’acqua scorre a cascata all’interno di entrambe le alte pareti lungo i corrimani. L’ampio spazio abitativo continuo dell’area interna è definito da cavità lisce scavate nel pavimento. Le pareti sono bagnate da una luce morbida e diffusa, che scende dai lucernari e filtra dal patio ventilato. «La casa è stata per me tutto ciò che ne hanno fatto la luce, il vento, le intemperie mentre passavano sulle due pareti come le vele di un mulino a vento immobile. La casa è stata per me un compendio di forme alterate dalla natura circostante [...]. Ho fotografato la casa e il suo candore abbagliante dentro e fuori semplicemente per quello che rappresenta, una possibilità espressiva» (M.A.).

ENG Exhibited at the MoMA in New York in 2005 and never before shown before in Italy, this series of photographs by Michele Alassio is a visual analysis of Emilio Ambasz’s architecture, and in particular of his Casa de Retiro Espiritual, located in the heart of an immense estate in Andalusia. “The house was for me everything that the light, the wind, the bad weather made of it as they passed over the two walls like the sails of a motionless windmill. The house was for me a compendium of forms altered by the surrounding nature. [...] I photographed the house and its dazzling whiteness inside and out simply for what it represents, an expressive possibility” (M.A.).
Castello 4745 www.venicephotography.it
Fino Until 15 luglio July
Prima personale in Italia dell’artista e autrice nigeriano-americana Monilola Olayemi Ilupeju (1996). Ispirandosi alle numerose contraddizioni e ai doppi significati insiti nell’idea, nella funzione individuale e sociale svolta dalla palestra – luogo di gioco, di godimento sensuale e di sperimentazione collettiva, ma anche luogo di sofferenza fisica e di competizione –, Ilupeju trasforma la galleria in un’arena con figure nude e sculture in ferro che fanno riferimento ad antichi e moderni attrezzi ginnici. Nell’attuale panorama socio-politico la palestra diventa una metafora del mondo: i corpi emarginati devono cercare di forgiare modi creativi e agili per meglio muoversi al suo interno e “sopravvivere”. Resistendo a un’unica forma statica, le figure ritagliate si allungano in forme insieme poetiche e violente, sollecitando lo spettatore a riflettere sui modi in cui l’arte e le sue intrinseche ambiguità possono affrontare queste distorsioni politiche e interiori.
ENG The first solo exhibition in Italy of Monilola Olayemi Ilupeju (b. 1996), a Nigerian-American artist and author. Inspired by the many contradictions and double meanings of the gymnasium – simultaneously a place for play, sensual enjoyment, and collective experimentation, but also for physical suffering and competition – Ilupeju transforms the gallery into an arena with nude figures and iron sculptures that reference ancient and modern gym equipment. In the current socio-political landscape, the gymnasium thus becomes a metaphor for the world, in which marginalized bodies must attempt to forge agile, creative ways to move in order to survive.
San Marco 3073
www.aplusa.it
18 maggio May-18 giugno June
20 maggio May-29 ottobre October
Il percorso artistico di Aldo Grazzi comincia agli inizi degli anni Settanta e sviluppa una riflessione estetica che lo porta a lavorare utilizzando mezzi espressivi diversi, dalla pittura alla fotografia, ai video e alla musica. A cura di Emanuela Fadalti e Matilde Cadenti, Evanescenze presenta la serie dei lavori che Aldo Grazzi ha realizzato tra il 1994 e il 2006 utilizzando reti in fibra come supporto sul quale disegnare con le forbici figure e geometrie impalpabili e visionarie. Alla base di questi lavori vi è una concezione di gesto artistico reiterato che, come un mantra, indaga ed esprime visivamente una meditazione sulla dimensione mistica e spirituale dell’esperienza umana. Le opere scelte per la mostra si rivelano in questo modo fondamentali per comprendere i linguaggi di una ricerca artistica complessa e multiforme che occupa un ruolo di assoluto rilievo nei percorsi dell’arte italiana degli ultimi decenni. ENG Aldo Grazzi (1954) began his artistic career in the early 1970s, developing an aesthetic reflection that prompted him to work using different means of expression, from painting to photography, video and music. Evanescences presents the series of works the artist created between 1994 and 2006 using fiber nets as a support on which he drew impalpable and visionary figures and geometries with his scissors. Underlying these works is a conception of a repeated artistic motif that, like a mantra, investigates and visually expresses a meditation on the mystical and spiritual dimension of human experience. Calle Berlendis, Cannaregio 6301 www.spazioberlendis.it
Una mostra immersiva, curata da African Art in Digital (AainD), trascende lo spazio fisico per restituire una serie di manufatti dell’Africa centrale, portati in vita attraverso un’installazione digitale e cinematografica, composta di suoni, luci e colori, che utilizza scansioni e animazioni 3D assieme a preziosi filmati d’archivio. I manufatti tradizionali africani diventano i protagonisti della loro stessa storia, accompagnando lo spettatore in un viaggio attraverso un paesaggio immaginario che rimanda ai panorami di un’Africa che fu. Il potenziale innovativo dei nuovi media consente di esporre digitalmente i manufatti africani in una nuova dimensione fisica e concettuale, offrendo un mezzo di restituzione che rende gli oggetti visibili a un pubblico più vasto, in particolare alle giovani generazioni, contribuendo a rafforzare il legame tra passato e presente e a creare un continuum verso il futuro.



ENG An immersive exhibition curated by AainD invites visitors to transcend physical space and encounter a captivating collection of Central African artifacts. Through the innovative use of sound, light, and color, the exhibition brings these artifacts to life in a thrilling cinematic experience. Utilizing 3D scans, animations, and archival footage, the exhibition showcases the groundbreaking potential of new media in digitally exhibiting African artifacts. This new approach not only offers a means of restitution but also makes these objects accessible to a wider audience, particularly younger generations. By exposing previously hidden or inaccessible historical objects, the exhibition strengthens the connection between the past and present, creating a sense of continuity.
Salizada Streta, Castello 368 www.africanartindigital.comwww.zueccaprojects.org

Storica dell’arte, curatrice e specialista in Media Art, Olga Shishko (Mosca, 1967) si è laureata all’Università Statale di Mosca al dipartimento di Storia e Teoria dell’Arte. Curatrice di lunga esperienza, è direttrice del progetto MediaArtLab, una delle più ampie e importanti mediateche di arte contemporanea in Russia. Prima dello scoppio della guerra era direttrice della sezione di Arte Cinematografica e Media Art del Museo Pushkin di Mosca e soprattutto del progetto Pushkin XXI, chiamato a unire tradizione e contemporaneità, a correlare il processo artistico russo con quello internazionale, a sviluppare il dialogo nelle forme della rappresentazione dell’arte contemporanea. Con l’inizio del conflitto Olga Shishko si è dimessa da tutti i ruoli precedentemente ricoperti. Ora è giunta a Venezia, isola dove arte, università e amicizie l’hanno fatta sentire di nuovo a casa. L’arte come valore universale di libertà è l’assunto per una nuovo inizio. L’abbiamo incontrata per parlare di futuro con occhi puntati sul presente.
La difficile decisione di lasciare la Russia, l’arrivo a Venezia, una nuova condizione esistenziale. Nonostante tutto ciò la necessità di continuare il proprio lavoro è più forte di qualsiasi censura fisica o mentale. Quali sono i punti cardine del suo pensiero, quelli che l’hanno fatta subito ripartire dai suoi progetti ‘lasciati’ per costruire un ponte ideale verso un nuovo presente?
Mia nonna diceva sempre: «Mai dire mai!», perché la vita prende spesso direzioni inaspettate. Bisogna pensare alla vita come a un viaggio avventuroso, in questo modo sarà più semplice superare i diversi momenti che ci troveremo ad affrontare. Ho lasciato il Museo dopo il 24 febbraio 2022 perché non potevo più svolgere le mie attività professionali. L’ultima esposizione che ho preparato prima dello scoppio della guerra è stata quella di Irina Zatulovskaya, Fuga in Egitto. Jump into the Unknown, una mostra che non verrà mai aperta in Russia. Eppure io non sono fuggita in Egitto, bensì nella mia amata Venezia, la città in cui posso respirare e a cui sono molto legata.
La mia casa rimane il Museo Pushkin, dove sono stata invitata a lavorare da Marina Loshak, la migliore direttrice di sempre. Ci lavorano persone straordinarie e nei sette anni in cui sono stata lì abbiamo fatto molto per promuovere il linguaggio dell’arte contemporanea creando bellissime mostre, tra cui due a Venezia (nel 2019 abbiamo
realizzato C’è un inizio nella fine. La Confraternita Segreta Tintoretto alla Chiesa di San Fantin: un’iniziativa della sezione contemporanea del Museo Pushkin dedicata ai 500 anni della nascita di Tintoretto; nel 2017 ho co-curato Man as a Bird. Immagini di Viaggi a Palazzo Soranzo Van Axel, Evento Collaterale della 57. Esposizione Internazionale d’Arte della Biennale di Venezia).
Ho lasciato il museo di mia spontanea volontà, in accordo con la direttrice, perché ho capito che non potevo rimanere in silenzio accettando uno stato di fatto che non mi avrebbe permesso di costruire liberamente progetti sull’arte contemporanea. Come curatrice ho cercato negli anni infatti di realizzare mostre in cui si sviluppassero anche temi sociali e politici: sia in quelle collettive, come Transitland: Video Art of Central and Eastern Europe after the fall of the Berlin Wall, Golden Age of the Russian Avant-garde, Mockumentary: Is Reality Not Enough?, Reflecting on Death, sia in quelle personali su artisti provenienti da tutto il mondo, come Journey of the Soul di Bill Viola, Soul of Stone di Fabrizio Plessi, un progetto realizzato in collaborazione con il Centro Studi sulle Arti della Russia (CSAR) dell’Università Ca’ Foscari, da me curato insieme a Silvia Burini e Giuseppe Barbieri.
Uno dei cardini del suo lavoro al Pushkin di Mosca è stata la creazione nel 2000 di MediaArtLab, la prima istituzione in Russia dedicata all’arte dei media, piattaforma di ricerca per lo studio, le esposizioni e le attività di promozione della Media Art in tutte le sue forme. Nel 2023 questo ambizioso progetto trova una preziosa collaborazione con lo CSAR dell’Università Ca’ Foscari offrendo la possibilità di realizzare nuovi contenuti ad esso correlati, che portano avanti quanto sviluppato in questi anni. Quali sono questi nuovi percorsi intrapresi?
Come nel resto del mondo, anche in Russia dalla fine degli anni Novanta si è registrato un rapido sviluppo dell’arte che impiega le nuove tecnologie: Video Art, Sound Art, Net Art e altre forme sperimentali, con riferimenti sia alle Avanguardie russe, per esempio a Kazimir Malevich o Sergei Eisenstein, sia agli artisti occidentali degli anni ’60, come Nam June Paik, Vito Acconci o Bruce Nauman.
Mi ero laureata all’Università Statale Lomonosov di Mosca all’inizio degli anni ‘90 con una ricerca sul Barocco. Il destino però ha voluto che mi occupassi di arte contemporanea quando ho iniziato a lavorare al Centro Soros per l’arte contemporanea. All’epoca stavamo creando una nuova cultura. Sono diventata una delle prime esperte in Russia di questo settore, impegnata come teorica e curatrice di progetti nel campo della Media Art. La tecnologia video permetteva di dire la verità, di costruire una cultura senza divieti, basata sulla democrazia. È importante sottolineare che il video è stato il primo “nuovo mezzo di comunicazione di massa” che si è da subito stabilito anche come mezzo di comunicazione audiovisiva privata, quindi come alternativa alla cultura televisiva e cinematografica regolamen-
tata e controllata dallo Stato in Russia. Per me, in quanto docente, era fondamentale che i miei studenti prendessero come punto di riferimento un nuovo linguaggio visivo che attuasse nuove strategie comunicative.
Il Centro Soros per l’arte contemporanea ha chiuso nel 1999. Mio marito e io abbiamo fondato nello stesso anno il centro indipendente di arte e cultura MediaArtLab per batterci in favore dell’autonomia dell’arte, per sostenere e realizzare progetti liberi dal controllo statale. In vent’anni MediaArtLab ha formato una comunità internazionale di media artist, registi sperimentali, documentaristi e video attivisti. Nel suo dinamico percorso MediaArtLab ha realizzato per la prima volta in Russia una serie di eventi su queste innovative forme espressive: il primo festival di arte digitale; la prima conferenza scientifica sulla cultura dei media e sui problemi del copyright su Internet; la prima proiezione di cinema multischermo; la prima collezione di videoarte russa; la prima mostra di opere di falso documentario (mockumentary). Nell’ambito del simposio Pro e Contra si è tenuta una tavola rotonda con il governo della Federazione Russa che ha influenzato in modo significativo la liberalizzazione del discorso sulla regolamentazione legislativa di Internet. Sembrava che piccoli passi, piccole iniziative, piccole vittorie avrebbero cambiato il Paese. Ma si trattava purtroppo di un’illusione.
MediaArtLab ha costruito attivamente progetti fino al 2014. In seguito è diventato praticamente impossibile continuare a lavorare, poiché lo Stato russo ha chiuso progressivamente importanti fondazioni e istituzioni culturali che sostenevano l’arte libera. Non abbiamo ad ogni modo mai vissuto con i soldi dello Stato; i progetti sono stati realizzati con le sovvenzioni dei centri culturali, delle ambasciate e dei nostri partner occidentali (numerose istituzioni culturali).
A Mosca è stato aperto anche il museo della cultura dello schermo Manege/MediaArtLab.
Sono orgogliosa del nostro ultimo progetto, realizzato con il grande regista e artista Peter Greenaway. The Golden Age of the Russian Avant-garde parla della tragedia degli artisti russi alla fine degli anni ‘20. Da un certo punto di vista questa installazione, giocata sul passato, parlava anche al presente. Gli immensi dodici personaggi, i dodici apostoli che apparivano davanti al pubblico sugli schermi multimetro, erano Malevich, Kandinsky, Filonov, Rodchenko, El Lissitzky, Majakovskij, Brik, Meyerhold, Ermolaeva, Eisenstein, Popova e Tatlin. Gli spettatori, insieme ai protagonisti della mostra, entravano a far parte di un girotondo della storia. Il progetto si basava sul principio del “montaggio delle attrazioni” di Sergei Eisenstein e attirava lo spettatore del XXI secolo nella storia dell’Avanguardia russa. Peter Greenaway come artista ha provato a fornire una sua personale lettura di quel tragico periodo, ponendosi con la sua storia esistenziale e la sua visione in un confronto dialettico con quegli eventi consumatisi cento anni fa. Il Quadrato nero di Kazimir Malevich era la metafora principale di questa grande opera cinematografica. Il quadrato nero era riconoscibile in diversi modi: il cubo nero come
Cacciare un dissidente, non permettere l’espressione di un pensiero alternativo, eliminare la libertà di pensiero è qualcosa che non ha mai avuto fine nella storia della Russia
soluzione spaziale architettonica dell’installazione e il quadrato nero che si sbriciola in un milione di frammenti e si riunisce in una tela bianca. Da un lato è un rettangolo nero, non dipinto, bidimensionale e non emozionale; dall’altro è un vuoto nero, un buco nero in cui affondano i personaggi. Gli specialisti dell’Avanguardia russa hanno mosso al tempo molte critiche al progetto. Credo che ora dovrebbero riconsiderarne il valore, l’essenza. Dopo tutto, la storia è ciclica… Il popolo russo è traumatizzato da tempo immemorabile. Non ha imparato nulla dalla storia passata. Non ha riflettuto sulla storia e sul terribile esperimento che la Russia ha condotto su di sé nel 1917. Quest’ultimo progetto è stato inaugurato nel 2014, dopodiché ho lasciato il Manege. Ma il viaggio e la vita sono proseguiti. Nel 2016 MediaArtLab è entrato a far parte del Museo Pushkin, dove è stato aperto un dipartimento di cinema e media art, il programma Pushkin XXI e la collezione di media art. Oggigiorno MediaArtLab, in quanto organizzazione non-profit, non ha assolutamente nulla da fare in un Paese dove non è più possibile proseguire la collaborazione internazionale sul fronte vivo dell’arte contemporanea, non essendovi più alcuna forma di libertà di espressione.
Nel corso degli anni l’organizzazione ha raccolto la propria collezione di produzioni multimediali, che oggi comprende 500 opere. MediaArtLab possiede una delle principali e più estese mediabiblioteche di arte contemporanea. Attualmente si contano più di 2000 opere provenienti dal cinema d’avanguardia, molte delle quali realizzate da veri e propri pionieri della video arte, e un’ampia collezione di lavori di video artisti.
In collaborazione all’Università Ca’ Foscari, e in particolare grazie al prezioso lavoro svolto con Silvia Burini e Giuseppe Barbieri, abbiamo mosso due passi importanti: abbiamo aperto l’archivio MAL agli studenti per scopi didattici e abbiamo creato la piattaforma-archivio Mapping Diaspora.
Quali i confini artistici della Media Art? Quale maturità artistica sta dimostrando?
La liberazione dalla materia, un cambiamento nell’ottica dello sguardo, la libertà di possedere e controllare i materiali stessi e una rinuncia all’autorialità. A 27 anni, quando sono entrata nel vortice del New Media Art Laboratory del Centro Soros per l’arte contemporanea, di cui ero supervisore, era difficile per me rendermi conto che nel mondo dell’arte ci fosse qualcosa di diverso da scultura, pittura, disegno, installazioni e performance. I teorici e gli artisti di tutto il mondo che venivano da noi negli anni ‘90, tra cui Peter Weibel (che considero il mio primo maestro e che mi ha introdotto alla Media Art), Woody e Steina Vasulka, Heidi Grundmann, Louis Beck, Peter Krajewski, stavano scoprendo tutte le forme espressive di Time Based Art: Sound Art, cinema esteso, Net Art, forme d’arte interattiva. Studiando, ho aperto diverse scuole e corsi (per esempio Manege Open School/MediaArtLab) dove il dialogo con i nuovi media continua ancora. Dialogo che per quanto mi riguarda non si fermerà mai. I nuovi media rappresentano sempre al loro primo apparire una sorta di utopia, una libertà, una sfida e un’innovazione, un desiderio di superare il buco nero e di entrare in un altro spazio, espanso. Nella prefazione al suo famoso libro del 1970, Expanded Cinema, Gene Youngblood scriveva: «Quando diciamo cinema espanso, in realtà intendiamo coscienza espansa. Cinema espanso non significa film al computer, emissioni video, luce atomica o proiezioni sferiche.
Il cinema espanso non è affatto cinema: come la vita, è un processo in divenire, un’incessante spinta storica a manifestare la propria coscienza al di là, proprio davanti agli occhi».
Qualunque sia il tipo di Media Art di cui parliamo (videoarte, cinema, Sound Art, computer e arte interattiva, video e performance digitale, intelligenza artificiale, Net Art, criptoarte e NFT) dovremmo innanzitutto parlare dell’ambiente (media), della radicalità del lavoro dell’artista con questo ambiente (una sorta di anticipazione, previsione, visione utopica di questo ambiente e dell’interazione dello spettatore con esso) e dell’aspetto comunicativo dell’opera. In effetti, l’ambiente stesso funge da conduttore e la comunicazione è diventata lo strumento principale della modernità. L’estetica della comunicazione non si occupa della produzione di oggetti, né è interessata ad altre forme di espressione tangibili; il suo soggetto, il suo contenuto sono lo spazio e il tempo. È importante perciò comprendere che viviamo in un’epoca in cui l’artista non è più un mero produttore di oggetti di consumo finiti (un quadro, un armadio, un letto), bensì un creatore, espressione di PROIEZIONI individuali (metodo).
Lo spazio geografico è stato sostituito da quello online. JeanFrançois Lyotard diceva che l’arte delle nuove tecnologie genera una connessione con lo spettatore senza materializzare le opere sotto forma di oggetti. Queste opere consistono nell’“immateriale”. Tutte queste forme d’arte hanno un tratto in comune: l’immaterialità. Il che espone queste forme espressive contemporanee al rischio di venire consegnate all’oblio assai più di altri media artistici più tradizionali, se così li possiamo definire.
Una degli elementi più interessanti per me, nelle mie vesti sia di spettatore che di ricercatore, da osservare nel processo creativo è il cambiamento prodotto nei sistemi plastici dalle mani degli artisti. Questo processo è particolarmente evidente quando gli artisti reinterpretano le opere di vecchi maestri. Picasso ha ridisegnato le Meninas di Velázquez 57 volte: potete immaginare quanti nuovi significati ha apportato? L’artista americana Eve Sussman ha creato una versione video della Meninas intitolata 89 seconds in the Alcázar. In esso è come se l’artista dicesse: Velázquez ha scoperto l’arte della fotografia secoli prima della sua comparsa, perché nelle Meninas cattura un fotogramma che sembra durare nel tempo, quindi possiamo immaginare cosa c’era prima e cosa ci sarà dopo quel fotogramma. Nel lavoro di Sussman è come se lo spettatore fosse trasportato all’Alcázar, dove la coppia reale posa per Velázquez. Sussman crea 5 copie che vengono rapidamente acquistate da vari musei del mondo, una delle quali destinata all’autore. Eve Sussman (insieme a Snark art) ha reinterpretato l’opera originale del 2004 e l’ha scomposta in 2304 blocchi digitali o atomi (come li chiama lei stessa), ognuno dei quali viene venduto separatamente tramite la tecnologia blockchain. In questo modo l’artista cede la copia dell’ultimo autore della sua opera facendone oggetto di una comproprietà con 2000 sconosciuti. Qui si concretizza anzitutto l’idea della condivisione su scala globale: il proprietario di ogni atomo può riprodurlo in qualsiasi momento, ma la versione completa può essere trasmessa solo se tutti i partecipanti accettano di far girare i loro atomi contemporaneamente.
Ci troviamo di fronte allo sviluppo di una nuova concezione dell’arte, del mezzo artistico e del ruolo di collezionisti e spettatori. Anche se a ben vedere non siamo al cospetto di un processo profondamente inedito. All’inizio del XX secolo il Museo di Basilea avrebbe potuto



Opening: 19 May 2023, 7pm


Thursday — Monday 10am — 6pm
Complesso dell’Ospedaletto
Barbaria de le Tole 6691

Venice
An ecocritical laboratory projecting present Venice into the future
perdere un’opera di Pablo Picasso. E anche allora, 100 anni fa, l’idea dello sharing funzionò: i rappresentanti dei cantoni svizzeri decisero di unirsi e di acquistare l’opera per poi farla rimanere al museo.

Di particolare interesse è la proposta di sviluppare un “Laboratorio di ricerca sulla migrazione delle immagini” al fine di esplorare il movimento delle immagini stesse, nel tempo e nello spazio. Quali potenzialità e al contempo quali rischi presenta oggi l’informazione digitale per la cultura e l’arte contemporanea globale?

Il punto di partenza del progetto Image Migration Research Lab è quello di comprendere la grande cultura attraverso i dettagli della petit perception secondo la teoria di Aby Warburg (1866-1929), uno studioso tedesco che ha superato le divisioni disciplinari e unificato la storia dell’immagine visiva in un discorso continuo. Le sue idee sulla migrazione delle immagini nella cultura di oggi sviluppano le capacità del pensiero combinatorio, la capacità di parlare per immagini e la comprensione che le immagini possono essere più importanti delle parole.

Si tratta di un progetto sulla memoria dell’arte e sui suoi meccanismi: immagini migranti, gesti sostenuti, composizioni ricorrenti; è anche un progetto sull’iconologia, il campo della scienza dell’arte dedicato al loro studio, di cui Aby Warburg è stato l’ideatore.
Più di cento anni fa lo storico dell’arte tedesco propose un approccio innovativo allo studio del mondo delle immagini che contemplava non solo l’arte alta, ma anche il mondo visivo della vita quotidiana.

Siamo abituati a usare le parole per comunicare, ma nel XXI secolo è particolarmente importante essere in grado di comprendere e utilizzare in modo intelligente le informazioni visive in rapido aumento. Spero tanto che all’Università Ca’ Foscari venga istituito un laboratorio simile e che io riesca presto a parlare in italiano con sempre maggiore sicurezza, così da poter svelare i misteri che conosco. Quello che mi piace di più è collegare le immagini non solo nell’arte visiva del passato, ma anche con le immagini in movimento del presente, coinvolgendo sia la Media Art che il cinema, il teatro e persino la pubblicità.
Oggi è importante capire le immagini, vedere l’inaspettato nell’ovvio. È davvero fondamentale riuscire bene ad analizzare le immagini, sì, facendone oggetto di primario interesse delle nostre attività intellettuali. È importantissimo utilizzare le conoscenze acquisite per orientarsi in un mondo moderno il cui complesso ambiente informatico è costruito su numerosi collegamenti tra immagini del passato e del presente.
La sua voce non cessa di accusare Putin e il suo entourage di aver distrutto il futuro di almeno due generazioni. Quale il profondo valore della parola “libertà” e della parola “verità” per le nuove generazioni e in particolare per gli artisti?
Per me la parola “libertà” è associata alla caduta del muro di Berlino. Come ha scritto la filosofa e teorica Alla Mitrofanova: «Quando ci siamo trovati coinvolti nella rivoluzione semiotica della Perestrojka, stavamo cercando una nuova metafora e abbiamo trovato una nuova tecnologia. Non era un modo per descrivere il mondo, ma un modo per giocare con esso. Questo è il modo in cui abbiamo cercato di tenerla. Ma non ci siamo riusciti...».
I confini dei diversi Paesi sono stati aperti in momenti diversi. Anche la libertà nell’arte e nella società si è formata in modo diverso. Per comprendere meglio l’estetica dell’arte nell’Europa dell’Est bisogna essere ben consapevoli del fatto che gli artisti di questi paesi negli anni ‘70 e ‘80 seguivano senza riserve critiche le regole sovietiche, vale a dire i principi del Realismo socialista. Vigeva una severa censura e vi era una gamma limitata di soggetti possibili su cui potersi cimentare per realizzare opere artistiche. Uno stato delle cose che non poteva naturalmente non influire, condizionandole strutturalmente, sulle pratiche artistiche stesse. Gli artisti che si adeguavano a questi requisiti ricevevano commissioni e acquisivano un certo status, il tutto naturalmente conseguito a prescindere dalle loro effettive capacità creative. Gli artisti non ufficiali, non riconosciuti dalle autorità, lottavano per sopravvivere creando nuove forme d’arte che sfidavano il sistema ufficiale. Il controllo asfissiante esercitato quotidianamente dalle autorità spinse molti di loro a rifugiarsi in Occidente, perché nei propri Paesi non sussistevano assolutamente alternative alle forme d’arte riconosciute e il mancato rispetto delle regole stabilite poteva portare a pesantissime persecuzioni. All’inizio degli anni ‘90 i Paesi satelliti dell’URSS si sono liberati dal pensiero totalitario. All’epoca mi sembrava che anche la Russia se ne stesse progressivamente liberando. Ma non era così. Oggi sono decisamente pessimista e penso che le restrizioni in Russia siano l’unico modo per mantenere in vita quel potere che ha da sempre deciso, continuando oggi a farlo ancor più pressantemente, da solo per tutti. Ci sono molti dissidenti, ma non si può parlare.
La parola “diaspora” suscita un sentimento di angoscia che stride contro l’idea stessa di libertà intellettuale. Un tema ancora non così frequente nei quotidiani racconti che giungono dalla Russia. Cosa sta accadendo agli intellettuali in questo presente di guerra che ricorda un passato da cortina di ferro?
Ho iniziato a scrivere un libro sui piccoli e grandi passi in avanti che sono stati compiuti nella cultura degli anni ‘90 e inizio 2000 in Russia e sui passi successivi, quando tutte le iniziative libere sono ridiventate soggette a censura. Tra i protagonisti del mio libro ci sono artisti, registi, critici d’arte che hanno costruito una Russia libera, come Giya Rigvava, Kathy Ray Hoffman, Peter Weibel, Olga Lialina, Kirill Preobrazhenskiy, Anatoliy Prokhorov, Dima Krymov, Manana Aslamazian, Naum Kleiman, Tatian Mogilevskaya, Aleksei Isaev, Eugeny Sgermeneva, Ksenija Peretruchina, Viktor Misiano, Dima Bulatov, Kirill Serebrynikov, Irina Yurna, Nina Zarezkaya, Vadim Koshkin. Ma gli eroi protagonisti di questo volume non sono solo figure creative, ossia chi costruisce o studia opere d’arte, ma anche coloro i quali hanno contribuito a promuovere l’arte e, quindi, una Russia “altra”. Improvvisamente, per caso, tra tutti i miei documenti, ho trovato un progetto che avevamo cercato di realizzare nel 2002, ma per il quale non avevamo ricevuto alcun sostegno finanziario. Si trattava di Pro@Contra. Diaspora 2002: un lavoro in alcun modo offensivo verso alcunché, il cui scopo era semplicemente quello di considerare la “diaspora” informatica della società e degli individui come una nuova realtà.
È importante rilevare come i “nuovi media”, sin dal loro primo apparire negli anni ‘90, abbiano rappresentato delle pratiche, delle strategie alternative sul terreno della cultura contemporanea in Russia
così come in tutto il mondo sviluppato. Un processo che continua a evolvere incessantemente nel segno dell’innovazione quotidiana. Sono modelli di base della cultura mediale (come cultura contemporanea nell’era delle nuove tecnologie mediali) e rappresentano una parte centrale del discorso pratico e teorico al di là dei confini politici e statali. Una riflessione sulla cultura mediatica contemporanea come diaspora virtuale potrebbe diventare un anello di congiunzione nel dibattito sulla globalizzazione o sulla nazionalizzazione.
La comunità di artisti, performers, musicisti e curatori che negli anni è cresciuta nell’ambito dei suoi progetti e delle sue collaborazioni ora diviene oggetto di un’urgente ricerca curatoriale. Ci racconti com’è nato Mapping Diaspora, il progetto di ricerca ideato e sviluppato con Silvia Burini e lo CSAR che vuole documentare le tracce della produzione artistica e intellettuale di coloro i quali – artisti, intellettuali, scrittori, registi, musicisti – hanno lasciato la Russia e l’Ucraina all’irrompere di questo drammatico conflitto. Quello che succede ora è terribile e fa paura, ma c’è un flusso in atto che non si può tralasciare. «Che Dio non ci faccia nascere in un’epoca di cambiamenti», ma è successo. E l’intelligencija russa, per l’ennesima volta, è nata in un’epoca di terribili cambiamenti. I temi dell’emigrazione russa nel XX secolo sono un argomento dolente per il Paese. Cacciare un dissidente, non permettere l’espressione di un pensiero alternativo, eliminare la libertà di pensiero è qualcosa che non ha mai avuto fine nella storia della Russia del XX secolo. Tanti artisti, musicisti, performer, scrittori non cercano solo di sopravvivere; continuano a lavorare. Sentono, vivono, ognuno

usando la propria lingua. Parlano di dolore, di arresto, di perdita dell’identità, dell’assenza di una propria casa.
Pensavo a un progetto del genere fin da settembre e immaginavo di utilizzare una risorsa come quella che io e il team del museo Pushkin abbiamo realizzato durante la pandemia, 100 Ways to Live a Minute Poi quando abbiamo iniziato a parlare con Silvia Burini e i suoi giovani collaboratori tutto si è concretizzato. È diventato chiaro che questo doveva essere prima di tutto un progetto di ricerca il cui scopo primario avrebbe dovuto essere quello di collegare il passato e il presente, la tragedia dell’Avanguardia russa e ciò che si ripete oggi dopo 100 anni. Di nuovo navi con i filosofi e gli intellettuali che partono. E di nuovo tutto a frantumarsi in piccoli frammenti, in perline. E noi non vogliamo perderne nemmeno una di queste perline. Per comporre insieme un quadro dell’arte che non muore, continuando a resistere e a vivere.

Abbiamo concepito un progetto di natura scientifica che possa essere sede di raccolta e in seguito di analisi circa la produzione artistica e intellettuale di coloro che hanno lasciato la Russia. La domanda principale a cui si tenterà di trovare risposta è: cosa stanno facendo e a cosa pensano ora queste persone? Il progetto Mapping Diaspora si propone quindi di accogliere e riunire diverse forme di riflessione su una delle più cospicue e drammatiche migrazioni del nostro presente.
Quale futuro per la cultura russa alla luce di questo forzato allontanamento degli intellettuali e degli artisti?
Sono fermamente contraria alla “cancellazione” della cultura russa.
Sono contraria all’eliminazione di artisti, poeti, performer o registi
russi dal contesto della cultura contemporanea. Hanno qualcosa da dire. Un enorme numero di persone impegnate nei processi creativi la cui vita si basa sulla denuncia dell’ingiustizia ha lasciato il Paese. È una diaspora contro la guerra. Le persone scappano perché non possono accettare ciò che sta accadendo; hanno certo paura della macchina della violenza, ma hanno anche il desiderio di preservare la propria identità.
Io volevo gridare e cancellare me stessa e tutti i miei progetti quando ho letto l’intervista di Mikhail Piotrovsky. Questa è stata la più disgustosa intervista rilasciata alla «Rossiyskaya Gazeta» dal direttore dell’Hermitage: «Siamo tutti militaristi e imperialisti. La guerra è l’autoaffermazione della nazione. Le nostre ultime mostre all’estero sono solo una potente offensiva culturale. Se si desidera, una sorta di “operazione speciale”. A molti non piace. Ma stiamo arrivando. E a nessuno dovrebbe essere permesso di impedire la nostra offensiva. All’inizio dell’operazione speciale in Ucraina le mostre dei musei russi erano dappertutto. Questa era la nostra, se volete, “operazione speciale”, una grande offensiva culturale».
Un ignobile tentativo di coinvolgere indistintamente tutte le figure culturali quali complici di un crimine. Ma fortunatamente il tempo è passato e registro con sollievo oggi che la cultura russa non è stata fortunatamente abolita dai circuiti internazionali: l’opera teatrale di Kirill Serebrennikov, Il monaco nero, viene presentata a Parigi, la mostra di Sasha Pozner è stata aperta a Berlino e quella di Andrei Kuzkin ancora a Parigi, gli spettacoli di Ksenia Peretrukhina e Misha Durnenkov vanno in scena in Finlandia, il film di Vitaly Manskij è nel programma del Festival di Berlino.



Nel silenzio di un quartiere residenziale immerso nel verde e puntellato di casette basse unifamiliari in legno con giardino, lontano dai grattacieli di Houston svettanti sulla metropoli degli affari imponente quanto inspiegabilmente deserta, si viene rapiti dall’atmosfera immobile e avvolgente che circonda un edificio di mattoni ottagonale iscritto in una croce greca.
Rapisce lo sguardo e le emozioni si rincorrono sin dall’esterno, dove un obelisco, opera dello scultore Barnett Newman, si riflette in una vasca d’acqua immobile. Inevitabile la curiosità magnetica che spinge ad entrare, con un effetto attrattivo per quell’alone di mistero palpabile; uno spazio unico minimalista, dominato da 14 tele, tra cui 3 trittici, apparentemente nere a monocromo, in realtà via via trascoloranti dal marrone fino al viola a seconda dei riflessi della luce provenienti da un lucernario, unica fonte luminosa.
Commissionate nel 1964 a Mark Rothko (1903–1970) da John e Dominique de Menil – illuminati collezionisti di origine francese che fecero costruire nelle vicinanze a Renzo Piano un museo (Menil Collection) per ospitare i 17.000 pezzi della loro enorme raccolta che spazia dall’Arte Precolombiana e Africana al Surrealismo –, sono inserite all’interno di una chiesa ecumenica opera di Philip Johnson, divenuta punto di riferimento e luogo di incontro, di meditazione, di preghiera, aperto a tutte le religioni senza appartenere a nessuna, per scambi filosofici, culturali, religiosi, su temi che toccano la giustizia, la libertà i diritti umani.
Un progetto che coinvolse profondamente ed emotivamente l’artista baltico di origine ebraico-lettone; ci lavorò per tre anni ma non riuscì a vederlo finito, poiché la cappella fu inaugurata nel 1971 ad un anno dalla sua morte, improvvisa quanto tragica.
Anima tormentata, dopo aver frequentato da bambino una scuola talmudica, si trasferì dall’ovest della Russia a 10 anni nell’Oregon con la famiglia, frequentò Yale ma inquieto abbandonò gli studi e
si stabilì a New York dove, venticinquenne, partecipò ad una prima collettiva. Tra il 1936 e il ‘37 lavorò al Federal Art Project, mentre a metà degli anni ‘40 gli fu dedicata una personale nella galleria di Peggy Guggenheim Art of this Century. Fu tra i fondatori del gruppo astrattista The Ten e la sua ricerca dopo un inizio surrealista, si sviluppò nell’ambito dell’Espressionismo astratto, che lo vide tra i precursori del colour field. Ampie campiture cromatiche perlopiù suddivise in rettangoli, dove le sfumature trascolorano per suggerire emozioni, impercettibili quanto misteriose; dai colori solari dei primi anni, stemperati come fossero a pastello, gialli, rossi, arancioni, via via la tavolozza si incupì, di pari passo coi suoi turbamenti esistenziali. Perlopiù sconosciuto fino agli anni ‘60, oggi le sue opere hanno raggiunto cifre stratosferiche e da Christie’s un suo dipinto è stato venduto nel 2012 al prezzo record di 87 milioni di dollari.
Il mistero è il protagonista sotto il cielo della Rothko Chapel, quasi una sorta di sua opera-testamento, dove le tele attraggono lo sguardo, spingono a interrogarsi cercando di individuare al loro interno una risposta che si vorrebbe scoprire nella religione, nell’estetica, nella filosofia, persino nella musica. Un mistero senza risposta, come la stessa vita di Rothko che non trovò pace alla depressione insoluta e che lo spinse nell’alcol, fino al suicidio, dopo essersi tagliato le vene e aver ingerito due flaconi di sonnifero. Un silenzio che avvolge le sue 14 tele ispirate negli anni ‘50 alla trascendenza di Beato Angelico che Rothko vide a Firenze nel Convento di San Marco, e che al contrario suggerì a Peter Gabriel una sua interpretazione; nel Fourteen Black Painting la musica del compositore britannico sembra fluttuare tra quelle tele, trasformandole in pale d’altare della contemporaneità.
Michela LuceRothko Chapel Houston, Texas www.rothkochapel.org

Cult authors and directors in avant-garde Italian theatre, internationally renowned as one of the most representative, provocative, and fearless players in the contemporary theatre scene, ricci/forte – a.k.a. Stefano Ricci and Gianni Forte – are at the helm of their third edition of the Venice Theatre Biennale. After the blue of their first edition, the red of their second, it is this year the turn of green: the name of the programme is Emerald
Emerald is the colour of the 2023 Venice Theatre Biennale. A bright, shiny colour that makes us think of hope. Am I wrong in thinking that your Biennale might be a much-needed escape from reality into Emerald City, a refuge where all is possible, even learning how to live?
Theatre is reflection, reflection is doubt, doubt is transformation. Theatre is a transfiguration that helps us focus on the Real. It is the stage that allows us to surpass the uniform indolence of daily life. There is no escape here, rather, we will arrive to our authentic self.
How can you produce such an elevated programme without bowing to the mainstream? Is there a formula that can make the Biennale contaminate the whole city?
Before a festival can be there, there must be a person and their artistic and ethical principles. Its’s the principle that guide them, not policy. The only antidote to cultural slumber is a kiss, care, and honesty towards our neighbour. It will be those lips bringing awareness and waking us up.
We are looking forward to “fifteen days of dreams, discord, revitalizing chaos”. What will we start with?
For the 51st edition, and for the first time with us as curators, the Biennale will expand its Theatre calendar. Over two weeks, we will present thirteen shows and two site-specific performances of incredible currency, while certainly we do not feel sandboxed in whatever is current. We will pique the imagination with the rhythm of fantasy, keeping true to our way of thinking, and play with references, ellipses, variations through the prism of political and civic commitment and feeling. The fourteen artists will lift the curtain that impedes our vision and reveal the plot of the winter of our discontent and memorialize our multi-pronged epoch, so full of violent clashes and ferocious repression, to conquer freedom.
You mentioned it before – this year, the creations of the Biennale College are integral to the Festival. How is the Biennale College doing?
Pardon our pride, but we are very, very happy of what we did with the College. Since 2021, the year we were appointed art directors of the Theatre Biennale, we have been working as talent scouts and extended our research radius up to age 35 for directors, and 40 for playwrights. A third category, performers, will be open to foreigners, also aged up to 40. We worked with many artists and afforded them some visibility and stability while they create their own vocabulary, which hopefully will take them off the beaten track. By integrating their work in the main Biennale programme, we give them the tools to irradiate their expressive potential as long as they will be working on their projects.
Autori e registi di culto del teatro di ricerca italiano, internazionalmente riconosciuti come una delle realtà più rappresentative, provocatorie e impavide della scena contemporanea ricci/forte, al secolo Stefano Ricci e Gianni Forte, sono alla guida della loro terza edizione di Biennale Teatro. Dopo la prima edizione caratterizzata dal blu, la seconda dal rosso, quest’anno tocca al verde smeraldo, colore evocativo, perché richiama Emerald City del Mago di Oz
Un’edizione del festival incentrata sull’incantesimo, il prodigio, il teatro come possibilità di catalizzare un’attenzione e soprattutto un rinnovamento. «La possibilità di rivoluzionare. A partire dagli artisti, ma per poi portare questa ondata prodigiosa anche in platea, perché c’è bisogno di rinnovamento, c’è bisogno di una nuova assunzione di responsabilità. E attraverso il prodigio, inteso come rimessa in gioco e rimessa in discussione delle nostre certezze, false, possiamo forse gettare le basi per un futuro culturale più vicino a quelle che sono le nostre istanze». Ogni risposta è un racconto nel racconto, lo stile accarezza le vette della sublime affabulazione e il loro Festival è una fresca fonte di rigenerazione culturale.
Emerald – smeraldo – è il colore dell’edizione 2023 di Biennale Teatro. Un tono deciso, brillante che evoca una speranza. Può il teatro segnare un cambiamento in un mondo dove i palcoscenici raccontano realtà sempre più superate dal quotidiano? Sono malizioso nel pensare che la vostra Biennale rappresenta una sorta di necessaria fuga dalla realtà per calarsi in una consolatoria Emerald City?
Il Teatro è riflessione. Riflessione è dubbio. Dubbio è trasformazione. Il Teatro è trasfigurazione per mettere a fuoco il Reale: è il palcoscenico che permette di superare l’ignavia uniformata del Quotidiano; nessuna fuga ma unicamente approdo ad un Sé autentico.
Inutile negarlo, la cesura tra cultura e politica è nettissima, così come quella con il Paese. Come si riesce ad ideare una rassegna di livello così elevato senza piegarsi al pensiero “dominante”? Esiste una formula, una ricetta alchemica, un sortilegio che ci permetta di contagiare con la magia di Biennale Teatro l’intera città oltre queste due travolgenti settimane di giugno?
Prima di un Festival c’è un uomo, e i suoi principi artistico/etici: sono loro a guidarlo, non certo quelli di una governance. L’unico antidoto al sonno culturale è un bacio, cura e onestà intellettuale verso il prossimo; sarà la consapevolezza di quelle labbra a risvegliare dal torpore.
Ci attendono “quindici giorni di sogni, divisioni, di caos rivitalizzante”: se doveste offrire un vademecum degli spettacoli, come si potrebbe delineare un ideale percorso di visione?
Per la 51. edizione, e per la prima volta durante il nostro mandato, la Biennale offrirà più giorni di programmazione per il suo festival di Teatro. Due settimane durante le quali verranno presentati 13 spettacoli e due performance site-specific di una sconvolgente attualità, pur non essendo ingabbiati nella realtà dell’Oggi. Infiammando l’immaginazione al ritmo di sistole e diastole della fantasia, perseguendo un’ostinata continuità di pensiero e un prodigioso gioco di rimandi/ellissi/variazioni, attraverso un’implacabile radiografia e i prismi dell’impegno politico-civile e dell’emozione, i 14 artisti (tra italiani e stranieri) solleveranno il velo che oscura il nostro sguardo per svelare la trama degli inquietanti intrecci dell’inverno del nostro scontento, testimoniare un’epoca tentacolare come quella attuale, intrisa di spaccature, scontri violenti e sanguinose repressioni, per conquistare l’approdo di un urgente orizzonte di libertà.

Come da voi stesso annunciato, quest’anno le giovani creazioni del College sono parte integrante e cuore pulsante del Festival. In che modo si sta sviluppando il percorso di Biennale College Teatro e quali i risultati di questi primi tre anni del vostro mandato?
Inalberando un vessillo di fierezza, un bilancio entusiasticamente positivo. Dal 2021, anno in cui siamo stati nominati Direttori Artistici di Biennale Teatro, abbiamo proseguito la missione di “scopritori-rabdomanti”, espandendo l’età dei partecipanti italiani (fino a 35 anni per registe/registi e a 40 per autrici/autori) dei due Bandi College Regia e Drammaturgia, già esistenti, e inanellando un terzo Bando Performance (fino a 40 anni), anche per stranieri. Attraverso un instancabile lavoro di scouting e guida, permettendo loro di uscire dall’invisibilità e precarietà, stiamo incoraggiando la fragranza di nuove voci e le multiformi esplorazioni delle giovani generazioni di creatori, dando loro la chance di far germinare in autonomia un personalissimo alfabeto artistico e i temi cardine del loro universo poetico, fuori dai sentieri battuti, e in più la possibilità di cercare e ricercare, edificando uno spazio d’accoglienza e di scambio. Integrando i loro lavori nel cuore stesso della nostra programmazione del Festival, non relegandoli in una sezione specifica o separata, forniamo loro, per quanto possibile, i mezzi necessari per poter irradiare al meglio le loro potenzialità espressive durante tutto il processo di sviluppo dei loro progetti.

GiuJun
15
giovedìThursday
ARMANDO PUNZO
Leone d’Oro alla Carriera
NATURAE (100’)
Arsenale, Teatro alle Tese h. 20
16
venerdì Friday
ARMANDO PUNZO NATURAE (100’)
Arsenale, Teatro alle Tese h. 18
VALERIO LEONI
Vincitore Biennale College Teatro
Registi Under 35 (2022-23)
CUSPIDI **
Arsenale, Tese dei Soppalchi h. 20
17
sabato Saturday
ARMANDO PUNZO
Cerimonia di consegna
Leone d’Oro alla carriera
FC BERGMAN
Cerimonia di consegna
Leone d’Argento
A seguire, conversazione con gli artisti Moderatore: Andrea Porcheddu
Ca’ Giustinian - Sala delle Colonne h. 12
VALERIO LEONI CUSPIDI **
Arsenale, Tese dei Soppalchi h. 18
FC BERGMAN
Leone d’Argento
HET LAND NOD (95’) *
Sala Marghera, Zona Industriale h. 20
18
domenica Sunday
FC BERGMAN
HET LAND NOD (95’) *
Sala Marghera, Zona Industriale h. 20
20
martedìTuesday
FEDERICA ROSELLINI regia
GIACOMO GARAFFONI
Vincitore Biennale College Teatro
Drammaturgia Under 40 (2021-22)
VERONICA **
Teatro Piccolo Arsenale h. 20
21
mercoledìWednesday
FEDERICA ROSELLINI regia
GIACOMO GARAFFONI VERONICA **
Teatro Piccolo Arsenale h. 20
MATTIAS ANDERSSON
VI SOM FICK LEVA
OM VÅRA LIV
(Noi che abbiamo vissuto le
nostre vite di nuovo) (150’) * Teatro alle Tese, Arsenale h. 20
22
giovedìThursday
MATTIAS ANDERSSON
VI SOM FICK LEVA
OM VÅRA LIV
(Noi che abbiamo vissuto le nostre vite di nuovo) (150’) * Teatro alle Tese, Arsenale h. 18
TANYA BEYELER E PABLO
GISBERT / EL CONDE DE TORREFIEL
LA PLAZA (90’)
Tese dei Soppalchi, Arsenale h. 20
23
venerdì Friday
TANYA BEYELER E PABLO
GISBERT / EL CONDE DE TORREFIEL
LA PLAZA (90’)
Tese dei Soppalchi, Arsenale h. 18
NOÉMIE GOUDAL / MAËLLE POÉSY
ANIMA (60’)
Parco Albanese, Bissuola-Mestre h. 21.30
24
sabato Saturday
MORANA NOVOSEL
Biennale College Teatro Site-specific FLUID HORIZONS **
Campo Sant’Agnese h. 18
GAETANO PALERMO
Biennale College Teatro Site-specific SWAN **
Via Garibaldi h. 18
BASHAR MURKUS AND KHASHABI ENSEMBLE
MILK (80’) *
Teatro alle Tese, Arsenale h. 20
NOÉMIE GOUDAL / MAËLLE POÉSY
ANIMA (60’)
Parco Albanese, Bissuola-Mestre h. 21.30
25
domenica Sunday
MORANA NOVOSEL FLUID HORIZONS **
Campo Sant’Agnese h. 18
GAETANO PALERMO SWAN **
Via Garibaldi h. 18
BASHAR MURKUS AND KHASHABI ENSEMBLE MILK (80’) *
Teatro alle Tese, Arsenale h. 18
BORIS NIKITIN
VERSUCH ÜBER DAS
STERBEN (Sul morire) (55’) *
Sala d’Armi A, Arsenale h. 20
26 lunedì Monday
MORANA NOVOSEL
FLUID HORIZONS **
Campo Sant’Agnese h. 18
GAETANO PALERMO
SWAN **
Via Garibaldi h. 18
27 martedìTuesday
MORANA NOVOSEL
FLUID HORIZONS **
Campo Sant’Agnese h. 18
GAETANO PALERMO
SWAN **
Via Garibaldi h. 18
BORIS NIKITIN
HAMLET (90’) *
Teatro alle Tese, Arsenale h. 20
28 mercoledìWednesday
STEFANO FORTIN
Vincitore Biennale College Teatro
Drammaturgia Under 40 (2022-23)
CENERE **
Mise en lecture
Regia Giorgina Pi
a seguire, conversazione con Stefano Fortin, Giorgina Pi, Davide Carnevali
moderatore: Andrea Porcheddu
Sala d’Armi E, Arsenale h. 16
MORANA NOVOSEL FLUID HORIZONS **
Campo Sant’Agnese h. 18
GAETANO PALERMO
SWAN **
Via Garibaldi h. 18
ROMEO CASTELLUCCI DOMANI (30’)
Scuola della Misericordia h. 18
BORIS NIKITIN
HAMLET (90’) *
Teatro alle Tese, Arsenale h. 20
CAROLINA BALUCANI
Vincitore Biennale College Teatro
Drammaturgia Under 40 (2022-23)
ADDORMENTATE **
Mise en lecture
Regia Fabrizio Arcuri
Carolina Balucani, Fabrizio Arcuri, Davide Carnevali
moderatore: Andrea Porcheddu
Sala d’Armi E, Arsenale h. 20.30
29 giovedìThursday
CAROLINA BALUCANI
ADDORMENTATE **
Sala d’Armi E, Arsenale h. 16
MORANA NOVOSEL
FLUID HORIZONS **
Campo Sant’Agnese h. 18
GAETANO PALERMO
SWAN **
Via Garibaldi h. 18
ROMEO CASTELLUCCI
DOMANI (30’)
Scuola della Misericordia h. 18
FABIANA IACOZZILLI regia
TOLJA DJOKOVIC
Vincitore Biennale College Teatro
Drammaturgia Under 40 (2021-22)
EN ABYME **
Tese dei Soppalchi, Arsenale h. 20
STEFANO FORTIN
CENERE **
Mise en lecture
Regia Giorgina Pi
Sala d’Armi E, Arsenale h. 20.30
30 venerdì Friday
MORANA NOVOSEL FLUID HORIZONS **
Campo Sant’Agnese h. 18
GAETANO PALERMO SWAN **
Via Garibaldi h. 18
ROMEO CASTELLUCCI DOMANI (30’)
Scuola della Misericordia h. 18
FABIANA IACOZZILLI regia
TOLJA DJOKOVIC EN ABYME **
Tese dei Soppalchi, Arsenale h. 18
TIAGO RODRIGUES
CATARINA E A BELEZA DE MATAR FASCISTAS (150’) *
Sala d’Armi A, Arsenale h. 20
sabato Saturday
MORANA NOVOSEL FLUID HORIZONS ** Campo Sant’Agnese h. 18
GAETANO PALERMO SWAN **
Via Garibaldi h. 18
ROMEO CASTELLUCCI DOMANI (30’)
Scuola della Misericordia h. 18
TIAGO RODRIGUES
CATARINA E A BELEZA DE MATAR FASCISTAS (150’) *
Sala d’Armi A, Arsenale h. 20
** Prima assoluta
* Prima italiana
Il programma può subire variazioni
Info e tickets: www.labiennale.org
Intervista Armando
PunzoUna vita in carcere, senza essere un detenuto, favorendo l’apertura di spazi di cultura e libertà mentale infiniti e portando il Teatro a livelli di eccellenza con attori non professionisti. Questa potrebbe essere in estrema sintesi la bio del regista Armando Punzo, nato a Cercola (Napoli) nel 1959, fondatore della storica Compagnia della Fortezza di Volterra, la prima nata in un carcere nel 1988 e divenuta una delle realtà più importanti della scena di ricerca, cui è stato assegnato il Leone d’Oro alla carriera della Biennale Teatro 2023. Nella motivazione del Premio i direttori della sezione teatro di Biennale Stefano Ricci e Gianni Forte riconoscono a Punzo e alla Compagnia della Fortezza di avere utilizzato il teatro per «ricominciare a sognare un nuovo uomo e imporlo alla realtà nonostante il pregiudizio, perché lo spirito e la fantasia non hanno sbarre che contengano». Un percorso lungo trentacinque anni di lavoro quotidiano e a tempo pieno con circa ottanta detenuti-attori quello compiuto da un artista a dir poco intrigante quale è Armando Punzo che ha portato alla realizzazione di oltre quaranta spettacoli. I suoi lavori hanno ottenuto significativi riconoscimenti sia in Italia che all’estero: Marat-Sade, I negri, I Pescecani ovvero quello che resta di Bertolt Brecht, Hamlice - Saggio sulla fine di una civiltà, Beatitudo sono solo alcuni dei titoli che, attraverso l’indagine diffusa sui grandi temi umani, hanno fatto di un carcere penale come la Fortezza medicea di Volterra un centro culturale all’avanguardia. Lo abbiamo intervistato alla vigilia dell’assegnazione del Leone d’Oro. Ciò che emerge in maniera inequivocabile dalle sue parole è l’idea chiara e pienamente vissuta dell’associare attraverso il teatro la dimensione del carcere all’idea di libertà, contrapponendola al fatto di quanto noi esseri umani siamo prigionieri senza accorgercene.

Il Leone d’Oro alla Carriera. Cosa rappresenta per lei questo riconoscimento?
Mi fa pensare una cosa, ovvero che se c’è un’idea precisa, come la definisco nel mio libro Un’idea più grande di me (Editore Luca Sossella, 2019), e una persona lavora e vi si dedica appieno, anche se ci vuole del tempo e può risultare un percorso in salita, ad un certo punto questa idea prende piede e si impone. Mi pongo con questo spirito di fronte al Leone d’Oro. Evidentemente qualcosa nato trentacinque anni fa e che ha richiesto tanto lavoro non è stato affatto vano; ora è un’idea che può essere riconosciuta, può essere letta per quello che è, e questo secondo me è l’aspetto più importante di tutto questo lungo e duro percorso. Al di là del riconoscimento personale, quindi, il Leone d’Oro rappresenta un riconoscimento a quest’idea e a tutto il lavoro svolto per realizzarla.
Alla Biennale presenterà lo spettacolo Naturae che parla del «sogno di un’umanità perfetta e luminosa, che costituisce la nostra autentica natura», come scrive nelle note di regia. Lei ha deciso di svolgere il suo lavoro in un luogo di chiusura piuttosto che di apertura, dove c’è innegabilmente il senso del male, che in un’occasione lei ha definito “trasparente”. Può chiarirci questo concetto? Non si può sfuggire al tema del male, inteso come il male nell’uomo, il male in questo mondo. Lavorando all’interno del carcere mi sono interrogato dentro, chiedendomi quale fosse il mio rapporto con il male. Sono arrivato alla conclusione di ritenere che evidentemente per me il male è e deve essere di una densità trasparente, altrimenti diventa pietra, muro invalicabile e insormontabile. Per me il male non può che essere assolutamente trasparente, quindi, sì; non posso fermarmi a quelle che sono le cronache, le mere azioni compiute da una persona in un determinato momento. Devo saper e poter andare oltre per riuscire a vedere cosa c’è dall’altra parte. In questo
senso il male deve essere trasparente, altrimenti nulla di ciò che faccio avrebbe senso: se ci si ferma davanti al male, si possono trovare tutte le giustificazioni di chiusura del mondo. Fermarsi davanti al male non basta, bisogna provare a guardare oltre e capire cosa c’è in quell’altrove; non per giustificare, alleggerire o addirittura idealizzare alcunché, ma semplicemente perché è umanamente indispensabile, necessario cercare sempre e comunque il bene.
Questa è la mia esperienza personale. Giorno per giorno mi rendo conto quanto incessantemente vada ricercato il bene e questo non solo in carcere, ma in ogni frangente della quotidianità.
Molti non smettono di cercare il male negli altri, anche in banalissime occasioni di confronto o scontro, come possono essere quelle in famiglia o al bar; sembra sempre si vogliano far emergere gli aspetti negativi, si parla solo di quelli, tutto il resto diviene secondario. Questa è una caratteristica umana a dire il vero, forse anche culturale, ma finisce solo col suscitare ulteriore male e non porta a nulla di buono, di umanamente positivo.
Lei ha sempre asserito che il teatro in carcere è soprattutto arte. Ci spieghi meglio le ragioni di questa sua convinzione.

Preciso: il mio teatro in carcere è soprattutto arte. Esistono altre realtà e altre esperienze che invece individuano nel teatro uno strumento al servizio della rieducazione. Ecco, detto in generale, questa idea del teatro al servizio di altro scopo proprio non mi convince. Piergiorgio Giacchè, studioso e storico del teatro, aveva sottolineato questa disposizione aperta, fuori dalle strettoie canonicamente rieducative, sin dall’inizio della nostra esperienza, nei primissimi anni Novanta: da subito si era reso conto che nell’utilizzo strumentale
A life spent in prison, without being an inmate, to create cultural and mental freedom and to take non-professional theatre to the highest levels. This, in short, might be Armando Punzo’s biography. Punzo (b. 1959) is the founder of theatre company Fortezza di Volterra, the first to be established (in 1988) within a correctional facility, and is awarded the Golden Lion for Lifetime Achievement at the 2023 Venice Theatre Biennale.
The Award
One thing I wonder – if a given idea is there, and one works on it and dedicates their life to it, it might take a long time, but in the end, that very idea will get big, and get real. This is how I feel about the Golden Lion. Something that I started thirty-five years ago, something that needed so much effort and so much work, hasn’t been in vain. It is an idea, now, that can be recognized and acknowledged for what it is. That’s what counts. Whatever the personal recognition may be, the Golden Lion is all about one beautiful idea.
Theatre, prisons, art
The theatre I make in prison is, above all, art. There are other ways and other experiences that use theatre as a tool for rehabilitation. To be frank, this idea of theatre serving a goal does not convince me at all. Art is contradictory, it must be free. I have never seen my experience at the Fortezza as an idea of saving anyone. If I ever had to save someone, I’d be needing to save myself first! I entered the prison for a different reason: I thought Theatre had to be re-established, and challenged in a difficult place. I wanted maximum openness and maximum closure to react.
The Company
I am there every day. As soon as I started in 1988, I understood that I just couldn’t leave at any time. Prison is like a black hole that eats everything, it is its nature. Prison has been created with the deliberate intent to annihilate basic human nature and eat anything positive that could have happened inside. This job I chose is a daily fight. The Company comprises over eighty people. In-house shows are produced by anything from sixty to eighty people, while when we are on tour, obviously not everybody can come. This is why we make two parallel productions, one for the inside and one for the outside. Last summer, some thirty people were granted permission to tour, which is a high number, given the circumstances.
Your upcoming show, Naturae
Naturae came after eight years of work. In brief: eight years ago, we started working on Shakespeare and the humanity Shakespeare wrote about. His characters look like us, dramatically, tragically, both the good and the bad. We wondered if it was about time to question if humankind was actually destined to be that way forever, because after four centuries, not much seems to have changed. We worked on the demolition of Shakespeare and produced Dopo la Tempesta (lit. ‘after the tempest’). Our idea was to never stage anything that could be read under the classical canons of theatre. The lead character stops, surrounded only by ghosts, and realizes that nothing he does makes sense anymore. Enter a small child – innocence personified. The child takes the lead actor by the hand, and offstage they go, leaving humanity hanging and embarking on a journey towards new possibilities. In the meantime I read Borges, an author that may accompany us and tell us where to take this lead actor. With Borges and Beatitudo, we worked on a more two-dimensional kind of humanity. After two years, this show also comes to an end, the child is back, once again taking the actor away. What we will show in Venice is the last phase, the naturae (lit. ‘natures’) are part of the human being that may look unimportant, like harmony, which we all know well but we don’t nurture much. We then worked on the idea of so-called ‘secondary’ human qualities that do exist, but are neglected. Our show is an attempt to tell the story of a man who gives life to his natures, showing what will happen if we just give more space to our qualities. We are not prisoners of the human nature Shakespeare wrote about. To most, the topic of being human in all its unravelling complications always look interesting, but to me… I find it a bit shallow, obsolete, and dusty.
di questo linguaggio espressivo vi è qualcosa di costitutivamente sbagliato, che depotenzia il teatro e l’atto artistico in sé. L’atto artistico è contraddittorio, deve essere libero, non può essere vincolato a un fine, perché altrimenti si perde il senso di cosa sia l’arte, ovvero un viaggio di conoscenza. L’arte non è una tesi, qualcosa di già pronto, confezionato; è piuttosto un dirigersi verso un tema e casomai scoprire di aver cambiato punto di vista su quel tema stesso nel corso del tempo. Quindi l’arte deve essere un percorso di scoperta e di conoscenza prima di tutto per l’artista e in secondo luogo per il pubblico che eventualmente ne fruisce.
L’idea del teatro come strumento di rieducazione rappresenta a mio avviso uno svilimento del teatro stesso; nel mio caso, quindi, rappresenterebbe una detrazione radicale dell’identità prima del mio progettare, perché non sono entrato a lavorare in carcere per questi motivi. Non ho mai vissuto l’esperienza della Fortezza accompagnato dall’idea di poter salvare qualcuno; se avessi dovuto salvare qualcuno, avrei dovuto salvare prima di ogni altro me stesso! Sono entrato in carcere mosso da ben altre ragioni, in primis dall’idea che il Teatro andasse rifondato mettendolo alla prova in un luogo difficile. Più nello specifico pensavo a come fare reagire massima chiusura e massima apertura insieme: la massima chiusura è rappresentata naturalmente dal carcere, mentre la massima apertura è il teatro, che credo personifichi lo spazio di maggior libertà in assoluto, ed è geneticamente, fisiologicamente così.
Leggendo le sue note biografiche pare che l’insoddisfazione verso il teatro con cui si trovava a fare i conti era tale che la Rocca di Volterra è arrivata quasi come una folgorazione, si può dire che sia stata la sua “via di Damasco”. Come è nata questa esperienza e perché proprio il carcere di Volterra, considerato di massima sicurezza, con detenuti che devono scontare pene anche molto lunghe, se non addirittura ergastoli?
Il fatto che Volterra sia una casa di reclusione dove si scontano pene molto lunghe costituisce un aspetto importante di questo progetto, perché con persone che hanno davanti a sé molti anni di pena è possibile svolgere un lavoro anche nel tempo, a differenza di quanto potrebbe accadere in un carcere circondariale, dove la permanenza è molto più breve. In teoria quest’ultima potrebbe sembrare una migliore opportunità, ma nel concreto non è così, perché i detenuti non vivono la prospettiva di un lungo arco temporale di detenzione, proiettandosi già all’esterno e di conseguenza meno interessati a scoprire e intraprendere percorsi nuovi. Al contrario una persona in carcere con una pena molto lunga, se decide di interfacciarsi a qualcosa di stimolante, in questo caso al teatro, può effettivamente compiere un’esperienza formativa importante, fino a potersi costruire un nuovo profilo professionale. Nel caso nostro divenendo magari a tutti gli effetti un attore, o comunque arrivare ad occuparsi di arte a livello professionale e non soltanto per un certo periodo ristretto della propria vita.
Una curiosità: quando lei entra in contatto con i detenuti le loro storie la influenzano oppure, trovandosi in quel luogo, il loro ‘curriculum’, se così possiamo chiamarlo, diventa a tutti gli effetti un elemento marginale da prendere in considerazione nel suo percorso di lavoro?
Non ho mai voluto leggere i loro fascicoli o essere messo a conoscenza di fatti specifici oggetto della loro detenzione. Naturalmente con il tempo ho saputo e imparato tanto di loro personalmente, ma non è davvero questo l’aspetto più rilevante del percorso. Se io entrassi in carcere e prima di incontrare una persona mi andassi a leggere il fascicolo per sapere tutto quello che ha fatto o detto, a che scopo dovrei farlo? Il mio problema, il mio obiettivo, è capire cosa possiamo fare insieme dal momento del nostro incontro in poi. Il passato fa parte del passato e di una vita ordinaria, per quanto irregolare essa sia stata, mentre a me interessa andare oltre l’io ordinario, voglio conoscere qual è l’io straordinario che possiamo mettere in campo io e quella determinata persona, o quello specifico gruppo di persone: questo è veramente l’elemento sostanziale, direi identitario dell’atto artistico. Ad altri interessa invece maggiormente l’io ordinario, il classico “inciucio da bar” per sapere cosa ha fatto questo o quell’altro; una morbosità questa sì deviata che mortifica l’essere umano.
Di quante persone è composta la Compagnia e come si struttura il lavoro all’interno del carcere?
Io sono lì presente tutti i giorni. Dal 1988 ho capito che non potevo lasciare il carcere. La prigione è come un buco nero che inghiotte tutto, è la sua natura. È stata creata appositamente con l’intento di annichilire la natura umana di base e poi rimangiare tutto quello che di positivo potrebbe essere fatto lì dentro: con questo luogo, lavorandoci, si ingaggia una battaglia quotidiana. La Compagnia è composta da oltre 80 elementi e normalmente in scena siamo tra le 60 e le 80 persone per gli spettacoli presentati in carcere, mentre quando andiamo in tournée chiaramente non tutti possono uscire, quindi abbiamo due scritture parallele, una per l’interno e una per l’esterno. La scorsa estate ne sono usciti una trentina per recitare nelle scene “normali”, un numero comunque significativamente assai alto considerando la provenienza.
Come è cambiato il rapporto con le istituzioni nel corso di oltre trent’anni?
È stato un crescendo di apertura e possibilità. All’inizio, stiamo parlando di trentacinque anni fa, la struttura carceraria nel suo complesso, sia agenti che detenuti, non capivano chi fosse questa figura di artista che entrava nel loro spazio con una proposta decisamente fuori dagli schemi. Alcuni tra gli agenti pensavano fossi stato mandato dalla camorra, mentre i detenuti credevano io fossi una sorta di spia, un delatore incaricato dall’istituzione carceraria al fine di carpire i loro segreti. È stato un lavoro lento, lunghissimo, anche molto difficile e conflittuale in alcuni momenti, per affermare in maniera inequivocabile che il mio unico intento era fare arte. Mi interessava l’uomo da quel punto di vista, tutto il resto no, né il carcere, né tutte le altre beghe; desideravo solo avere spazio, tempo e persone con cui stare insieme e con cui poter lavorare. Ho dovuto conquistare progressivamente il mio spazio e devo farlo ancora oggi, anche se chiaramente ora riesco a fare cose che trentacinque anni fa erano semplicemente impensabili. È stata la lenta conquista di un’apertura; il teatro si è guadagnato lo spazio immaginativo, ha messo solide radici dentro a un carcere e quindi questa apertura continua ad espandersi. All’inizio era davvero molto faticoso. In verità continua ad esserlo, perché bisogna comunque giorno per
EACH OF THE TEN ROOMS IS CHARACTERIZED BY A PRECISE IDENTITY. DURING THE RESTORATION, THE HISTORY AND TRADITIONS OF VENICE WERE CAREFULLY PRESERVED, AND ARE NOW ENHANCED BY THE MODERN DESIGN OF THE SELECTED FURNISHINGS AND FABRICS. A MAGICAL PLACE FOR HOLIDAYS, PRIVATE FUNCTIONS, WEDDINGS, EXCLUSIVE EVENTS OR FAMILY CELEBRATIONS. HOTELHEUREKA. COM





SABATO 1° APRILE
ORE 19.30
SCUOLA GRANDE
S. GIOVANNI EVANGELISTA
La Belle Époque
delle compositrici
Pierre Fouchenneret violino
Lise Berthaud viola
Yan Levionnois violoncello
Adam Laloum pianoforte
opere per archi e pianoforte di Strohl, Fleury, Sohy, L. Boulanger e Bonis
DOMENICA 2 APRILE
ORE 17
Racconti fantastici
Jean-Frédéric Neuburger pianoforte
Contes fantastiques di Dillon
MARTEDÌ 4 APRILE
ORE 18
Zitelle e putte.
Le sorprendenti protagoniste della musica veneziana conferenza di Valeria Palumbo
VENERDÌ 14 APRILE
ORE 19.30
Note flautate
Juliette Hurel flauto
Hélène Couvert pianoforte
opere per flauto e pianoforte di Holmès, Bonis, Grandval, Chaminade e L. Boulanger
MARTEDÌ 18 APRILE
ORE 19.30
Sottovoce
Cyrille Dubois tenore
Tristan Raës pianoforte
mélodies di Strohl, Grandval, Lemariey, Grumbach, Holmès, Damaschino, Jaëll, Chaminade...
GIOVEDÌ 27 APRILE
ORE 19.30
Quartetto romantico
Alexandre Pascal violino
Léa Hennino viola
Héloïse Luzzati violoncello
Célia Oneto Bensaid pianoforte
opere per archi e pianoforte di Grandval, Strohl e Jaëll
VENERDÌ 5 MAGGIO
ORE 19.30
Il tempo delle ambizioni
Sergej Galaktionov violino
Amedeo Cicchese violoncello
Linda Di Carlo pianoforte

opere per trio con pianoforte di Farrenc, Grandval e Chaminade
GIOVEDÌ 11 MAGGIO
ORE 19.30
Sulla corda
Johannes Gray violoncello
Anastasiya Magamedova pianoforte
opere per violoncello e pianoforte di Strohl, Renié e Jaëll
Visite guidate gratuite

Il Palazzetto Bru Zane offre ogni giovedì delle visite guidate gratuite con i seguenti orari
14.30 italiano
15.00 francese
15.30 inglese
Palazzetto Bru Zane
San Polo 2368, Venezia
+39 041 30 37 615
tickets@bru-zane.com
Biglietti 15 | 5 euro*
*studenti e minori di 30 anni
BRU-ZANE.COM
giorno affermare le nostre necessità e anche i diritti e l’esistenza di questo lavoro.
Torniamo allo spettacolo Naturae : ce ne può raccontare la genesi? Cosa effettivamente vedremo a Venezia?
La genesi in realtà è molto complessa: si tratta di ben otto anni di lavoro. In estrema sintesi: otto anni fa Shakespeare e l’umanità che racconta sono divenuti il nostro tema di lavoro. Un tipo di umanità che ci assomiglia drammaticamente, tragicamente, sia negli aspetti positivi che in quelli negativi. Non parlo solo delle tragedie, del sangue, delle vendette, ma dell’essere umano così come noi lo comprendiamo, come lo viviamo, così come noi siamo in definitiva.
Abbiamo preso ad esempio questa esperienza di narrazione dell’essere umano chiedendoci se effettivamente non fosse arrivato il momento di metterla in crisi, perlomeno in discussione, provando a domandarci se l’essere umano è e sarà sempre davvero solo così, perché è questo ciò che ci consegna Shakespeare, ovvero la sensazione che nulla mai cambierà, perché sono passati quattro secoli eppure siamo ancora fermi allo stesso punto.
Abbiamo svolto un lavoro enorme per cercare di demolire quest’immaginario shakespeariano fino ad arrivare a Dopo la Tempesta, diretto riferimento all’ultimo testo del Bardo, dove l’idea era quella di non mettere più in scena alcunché di tangibile, di tradizionalmente leggibile con i canonici registri teatrali. Il capocomico si ferma e ha intorno a sé solo fantasmi; ripensa a questi fantasmi, che tante volte ha messo in scena lui stesso, ma ad un certo punto è come se si rendesse conto che quello che fa non ha più alcun senso e quindi ferma il gioco della rappresentazione dell’uomo. Interviene un bambino molto piccolo, nel nostro caso era Marchino, il nipote di un amico, che rappresenta l’innocenza. Alla fine di questo primo lavoro, Marchino prende il capocomico per mano e lo porta via, lasciando lì ferma quell’umanità e iniziando un viaggio alla scoperta di altre possibilità.
Nel frattempo ho letto Borges e ho individuato in lui un autore che ci poteva accompagnare per capire dove condurre questo capocomico. Con Borges e Beatitudo abbiamo affrontato un’altra umanità, più bidimensionale; è stata una vera sfida, perché con Borges non riesci ad immedesimarti o ad avere lo stesso approccio che puoi avere con Shakespeare. Passati due anni di lavoro, anche al termine di questo spettacolo, ritorna il bambino a prendere per mano il capocomico e lo porta di nuovo via con sé, fino ad arrivare a Naturae, nelle sue diverse declinazioni. Quella che verrà mostrata a Venezia è l’ultima fase e rappresenta l’idea di mettere in luce queste “naturae”, cioè parti all’interno dell’essere umano che sembrano essere minoritarie, come ad esempio l’armonia, una qualità che tutti conosciamo benissimo ma che frequentiamo poco. Abbiamo iniziato dunque a lavorare sull’idea di queste qualità umane considerate “secondarie” che esistono concretamente, ma che vengono normalmente trascurate. Lo spettacolo è il tentativo di raccontare un uomo che dà vita alle sue “naturae”, mostrando cosa accade se diamo più spazio alle nostre qualità, senza essere sempre prigionieri di questa natura umana per come viene descritta e raccontata da Shakespeare, ma più in generale per come viene restituita ancora oggi da tanti scrittori, artisti e teatranti. Il tema dell’essere umano letto nelle sue più aggrovigliate contraddizioni sembra sempre attuale; io trovo che sia invece un argomento semplicemente superficiale e anche forse
superato, polveroso, nonostante molti artisti si credano rivoluzionari nel trattare sempre questi temi di ‘attualità’. Ora abbiamo addirittura l’Europa che ci fornisce i temi contemporanei di cui occuparci, come ad esempio i migranti… Un dettato “corretto” che personalmente non mi coinvolge e non mi convince in alcun modo.
Lei ha già lavorato alla Biennale nel 1999-2000 con dei laboratori di produzione, quindi si tratta di un ritorno a Venezia. A guardare i dati degli spettatori del teatro “ufficiale” pare ci sia di che preoccuparsi, mentre festival come la Biennale Teatro trasmettono la sensazione di un fermento, in particolare per il crescente interesse e la rinnovata partecipazione da parte dei giovani verso questa forma espressiva. Dal suo osservatorio particolare come vede il presente e il futuro prossimo del teatro nel nostro Paese?
Mi sembra ci sia stato un grande fiorire di interesse attorno al teatro anche in questi difficili anni di chiusure e riaperture; bisogna fortunatamente riconoscere che le persone vanno ancora a teatro, sì. Che l’Italia sia sempre un po’ indietro rispetto alle innovazioni penso faccia parte della natura del nostro Paese, incline da sempre a una sorta di innata chiusura verso il nuovo a favore di tutto ciò che è tradizione. Però io nutro fede, perché evidentemente ci sono degli spazi, e la Biennale è sicuramente uno di questi, dove è possibile confrontarsi con quanto di nuovo e anche contraddittorio c’è al momento, e questo è fondamentale. Quindi, sì, ci sono degli spazi in Italia; la vera questione è che ce ne dovrebbero essere di più. Ad esempio abbiamo avuto in visita recentemente delle scolaresche da Livorno, prime e seconde classi delle scuole superiori, e mi sono reso conto di quanto lavoro serva ancora fare non tanto per raccontare il mio teatro in carcere, ma proprio per far capire quanto sia importante riuscire a sviluppare dei punti di vista diversi scoprendo ciascuno le proprie potenzialità. Mi colpisce molto quanto questo purtroppo venga poco praticato un po’ ovunque.
Ora sta per riuscire a dare una concretezza materica al proprio teatro grazie al progetto di Mario Cucinella, in cui finalmente si delinea uno spazio fisico per un pubblico più vasto all’interno del carcere di Volterra. Diventare un teatro stabile nel ventre di una struttura carceraria è sicuramente una grande conquista. Ci sono altri esempi di questo tipo in Europa o nel mondo?
No, non c’è nessuna esperienza così longeva. E non c’è nessuno che abbia fondato il proprio lavoro artistico solo su questo tipo di esperienza, nel senso che io faccio questo in maniera esclusiva, non è uno dei vari miei lavori: è il mio lavoro, mentre normalmente questo tipo di interventi si fanno o per periodi limitati o per progetti ben definiti. Non ci sono esperienze simili per ora. Credo di non peccare di presunzione dicendo che si tratta di un’esperienza di rara importanza, ma quel che è ancora più significativo è che una simile esperienza si stia consumando proprio in Italia, perché siamo da sempre abituati a pensare che cose del genere debbano accadere necessariamente altrove, quando invece l’Italia ha una legge precisa che regola questo genere di attività. Senza parlare della Costituzione, che è straordinaria e che per prima permette che queste esperienze si possano concretamente realizzare. Il progetto di Mario Cucinella poi è qualcosa di davvero importante, di veramente prezioso.
Instancabili rabdomanti dell’eccellenza contemporanea, i direttori ricci/forte non potevano perdere l’occasione di presentare nel loro “vibrante e ipnotico laboratorio di creazione scenica” un prodigio quale la compagnia fiamminga FC Bergman, tra le formazioni più innovative e originali del panorama europeo, che con il proprio linguaggio sfida lo spazio teatrale e il pubblico stesso ad abbandonare convenzioni e aspettative per abbracciare una visione artistica audace e provocatoria. Il collettivo, costituito nel 2008 dagli attori/registi/artisti Stef Aerts, Joé Agemans, Bart Hollanders, Matteo Simoni, Thomas Verstraeten e Marie Vinck, è noto per non porsi limiti, o meglio, per infrangerli tutti. Che si tratti di trasportare il palco in un salone costruito tra quinte di navi svettanti nel porto di Anversa (Terminator Trilogy), di trasformare la platea in una piscina di marmo ( About Reynard the Fox ), di edificare una torre di 4 piani con 25 stanze e ascensore ( J.R.), di prolungare la scena oltre un’enorme parete trasparente in una foresta di felci (Van der Vos), o di immergere pubblico e attori in un villaggio nel mezzo del bosco ( 300el x 50el x 30el ), FC Bergman crea sempre veri e propri mondi, servendosi di architetture immaginifiche e fuori misura.
«Con le loro creazioni – scrivono Stefano Ricci e Gianni Forte nella motivazione – gli artisti fiamminghi FC Bergman, ispirandosi al cinema, alla letteratura e alla storia dell’arte, amalgamando un’estetica pittorica e l’uso di una tecnologia molto avanzata con i grandi racconti allegorici-medievali-biblici, plasmano un originale linguaggio di teatro-danza site-specific, poetico e al tempo stesso irriverente, che rilascia una sensazione di sconcertante disagio nello spettatore. Utilizzando riferimenti, simboli e immagini profondamente radicati nella cultura e civiltà occidentale, sfuggendo alla dittatura del punto di fuga dei teatri all’italiana con prospettive organizzate in vorticosi tableaux vivants e riservandosi un margine d’imprevedibilità e improvvisazione, gli FC Bergman flirtano con i limiti del fattibile, creando delle apocalittiche favole moderne, spesso senza parole ma di sorprendente forza plastica e potere evocativo, focalizzandosi così sull’Uomo – combattuto tra il desiderio esistenziale di trascendere i propri perimetri e la paura di un cambiamento – seguendolo nelle sue commoventi odissee che si metamorfizzano poi in tragicomiche disavventure». Per la prima volta alla Biennale Teatro, FC Bergman presenta uno dei suoi spettacoli più celebri, offrendo al pubblico un’esperienza immersiva unica con la prima nazionale di Het Land Nod (La Terra di Nod). Il teatro esce dal teatro per andare a ricostruire, in un immenso hangar nella zona industriale di Marghera, la copia esatta e in scala reale dell’imponente Sala Rubens del Museo di Belle Arti di Anversa. Uno spettacolo privo di parole, dall’impatto visivo grandioso in cui lasciarsi trascinare senza remora alcuna dalla poesia delle immagini e dall’energia delle acrobazie. Chiara Sciascia
Tireless diviners of modern excellence, the ricci/forte team couldn’t miss the chance to present a prodigy such as Flemish company FC Bergman, one of the most innovative and original formation in Europe, who defy theatrical space as well as the audience with their daring, provocative work. The collective, which includes actors/directors/artists Stef Aerts, Joé Agemans, Bart Hollanders, Matteo Simoni, Thomas Verstraeten, and Marie Vinck, has been founded in 2008 and is known for having no boundaries, or rather, for tearing them down as they see them. Their shows include installations at Antwerp Harbour (Terminator Trilogy), a parterre-turned-marble pool (About Reynard the Fox), a four-storey tower ( J.R.), a fern wood (Van der Vos), and a village in a forest (300el x 50el x 30el ). Everyone is a universe in itself, making use of fantastic architecture. In Stefano Ricci’s and Gianni Forte’s words: “FC Bergman took inspiration from cinema, literature, and art history to create a mix of pictorial aesthetics, modern technology, medieval and biblical allegory, dance, theatre, and poetry. They use references, symbols, and images that are deeply rooted in the audience’s culture and in western civilization. Their tableaux vivant-like installations and their taste for unpredictability and improvisation help them flirt with the limits of what’s feasible to create modern apocalyptic stories, often wordless, though surprisingly capable of plastic force and evocative power. They focus on Man and his struggle between the existential desire to transcend his perimeter and his fear of change, following him in poignant odysseys that transform in tragicomical misadventures.” For the first time at Biennale Teatro, FC Bergman present one of their most famous shows: Het Land Nod (Nod’s Land). Theatre walks out of time and rebuilds, in the Marghera industrial district, the imposing Rubens Hall of the Fine Arts Museum in Antwerp. The show uses no words – only grandiose visual impact, the poetry of image, and the energy of acrobatics.
Het Land Nod
17, 18 giugno Zona industriale, Marghera
Consegna Leone d’Argento
17 giugno h. 12 Ca’ Giustinian, Sala delle Colonne
www.labiennale.org

Gli Incredibili Ai fiamminghi FC Bergman il Leone d’Argento 2023© Kurt Van der Elst

C’era una volta la Svezia, Paese incontaminato, esempio per tutti di socialdemocrazia e campione di rispetto dei diritti umani. Libertà e facilità nei rapporti. Lavoro per tutti. Vi ho vissuto e lavorato negli anni Ottanta. L’ho amata proprio per questa attenzione verso gli altri, per una cultura industriale decisamente orientata alla motivazione. Ricordo di aver visitato una prigione nei pressi di Gothenburg: villette a schiera in mezzo al verde, nessuna recinzione visibile, televisore in ogni camera.
Ma il mondo cambia e Mattias Andersson ne è l’occhio e il testimone. Nasce come attore, poi drammaturgo e oggi direttore artistico della più importante istituzione teatrale della Svezia: The Royal Dramatic Theatre, da tutti conosciuto come Dramaten, a Stoccolma. Un’istituzione dalla cui scuola sono nati attori del calibro di Greta Garbo, Ingrid Bergman, Max von Sydow, Bibi Andersson, per citarne solo alcuni.

Prima, Mattias era stato per quindici anni direttore artistico e anima creativa del Backa Theater, molto conosciuto e attivo a Gothenburg, con la vocazione di richiamare i giovani al teatro e alle sue attività socializzanti.
Il 21 e 22 giugno lo vedremo al Teatro alle Tese all’Arsenale con Vi som fick leva om våra liv, ovvero come possibile traduzione Noi che abbiamo vissuto le nostre vite di nuovo Abbiamo voluto conoscerlo più da vicino.
In una Biennale che ha tra le proprie priorità la formazione e la promozione di giovani artisti, le vorremmo chiedere come e perché si è dedicato al teatro e quali sono state le sue esperienze precedenti.
Ho avuto una formazione da attore all’University College of Acting di Gothenburg, tuttavia ho iniziato a scrivere teatro molto prima, quando frequentavo il liceo. Nel corso degli anni ho fatto l’attore mentre continuavo a scrivere, poi il regista sempre da libero professionista. Ho lavorato moltissimo al Backa e nel 2007 ne sono diventato direttore artistico. Dal 2020, invece, ho assunto il mio attuale
incarico di direttore artistico al Dramaten, il Teatro Reale Drammatico di Stoccolma.
La sua vita prima del 2007?
Era tutto più difficile. Volevo disperatamente portare in scena i miei progetti, ma non sempre era possibile trovare i finanziamenti. A volte riuscivo a realizzare qualcosa grazie alla commissione di qualche ente pubblico, altre volte riuscivo a produrre qualcosa autofinanziandolo. Ero sempre in giro. All’epoca facevo di tutto pur di stare in teatro il più possibile; ho addirittura accettato l’incarico di addetto alle pulizie per stare vicino alle scene. Non avevo ancora vent’anni, ma il teatro era già il mio interesse esclusivo.
Ho avuto la possibilità di vedere il suo spettacolo
The Misfits a Bologna nel 2016. Una narrativa molto cruda sulla gioventù bruciata, sugli emarginati, sul sacrificio di capri espiatori in una società dominata da una gerarchia basata su soldi e potere. Spettacolo in un certo senso emblematico della sua produzione al Backa e del teatro stesso.
Il Backa è molto simile a un progetto sociale e si rivolge a un pubblico eterogeneo per estrazione economica, di classe e anche per etica. È stato molto interessan-
te creare teatro e al tempo stesso creare significato per affrontare le questioni sociali del momento attraverso l’arte, senza ricorrere a mezzi pedagogici usuali, in modo da fornire al pubblico strumenti alternativi di comprensione e riflessione sul mondo in cui ci troviamo oggi a vivere. Tuttavia non è mai stato nostro interesse forzare una tesi politico-sociale piuttosto che un’altra.
Il teatro è però anche intrattenimento. Come gioca questo fattore nei suoi lavori?
Certo, io e tutti noi abbiamo bisogno anche di questo e ne avremo bisogno per generazioni. È chiaro che lo spettacolo deve essere attraente e intrattenere, anche se intrattenimento non significa per forza superficialità o impossibilità di affrontare temi complessi. È necessario che il pubblico sviluppi un interesse per questa forma d’arte, che ne sia attratto. Il mio desiderio è che l’esperienza teatro rimanga viva e attiva per generazioni.
Come definirebbe il suo ruolo?
Sono prima di tutto un drammaturgo. Anche se in quest’ultima opera mi baso su atti documentari e fatti realmente accaduti, il testo è sempre una mia creazione. Nello spettacolo che porteremo a Venezia utilizzo a piene mani interviste condotte da sociologi e ricercatori, ma questo è in qualche modo solo il materiale grezzo, su cui poi intervengo creando una composizione autonoma.
Come ha operato nella scrittura di questo testo?
Per questo lavoro ho iniziato analizzando le interviste, centinaia di pagine da assorbire ed indagare in profondità. Poi ho cominciato a scrivere, cercando di dare a queste interviste un ritmo, che è ciò che dà forma allo spettacolo. Ho inserito gli attori in campo aperto, provando ad associare persone diverse a testi diversi. Mi sono servito anche dell’aiuto di un coreografo, quindi nella versione finale vedrete anche molta danza. Il risultato è un lavoro collettivo, grazie anche all’apporto prezioso che gli attori hanno dato nelle prove. È un lavoro da svolgere “step by step”, che impone di andare avanti e tornare spesso indietro, riscrivendo anche interi passaggi; si tratta di operare grandi e piccoli cambiamenti incessantemente, di essere disponibili a rivedere tutto da capo ogni volta. Gli attori sono agenti di cambiamento e al contempo devono essere in grado di accettare cambiamenti nei loro ruoli anche all’ultimo minuto. Tutto è in divenire sino al debutto. Se alla fine tredici sono gli attori in scena, in realtà almeno altri cento hanno contribuito in qualche modo all’esito conclusivo della messinscena.
Lavorare al Dramaten non è facile. È il teatro più grande di Svezia, le produzioni sono numerose. L’attenzione dei media verso le sue attività e le sue proposte è alta ed intensa, conseguentemente la qualità degli spettacoli deve sempre essere a sua volta elevata.
Once upon a time, there was Sweden. A beautiful, pristine land, an example of social democracy and a champion of human rights. Free, easy, friendly. A job for everyone. I lived and worked there during the 1980s. I loved how attentive Sweden was to people’s needs, and I loved its motivational industrial culture. I remember once visiting a prison outside Gothenburg: rowhouses surrounded by greenery, no fences around them, and a TV in every room. The world changes, though, and Mattias Andersson will be our witness and our eye on the times. Andersson is an actor turned playwright, now art director of the most important theatre in Sweden: The Royal Dramatic Theatre (the Dramaten) in Stockholm, an institution that oversaw the growing careers of Greta Garbo, Ingrid Bergman, Max von Sydow, Bibi Andersson, among others. Before that, Mattias Andersson had been art director at the Backa Theatre in Gothenburg for fifteen years.
On June 21 and 22, we will meet Andersson at the Arsenale with Vi som fick leva om våra liv, or We who lived our lives over. We wanted to get to know him better.
One of the Biennale’s priorities is the education and mentorship of young artists. Tell us more about why you chose theatre and about your earlier experiences.
I got my education as an actor at the University College of Acting in Gothenburg, and I have been writing plays since I was in high school. Over the years, I kept on writing, both when I worked as an actor and as a director. I got my job at Backa as its art director in 2007, and since 2020, I work in the same capacity at the Dramaten.
Harder. I wanted so much to see my plays on stage, but often I just couldn’t get the means to do it. Sometimes, I was able to start a production thanks to public funds, other times, I would finance it myself. I was always hustling; I did everything I could to just be at theatre all the time. I worked as a janitor, as well. I wasn’t even twenty, and theatre was all I could think about.
I saw your play The Misfits in Bologna in 2016. A raw story on wasted youth, marginalization, scapegoating in a society built on money and power. The show is, in a way, an example of your time at Backa and of theatre itself.
The Backa is similar to a social project and speaks to a diverse audience in terms of socio-economic
È necessario che il pubblico sviluppi un interesse per questa forma d’arte, che ne sia attratto. Il mio desiderio è che l’esperienza teatro rimanga viva e attiva per generazioni
A game ENG of if
Lei ha anche lavorato sul filone dei polizieschi nordici, che sono diventati negli ultimi decenni celebri in Italia e in tutta Europa. Abbiamo anche notato molta attenzione a Dostoevskij…
Ho lavorato sul nordic crime in un progetto molto specifico. Questo genere ha sicuramente portato immagini sanguinose sui nostri schermi, violenza mista a intrattenimento che entra nelle case la sera, all’ora di cena. Queste produzioni costruiscono sicuramente una particolare narrazione della nostra società. Ciò che personalmente ho cercato di fare è di associare ad essa del materiale documentario. È molto interessante vedere come l’industria televisiva riproduca stereotipi e narrazioni sulla società contemporanea, ritraendo l’attrazione verso la violenza che esiste realmente ed è di anno in anno crescente nella società. Condivido il parere di molti osservatori e critici di questi prodotti sul fatto che l’industria dell’intrattenimento possa contribuire non poco a questa crescita. Di Dostoevskij, a cui ho attinto per film per la tv svedese e per la radio, in particolare nel lavoro Delitto e Castigo, mi ha interessato la tematica relativa al perdono, al valore assoluto della creatura umana, all’etica nel contesto di un omicidio.
Pensa che il teatro debba anche combattere la violenza? Il teatro oggi è un’alternativa all’esperienza individualistica delle nostre micro piattaforme, telefonini, tablet, computer… Andare a teatro significa trovarsi insieme in una stessa sala e vivere un’esperienza collettiva. In questo senso il teatro è motore di empatia e umanità, di

possibile comprensione reciproca. Non penso che lo spettacolo sia di per sé interattivo, ma il solo fatto di condividere un’esperienza comune crea una forma di dialogo, dimensione sideralmente altra e decisamente più socializzante rispetto al trascorrere ore e ore a guardarsi video su TikTok, Instagram o YouTube chiusi soli nella propria stanzetta. È questo che fa la differenza, e che differenza!
Non possiamo non rivolgerle la stessa domanda che sta alla base del suo spettacolo We who lived our lives over : cosa farebbe se avesse la possibilità di vivere la sua vita una seconda volta?
È una domanda assai drammatica, perché ti costringe a pensare a cosa possiedi, a cosa hai realizzato, a quali sono stati i tuoi successi nella vita.
Ovviamente mi considero un privilegiato, vivo in un Paese sicuramente dal buon tenore di vita. Posso fare quello che voglio e dispongo di molti beni e servizi. A volte penso però che dovremmo lavorare di più per gli altri che per noi stessi; non lo so, mi sembra che vi sia un che di decisamente narcisistico nel fare arte. È però anche vero che le altre persone sono sempre pronte a giudicare il tuo operato. La pressione sociale è sempre forte. Forse svolgere un lavoro orientato ad aiutare gli altri, come l’assistente sociale o l’insegnante, potrebbe calmare un po’ di questa pressione. Anche se devo confessarlo, il mio lavoro è sempre stato anche, in un certo senso, quello di ‘assistente sociale’.
class, and ethics, too. It has been very interesting to make theatre and at the same time to make meaning, to understand current social issues using art, and not the usual pedagogy. The audience was given alternative tools to understand and reflect on the world we live in; however, it has never been our intention to force one vision or the other unto the audience.
Theatre also means entertainment. How does entertainment figure into your work?
Of course. I and everyone else need this, and will for generations. Obviously, any show must be attractive and entertaining, although entertainment doesn’t necessarily mean shallowness or avoidance of important questions. The audience must develop an interest in this form of art, they must feel some attraction. My wish is for the theatre experience to live on for generations.
What will your role be?
I am a playwright first. Even though in this last work, I based by writing on documents and real events, text is my creation alone. In the show we will bring to Venice, I make full use of interviews conducted by sociologists and researchers, but that is only the raw material. My work stands on its own.
How did you work on your play?
I began by analysing the interviews, hundreds of pages to study. I then started writing to give rhythm to the same interviews, which is
what shapes the show overall. I placed actors in an open field, and paired different people to different texts. I also used the work of a choreographer, which means there will be some dance in the final version. This is collective work, also thanks to contributions the actors gave over rehearsal. We took steps forward and steps back. Sometimes, I rewrote full passages. Change large or small took place all the time, and everybody needed to be ready to start over again each time. Actors are agents of change, and change they must accept even up to the last minute. In the end, thirteen actors will be on stage, though over a hundred contributed in some way or other to the final script.
Working at Dramaten is not easy, it is the largest theatre in the country, with many productions. The attention of the media is intense, which means the shows must be of the highest quality.
You worked on Nordic crime, which has become very popular in Italy and all over Europe. We also noticed a certain attention devoted to Dostoevsky…
I worked on a very specific Nordic crime project. This genre surely brought quite some gore on the screen: violence mixed with entertainment right at dinner time. These productions certainly drive a specific narrative on our society. Personally, I tried to add some documentary into it. It is very interesting how the TV industry reproduces stereotypes and narratives on modern societies by portraying its fascination with violence, which certainly exists and is growing. I agree with most commentators: showbusiness contributed greatly to this growth.
I took some inspiration from Dostoevsky for Swedish film and radio, from Crime and Punishment, especially. I was particularly interested in the theme of forgiveness, the absolute value of the human being, and ethics in the context of murder.
Do you think theatre must fight violence?

Theatre is, today, an alternative to the individualistic experience of our micro-platforms: smartphone, tablets, computers… Theatregoing means to come together in a same room and live an experience together with other people. In this sense, theatre drives empathy and humanity. It drives possible mutual understanding. I don’t think the show will be interactive, per se, but the mere fact of sharing a common experience creates a form of dialogue, which is immensely different and certainly more social than spending hour after hour on TikTok, Instagram, or YouTube, alone in one’s room. There’s a difference, and what a difference!
We shall ask of you the essential question of your show: what would you do if you were to live your life a second time?
Quite a dramatic question, because it forces you to think of what you own, of what you built, of what success you had in life. Obviously, I consider myself privileged. I live in a country that allows a high quality of life. Sometimes, though, I think we ought to work more for others than we do for ourselves. I don’t know, it seems to me that there’s something narcissistic in making art. Social pressure is always strong. To get a job that is more oriented to helping others, like social worker or teacher, might do something to ease some of that pressure. However, a playwright is always something of a social worker…
Mi permetto di riportare le origini del teatro di Romeo Castellucci al Convegno di Ivrea del 1967 che segnalò l’esistenza attiva di una sorta di avanguardia nella scena di quegli anni, i cui fermenti erano già presenti, tra gli altri, nei giovanissimi Carmelo Bene, Leo de Berardinis e Perla Peragallo. I concetti alla base di quel ricercare febbrile nuove modalità espressive erano quelli di teatro laboratorio e teatro collettivo. Il teatro come “struttura aperta” e messa in discussione dell’identità linguistica del linguaggio teatrale, dove gesto, parola, suono, spazio devono risultare tutti fattori paritari nell’economia complessiva di uno spettacolo. Per Castellucci basti pensare alla collaborazione con Scott Gibbons e la sua scrittura musicale: il suono diviene entità fisica sul palcoscenico e meglio ancora se non vi è palcoscenico; nei luoghi aperti di rappresentazione le “macchine dei rumori” sono talvolta poste tra il pubblico o all’interno degli edifici, dove anche l’architettura diviene quindi elemento centrale nella scrittura.
In Bros, in tour teatrale in questi giorni, l’alto rumore e i violenti colpi di pistola divengono anch’essi corpo tra i corpi in scena. «Il pubblico deve essere coinvolto emotivamente – dice Castellucci –, ogni opera d’arte è un pungiglione, ogni opera deve commuovere, muovere… deve essere uno strappo esistenziale». Sul tema del teatro collettivo basti qui ricordare l’apertura di un suo spettacolo alla Triennale di Milano: il regista si presenta sul palco all’apertura del sipario, pronuncia poche, lineari parole, «Io mi chiamo Romeo Castellucci», e subito entrano tre cani che lo azzannano violentemente. Della serie la fine di ogni regista nel suo ruolo di dittatore a teatro. Adoro Romeo Castellucci per tre motivi fondamentali. Primo, la sua umiltà: «sono capitato nel teatro senza volerlo… buona parte del mio lavoro è una mia miopia assoluta… sono attirato da tutto ciò che non conosco». Secondo, quando era direttore della Biennale Teatro nel 2005 fece un gesto rivoluzionario: per scegliere gli spettacoli
aprì un vero e proprio bando, rendendo aperto e trasparente tutto il processo di selezione, ovvero rompendo l’umano ma non corretto meccanismo “dell’oggi io ti faccio una cortesia, domani mi aspetto un ritorno”. Ma in tutto questo incessante processo di ridefinizione dei codici anche sistemici del fare e produrre teatro ciò che più conta è la sua predilezione per le compagnie innovative, anche se, o per meglio dire, ancor più se senza potere contrattuale. Terzo, l’attenzione verso il pubblico, come se il rapporto tra visione e azione si invertisse. Scrive infatti: «gli attori devono essere lo specchio scuro dello spettatore», e sue opere come Bros, Il Terzo Reich, o ancora più il ciclo di spettacoli Tragedia Endogonidia, ne sono un chiaro esempio. All’estero la sua Socìetas Raffaello Sanzio è forse la compagnia italiana più conosciuta. «Le Monde» ne parla come una delle più importanti compagnie teatrali nel mondo e così la valuta anche il critico teatrale Franco Perrella nel suo Storia europea del teatro italiano (Carrocci Editore).
A Venezia vedremo Domani, reduce da un grande successo alla Triennale di Milano. La scena è dominata da una figura femminile di altezza fuori dal normale, a piedi nudi, capelli neri fradici d’acqua, sottoveste di lycra rosa pastello. Le pupille sembrano bianche. La donna procede incerta, sostenendo un lungo palo terminante con una scarpa di piccole dimensioni. Di sottofondo rumori tipici della foresta. Così inizia l’opera. Novella Tiresia? Rabdomante in un arido deserto umano? Portatrice di un ‘emblema’ che per natura non spiega e non vuole essere spiegato, ma solo accettato? La grande madre dell’universo? O colei che ci conduce tremando verso un destino ignoto? O, ancora, una reintroduzione del simbolo nella figura della performer, la brasiliana Ana Lucia Barbosa, donna feticcio, oltre due metri di altezza, famosa per saper dare piacere e dolore per avere («I have slaves all over the world»)? Il titolo Domani ci può forse guidare…

Il compositore Scott Gibbons farà il suo meglio per tradurre l’incedere nervoso ed enigmatico della performer in domande dolorosamente e acusticamente inquietanti per lo spettatore. Loris Casadei

Il segreto dei misteri L’imperdibile performance di Castellucci con Ana Lucia Barbosa
The history of Italian avant-garde theatre dates back decades. The research for new modes of expression have often been conducted under the guidelines of theatre-as-workshop and collective theatre, an ‘open structure’ that would question its own linguistic identity –gesture, word, sound, space all must concur to the show.
In Bros, which is touring Italy as we speak, loud noise and gunshots are themselves characters on stage. Says Romeo Castellucci, director, “The audience must be involved emotionally. Every piece of art is a stinger, it must move and touch you. It must tear away at your existence.”

I remember one of his shows in Milan – Castellucci enters stage and states: “My name is Romeo Castellucci”, and right away three dogs attack and maul him. I just love his work. Coming up in Venice is Domani (lit. ‘tomorrow’), applauded at the Milan Triennale. The stage is dominated by a taller than ordinary woman, barefoot, clad in pastel pink lycra, her hair drenched in water. Her pupils look white. She steps forward, shakily, a long pole in her hand. Is she a clairvoyant? a diviner? a standard-bearer? Is she the mother of the universe? Or maybe she will lead us, trembling, onto an unknown fate? Ana Lucia Barbosa, 6’8’’ in height, is both the performer in and inspiration for the show. Does the title, tomorrow, hide the key to understanding it? Composer Scott Gibbons gave his best to translate her enigmatic, nervous stride in painfully, acoustically unnerving questions.
«Le persone passano la vita a spegnere fuochi. Corrono, si affannano a spegnere fuochi. Ma è raro che pensino: do inizio a un fuoco, appicco un incendio, brucio. Si deve bruciare. Bruciare è non sapere che cosa accadrà. Chi spegne un fuoco, sa come le cose finiscono. Un incendio, invece, è imprevedibile, chi accende un fuoco fa una domanda al futuro. Rischio, incertezza e speranza. Le fiamme hanno una propria volontà. Il cambiamento non ha padrone. Chi inizia un incendio può finire bruciato». Con questo prologo si apre Catarina e a beleza de matar fascistas firmato da Tiago Rodrigues, autore, drammaturgo e regista portoghese, dall’autunno 2022 primo direttore artistico non francese del prestigioso Festival di Avignone. Ispirato ad una vicenda storica realmente accaduta, l’imponente spettacolo affronta i temi dell’oggi e i tormenti ideologici di un’intera epoca squarciando il velo del perbenismo con piglio irriverente e provocatorio, a ritmo serrato, senza fare sconti né concessioni. Nel maggio del 1954 a Beleizão, un villaggio nel sud del Portogallo, durante la dittatura di Salazar, Catarina Eufémia, bracciante analfabeta alla guida della rivolta per l’aumento salariale, viene uccisa da un gendarme fascista a soli 26 anni. Rodrigues ne riporta in ‘vita’ lo spirito: la sua Catarina appare in sogno alla nipote e torna a chiedere vendetta. È così che nella famiglia nasce una tradizione: ogni anno si riuniranno nella casa di campagna a Beleizão, e rapiranno e uccideranno un fascista per rendere giustizia all’antenata. Un’esecuzione rituale che si perpetra per oltre settant’anni, fino a quando la nuova Catarina, una giovane di un futuro molto prossimo, compiuti i suoi 26 anni, si sottrae al rito di passaggio. Catarina non se la sente, tentenna, è colta dal dubbio, s’interroga sul senso di usare la violenza contro la violenza. La ragazza prova a capire se un’altra strada sia possibile, apre un dibattito, va contro la tradizione e disobbedisce all’ordine che le è stato dato. Ardita e spregiudicata, l’opera di Rodrigues è un deciso invito a domandarsi instancabilmente il perché delle cose, a pensare con la propria testa invece di adeguarsi alle idee imposte, a costo di sbagliare e a condizione di saperlo riconoscere.
«Sono tanti gli interrogativi: quanto ci si può spingere per proteggere la democrazia? Possiamo infrangerne le regole mentre cerchiamo di difenderla? Chi è un fascista? Domande antiche che continuiamo a farci oggi. Ma lo spettacolo non vuole dare risposte – ha dichiarato il regista in un’intervista – Il mio ruolo di artista è proteggere la libertà di farsi delle domande, anche quelle che pone questa guerra. Mi interessa difendere la libertà di vivere il dubbio, a prescindere dal mio parere personale. Questa è democrazia». ENG The beauty of killing fascists – that’s what the title means, we argue – of a play by Rodrigues, Portuguese author, playwright, and director and also the first non-French director of the prestigious Avignon Festival. Inspired by a real story, the show explores the issues of today and the ideological controversy of a past epoch, tearing open the veil of respectability with provocative irreverence and quick rhythm. Beleizão, southern Portugal, May 1954. Caterina Eufémia, 26, an illiterate day labourer protesting for better pay, is killed by a fascist gendarme. Rodrigues brings Catarina’s spirit back to life: she appears to her niece in a dream, asking for revenge. A family tradition was born: every year, they would meet in the country house in Beleizão, and would kidnap and kill a fascist to avenge their ancestor. The ritual continues for over seventy years, until a younger Catarina turns 26, and won’t participate in it. She just doesn’t feel like doing it, she wavers, she doubts her motives, she questions what it means to fight violence with violence. She wonders if any other way out is possible, goes against tradition, and disobeys.
The theatre piece is wild and daring, an invitation to relentlessly question the reason behind what we do and to think independently. How far should we go to defend democracy? Can we break the rules as we do? Who is a fascist?
Catarina e a beleza de matar fascistas 30 giugno; 1 luglio Teatro Piccolo Arsenale www.labiennale.org
La libertà del dubbio Tiago Rodrigues da Avignone a Venezia
© Filipe Ferreira
Come lascia intuire il titolo il tutto si svolge – o non si svolge – in una piazza: il palcoscenico evoca un’agorà grigia, anonima, evanescente, un non-luogo che può essere – o non essere – ovunque nel mondo. Lo spettacolo inizia con il finale di un’opera durata 365 giorni, mentre sullo sfondo una voce fuori campo racconta che si tratta di una parte di uno spettacolo globale che si svolge in simultanea in 365 città diverse per un anno intero. Siamo testimoni degli ultimi istanti di questa performance collettiva che ci interroga sul senso della cultura e della vita. La lettura dei pensieri che si agitano nella testa di uno degli spettatori di fronte a questa sola immagine è l’unico movimento in scena, il momento spettacolare stesso è ricondotto alla lettura personale.
Il sipario si abbassa e si rialza sulla Plaza popolata da donne velate, madri con passeggini, rider, soldati armati, coppie, turisti, volti inquietantemente anonimi, che si muovono in uno spazio e un tempo i cui limiti sono sfumati da una realtà già liquida e costruita da frammenti di vite rese invisibili quasi per volontaria omissione; una realtà fusa, dissolta dalle numerose soggettività che vi convivono senza toccarsi. Lo spazio pubblico diventa paradigma di un mondo globalizzato e conflittuale, dove la violenza può esplodere da un momento all’altro.
El Conde de Torrefiel, collettivo catalano formato nel 2010 da Pablo Gisbert e Tanya Beylar dopo l’esperienza comune con la compagnia La Veronal di Marcos Morau, mette in crisi il teatro convenzionale puntando ad un rinnovamento della creazione scenica attraverso una pratica che intreccia coreografia, arti plastiche e drammaturgia. La Plaza, narrato in seconda persona singolare, come altri lavori della compagnia sposta il punto di vista: annulla l’io o il noi come rappresentazione collettiva attivando il gioco di percezione di un mondo forzatamente alienato, alienante, immobile, vicino alla morte e al nulla, dove gli altri diventano solo un’immagine superficiale che a malapena si può toccare. Con uno spettacolo applaudito in tutto il mondo, Gisbert e Beylar sfidano il pubblico a guardare in faccia la realtà che lo circonda oltre il teatro, dove la vita accade, senza nascondersi dietro stereotipi, pregiudizi o paure, per riflettere sul nostro ruolo di spettatori, di individui sociali e sulle responsabilità e le libertà che ne derivano. La domanda è semplice quanto essenziale: cosa significa essere vivi? Chiara Sciascia
As one might guess from the title, every happens –or doesn’t – in a Plaza: the stage evokes the memory of a grey, nameless, evanescent agora, a non-place that may (not) be anywhere in the world. The show begins as the finale of a 365-day performance, while on the background, an offscreen voice details how the show takes place simultaneously in 365 cities for a full year. We will witness the last few moments of this collective performance that investigates the meaning of culture and life. The curtains open on a Plaza populated by veiled women, pram-pushing mothers, armed soldiers, couples, tourists – all faces are eerily anonymous, and move about in a time and space whose limits are blurred into a liquid reality. Their lives are invisible due to their own voluntary omissions. Public space becomes the paradigm of a globalized, conflict-ridden world where violence may set off at any moment. El Conde de Torrefiel is a Catalan stage art collective established in 2010 by Pablo Gisbert and Tanya Beylar. The duo works on the renovation of stage art using choreography, plastic art, and drama. La Plaza is narrated in second person to erase the self and activate the perception of a forcibly alienated, alienating, immobile world.
La Plaza 22-23 giugno Arsenale, Tese dei Soppalchi www.labiennale.org




Born in 1979, Nikitin grew up in Basel in a family of Ukrainian, Slovak, French, and Jewish heritage. He is a director, author, and essayist awarded the Swiss Theatre Prize in 2020, and researches the intersection between performance and theatre, fiction and reality, illusion and document, amateurship and virtuosity. In Basel, he created and directed festival
Nato nel 1979 e cresciuto a Basilea, in una famiglia di immigrati che incrocia origini ucrainoslovacco-franco-ebraiche, regista, autore, saggista, Premio Svizzero per il Teatro nel 2020, Boris Nikitin svolge la propria ricerca all’intersezione tra performance e teatro, finzione e realtà, illusione e documentazione, dilettantismo e virtuosismo attoriale, mettendo costantemente in discussione i codici della creazione e fruizione teatrale.
A Basilea ha ideato e diretto il festival It’s The Real Thing – Basler Dokumentartage, dedicato ai più innovativi lavori teatrali e performativi con approccio documentaristico, facendo luce sui vari modi in cui produciamo e rappresentiamo realtà diverse nella politica, nei media, nella scienza, nelle storie o nell’arte. L’opera di Nikitin si fonda sulla sua personale visione della “vulnerabilità”, che reinterpreta non come difetto, ma come abilità straordinaria: il potenziale che trasforma le persone in entità politiche e poetiche, la capacità di manifestarsi, documentarsi, rendersi visibili e vulnerabili alle critiche e agli attacchi, e quindi di intervenire sulla realtà.
I due spettacoli presentati al Festival, Attempt on dying (Sul morire) e Hamlet, sono creazionimanifesto del regista svizzero, che salirà sul palco in prima persona, traducendo appunto in realtà la propria visione. Se Hamlet infatti mette in scena Julia*n Meding, performer e musicista elettronico, nei panni di un ribelle Amleto contemporaneo, che mostra sé stesso, il proprio corpo, la sua biografia in una performance a metà tra teatro musicale punk-queer e documentarismo, Attempt on dying vede protagonista proprio Nikitin e la sua personalissima autobiografia. Il monologo è scarno, la scenografia assente, un’unica sedia, jeans e t-shirt, ma l’attore-autore-regista è ‘nudo’ di fronte alla platea. Senza filtri racconta la storia di suo padre, morto di SLA nel 2016, o meglio degli ultimi mesi della sua vita, quando l’uomo espresse la volontà di ricorrere al suicidio assistito – legale in Svizzera –, una dichiarazione che cambiò tutto: «imparare a vivere imparando a morire. Non è necessario essere per essere finalmente in grado di essere». Infrangere un tabù ha un potere liberatorio, e Nikitin collega il coming-out del padre, con il suo coming-out di 20 anni prima, quando esternò la propria omosessualità in un’intima e radicale riflessione teatrale sul superamento dei limiti della vergogna, sull’importanza di uscire dalla propria comfort zone per mostrarsi ed esistere. Il coming-out è un diritto ma anche un dovere verso il prossimo, strumento indispensabile per entrare in contatto con l’altro e per il necessario superamento di un confine che spesso ci autoimponiamo. C.S.
It’s The Real Thing – Basler Dokumentartage, dedicated to the most innovative theatre with a documentarist approach, shedding some light on the several ways we build and represent different realities: in politics, media, science, history, art. Nikitin’s production is founded on his personal vision of ‘vulnerability’, which he reinterprets not as a flaw, but as an extraordinary ability. Vulnerability is the potential that makes political and poetic entities out of people, it is the ability to manifest, document, be visible and vulnerable to critique and attack, which is the ability to act on reality.
The two shows presented at the Biennale, Attempt on dying and Hamlet, are manifesto creations by the Swiss director, who will be on stage himself, translating his vision into reality. Hamlet stars Julia*n Meding, electronic musician and performer, as a modern-day Hamlet that shows himself, his body, his biography in a performance midway between punkqueer musical theatre and documentary. Attempt on dying stars Nikitin and his life: bare monologue and a very bare set of a single chair. The actor, in jeans and T-shirt, almost stands bare before the audience and tells the story of his father, who died of ALS in 2016 and over the last few months of his life, thought about resorting to assisted suicide, which is legal in Switzerland. Boris Nikitin draws a parallel between the coming out of his father about his intentions, and his own coming out about his sexuality.
Arsenale, Sala d’Armi Hamlet
27, 28 giugno, Arsenale, Teatro alle Tese

Il potere della vulnerabilità
Boris Nikitin porta in scena sé stesso, tra palco e realtà
© Donata Ettlin
Quattro anime unite ma mai sovrapposte danno vita a una performance-installazione immersiva unica nel suo genere, che rende visibili metamorfosi invisibili, andando ben oltre la lezione morale sul clima e svelando il futuro celato nel passato. Nata dalla collaborazione tra la regista, autrice e attrice Maëlle Poésy e l’artista visiva Noémie Goudal, portata in scena dalla performer, acrobata e artista circense Chloé Moglia e accompagnata dalle sonorità elettroniche di Chloé Thévenin, Anima è un esperimento artistico che si ispira alla paleoclimatologia. La disciplina, che studia i cambiamenti del clima nell’antichità, costituisce da anni il centro delle ricerche e delle sperimentazioni di Goudal, interessata a creare nella sua pratica artistica installazioni di tipo illusionistico all’interno di paesaggi naturali che poi documenta tramite video e fotografia. Partendo dalla fascinazione per le lentissime ma cruciali trasformazioni estreme dei paesaggi del Pianeta, le quattro artiste mettono in discussione le nostre esigenze spaziali e temporali, ponendo il pubblico al centro di un trittico ‘vivente’ in cui va in scena perpetuamente lo spettacolo di distruzione e ricostruzione della Natura. Quale vertigine ci coglie quando scompare la linea dell’orizzonte, o addirittura la rugosità del terreno? Che disagio ci provoca non saper più distinguere il giorno dalla notte? Mentre la forza degli elementi naturali si scatena minando la presunta eternità di luoghi e habitat conosciuti e la musica di Chloé Thévenin si fa sempre più ammaliante, fondendo in strati ovattati i suoni dell’acqua e della giungla con sonorità techno, Chloé Moglia attraversa la geografia di Anima, sospesa nel vuoto, appesa alla struttura metallica forte e decisa, ma allo stesso tempo fragile e impermanente di fronte all’incommensurabile tempo geologico. «Il tempo della razza umana non è che un mero minuto a confronto del tempo del Pianeta – scrive Noémie Goudal – Durante la nostra vita sulla Terra, non riusciamo effettivamente a percepirne i movimenti; abbiamo una relazione di stabilità con il Pianeta, simbolizzata da limiti chiari e confini prestabiliti. Anima è un tentativo di cambiare la nostra prospettiva e percepire il mondo così com’è intrinsecamente, per definizione, in perpetuo movimento». C.S.

Four anime (‘souls’) united, though never overlaid, bring to life a new immersive installation/performance that is one of a kind. It makes invisible metamorphoses visible, and goes beyond the moral lecture on climate while revealing the future that absconds in the past. Born of a collaboration between director, author, and actress Maëlle Poésy and visual artist Noémie Goudal, staged by performer, acrobat, and circus artist Chloé Moglia with sound by Chloé Thévenin, Anima is an art experiment that took inspiration from palaeoclimatology. The study of climate in ancient eras has been for years the focus of Goudal’s research and experimentation, who is created illusionistic installations within natural landscapes documented in video and photography. Fascinated by the extremely slow, yet crucial transformation of landscape all around the planet, the four artists question our special and temporal needs by putting the audience at the centre of a living triptych that shows the destruction and reconstruction of Nature. How does vertigo get to us when the horizon fades out, or the ground itself seem to disappear? How uneasy will we feel when we’ll be no longer able to tell day from night?
Anima 23, 24 giugno Parco Albanese-Mestre www.labiennale.org
Il latte, immacolato simbolo di vita, speranza e sopravvivenza, diventa metafora di morte, violenza e perdita in Milk, potente opera di teatro-danza del regista palestinese Bashar Murkus, fondatore e direttore artistico del Khashabi Theatre di Haifa in Israele.
Tragedia contemporanea che mette al centro la figura della donna e della madre, Milk si interroga sul tema del lutto e sul suo significato umano più profondo. «Immagino che perdere un figlio a Gaza o a Parigi non sia molto diverso in termini di dolore per una madre – scrive Murkus –, il mio obiettivo non era quantificare né fare paragoni. Quello che mi importava era capire come affrontiamo la perdita. In questi due anni di ricerca con il mio team, abbiamo affrontato il soggetto in molti modi diversi al fine di creare prospettive differenti. Così ci siamo trovati ad allargare il soggetto, a investirlo di significati più profondi, più generali. Oggi questo progetto ha più a che fare con l’idea di disastro, di catastrofe. Non si tratta di cause o categorie, e nemmeno di conseguenze, ma piuttosto del modo in cui questi eventi distruggono la nostra percezione del tempo, della vita. La dividono in due. Sono forze molto specifiche che dividono il tempo in un prima e un dopo che non possono mai essere riconciliati.
Quello che guardo è lo spazio tra questo prima e questo dopo. Uno spazio che trasforma il tempo in qualcosa che non ha durata, non ha fine. Ho cercato di capire come e in che misura questo spostamento ci trasforma, ci scuote».
La scenografia è essenziale. Il pavimento nero, ricoperto di spugne che assorbono la luce e smorzano i rumori. Entrano in scena corpi di carne e ossa, donne che stanno piangendo. Le loro lacrime bianche sono lacrime di latte, lo stesso latte che avrebbero dato ai figli se non li avessero perduti. Poi altri corpi ancora, quelli dei manichini medici ammucchiati sul palco. La morte e la vita sono ovunque. Il disastro che colpisce i corpi delle donne è visibile, palpabile, spaventoso. Sono donne che, per sopravvivere, trasformano ciò che le circonda e le tocca in un paesaggio di incandescente bellezza. Possiedono l’arcaico potere di trasformare l’indicibile. Dal nero al bianco l’opera si trasforma in pura poesia visiva grazie ad un mare di latte che invade tutto, prendendo quasi vita. Milk non racconta una sola storia, ma una pluralità di storie che hanno in comune l’impossibilità di finire. Sono lotte perpetue, inferni sulla terra. Come avviene il disastro? Avviene in un istante, e non ha mai fine. Presentato ad Haifa nel 2016, poi al Festival di Avignone e applaudito in altri importanti festival europei, Milk è una delle oltre 20 produzioni del prolifico Bashar Murkus, regista militante che a soli 30 anni ha saputo catturare l’attenzione internazionale fornendo un intenso sguardo teatrale sulla cultura palestinese contemporanea attraverso le sue profonde visioni artistiche, politiche, sociali e umanistiche, con una formidabile capacità di dispiegare queste stesse visioni in un linguaggio poetico e universale tanto visivo e potente quanto sensuale.
Appartenente alla terza generazione di palestinesi che dal 1948 vive nel nuovo Stato di Israele, Murkus, condottiero ispiratore, rivendica il diritto di preservare la cultura e l’arte palestinesi nei territori occupati. Con la fondazione del Khashabi Theatre nel 2015 ha dato vita insieme ad altri artisti indipendenti ad uno spazio creativo libero, autogestito e autofinanziato in cui tabù sociali, artistici e censure politiche possono essere sfidati e abbattuti. Chiara Sciascia
Milk is the immaculate visualization of life, hope, and survival, but in Milk, it is the metaphor of death, violence, and loss. A powerful dance/theatre piece by Palestinian director Bashar Murkus, founder and art director of the Khashabi Theatre in Haifa, Israel. The show is the modern tragedy of a woman, a mother, that questions grief. Says Murkus: “I assume that losing a child in Gaza or in Paris isn’t that different in terms of pain for a mother. Comparing or quantifying are not my goals. What matters is to understand how we process loss.” The stage supports a minimal set: a black padded floor absorbs lights and muffles sounds. Enter mourning women: their white tears are milk, the same milk they’d nurse their children with, hadn’t they lost them. Enter medical mannequins. Death and life are all about the set. Women will show the ancient power to transform the unspeakable. From black to white, it all turns into pure visual poetry thanks to the pervasive presence of living milk.
Milk 24, 25 giugno Arsenale, Teatro alle Tese www.labiennale.org

Un mare di bianche lacrime Da Haifa la potente opera del regista palestinese Bashar Murkus© Khulood Basel
Specializzata in studi umanistici e scienze sociali, laurea magistrale in Regia teatrale all’Accademia di Zagabria, Morana Novosel (1987) si dedica dal principio al teatro collettivo e ai processi di creazione collaborativi, oltre che al teatro contemporaneo drammatico e post-drammatico. Artista come molti altri impossibilitata a sottrarsi al suo tempo, la regista croata vince il bando Performance Site-specific 2023 con Fluid Horizons, creazione che ispirandosi al pessimismo ambientale del Dark Mountain Manifesto di Paul Kingsnorth e Dougald Hine si chiede come sarebbe l’arte se accettassimo di non poter più sovvertire i danni dell’impatto dell’umanità sul Pianeta. «Voci riprodotte, fonti sonore, stralci di appunti, tasti da premere sul telefono: suggestioni, frammenti di timone per tentare di rimettere insieme le tessere di un puzzle che non combaciano mai. Guerre, pandemie, ignavia, e disinteresse codardo al di fuori dei propri perimetri, ci hanno reso spettatori attenti a una forma imposta; Morana Novosel ci schiaffeggia con il suo dispositivo scenico costringendoci all’azione», si legge nelle parole dei direttori ricci/forte. Fluid Horizons si serve di «Venezia per piangere la perdita di umanità; cambiamenti climatici, innalzamenti delle maree, gas serra e riscaldamento globale trascinano questa umanità serenissima nella propria sordità verso un rinnovato concetto di Atlantide. Forse l’accampamento di congegni di comunicazione della Novosel assurge a una landa di tesori sommersi, a raccontarci cosa eravamo diventati, a testimonianza del futuro dell’uomo: la fine della civiltà non è la fine del mondo; la perdita del nostro habitat di comunicazione ci ha resi molluschi diffidenti [...] Morana Novosel ci restituisce le capacità residue da rimettere in gioco per una rivoluzione umana».
ENG Morana Novosel (b. 1987) works on collective theatre and collaborative creative processes as well as on modern drama. Novosel won the Site-specific Performance award in 2023 with Fluid Horizons, a creation inspired by the environmental pessimism found in Paul Kingsnorth’s and Dougald Hine’s Dark Mountain Manifesto. In the words of ricci/forte: “Recorded voice, sound sources, notes, telephone keys: suggestions and fragments that help us to piece together a puzzle that never seems to be completed.”

Originario di Adrano in Sicilia, classe 1998, artista multidisciplinare, regista e performer, Gaetano Palermo, dopo la laurea in Filosofia presso l’Università di Bologna, si specializza in Teatro e Arti performative allo IUAV di Venezia e in Arti visive all’Accademia di Belle Arti di Kassel. Vince la terza edizione del bando Biennale College Teatro – Performance Site-specific 2023 con Swan, una creazione che prende le mosse da La morte del cigno di Michel Fokine astraendolo dalla sua dimensione puramente teatrale e coreografica per trasporlo su un piano quotidiano riferito all’adolescenza femminile. Incarnata dalla giovane performer e artista Rita di Leo, la pattinatrice in tutù protagonista di Swan è ritratta durante un momento intimo di svago e trasporto personale quando si trova a vivere una sorta di surrealtà determinata dal contesto circostante.

«Gaetano Palermo – scrivono ricci/forte nella motivazione della selezione – mette in evidenza il lato oscuro dell’individuo attraverso la paura dell’altro che non conosciamo e la sua solitudine, disgiungendo lo sguardo dello spettatore nel duplice ruolo di co-protagonista e di voyeur. Conducendolo altrove, in mondi onirici di desideri e di angosce, scatena in lui un’identificazione [...] permettendoci così d’intravedere in controluce la sindone di un intero Pianeta, in rotazione sul perno del Sé come un derviscio ebbro, ostentando una furia ribollente e una brutalità paralizzante in tutte le sue forme politicoideologiche, sociali, religiose, sessuali, economiche, ambientali, sempre più stratificate come sedimenti rocciosi inscalfibili».
ENG Born in Sicily in 1998, Gaetano Palermo is a multi-disciplinary artist who studied in Bologna, Venice, and Kassel, Germany. Palermo won the third edition of the Biennale College Theatre with Swan, a creation inspired by Michel Fokine’s The Dying Swan The concept is abstracted from its purely theatrical dimension and transposed on the plane of female adolescence. Skater, performer, and artist Rita di Leo is portrayed in a moment of recreation as she lives in a sort of surrealness determined by circumstance.
Già invitato alla Biennale Teatro 2020 con George II, presentato con la regia di Alessandro Businaro nell’ambito del 48. Festival diretto da Antonio Latella, Stefano Fortin è il vincitore del bando Autori under 40 del College 2022, e porta in scena quest’anno Cenere in forma di mise en lecture, diretto dalla regista Giorgina P. «Dotato di un originale segno impressionista, viscerale e urgente, in una contemporaneità che si dissolve in un batter di ciglia, logorata dall’ansia dell’apparire», Stefano Fortin è stato selezionato dai Direttori Stefano Ricci e Gianni Forte «per la sottile trasognata poeticità e la raffinatezza caustica nel germinare un Presente apparentemente realistico, ironico e terribile allo stesso tempo, in risonanza con le inquietudini dell’Oggi, convocando la momentanea dilatazione visionaria di una temporalità razionale, sfaldandola di qualsivoglia velleitaria certezza, lasciando deflagrare una panoplia di desideri arditi e/o sentimenti reconditi come la rabbia che, scorrendo magmaticamente sottopelle, finiscono per venire alla luce ed eruttare lapilli incandescenti e corrosivi pulviscoli rossi di cenere che, disorientandoci prima, ci avviluppano poi in un turbamento irreversibile». Facendo della parola un “residuo di rabbia bruciata” Fortin porta in scena tre storie diverse in cui la rabbia, forza creativa e distruttiva, ricopre tutto come un manto di cenere
ENG Already a guest at the 2020 Venice Theatre Biennale with George II, Stefano Fortin is the winner of the 2022 Biennale College competition, Authors section. His play, Cenere (lit. ‘ash’), is a mise-en-lecture directed by Giorgina


P. Biennale directors Stefano Ricci and Gianni Forte praised Fortin for his “original impressionist style, visceral and urgent, that resolves in a blink [and] his subtle, dreamlike poetry, his corrosive refinement in the germination of an apparently realistic present, at once ironic and terrifying, resonating with the disquiet of today and summoning the momentary visionary dilation of rational temporality.” Fortin’s three stories see rage, a creative and destructive force, covers all that is visible like a drizzle of ashes.
Una festa finita, una radura nel bosco, una maledizione ignota che colpisce l’umanità intera, riducendola al sonno. È come se ogni essere umano si fosse ferito con un ‘fuso’, qualcosa che non avrebbe dovuto toccare, e ora le mani sporche di rosso lo isolano da resto del mondo, non gli resta che cadere addormentato, solo, nessuno può avvicinarsi a lui, pena la condivisione del medesimo destino. Carolina Balucani attrice e autrice diplomata al CUT di Perugia già in scena con maestri del calibro di Latella, Placido e Baracco, si aggiudica il Bando Autori under 40, e presenta la mise en lecture di Addormentate, con la regia di Fabrizio Arcuri. Un testo che s’ispira all’antica fiaba, preannunciando fin dal titolo «una letargia, una percezione alterata – scrivono ricci/forte nella motivazione –, uno stato onirico entro il quale l’Ignoto rende concreto un bisogno inappellabile: entrare in contatto con qualcuno, essere bucati dall’Altro da noi e in questo sconfinamento ritrovarci rinnovati». Un viaggio al termine della notte che ci porta a chiederci insieme ai Direttori «come siamo arrivati a travestirci tutti da Belle Addormentate e quale tipo di azzurro, principe o meno, attendiamo per ritornare desti? Forse facendo nostra la pena degli altri, individuando l’oltraggio recato a terzi come una lesione indissolubilmente aperta sulla nostra pelle?».
ENG The party’s over, a clearing in the wood, a mysterious spell is cast on humankind, forcing all into deep slumber. It’s like every person pricked their fingers on the twirling spindle, something we shouldn’t have touched. Now, our red-stained hands isolate us from the rest of the world, and nobody can draw close, lest they fall victim to the same destiny.
Carolina Balucani is an actress and author. She won the Biennale College competition, Authors section, with a mise-en-lecture of Addormentate (lit. ‘sleeping’), a piece inspired by the ancient fairy tale and a journey to the end of the night that made ricci/forte wonder: “How did we end up all dressed like Sleeping Beauties, and what Prince Charming are we waiting for to wake us up?”
Addormentate 28, 29 giugno Arsenale, Sala d’Armi www.labiennale.org

Classe 1988, cresciuta a Roma e di stanza a Milano, Tolja Djokovic si dedica al teatro da subito dopo il liceo come attrice e performer, intraprendendo un percorso con la compagnia Fanny&Alexander, dove trova terreno fertile per coltivare la propria passione per la scrittura dando un taglio autoriale al proprio lavoro. Si laurea con una tesi sperimentale sulla Lettura ad alta voce del testo poetico e termina la propria formazione al corso internazionale per dramaturg di Ert. Nel 2021 vince il bando College Teatro Autori under 40 della Biennale con il testo En abyme e, dopo averlo presentato al Festival 2022 come mise en lecture, torna quest’anno per la messa in scena completa dello spettacolo ad opera di Fabiana Iacozzilli. En abyme è un dispositivo drammaturgico raffinato e complesso, in cui la prosa lucida e decisa del documentario si alterna a ecfrasi minuziose, per lasciare infine spazio alla poesia. Tra drammaturgia e sceneggiatura cinematografica, En abyme parte dalla fascinazione dell’autrice per l’abisso geografico, esistente, della Fossa delle Marianne che il regista James Cameron nel 2012 esplorò raggiungendo profondità mai toccate prima, per portare in superficie gli abissi nascosti nelle pieghe della nostra vita. Per Djokovic la discesa negli abissi è «una situazione esemplificativa di stati d’animo diversi, da un lato la paura di andare a fondo, dall’altro l’introduzione delle scoperte che può fare solo chi è pronto a correre il rischio di perdersi […]. Mi hanno sempre interessato i limiti che pone la pratica scenica e ho avvertito l’esigenza di comprendere e sperimentare sino a che punto ci si può spingere con l’immaginazione, nella sfida a superarli».

ENG Actress and performers Tolja Djokovic honed her skills as an author to give a touch of autership to her work. She graduated with a dissertation on poetry reading, and won the Biennale College competition in 2021, Authors section, with En abyme. The piece is a refined, complex prose whose ekphrases soon leave room for poetry. Descending into the abyss is “an example of different moods: on one side, the fear of sinking; on the other, the discovery that is only the purview of those who accept the risk of getting lost.”
Drammaturgo, regista e artista cesenate che definisce la propria ricerca “un osservatorio sul vuoto”, su ciò che rimane del mondo contemporaneo dopo il collasso dell’identità, Giacomo Garaffoni ha iniziato il proprio percorso con Teatro Valdoca, Societas Raffaello Sanzio, Romeo Castellucci e Silvia Costa, partecipando ai più importanti festival del settore. Nel 2020 ha fondato Indocile Collettivo, insieme a Michele Ambroni e Sofia Rossi, che debutta con Cassandra – il diritto di parlare, spettacolo-mostra di indagine sulla psichiatria femminile violenta di inizio ‘900. Dopo aver vinto il bando Autori under 40 nel 2021, Garaffoni ha presentato lo scorso anno a Venezia la mise en espace di Veronica, che quest’anno entra a far parte del programma del Festival, prodotto da La Biennale e diretto da Federica Rossellini, attrice e regista del Piccolo di Milano già vincitrice di due premi UBU.
Veronica è «una tragedia di impianto classico scritta intorno a una tragedia di ogni giorno» afferma Garaffoni, che con questo lavoro torna a concentrarsi sull’universo femminile attraverso la storia di un gruppo di amiche, dette Le Mogli, colpite dalla morte improvvisa di una di loro. Veronica è un fantasma onnipresente durante tutta l’opera, una macchia blu su un divano che si allarga sempre più in un’assenza/presenza che tutto pervade. «L’eco di un corpo che è stato materia concreta della mancanza. Eppure, quella macchia non è fissata – si legge nelle note del regista –, è un pigmento blu puro e il tentativo di pulirla non farà altro che tingere gradualmente tutta la scena e i corpi di tutte le donne».
ENG Playwright Giacomo Garaffoni calls his work an ‘outlook on the void’, or what remains in the modern world after identities collapsed. In 2020, Garaffoni founded Indocile Collettivo, which debuted with Cassandra – il diritto di parlare, a show/exhibition on women’s psychiatric care in the early 1900s. The winner of the Authors section at the 2021 Theatre Biennale College, last year Garaffoni presented classical drama Veronica, which will be part of the main programme of the Biennale this year.
«Attraverso l’utilizzo di una disfonia sonora, di un’interazione di codici espressivi differenti, di una parola da reinventare fatta di frammenti intrecciati, Valerio Leoni fornisce ganci liturgici offrendoci – attraverso la lezione di quel teatro povero che restituisce la dignità del ruolo di officiante – l’opportunità di perdere il consueto orientamento spaziale e temporale abbandonando la cristallizzata consapevolezza di sé…» si legge nella motivazione data dai direttori ricci/forte nell’assegnare il bando Registi under 35 del biennio 2022/23 al frusinate Leoni. Regista, attore e drammaturgo, fondatore della compagnia Agiteatro, direttore artistico e fondatore insieme a Sofia Guidi del centro culturale romano Labirion Officine Trasversali, Valerio Leoni presenta il suo Cuspidi, lavoro germinato proprio a Labirion. In scena tre personaggi/emozioni: A fatto di Urla (Sofia Guidi), B fatto di Polvere (Sara Giannelli), C fatto di Scatole (Jacopo Provenzano). Tre «sciamani esploratori, legati dallo stesso sentimento di perdita di senso e d’impotenza – si continua a leggere nella motivazione – che cercano rifugio in una platonica Caverna per ritrovare un contatto fisico troppo a lungo interdetto o dimenticato, recuperare una conversazione interrotta e instaurare un nuovo dialogo con l’altro, evitando così di essere inghiottiti dal buio che un futuro apocalittico proietta davanti ai loro occhi». ENG Director, actor, and playwright Valerio Leoni presents Cuspidi (lit. ‘pinnacles’). On stage are three characters/feelings, A is Scream (played by Sofia Guidi), B is Dust (played by Sara Giannelli), C is Boxes (played by Jacopo Provenzano). Three “shamans and explorers, bound by the same feeling of senselessness and impotence – in the words of ricci/forte – that look for Plato’s Cave to find a physical contact that has been denied or forlorn for too long. They want to resume a conversation once interrupted, and established a dialogue with the other, lest they get swallowed into dark, apocalyptic future.”
Navetta gratuita/ Free Shuttle Boat Da/ from Arsenale
a/ to S. Elena – S. Zaccaria – Zattere – Tronchetto – P.le Roma al termine degli spettacoli serali/ after the evening shows È disponibile un servizio di snack bar/ Snack bar service available (Arsenale)

Bus navetta gratuito/ Free shuttle boat
Da/ from Tronchetto e da/and from Mestre a/ to Sala Marghera –Zona Industriale (Via dell’Idrogeno 7) e da/ and from Sala Marghera – Zona Industriale a Tronchetto e Mestre per gli spettacoli di FC BERGMAN del 17 e 18 giugno 2023 for the FC BERGMAN shows of 17 and 18 June 2023
Prevendita biglietti online/ Tickets can be purchased online
Per informazioni su prezzi, modalità di ingresso alle cerimonie, mise en lecture, spettacoli college e site-specific consultare il sito/for information on ticket prices, how to enter the ceremonies, mise en lecture, college and site-specific performances please consult the website
www.labiennale.org



L’improvvisazione è un muscolo che nel repertorio classico si è atrofizzato.
La musica però se ne infischia, non si controlla, non rimane identica: ci saranno sempre nuovi artisti, nuovi stili, nuovi modi di suonare Uri Caine

Direttore artistico della Biennale Musica giusto vent’anni fa, in quella che fu la 47. edizione, Uri Caine è ricordato come un traghettatore verso le sponde più sperimentali che avrebbero poi caratterizzato le successive edizioni, una guida capace di trasportare la Biennale Musica nelle curve più aspre e rischiose e assieme suggestive della musica contemporanea. La relazione tra composizione e improvvisazione si trovava al centro del progetto programmatico di quella Biennale e dell’indagine espressiva di Caine, tratto che possiamo riscontrare ancora oggi come radicale nel percorso artistico del pianista originario di Philadelphia, iniziato allo studio dello strumento da Bernard Peiffer e alla composizione con George Rochberg. In quel 2003 l’esposizione dell’attualità newyorkese aveva lasciato spazio ai grandi maestri di Chicago, alcuni fondatori dell’AACM (Association for Advancement of Creative Musicians), comunque trasferitasi a New York all’inizio degli anni ‘70. La loro presenza aveva ricordato a molti da dove provenissero le brillanti intuizioni sonore di molta ricerca contemporanea; pur se oscurati da nuovi movimenti metropolitani, artisti come Roscoe Mitchell, Muhal Abrams, Henry Threadgill mantengono adesso un carisma luminoso, diffondono una scienza sonora ancora ricca di indicazioni, specie sul metodo specifico che la Biennale Musica dell’epoca voleva divulgare. A Venezia, Uri Caine è rimasto indissolubilmente legato, come testimoniano i tanti concerti tenuti in laguna in questi vent’anni, occasioni in cui l’artista ha regalato al pubblico momenti di improvvisazione pura e cristallina, supportati da un talento schietto e verace, da una curiosità davvero insaziabile. Il 10 giugno allo Squero dell’Isola di San Giorgio lo troviamo protagonista di un concerto che oscilla tra classica, jazz e improvvisazione, in cui la musica si offre come un unicum senza fratture né frontiere, uno spettacolo nel quale dialogano Beethoven e Thelonious Monk, il Tin Pan Alley (nome dato all’industria discografica newyorkese tra ‘800 e ‘900) e Gustav Mahler, Richard Wagner e George Gershwin, lo swing e Giuseppe Verdi, passando per Bach e i Beatles. Change! è il titolo del concerto, del brano e dell’album che Uri Caine scrisse per celebrare Octavius Catto, attivista impegnato nella lotta per i diritti civili e fautore dell’integrazione della popolazione nera nell’America post-guerra civile: una canzone che Caine ha composto nel 2014 e chiamata all’epoca The Passion Of Octavius Catto, per orchestra, coro gospel, solista gospel e piano trio. Un brano che possiede una fortissima vocazione civile, scritto per commemorare la vita dell’attivista, che venne assassinato il giorno delle elezioni, nel 1872, proprio nel tentativo di votare.
Canzoni che non sono ‘semplicemente’ canzoni, quindi, ma atti intimi che diventano aperti al pubblico grazie ad un’improvvisazione capace davvero di parlare a tutti, di ‘farsi capire’.
Dopo essersi trasferito a New York nel 1985, Caine ha inciso 36 album come leader, con lavori recenti che includono Space Kiss con il Lutoslawski Quartet, Calibrated Thickness e Catbird con il suo trio di pianoforte e Callithump per piano solo.
Ha registrato progetti con il suo ensemble eseguendo arrangiamenti di Mahler, Wagner, Mozart, Verdi, Schumann e Bach. Ha inoltre diretto un trio acustico con il quale ha realizzato diverse registrazioni tra cui Live at the Village Vanguard e con il suo trio elettrico Bedrock. Le composizioni più recenti includono Agent Orange, su commissione dell’Orchestra Filarmonica di Bruxelles e 4 Wunderhorn Songs, scritta per l’Orchestra da Camera di Basilea.
Ha ricevuto l’incarico di compositore in residenza per la Los Angeles Chamber Orchestra per tre anni e ha eseguito la sua versione delle Variazioni Diabelli con la Cleveland Orchestra, la Swedish Chamber Orchestra, la Moscow Chamber Orchestra, l’Orchestra del Teatro Comunale di Bologna, l’Orchestra Verdi e l’Orchestra Toscanini.
Il 10 giugno a San Giorgio un concerto che è molto più di un concerto, un incontro con un musicista che è molto più di un musicista.
Uri Caine had been art director at the Music Biennale exactly twenty years ago, in what was the festival’s forty-seventh edition. We know him as the one who ferried the Biennale onto the land of experimentation, a feature that we came to associate with the Biennale since. The relationship between composition and improvisation is at the centre of the programme both at Biennale and for Caine himself, something we can see today as deeply routed in the Philadelphia-born pianist’s career, who studied piano with Bernard Peiffer and composition with George Rochberg. Caine certainly enjoys a privileged relationship with Venice, as proved by the many shows he held in town over twenty years. Pure, crystal-clear improvisation supported by fresh, real talent and insatiable curiosity. On June 10, at San Giorgio Island, he will perform in a show of classical, jazz, and improv: music will pour out with no fractures nor borders, a continuous conversation between Beethoven, Thelonious Monk, Gustav Mahler, Richard Wagner, George Gershwin, swing, Giuseppe Verdi, the Beatles. Change! Is the name of the show, the song, and the album that Uri Caine wrote to celebrate American civil right activist Octavius Catto (1839—1871). The song for orchestra, gospel choir, solo, and piano was known in 2014 as The Passion of Octavius Catto commemorates Catto, who was killed on election day, 1872, on his way to the poll. Uri Caine moved to New York in 1985 and recorded 36 albums as lead artist. His latest works include Space Kiss with Lutoslawski Quartet, Calibrated Thickness and Catbird with his piano trio, and Callithump for piano solo. He also recorded, together with his ensemble, arrangements of Mahler, Wagner, Mozart, Verdi, Schumann, and Bach. More recent compositions are Agent Orange, a commissioned work for the Brussels Philharmonic Orchestra, and 4 Wunderhorn Songs, written for the Basel Chamber Orchestra, among others. The musician has also been offered a three-year residency at the Los Angeles Chamber Orchestra and produced his version of the Variazioni Diabelli with the Cleveland Orchestra, the Swedish Chamber Orchestra, the Moscow Chamber Orchestra, the Bologna Theatre Orchestra, the Verdi Orchestra, and the Toscanini Orchestra. We are looking forward to a June 10 concert that will be much more than a concert, with a musician who is so much more than a musician.

«Marco se n’è andato e non ritorna più/ e il treno delle sette e trenta senza lui/ È un cuore di metallo senza l’anima/ Nel freddo del mattino grigio di città…». Sicuramente l’avete letta cantando… Sono passati trent’anni da allora, e chissà se e quanto quel Marco se ne sarà pentito. Ma certamente non ha rimpianti Laura, che per l’appunto trent’anni fa, il 27 febbraio del 1993, caschetto nero lungo alle spalle, giacca scura dal taglio maschile, giovanissima, 18 anni appena, faccia pulita acqua e sapone, trionfa con La solitudine a Sanremo, sezione Nuove Proposte : un brano destinato a diventare un classico, oltre che dolce e consolatoria colonna sonora di molti, moltissimi cuori infranti. Una vittoria che rappresenta l’inizio di un sogno per la giovane Laura, che ha iniziato a cantare con il papà Fabrizio nei pianobar già a 13 anni e ora si vede spalancate le porte del successo. Da quel momento la cantante di Solarolo non si ferma più, piedi ben piantati in terra, e tanta voglia di lavorare, imparare e farsi conoscere, l’hanno portata ad inanellare un successo dopo l’altro, in patria e all’estero, dove diventa l’artista italiana più ascoltata. Canta in italiano, portoghese, inglese, francese, spagnolo, conquista l’Europa, gli States ma soprattutto l’America Latina, i suoi brani registrano vendite e successo strepitosi. Colleziona tour mondiali, importanti premi, collaborazioni con star internazionali del calibro di Madonna, Phil Collins, Michael Jackson, Kylie Minogue, Miguel Bosé, Gloria Estefan, Michael Bublé, Ray Charles, Juan Gabriel, James Blunt e finisce pure per essere invitata a cantare alle nozze di Barbara Streisand, per dirne qualcuna. Nel 2006 è la prima italiana a ricevere un Grammy Award nella categoria Miglior Album Pop Latino dell’anno con Escucha atento (in Italia l’amatissimo Resta in ascolto ).
Nel 2007 altro record: Laura è la prima – orgogliosissima – artista donna a salire sul palco di un San Siro che la acclama a gran voce e, sotto una pioggia battente, regala ai suoi fan un concerto che entra nella storia. Nel 2021 ottiene addirittura una candidatura all’Oscar per Io sì, colonna sonora del film La vita davanti a sé, con Sophia Loren.
Una donna da guinness Laura, e lo ha dimostrato pochi mesi fa di nuovo, quando per celebrare questo importante anniversario, nella notte tra il 26 e il 27 febbraio scorso, ha tenuto in 24 ore tre concerti uno dopo l’altro, partendo da New York, passando per Madrid per giungere a Milano con il gran finale, una vera e propria sorpresa per tutti i suoi fan. E i festeggiamenti per i 30 anni di carriera proseguono con un altro concerto destinato a entrare nella storia: l’anteprima del suo World Tour, che vedrà per la prima volta la Pausini salire su un palco in Piazza San Marco, con la città di Venezia a farle da incomparabile quinta.
«In questi 30 anni, credo di aver fatto quasi mille concerti – racconta Laura – e il live è il motivo principale per cui amo questo mestiere. Lo chiamo così con fierezza, perché la musica è una cosa seria. Parte da una passione e quando si ha la fortuna e il talento per farlo diventare il tuo lavoro, ci vogliono molto studio, disciplina, costanza, volontà e sacrificio. Ne vale la pena. Ho imparato questo mestiere sul campo, viaggiando da subito, studiando per cantare in cinque lingue, senza mai darmi per vinta ma comunque facendo molte rinunce. Ne sono sempre orgogliosa! Perché cantare in mezzo mondo in italiano, canzoni scritte da italiani, con spettacoli disegnati da italiani, è un brivido, ogni volta…».
E sarà un brivido incancellabile sicuramente anche questa volta, tanti auguri Laura! Noi siamo già in ascolto… Gioia Nigro
Laura Pausini is a record-smashing artist. She recently celebrated her thirty years in the music industry with three concerts in a twenty-four-hour span: New York, Madrid, and Milan. Celebrations didn’t end there, either: her world tour is due to start soon, and there will be no better way to start that off with a magical concert in Piazza San Marco, a first for Pausini. Three dates to enjoy a great night out with her music and the city of Venice as beautiful, romantic backdrop: June 30, July 1 and 2.
In 2022, Carl Orff’s Carmina Burana, in a performance by the Fenice Theatre Orchestra conducted by Fabui Luisi, marked the return of great classical music in Piazza San Marco thanks to a momentous, memorable concert which was all the more meaningful after the forced stop due to the pandemic. Exactly one year later, the Fenice Orchestra will perform again in the Piazza, this time conducted by Juraj Valcˇuha. The concert’s programme lists another cornerstone of timeless music: Beethoven’s ninth symphony. Paolo Conte recently have a historic concert at Milan’s Scala Theatre. The sold-out event consecrated him as the only singer-songwriter who ever performed at Scala, one of the most famous opera theatres in the world. Conte will be in Venice on July 9, some fourteen years after the July 13, 2009 concert he performed in together with the Venice Symphony Orchestra. The upcoming concert will also take place in Piazza San Marco, and will be based on the one the artist gave at Scala, though with five different songs.
One of the most important international singer-songwriters of our time, Damien Rice, will be at Fenice on July 11 as part of Veneto Jazz’s programme of independent performers AAVV, in cooperation with Vigna PR, Concerto Music, and Live Nation. After three records – O, 9, and My Favourite Faded Fantasy – Rice will tour the world with his work, which stands out for its unconventional style and improvisational attitude.

L’anno scorso i Carmina Burana di Carl Orff, con l’Orchestra del Teatro La Fenice diretta da Fabio Luisi, hanno sancito il ritorno della grande musica classica in Piazza San Marco, consegnando alla storia un concerto epocale e memorabile reso ancora più significativo dal riposo forzato che eventi di questa portata avevano dovuto vivere durante la terribile emergenza sanitaria mondiale. A un anno esatto di distanza la Fenice replica l’appuntamento estivo con un autentico happening, stavolta dedicato ad un’altra pietra miliare della musica di ogni tempo, di sicuro nel novero delle più famose sinfonie di ogni tempo: la Nona di Ludwig van Beethoven, diretta da Juraj Valcˇuha. Note famose in tutto il mondo che risuonano in una delle Piazze più celebri e immediatamente riconoscibili, un grande evento di musica classica in un luogo che nell’estate 2023 vedrà pezzi da 90 del panorama musicale italiano come Laura Pausini e Paolo Conte protagonisti assoluti.
Sinfonia n. 9
8 luglio Piazza San Marco | www.teatrolafenice.it
Dopo l’epocale live alla Scala di Milano, che ha registrato il tutto esaurito e lo ha consacrato come unico cantautore mai esibitosi su quel palcoscenico, Paolo Conte torna live il 9 luglio in Piazza San Marco, uno dei luoghi più iconici al mondo, a distanza di 14 anni dal concerto del 31 luglio 2009 insieme all’Orchestra Sinfonica di Venezia. Durante l’evento l’icona indiscussa della musica cantautorale non solo italiana, ma anche internazionale, regalerà al pubblico uno spettacolo nuovo, esibendosi con la speciale scaletta, con cinque brani diversi, presentata per la prima volta durante il concerto alla Scala. Anche per la tappa di Venezia il cantautore sarà accompagnato dal suo storico ensemble orchestrale di undici musicisti eccezionali: Nunzio Barbieri, Lucio Caliendo, Claudio Chiara, Daniele Dall’Omo, Daniele Di Gregorio, Luca Enipeo, Francesca Gosio, Massimo Pitzianti, Piergiorgio Rosso, Jino Touche e Luca Velotti.
Paolo Conte 9 luglio Piazza San Marco | www.venetojazz.com
Tra i più importanti cantautori internazionali del nostro tempo, Damien Rice arriva l’11 luglio alla Fenice, portato al pubblico da Veneto Jazz nell’ambito della rassegna AAVV Autori Vari Indipendenti, in collaborazione con Vigna PR, Concerto Music e Live Nation. Dopo la pubblicazione degli album O, 9 e del più recente My Favourite Faded Fantasy, Rice porta in giro per il mondo il proprio lavoro, contraddistinto sempre da uno stile non convenzionale e dal piacere per l’improvvisazione. Artista unico ed eclettico, la cui vita da nomade lo ha portato spesso a cantare per le strade, viaggiando di città in città, ma che non gli ha precluso di raggiungere i più importanti palchi del mondo, trae le sue ispirazioni da Jeff Buckley, Leonard Cohen e Nick Drake. Damien Rice preferisce improvvisare sul palco senza avere una setlist, e predilige viaggiare in barca a vela piuttosto che con un tour bus, per questo motivo sta progettando un altro tour in barca a vela nel Mediterraneo che partirà proprio nell’estate del 2023.
11 luglio Teatro La Fenice | www.venetojazz.com

Ricordo molto bene la prima volta in cui mi sono imbattuto nel loro nome, per ovvi motivi allergico ad ogni possibile tentativo di plagio. Se dopo diverso tempo sono finalmente riuscito a soddisfare la curiosità di sapere da dove venisse un nome così particolare (da una birra scozzese a gradazione piuttosto alta, la Tactical Nuclear Penguin), ci hanno pensato loro stessi a farsi conoscere attraverso la propria musica e un successo di pubblico costante e inesorabile, favorito da testi accattivanti e originali, musiche che definire orecchiabili è dir poco, oltre che da una presenza studiata e ragionata agli eventi chiave della scena musicale italiana. Una presenza discreta ma fissa, a Sanremo come nella programmazione radiofonica grazie a canzoni come Ringo Starr, Pastello bianco e Giovani Wannabe
Cresciuti a latte e Queen e Coldplay, ma senza mai abbandonare i sentieri tracciati da De André e Dalla, i Pinguini arrivano il 7 luglio al Parco San Giuliano per un concerto epocale, che rimette in connessione gli spazi mestrini con un pubblico che ormai da diverso tempo ha dovuto, per vari motivi, interrompere i contatti con la grande musica live, tra fenomeni metereologici avversi, patatrac organizzativi e inimmaginabili emergenze sanitarie planetarie.

Riccardo Zanotti, Nicola Buttafuoco, Lorenzo Pasini, Simone Pagani, Matteo Locati ed Elio Biffi hanno visitato in febbraio i luoghi in cui saranno chiamati a suonare senza nascondere una buona dose di emozione, ma con una voglia matta di salire sul palco e far saltare un pubblico che sembra già attestarsi intorno alle 50.000 persone. Davide Carbone
Gli anni ‘70 sono stati in Italia una sorta di linea di confine tra il vecchio mondo e il nuovo, nelle arti come nel contesto sociale. Nel quadro musicale hanno stravolto le linee tradizionali della cosiddetta musica leggera, generando nella fattispecie a Napoli, una delle città più conservatrici in ambito musicale, una vera rivoluzione. Profeti ne sono stati gruppi come Napoli Centrale che mischiando le sonorità tradizionali napoletane ai ritmi di generi sviluppatisi in Paesi lontani ma affini allo spirito partenopeo, quali il blues, il funky o il soul, hanno composto una chimica di suoni in un impasto che oggi definiremmo glocal, o meno urticantemente world music. James Senese ne fu il fondatore, coadiuvato da valenti musicisti come Franco Del Prete, batterista degli Showmen di Ivano Fossati, e Mark Harris, che successivamente collaborerà con Fabrizio De Andrè. Per non dire del periodo in cui al basso suonava un ragazzo allora sconosciuto, un certo Pino Daniele. Partiti a suonare nei locali cittadini, in breve tempo il gruppo varca i confini della fama cittadina facendo conoscere le nuove sonorità partenopee in tutta Italia, divenendo una delle formazioni di punta della scena nazionale di quel decennio seminale. James Senese d’altronde di per sé personificava, figlio com’era di una mamma partenopea e di un militare afroamericano venuto a liberarci dal giogo nazifascista, in maniera perfetta la nuova cultura meticcia napoletana del dopoguerra, quel mix etnico e musicale che stava allora nascendo e che di lì a poco ridisegnerà la grammatica del sound mediterraneo contemporaneo. Il suono meraviglioso e struggente del suo sax resta una delle cose più intense e capaci di retituire il significato di quegli anni, bellissimi e tremendi.

La storia di Senese comunque non si è fermata a quell’esperienza. Dopo una lunga pausa ha ricominciato negli anni ‘90 il suo percorso musicale, da solo o accompagnato da altri musicisti. Durante la sua lunga carriera ha collaborato con leggende come Gil Evans, Art Ensemble of Chicago, Steve Thorton, Lester Bowie, Don Moye, Roberto De Simone, Tullio De Piscopo, Enzo Avitabile, oltre che con Pino Daniele. Gruppicardine del panorama meridionale come Almamegretta e 99 Posse, formatisi negli anni ’90, gli devono moltissimo.
Sento il sax di Chi tiene o’ mare di Pino Daniele: un suono lacerante, che ti entra nell’anima, facendoti capire l’animo napoletano più di mille racconti. Sì, è il suo, è il sax di James Senese. Massimo Macaluso

























































































Prime due date in terra veneta per il tour estivo di Marco Mengoni, che debutta col numero zero il 17 giugno a Bibione e il 20 giugno all’Euganeo di Padova. Il suo ultimo lavoro, MATERIA ( Pelle ) è il proseguimento del progetto musicale MATERIA, iniziato con (Terra ), già doppio disco di Platino. Si trovano tre anime differenti e complementari che uniscono le origini musicali di Mengoni, le sue ricerche sonore e la sua attenzione verso la contemporaneità. Con questo nuovo capitolo il cantautore presenta le sue ricerche musicali e le contaminazioni che da sempre lo attraggono e si fondono, creando qualcosa di nuovo. Il fil rouge rimane ancora una volta l’apertura verso il prossimo, il valore della diversità e della contaminazione. Una complessità che Mengoni ha trasformato in un baluardo, inno di vita e gioia che conduce o dovrebbe condurre gli esseri umani ad abbattere i confini e le barriere per spingersi più in là, lottando con tutte le forze per scoprire un mondo nuovo, capace di renderci cosmopoliti, così come già lo siamo, in maniera assai spesso inconsapevole. Mengoni stesso volendo interrogarsi sulle diverse etnie che scorrono nel suo sangue ha scoperto di essere italiano solo al 35%.
La presenza nell’album di strumenti unici come balafon, ngoni, mbira, karimba e di parole prese da lingue diverse, da “respirare” in lingua maori a “Unatoka wapi”, il nostro “Da dove vieni?” lo dimostrano senza remore. Una ricerca continua di stimoli e di contatto, sensoriale e ancestrale, che dal vivo immerge panicamente orecchie e anima del pubblico. Marzio Fabi
Marco Mengoni 20 giugno Stadio Euganeo-Padova

Tra i fans di Bruce Springsteen gira un detto secondo cui il mondo si divide in due: chi ama Bruce e chi non lo ha ancora visto dal vivo.
Andare ad un concerto del Boss equivale ad un vero e proprio battesimo per gli appassionati di rock di ogni età e generazione, una sorta di rito di iniziazione, una cerimonia sciamanica. Non di rado può capitare di vedere famiglie composte da nonni, figli e nipoti assistere alle interminabili performance del rocker di Long Branch, Freehold, New Jersey, anche perché il suo successo attraversa ormai almeno tre generazioni. Un miracolo di sopravvivenza in un mondo, come quello del rock, che i suoi idoli li brucia nello spazio di un mattino. Soprattutto al giorno d’oggi, al tempo dei fenomeni da reality che riescono a malapena a sfornare, se va bene, un paio di album, tutt’altro che memorabili per giunta.
La leggenda, ma di fatto è viva realtà, vuole che Bruce non abbia una scaletta preparata, o meglio, che ne abbia una infinita buona per sei concerti di fila, facendosi “guidare” in diretta dal pubblico nella scelta dei pezzi da interpretare. È infatti consuetudine che durante i concerti i fan, in particolare quelli delle prime file, esibiscano striscioni o cartelloni con scritti i nomi delle canzoni che vogliono ascoltare. Così quando Bruce scende tra il pubblico, con cui ha un rapporto quasi simbiotico, non deve fare altro che prendere il cartellone, girarsi verso l’E Street Band ed attendere il via dal suo batterista. Certo, te lo puoi permettere se hai al tuo fianco musicisti del calibro di Steven Van Zandt, Garry Tallent, Max Weinberg (a mio parere uno dei migliori drummers della storia del rock) e Jake Clemons, nipote dello storico sassofonista Clarence Clemmons, the Big Man!, che è riuscito nell’impresa non facile di non far rimpiangere lo zio, un vero e proprio totem, pietra miliare della band, quasi che il sangue del gigante nero abbia continuato a scorrere nelle sue vene. Te lo puoi permettere se sei Bruce Springsteen, forse il più grande performer live della storia del rock, che nonostante l’età ed i numerosi concerti non si risparmia mai e non scende dal palco se non c’è rimasto su almeno tre ore, senza fermarsi un attimo. Comunque la giostra del pifferaio del New Jersey è partita ancora una volta, passa da Ferrara il 18 maggio e c’è da scommettere che a dispetto delle 73 stagioni suonate avrà la stessa carica di energia e di positività di sempre. Perchè il Boss non tradisce mai le aspettative, sappiatelo... E lunga vita al rock!
Massimo Macaluso
Ha abbandonato i Genesis nel momento di maggior successo, probabilmente consapevole che il gruppo stesse andando verso il mood un po’ sdolcinato e canzonettaro di Phil Collins, perdendo la drammaticità teatrale che l’aveva coontraddistinto nel primo periodo, quello di Nursery Cryme e di Foxtrot per intenderci, quanto di più iconico sia stato prodotto dalla musica progressive. Evidentemente non gli andava a genio assecondare lo slittamento verso il commerciale, il facilmente commestibile musicalmente parlando. Allora Peter Gabriel ha iniziato a percorrere altre vie, più scarne ed essenziali, meno barocche, decisamente meno pop, a cominciare dalla ballata Solsbury Hill inclusa nel suo primo album da solista, dolce ma dura al tempo. Poi è stato un susseguirsi di album in cui spesso abbiamo ritrovato le sonorità dei primi Genesis, ma senza mediazioni e senza compiacimenti per chi ascoltava. In questa intensissima ricerca di nuovi percorsi si inserisce a pieno e profondo titolo la nascita di Womad (World Of Music, Arts And Dance), il festival da lui fondato nel 1980 che ha di fatto sancito la nascita, o per meglio dire il suo battesimo ufficiale, di quella che oggi tutti conosciamo come world music. Un raduno musicale progettato al fine di dare visibilità in Occidente alle tradizioni dei luoghi meno conosciuti del mondo e trasformato dal Nostro in un appuntamento annuale itinerante. Conseguenza diretta di questa straordinaria idea sarà poi la costituzione di una nuova etichetta discografica, quella Real World che attraverso le sue produzioni, le sue uscite discografiche ha davvero contribuito in maniera decisiva a svelare vere e proprie gemme, tra tradizione e contemporaneità, delle musiche di tutti i continenti, naturalmente con un’innata e costitutiva vocazione verso quelle culture musicale più nascoste e disconosciute, il tutto sempre all’insegna del dialogo, della contaminazione tra i generi. Insomma, parliamo di un artista poliedrico come pochi altri, che nella sua continua ricerca di forme espressive musicali e nei suoi stessi continui cambiamenti e rinascite può essere forse avvicinato, sia pure con percorsi ed estetiche propri, solo al mai troppo compianto Duca Bianco, quel David Bowie capace di dare del tu a tutti i generi art rock e al pop rimanendo inconfondibilmente sé stesso, ossia un concretissimo visionario inarrivabile.
Non vanno poi dimenticate le incursioni di Gabriel nel cinema nelle vesti di produttore di colonne sonore, una per tutte quella de L’ultima tentazione di Cristo di Scorsese.
Ha collaborato col Gotha della musica mondiale, da Robert Fripp a Tony Levin, da Brian Eno a Daniel Lanois. Insomma un artista a tutto tondo, che non finisce ancora di stupirci per la longevità e la creatività, e che avremo il piacere di rivedere all’Arena di Verona il 20 maggio. L’occasione è imperdibile anche per poter ascoltare i brani dell’imminente nuovo album I/O, prima, attesissima uscita dopo 12 anni di silenzio, la cui pubblicazione viene di mese in mese preceduta da dei singoli lanciati in coincidenza con ogni nuova luna piena. Che la sua luce ci accompagni, per chissà quanto ancora. Massimo Macaluso
Il Centro d’Arte, in collaborazione con SaMPL – Sound and Music Processing Lab del Conservatorio C. Pollini, presenta Audiomanzia, un nuovo festival dedicato alla sperimentazione sonora che dal 19 al 21 maggio alterna sessioni d’ascolto, performance, incontri e concerti, per indagare il potere divinatorio e magico della musica e, in particolare, dell’ascolto collettivo. La prima serata inizia con una sessione d’ascolto dei lavori selezionati per la call internazionale, un’esplorazione del rapporto tra arti del suono e arti occulte, sottoculture magiche e rituali audio contemporanei.
Successivamente, sarà la volta della performance live di Mai Mai Mai, figura fondamentale dell’elettronica italiana che adatterà le sue ricerche etnomusicologiche a tecniche storicamente usate per la comunicazione spiritica, attraverso tecnologie audio, registrazioni etnografiche d’archivio e narrazioni medianiche. Il giorno successivo vede la partecipazione come curatore di Riccardo Giacconi, co-fondatore del festival di ascolto Helicotrema e del laboratorio di narrazione sonora Botafuego, per una riflessione sul rapporto tra ascolto e ipnosi, audio storytelling e il suo concetto di “seconda persona sonora”. A seguire, performance live in quadrifonia di Giulia Rae, compositrice e sound designer attualmente ricercatrice associata presso l’Institute of Sonology de L’Aia. Terza e ultima serata alla Sala dei Giganti con una rara apparizione solista di Aleksander Kolkowski, compositore, musicista e ricercatore che presenta Wireless, performance meccanico-acustica nella quale recupera la forza immaginifica degli albori del suono registrato utilizzando tecnologie antiche e ‘obsolete’ come grammofoni, fonografi Edison e violini Stroh.
L’8 giugno al Teatro Torresino arriva Ghosted, il nuovo trio formato da Oren Ambarchi, Johan Berthling e Andreas Werliin, protagonisti assoluti di quella scena musicale che incrocia il jazz di ricerca, il rock psichedelico e l’elettronica più avventurosa.

Correva l’anno 1983, ci troviamo negli ambienti del gothic rock inglese, un flusso di bollore magmatico che solo la scena musicale d’Oltremanica poteva presentare.
Proviamo a isolare due band attive in quegli anni irripetibili: i Southern Death Cult (il cui cantante era Ian Astbury) e i Theatre of Hate (in cui suonò per breve tempo come chitarrista Billy Duffy).

È proprio il 1983 quando entrambi decidono di tagliare i rami secchi, abbandonando le rispettive formazioni e dando vita ai Death Cult, nome abbreviato della vecchia band di Astbury (che lo aveva mutuato da quello di una tribù Indiana del delta del Mississippi del XIV e XV secolo, essendo appassionato di cultura nativo-americana). In quello stesso anno il gruppo, con al basso Jamie Stewart e alla batteria Ray Mondo – entrambi ex membri dei Ritual –, pubblicò un EP omonimo e il singolo Gods Zoo. A partire da questo, dopo l’abbandono di Ray Mondo, che essendo illegalmente in Inghilterra venne espulso e rimpatriato in Sierra Leone, il batterista divenne Nigel Preston, anch’egli ex Theatre of Hate oltre che dei Sex Gang Children. Non male come inizio, per una band che avrebbe fatto la futura storia dell’hard rock e il cui frontman si sarebbe trovato a raccogliere l’eredità di una leggenda come Jim Morrison, nel breve percorso della band dopo la misteriosa dipartita del cantante-icona.
I The Cult arrivano a Pordenone l’1 luglio, ospiti del Pordenone Blues Festival, il giorno dopo i Deep Purple e prima di altre grandi firme del rock e del punk come Airbourne, The Stranglers e Buzzcocks. Ben 11 gli album in studio: Dreamtime (1984); Love (1985); Electric (1987); Sonic Temple (1989); Ceremony (1991); The Cult (1994); Beyond Good and Evil (2001); Born into This (2007); Choice of Weapon (2012); Hidden City (2016). Nell’ottobre del 2022 pubblicano Under The Midnight Sun, capolavoro acclamato da pubblico e critica, undicesimo disco della loro carriera.
Da sempre venerati da una foltissima tribù di adepti, i The Cult sono riusciti con grande abilità e genialità a introdurre nel sound gotico delle origini gli elementi di blues, psichedelia e possenti riff di chitarra, arrivando alla definitiva svolta hard-rock.
Uno stile che si è saputo nutrire delle influenze giuste, distillando poi sonorità a loro volta diventate fondamentali nella crescita di generazioni di musicisti. Inimitabili ma punto di riferimento assoluto per chiunque abbia intrapreso quel percorso musicale. In una parola: cult. Daniele Pennacchi
Provengono da Berlino, Schwerin, Wittenberge e Lipsia, e con il loro amalgama teutonico di industrial-rock, techno e gothic elettronico, immerso in un impianto fortemente scenico e pirotecnico, fanno ‘esplodere’ gli stadi con concerti spettacolari che da trent’anni registrano ovunque il tutto esaurito.
I Rammstein si formano a Berlino nel 1993 su iniziativa del chitarrista Richard Z. Kruspe-Bernstein. All’indomani del crollo del Muro, in un’atmosfera ancora connotata dai rigurgiti industrial della Germania Est, Kruspe-Bernstein riunisce attorno a sé gli altri componenti della band: Paul Heiko Landers (chitarra), Oliver “Olli” Riedel (basso), Christoph “Doom” Schneider (batteria) e, successivamente, il tastierista Christian “Doktor Flake” Lorenz, che diventerà l’alter ego autoriale di Kruspe-Bernstein incorporando nuovi toni neo-romantici e ballabili in quelli più duri e gotici che avevano caratterizzato il songwriting della band fin dall’inizio. La scelta del cantante ricade su Till Lindemann: la voce bassa e profonda, la presenza scenica imponente e l’abilità nel maneggiare mezzi pirotecnici lo rendono il frontman ideale dei neonati Rammstein. Più che un progetto musicale, il loro è un manifesto programmatico. Il nome della band deriva dalla città di Ramstein, al confine con la Francia. Sede di una base militare NATO, Ramstein è tristemente famosa per un incidente aereo avvenuto nel 1988, causato da un jet delle Frecce Tricolori che provocò la morte di sessantasette persone. La “m” in più nel nome del gruppo rispetto alla città tedesca è dovuto ad un errore di battitura. In seguito la band decise di non correggere l’errore in quanto la parola Ramm, che significa ariete, unita a Stein, sasso/ pietra, evocava l’immagine dell’arma da assedio utilizzata nell’antichità per sfondare le porte di accesso a fortezze e castelli. Un simbolismo perfettamente in linea con la loro musica, potente e vigorosamente metallica. A mettere definitivamente a fuoco l’identità dei Rammstein è l’uso esclusivo della lingua tedesca. Cresciuto nella Germania comunista, Lindemann non aveva avuto molte occasioni di entrare in contatto con ambienti anglofoni. Il suo forte accento tedesco avrebbe compromesso la credibilità di testi scritti in inglese. Per contro, il suo timbro carismatico e profondo, i toni enfatici e uno spiccato rotacismo nel pronunciare le parole nella sua lingua madre hanno marcato in modo distintivo lo stile della band, che è riuscita negli anni a cavalcare a proprio vantaggio lo stereotipo della durezza germanica con costumi stravaganti, molta ironia e quel po’ di kitsch che non guasta. Marisa Santin

















Extending along the waterfront on one of the most beautiful stretches of the Grand Canal, the splendid Gritti Terrace continues to be the social hub of Venice. Drop in from 12:30pm until 17:30pm for an informal lunch, afternoon snacks, or a glass of perfectly chilled bubbles immersed in a living canvas of the city’s legendary monuments.

FOR RESERVATIONS, PLEASE CALL +39 041 794611 OR VISIT CLUBDELDOGE.COM







Una laurea in Lingue e Letterature straniere, master in Storia ed Estetica dello Spettacolo e in Management e Marketing sempre dello Spettacolo: percorsi di studio che già di per sé ne definiscono vocazione e professionalità. Una lunga carriera contrassegnata dall’interesse per la danza che lo ha portato a seguire come critico, consulente e, in breve tempo, direttore artistico molti festival, fino ad essere responsabile artistico e organizzativo delle attività di danza della Fondazione Teatro La Fenice. Franco Bolletta è il nume tutelare della danza, uno dei massimi esperti in Italia, capace di avere sempre un occhio attento all’equilibrio tra tradizione e contemporaneità, sia coreograficamente che drammaturgicamente, intercettando e offrendo in programmazione al pubblico de La Fenice le migliori produzioni a livello internazionale.
L’occasione per incontrarlo è Lac, una rilettura de Il lago dei cigni del coreografo Jean-Christophe Maillot. Basata su una drammaturgia ideata appunto da Maillot insieme allo scrittore Jean Rouaud, su musiche originali di C ˇ ajkovskij, con aggiunte di Bertrand Maillot, eseguite dal vivo dall’Orchestra del Teatro La Fenice diretta da Igor Dronov, Lac vede protagonista sul palco una tra le compagnie più apprezzate della scena internazionale, Les Ballets de Monte-Carlo. La coreografia fonde balletto classico e danza moderna dando vita a uno spettacolo drammatico e sensuale, attraversato dall’inizio alla fine
da una intrigante tensione. Maillot mette la narrazione al centro dell’opera. Ne Il lago dei cigni tutto è oscuro, complicato e ricco di significato; C ˇ ajkovskij stesso aveva concepito l’idea di un balletto sinfonico sul tema di una creatura umana la cui metamorfosi rendesse impossibile qualunque amore. La genesi di questo cigno, creato a partire da miti greci, nordici e russi, ne fa, fin dal suo concepimento, un essere ibrido affascinante. Maillot si riconnette con i tormenti di un racconto in presa diretta che affronta le nostre paure infantili e i nostri terrori notturni.
Il lago dei cigni è una pietra miliare del balletto classico. Cosa lo rende davvero unico, leggendario e incredibilmente senza tempo?
Il motivo di questa consacrazione risiede in molti elementi che ne caratterizzano lo svolgimento: la musica, la drammaturgia, la coreografia e, non ultima, l’idea imponderabile della casualità dei miti.
Il lago dei cigni nacque sfortunato, per inesperienza e sciatteria organizzativa. Fu solo la genialità di Marius Petipa, nel riprenderlo al Marinskij di San Pietroburgo dopo il fiasco del Bolshoij, a portarlo alla gloria meritata. Il fatto che tutte le grandi ballerine del Novecento e oltre abbiano voluto interpretare il personaggio di Odette/ Odile, contribuendone a rafforzare il mito, dice eloquentemente tutto sulla dimensione senza tempo di questa straordinaria opera d’arte.
Moltissime le versioni, puntuali o meno, che da più di un secolo vengono proposte del balletto.
Franco Bolletta is the art director and manager of the dance section at Fenice Theatre. Bolletta enjoyed a long career in the world of dance, taking multiple roles all the while, and is considered one of the best dance experts in Italy, given his attention for both the classical and the modern, and his ability to create beautiful dance programmes with the best international productions. We met him to discuss Lac, a reading of Swan Lake by choreographer Jean-Christophe Maillot. Based on a drama Maillot wrote with author Jean Rouaud, the ballet uses Tchaikovsky’s music with additions by Maillot played live by the Fenice Orchestra, conducted by Igor Dronov. On stage, one of the best international ballet companies: Les Balelts de Monte-Carlo. This choreography blends classical ballet and modern dance for a dramatic, sensual show, filled with tension from start to end. Tchaikovsky himself wanted a ‘symphony ballet’ piece about a human creature whose transformation would prevent love in any form. The genesis of this Swan, built upon Greek, Nordic, and Russian myth, makes it a fascinating hybrid creature since its inception. Maillot puts the story front and centre and reconnects with the a tormented tale about childhood fear and night-time horror.
Swan Lake, a cornerstone of ballet and a unique, timeless legend
The reason it is lies in its several components: music, drama, choreography, and, in no little part, the imponderability of randomness in myth. Swan Lake had a difficult start, due to inexperience and mismanagement. It was only thanks to the genius of Marius Petipa that afforded it its glory, after the fiasco at Bolshoy and a new, fortunate production at the Mariinsky, in Saint Petersburg. The fact that the greatest ballerinas of the twentieth century all wanted to play Odette/Odile reinforced Swan Lake’s status as a piece of ballet myth, and says a lot on the timeless dimension of this extraordinary piece of art.




The most fabulous staircases of the City
Scuola Grande San Giovanni Evangelista and Scala Contarini del Bovolo





biglietto combinato | combined ticket
gioiellinascostidivenezia.it | scuolasangiovanni.it
La versione personale che Jean-Christophe Maillot, direttore e coreografo dei Ballets de Monte-Carlo, ci offre assume sfumature contemporanee di grande forza scenica. Quale le peculiarità del suo Lac ?

Jean-Christophe Maillot attua una rilettura del Lago di C ˇ ajkovskij/ Petipa/Ivanov dando alla drammaturgia un tocco in più di mistero e magia. I personaggi rimangono gli stessi in linea di massima, eccezion fatta per la regina, che viene sostituita con un’amante/compagna del re e della di lei figlia, che la madre vorrebbe maritare allo sconsolato principe. Maillot, come è sua abitudine, fa una citazione da precedenti versioni: in epoca sovietica nella versione di Oleg Vinogradov per Il Kirov Ballet ci sono i cigni bianchi (buoni) e i cigni neri (cattivi) che lui riprende per il suo Lac.
Un’altra peculiarità del coreografo francese è il rispetto della musica e il vantaggio di avere a disposizione una compagnia di elevato livello tecnico-artistico.
Recensendo lo spettacolo nell’aprile 2014 «The Times» scrive: «La coreografia di Maillot, ad alta intensità energetica e spaziale, domina il linguaggio del balletto classico, si accoppia scorrevolmente alla musica e accentua l’elegante duttilità tecnica dei danzatori». Secondo lei è la formula perfetta per traghettare il balletto classico nella contemporaneità?
È uno dei modi. Un altro, e forse uno dei più interessanti, è quello utilizzato dal coreografo belga Joroen Verbruggen per il suo Schiaccianoci creato per la compagnia del Grand Théâtre de Geneva. A parte la musica, tutto il resto cambia: drammaturgia, grammatica coreografica. Il risultato è esaltante, ha avuto l’idea giusta.
Le scene di Ernest Pignon-Ernest, i costumi di Philippe Guillotel, la drammaturgia di Jean-Christophe Maillot e Jean Rouaud, la musica addizionale di Bertrand Maillot, il light design di Jean-Christophe Maillot e Samuel Thery: un dream team di professionisti che dimostra come il balletto classico sia quanto mai vivo e vitale. Quale lo stato di salute della produzione della danza e delle scuole e compagnie?
Scomparsi i coreografi che hanno fatto la storia della danza nello scorso secolo, rimangono quelli che sono stati a loro volta geniali ma che non hanno più grandi illuminazioni, fatte rare eccezioni. Ne parlo comunque con tutto il rispetto dovuto, s’intende, poiché trattasi sempre di straordinari professionisti.
È un periodo di transizione, come ce ne sono sempre stati nella storia della danza. Le Accademie continuano, per fortuna, a formare buoni danzatori che, se avranno la fortuna di entrare a fare parte di compagnia di livello, riusciranno a perfezionarsi e a dire la loro in maniera innovativa in termini di visioni ed interpretazioni.
Perchè la programmazione del Teatro La Fenice, attentissima su altri filoni classici, non lo è ugualmente nei riguardi del Balletto? È difficile creare un’offerta stagionale specifica?
È un problema di spazio e di finanziamenti. Il FUS (Fondo Unico per lo Spettacolo ndr) non è mai cambiato salvo alcune volte, ma al ribasso. Le stagioni sono brevi e non si riesce a programmare tutto quello che si vorrebbe e potrebbe proporre. Lo spettacolo dal vivo ha dei tempi fisici imprescindibili e queste stagioni compresse impediscono una programmazione più articolata e dispiegata con il giusto respiro.
Several versions, one choice: Lac
Jean-Christophe Maillot’s read of the Swan Lake of Tchaikovsky/ Petipa/Ivanov boosts the drama with an extra touch of mystery and magic. The characters are mostly the same, with the exception of the queen, who is replaced with a king’s mistress or lover, and her daughter, which she wants to marry of to the despondent prince. Maillot also makes references to former versions: in Soviet times, Oleg Vinogradov divided the swans in white (good) and black (bad) for the Kirov Ballet, which Maillot adopts for his Lac.
Maillot’s high-energy, space-consuming choreography is well versed in the language of classical ballet, engaging fluently with the music and accentuating the length and suppleness of the dancers’ elegant technique. (The Times, 2014)
One of the many formulas to ferry classical ballet into modernity. Another, which is maybe one of the most interesting, is one adopted by Belgian choreographer Jeroen Verbruggen for his Nutcracker, written for Geneva’s Grand Théâtre company. The music stays the same, everything else doesn’t: script and choreography. An exciting result – he did the right thing.
A dream team of professionals to show how alive and well is classical ballet.
Once the choreographers that made the history of twentieth-century ballet passed away, only a few remain, those who despite their abilities did not revolutionize the field. I do respect them, obviously, we are talking of skilled professionals. This is a transitional period, as there always have been in the history of dance. Schools keep on training excellent dancers, who, if they’ll find a place in a good company, will perfect and innovate further.
The programme at Fenice: a classical ballet season that can be even greater.
There are both money and space constraints. The government’s showbusiness fund has never been increased. In fact, on occasion it has been cut somewhat. Our season programmes are short, and that means we cannot do everything we would like. Producing live shows takes time, and if the season is short, it becomes impossible to do more, and to take a breather when it is needed.
È rapidamente emerso come uno dei più interessanti direttori americani in attività attualmente, ed è divenuto uno dei più richiesti talenti della nuova generazione. Avendo vinto il James Conlon Conducting Prize all’Aspen Music Festival & School, e conseguentemente lavorando come direttore associato alla Cincinnati Symphony Orchestra e alla New York City Opera, entra sotto la luce dei riflettori al Bolšoj nel dicembre del 2013 dirigendo una nuova produzione del Don Carlo di Verdi. Ha commissionato composizioni, diretto prime assolute e collaborato strettamente con compositori del rango di John Adams, Philip Glass, Sofia Gubaidulina, Jennifer Higdon, Andre Previn, Augusta Read Thomas, Shulamit Ran e John Zorn.Nei concerti alla Fenice lo troviamo impegnato nella Sinfonia n. 6 in fa maggiore Op. 68 Pastorale di Beethoven e in Also sprach Zarathustra Op. 30 di Strauss.
ENG Trevino rapidly emerged as one of the most interesting American conductors of today, and one of the most sought-after talents of his generation. He won the James Conlon Conducting Prize at the Aspen Music Festival & School and later worked with the Cincinnati Symphony Orchestra and at the New York City Opera. At the Fenice Theatre in Venice, Trevino will conduct Beethoven’s Symphony no. 6 in F majora and Strauss’s Also sprach Zarathustra, op. 30.


26, 28 maggio Teatro La Fenice
Nato a Birmingham nel 1990, è stato violoncello principale della CBSO Youth Orchestra, il che gli ha permesso di partecipare nel 2007 a diverse masterclass sulla direzione d’orchestra all’interno della Youth Orchestra Academy. L’anno successivo è entrato al Royal Northern College of Music per studiare violoncello con Eduardo Vassallo, per poi proseguire con il prestigioso Master in Direzione a cura di Clark Rundell e Mark Heron. Il concerto di venerdì
9 giugno è preceduto da un incontro a ingresso libero con il musicologo Roberto Mori, che illustra il programma musicale incentrato su Franz Schubert e Luciano Berio ( Rendering ) e van Beethoven ( Sinfonia n. 5 in do minore op. 67 ).
ENG Born in Birmingham in 1990, Alpesh Chauhan played the cello at the CBSO Youth Orchestra, which allowed him to take conduction classes at the Youth Orchestra Academy. In 2008, Chauhan enrolled in the Royal Northern College of Music to further both his cello (with Eduardo Vassallo) and conduction studies. The concert he will conduct on June 9 will be introduced by a free-access meeting with musicologist Roberto Mori on the concert’s programme: Schubert, Berio, and Beethoven.
9, 10 giugno Teatro Malibran

Ha ricoperto numerosi incarichi prestigiosi con orchestre e teatri internazionali, debuttando alla Fenice nel 1988 nel primo allestimento della versione revisionata di Elegy for Young Lovers di Hans Werner Henze. Da allora ha lavorato con i più importanti teatri e festival internazionali, tra cui Scala, Bayerische Staastoper, Stuttgart Opera, Frankfurt Opera, Glyndebourne Festival Opera e Chicago Lyric Opera. Nella Stagione 2018-2019 ha diretto la tanto attesa prima mondiale di Fin de partie di György Kurtág alla Scala e alla Dutch National Opera. Il programma dei concerti alla Fenice comprende Franz Joseph Haydn, con la Sinfonia in sol maggiore Hob. I: 94 La sorpresa e Richard Strauss, di cui ascoltiamo Ein Heldenleben (Una vita da eroe), Op. 40. ENG Stenz took several prestigious positions with international theatres and orchestras. He debuted at Fenice in 1988 in the first staging of a revised Elegy for Young Lovers by Hans Werner Henze. In the 2018-2019 season, he directed the much-anticipated world premiere of György Kurtág’s Fin de partie at Milan’s Scala and at the Dutch National Opera. At Fenice, Markus Stenz will conduct the orchestra on music by Haydn (Symphony No. 94 in G major, known as the Surprise Symphony) and Strauss (Ein Heldenleben (A Hero’s Life), Op. 40).
30 giugno, 2 luglio Teatro La Fenice

L’Olandese volante di Richard Wagner è in scena alla Fenice dal 22 giugno prossimo in un nuovo allestimento con la regia di Marcin Lakomicki, le scene di Leonie Wolf, i costumi di Cristina Aceti e il light design di Irene Selka. Orchestra e Coro sono diretti da Markus Stenz, con Alfonso Caiani preparatore del Coro.
Fortunato Ortombina, Sovrintendente della Fenice ci offre il suo racconto dello spettacolo, incluse divagazioni, colte e pertinenti, sul musicista di Lipsia.
«Finalmente Wagner torna alla Fenice, con un intento programmatico che non si limiterà alla recita di quest’opera, in virtù del rapporto particolare che legava il compositore a Venezia. Non va scordato che Wagner era un assiduo avventore del Caffè Lavena di Piazza
San Marco, dove amava ascoltare i concerti della banda comunale cittadina: abbiamo anche la testimonianza del direttore di questa banda, che nel 1882 venne avvicinato da un anziano signore molto elegante che gli chiese di ripetere la sinfonia La gazza ladra, appena eseguita. Richiesta che il direttore non poté soddisfare, perchè proveniva da una persona sola e non dalla Piazza o da un gruppo più numeroso di spettatori. Il signore elegante comprese e salutò, ringraziandolo comunque. Immaginate la faccia del direttore quando il primo clarinetto lo mise al corrente dell’identità dell’elegante signore: Richard Wagner.
Egli era un ascoltatore attentissimo dell’orchestra comunale e del repertorio operistico italiano che veniva proposto in Piazza San Marco, a sfatare il falso mito secondo cui il compositore tedesco guardasse con sufficienza a quel repertorio. Per quale motivo avrà chiesto di risentire La gazza ladra, che di sicuro conosceva? Probabilmente per aver sentito, nel primo ascolto, combinazioni di strumenti a fiato che lo avevano incuriosito e stimolato.
La prima opera di Wagner rappresentata a Venezia è il Rienzi nel 1874 e appena un anno dopo la sua morte, avvenuta proprio a Venezia nel 1883, va in scena per la prima volta il suo Der Ring des Nibelungen nella versione completa, ciclo di quattro drammi musicali che per buona parte del Novecento sarà rappresentato con discreta regolarità. Sono molti in città gli appuntamenti wagneriani nel corso dei decenni. Nel 1980 Peter Maag dirige alla Fenice un Tristan ; suo assistente era un allora ventunenne Christian Thielemann, oggi considerato il più grande direttore wagneriano al mondo, tornato nel 1990 a dirigere il Lohengrin
Ogni volta che viene eseguito Wagner a Venezia si crea una relazione intima con il pubblico, veneziano e non. Si stabilisce un rapporto di fortissima identità tra le diverse componenti coinvolte in queste esecuzioni: Wagner stesso, la Fenice, gli spettatori. Venendo allo specifico di Der fliegende Holländer, l’opera fa parte del cosiddetto “Wagner romantico”. La Fenice aveva proposto il Ring tra il 2006 e il 2010, con la direzione di Jeffrey Tate e la regia di Robert Carsen. Un appuntamento importante con un allestimento impegnativo, che non può essere dunque proposto spesso. Ma nei prossimi anni avremo la possibilità di recuperare il tempo perduto, o per meglio dire di ricalibrare gli indirizzi programmatici. Ora abbiamo in programma L’Olandese Volante, a cui seguiranno in futuro Lohengrin e Tannhäuser, fino a quando metteremo in cartellone un altro Ring. Il nuovo allestimento della Fondazione Teatro La Fenice in programma dal 22 giugno è diretto da Markus Stenz, un musicista che con il teatro lirico veneziano ha un rapporto particolare, avendo iniziato la sua carriera di direttore proprio qui a Venezia ad appena 22 anni. È stato lontano dalla Fenice per tanto tempo e oggi, finalmente, è di nuovo con noi. Oltre a dirigere quest’opera di Wagner, lo ritroveremo nella prossima Stagione impegnato in un’opera di Strauss.
La regia dell’allestimento è affidata a Marcin Lakomicki, giovane professionista molto addentro al repertorio tedesco. Il cast è di assoluto rispetto e vede Toby Spence nei panni di Erik, Franz-Josef Selig ad interpretare Daland, Anja Kampe nelle vesti di Senta; come Olandese Samuel Youn, un basso baritono coreano che ebbi il piacere di ascoltare in un Rigoletto messo in scena nella piazza di Oderzo ben 12 anni fa. Fin da allora mi impressionò favorevolmente e ora lo si trova come uno dei più autorevoli interpreti di questo ruolo.
L’Olandese Volante è un’opera in cui il vero protagonista, al di là dei singoli personaggi, è il mare. L’opera inizia con una delle incomparabili ouverture di Wagner. Il mare in tempesta è dipinto come in un poema sinfonico. Le tempeste di Rossini e Meyerbeer sono solo una leggera brezza in confronto all’uragano di Wagner.
Inutile dire come l’elemento marittimo leghi ancor di più questo evento alla città di Venezia, che dell’incontro tra mare e terra è avamposto del mondo, culturale e geografico». Fabio Marzari
La Stagione di musica da camera della Fenice ci ha abituato da anni a mettere insieme quantità e qualità, con una gran numero di date che mensilmente si avvicendano nelle Sale
Apollinee e nella Sala Grande del teatro alternando concerti solisti, formazioni cameristiche e appuntamenti che affiancano musica e recitazione, da sempre linguaggi affini e paralleli. Maggio e giugno mettono assieme un campionario completo della febbrile attività di Musikamera con concerti di Massimiliano Grotto (24/5) e Angela Hewitt (11/6), i duetti Caroli-Martignon (31/5), Padmore-Cooper (13, 14/6) e Armellini-Zanon (18/6) e un incontro tra la voce recitante di Milena Vukotic, il flauto di Mario Ancillotti e il pianoforte di Alessandro Marangoni (7, 8/6).

Musikamera
24, 31 maggio; 7, 8, 11, 13, 14, 18 giugno Teatro La Fenice www.teatrolafenice.it
Quando si parla di Uto Ughi, non si parla mai ‘solamente’ di musica. La sua attenzione verso le nuove generazioni lo ha reso figura capace di andare oltre i confini del proprio virtuosismo, al pari di illustri colleghi come Claudio Abbado e Riccardo Muti.
La musica ancora una volta riesce a farsi portatrice di messaggi universali, non solo educando al bello ma facendo capire ai più giovani cosa voglia dire coltivare un talento attraverso la disciplina, sopportando sacrifici e ricevendo in cambio l’impareggiabile soddisfazione di vivere delle proprie passioni, condividendole con gli altri.
L’evento del 18 maggio alla Scuola Grande di San Rocco, ideato dal M° Uto Ughi e dall’Associazione culturale Arturo Toscanini di Savigliano, è realizzato grazie al sostegno di ENI e ha la finalità di diffondere e regalare la gioia della grande musica classica alla cittadinanza, specialmente alle giovani generazioni che oggi più che mai necessitano di recepire i grandi valori che questa trasmette.
Un repertorio che a Venezia è quasi obbligato, ossia le Quattro Stagioni di Antonio Vivaldi, sicuramente la più nota delle composizioni del Prete Rosso. Quattro concerti distinti, in realtà, ispirati da altrettanti sonetti del compositore veneziano che li ha dedicati ciascuno ad un particolare periodo dell’anno, con i propri profumi e i propri colori. Uto Ughi legge e commenta i sonetti vivaldiani che precedono l’esecuzione di ogni concerto, per restituire al testo tutta la sua poeticità e facendo apprezzare la musicalità dei versi e quella delle note del suo violino. Si potrà seguire il testo sul programma di sala per una maggiore comprensione del testo, in quella che diventerà una coinvolgente lezione-concerto.
Per gli studenti del Conservatorio sono inoltre previste anche masterclass di alto perfezionamento in violino, e le prove del concerto saranno a porte aperte per gli studenti di tutte le scuole di ogni ordine e grado che vorranno assistervi. Davide Carbone


Nelle domeniche di maggio all’M9 prosegue il ciclo di concerti Sulle note del secolo. I maestri del ‘900 coordinato dal Maestro Giovanni Battista Rigon.
L’appuntamento del 21 maggio è dedicato alla scuola tedesca, all’introduzione di Riccardo Vaglini seguono i brani di Paul Hindemith, Julius Röntgen ed Hermann Goetz.
La rassegna si chiude il 28 maggio con un concerto nel segno della grande tradizione italiana. Giovanni Bietti, compositore, musicologo e autore-conduttore di Lezioni di Musica (Rai Radio 3) dà il via a un viaggio che parte da Gian Francesco Malipiero e arriva alle melodie di Antonio Vivaldi, passando per Ildebrando Pizzetti e Baldassarre Galuppi.
Sulle note del secolo. I maestri del ‘900
14, 21, 28 maggio M9 - Museo del’900-Mestre www.m9museum.it
ENG The name of Uto Ughi means so much more than music, his attention for the younger generations is a driving force for the education of aspiring artists and helps them understand that discipline and sacrifice will bring about the unparalleled satisfaction of living of one’s own passion. Coming up on May 18 an event created by Ughi and the Arturo Toscanini culture club: Antonio Vivaldi’s Four Seasons, a staple piece of classical music and of Venetian culture. Usually performed in a row, each season is, in fact, its own concert, and each is accompanied by poetry by Vivaldi. Uto Ughi will read and comment the sonnets before the execution, to better appreciate the art and blend the musicality of the verses with the notes of his violin. Ughi is also in town for a violin master class programme offered to students of the local Music Academy.
Inedita edizione primaverile per la rassegna I Luoghi di Baldassare – Festival Galuppi e della Musica, che quest’anno festeggia la trentesima edizione. Undici concerti, con interpreti di grande fama e la collaborazione dei Conservatori di Venezia e Bologna, che toccano tre luoghi simbolo della città: il Teatro La Fenice, la chiesa e la Scuola Grande di San Rocco. Filo conduttore della manifestazione, nata per ricordare il celebre compositore Baldassare Galuppi, detto il buranello, nato nel 1706, sarà “il sacro in musica”.
Il calendario della rassegna propone diversi approfondimenti su musica strumentale e da camera, Opera Buffa del Settecento, e poi ancora alcuni segmenti che da sempre formano la spina dorsale della manifestazione: le Sezioni, Strumenti Rari, Collaborazioni Internazionali, Manoscritti inediti, Centenari, Vincitori premi internazionali e Linea verde, quest’ultima dedicata ai giovani concertisti.
«Trent’anni di vita di una rassegna – spiega il direttore artistico Alessio Benedettelli – pensata per i cittadini di Venezia e della Città metropolitana, che quest’anno abbiamo deciso di anticipare nella programmazione per evitare il sovraffollamento di appuntamenti musicali nei mesi di settembre e ottobre.
L’edizione del trentennale indaga una parte dell’universo compositivo poco proposta nei programmi musicali in genere. Messe, cantate, mottetti, sacre rappresentazioni, oratori, sono solo alcuni aspetti dell’enorme produzione in cui i più celebri musicisti si siano cimentati».

Tra i concerti in programma sono da ricordare la Petite Messe Sollennelle di G. Rossini per soli, coro, pianoforti e armonium il 14 maggio. A seguire il 20 maggio il concerto dedicato a Adriano Banchieri ed eseguito dai maestri del Dipartimento di Musica Antica del Conservatorio “G.B. Martini“ di Bologna.

La Sacra Rappresentazione di Caterina Serva e schiava dei Servi di Gesù Cristo fa conoscere maggiormente allo spettatore, domenica 28 maggio, la storia della Santa di Siena. Di un autore poco eseguito come Platti viene proposto il 1° giugno un Miserere per solo coro e un Requiem, contrapposto a quello più famoso di Mozart in programma invece sabato 17 giugno.
GIOVEDÌ 25 MAGGIO
ORE 18
CONFERENZA
Spontini e La Vestale, genesi e metamorfosi di un capolavoro
Federico Agostinelli relatore ingresso libero
prenotazione obbligatoria

Una degustazione di vini con La Laguna nel bicchiere sarà offerta a fine conferenza
USCITA 11 MAGGIO
BRU ZANE LABEL
contact@bru-zane.com

IN TUTTA ITALIA.
Da oltre 30 anni siamo a fianco di enti e istituzioni. Scopri il nostro impegno su corporate.coopculture.it
Working alongside cultural organizations and institutions in Italy for over thirty years, creating places of culture on a human scale.









Discover our commitment on corporate.coopculture.it impresa culturale e cooperativa | cultural and cooperative enterprise


Stagione numero 100 per l’Arena di Verona, l’anfiteatro romano secondo per fama solo al Colosseo, ma indiscutibilmente il teatro d’opera all’aperto più famoso al mondo. Le epiche rappresentazioni che hanno visto alternarsi grandi direttori e interpreti leggendari, appartengono ad altre stagioni, lontane nel tempo, basti pronunciare tra tanti il nome di Maria Callas, che in Arena fece il proprio debutto internazionale.

È cambiato il pubblico e all’Arena si cerca la spettacolarità di allestimenti sibaritici che riportano ad un barocchismo un po’ kitsch che fa storcere il naso ai puristi dell’opera, ma il successo costante delle stagioni con gli spettacoli sold out dimostrano una grande e sempre viva affezione del pubblico verso le rappresentazioni in cartellone. Oltre ad una nuova produzione di Aida, l’opera regina in Arena che ancora incanta schiere di pubblico di ogni provenienza, gli altri titoli sono Nabucco, Rigoletto e La Traviata di Verdi, Carmen di Bizet, Tosca e Madama Butterfly di Puccini e Il Barbiere di Siviglia di Rossini. Uno sforzo produttivo importante per portare in scena nella stessa stagione gli allestimenti firmati da veri maestri del genere come Franco Zeffirelli e Hugo de Ana, e un omaggio alla grande storia areniana rappresentata da Gianfranco de Bosio. Non mancano appuntamenti divenuti fissi come l’evento di Roberto Bolle and Friends o il Teatro alla Scala in Arena con l’Orchestra del teatro meneghino. Cinquanta serate in tre mesi, inclusi tre Gala dedicati a grandi interpreti come Juan Diego Florez, Plácido Domingo e Jonas Kaufmann. F.M. ENG The Verona Arena sets off its 100th opera season. The Roman amphitheatre second in fame to the sole Coliseum, and arguably the most famous opera house in the world, saw legendary artists perform on its stage. One name for all: Maria Callas, who made her international debut there. Different audiences, today, keep the world of opera evolving, and they’re doing something right at the Arena with sold-out show after sold-out show. There’s a new Aida production in the programme, as well as the Nabucco, Rigoletto, Traviata, Carmen, Tosca, Madama Butterfly, and the Barber of Seville. Fifty shows in total, over the span of three months, including recurring events we’ve grown to love such as Roberto Bolle and Friends
Dal 21 aprile all’11 giugno tornano le note delle Settimane Musicali al Teatro Olimpico, il Festival che ogni anno richiama al Teatro Olimpico di Vicenza e in altri luoghi storici della città un pubblico di appassionati, nel rito condiviso della musica dal vivo. Con la direzione artistica di Sonig Tchakerian, il Festival riconferma la propria vocazione di palcoscenico votato al pluralismo dell’espressione artistica e di laboratorio di creazione dove la musica da camera incontra il jazz, il teatro e il racconto. Il calendario di quest’anno rientra nella programmazione triennale del Festival che prende spunto da un pensiero di Pier Paolo Pasolini: Prima il silenzio, poi il suono, o la parola. Un invito alla riflessione, dalla privata intimità che il silenzio protegge alla condivisione dell’esperienza del suono e della parola. Molti gli appuntamenti che articolano il calendario del Festival: i concerti di musica da camera al Teatro Olimpico, il Concorso Pianistico Premio Brunelli, il Progetto Giovani, il Mu.Vi – Musica Vicenza e le conversazioni con musicologi prima dei concerti.
L’evento inaugurale del Festival è domenica 21 maggio con il primo dei quattro appuntamenti al Teatro Olimpico in compagnia di artisti di fama internazionale. Il concerto è intitolato Seasons and Mid-Seasons e si apre con l’evocativo e sacro Inno di Nerses Shnorhali, teologo, poeta e scrittore armeno del XII secolo. Il canto di Shnorhali rappresenta la preziosa e singolare occasione di ascoltare, nell’anno in cui ricorrono gli 850 anni dalla morte dell’autore, un brano di rara esecuzione, un invito al silenzio, alla meditazione, al suono e all’ascolto. Il concerto prosegue con un repertorio che spazia dal barocco al jazz, da Le Quattro Stagioni di Antonio Vivaldi alle Mezze Stagioni del sassofonista e compositore Pietro Tonolo. Protagonisti del concerto saranno Sonig Tchakerian al violino, Pietro Tonolo al sax e l’Orchestra Regionale Filarmonia Veneta. Il secondo concerto al Teatro Olimpico è venerdì 26 maggio e vede il ritorno di Mario Brunello che, con il suo violoncello, è impegnato in musiche di Johann Sebastian Bach e del compositore russo, di origine polacca, Mieczyslaw Weinberg per un viaggio dal barocco al Novecento. Domenica 28 maggio è in programma Una visita a Beethoven, spettacolo basato sul racconto di Richard Wagner in giovane età, testo in cui immagina il suo avventuroso viaggio per incontrare Beethoven. Uno spettacolo che vede in scena l’attore Paolo Kessisoglu, Sonig Tchakerian al violino e Leonora Armellini al pianoforte. Venerdì 2 giugno è la volta del concerto Dialoghi con il pianista Andrea Lucchesini e il clarinettista Gabriele Mirabassi, impegnati in un programma che attraversa diverse epoche e paesi: dal ’700 italiano al repertorio contemporaneo, dal mondo sudamericano all’improvvisazione jazz. Un viaggio musicale tra epoche diversi e paesi da non perdere in questa rassegna vicentina. Katia Amoroso

 Lelouch
Lelouch
Tre film italiani sono in lizza per la Palma d’oro: Il sol dell’avvenire di Nanni Moretti, La chimera di Alice Rohrwacher e Rapito di Marco Bellocchio. Non solo, un po’ italiana (un bel po’) è anche la madrina dell’edizione di quest’anno: sarà Chiara Mastroianni a fare gli onori di casa. L’attrice e modella francese di origini italiane in linea paterna è forse la figura che meglio di tutte incarna l’abbraccio tra cinema italiano e francese, in quanto figlia di un mostro sacro per eccellenza di entrambi i panorami della settima arte.
Il film di Moretti, in sala da diversi giorni, è stato a più riprese definito come un perfetto esempio dello stile del regista, ad alto tasso morettiano eppure in grado di interrogare, provocare e divertire anche chi non appartiene alla sua squadra, portando al cinema una storia che riflette sulla caduta dei grandi ideali e su quanto questa possa dimostrarsi in qualche maniera addirittura terapeutica, provvidenziale.
Bellocchio e Rohrwacher ancora non hanno vissuto il grande incontro con il pubblico, la loro presenza a Cannes sembra per certi aspetti naturale, confermandoli come registi capaci di parlare a platee internazionali attraverso storie che di respiro internazionale magari non sono, ma che il linguaggio del cinema non fatica a trasformare.
L’edizione 2023 di Cannes di candida ad essere una delle più ricche e variegate degli ultimi anni, a partire dalla presenza di volti noti, ingrediente irrinunciabile per ogni festival che si rispetti: probabile infatti la presenza di Johnny Depp, Julianne Moore, Robert De Niro, Leonardo DiCaprio, Martin Scorsese, Natalie Portman, Cate Blanchett e Jude Law, giusto per citarne alcuni. DiCaprio arriverà a braccetto di Martin Scorsese, con cui presenterà il loro film targato Apple (diretto da Scorsese e interpretato da DiCaprio) Killers of the Flower Moon. Anche Scorsese presenzierà all’anteprima, mentre ancora non sono sicure le presenze di altre star del cast, per esempio Robert De Niro, Lily Gladstone e Jesse Plemons.
Ispirato all’omonimo libro di David Grann, il film è ambientato negli anni ‘20 e racconta di una serie di crimini molto violenti che scoppiarono tra i nativi americani in Oklahoma, area ricca di petrolio. Sul caso indagherà un agente dell’FBI. Sembra che il Festival di Cannes abbia deciso di aprire le proprie porte ai blockbuster americani, dopo il pioniere dell’anno scorso, ossia Top Gun: Maverick Questa volta tocca a Indiana Jones e il quadrante del destino, quinto film della famosa saga che sarà presentato in anteprima mondiale il 18 maggio, diretto da James Mangold, alla seconda presenza a Cannes: «Nel 1995 è stato un onore per me venire a Cannes con il mio primo film all’interno della Quinzaine des Réalisateurs – ha dichiarato il regista ricordando il suo esordio in Francia con Dolly’s Restaurant – Ventotto anni dopo, sono orgoglioso di tornare con qualcosa di un po’ più spettacolare». Il quinto capitolo dell’epopea di Indy vedrà nel cast una vera e propria parata di stelle: oltre a Ford, ci sono Phoebe Waller-Bridge ( Fleabag ), Antonio Banderas, John Rhys-Davies ( I predatori dell’arca perduta ), Toby Jones ( Jurassic World – Il regno distrutto ) e Mads Mikkelsen ( Animali Fantastici – I segreti di Silente ).
In un’edizione che per la prima volta vede un Presidente di giuria (Ruben Ostlund) che nell’anno precedente si è aggiudicato la Palma d’oro (con Triangle of Sadness, bissando il successo di The Square nel 2017), il film di apertura sarà in costume: Jeanne du Barry (Fuori Concorso) di e con Maïwenn e con Johnny Depp.
Ambientato nella corte francese settecentesca, racconta come una ragazza della classe operaia sia riuscita astutamente a diventare la favorita di Re Luigi XV. Con le presenze annunciate tra gli altri di Michelle Yeoh, fresca di Oscar con il fenomenale Everything Everywhere All at Once, e di Almodóvar con il suo cortometraggio Strange Way of Life (protagonista Pedro Pascal), il Festival di Cannes porta avanti una rivoluzione lenta e inesorabile che lo apre al mondo oltre la dimensione pop, “facendo cinema”.
Three Italian films vie for the Palme d’or at the Cannes Film Festival this year: A Brighter Tomorrow by Nanni Moretti, La chimera by Alice Rohrwacher, and Kidnapped by Marco Bellocchio. Italy will also be represented, at least in good part, by the Festival’s godmother: Chiara Mastroianni. Mastroianni is one of the best examples of the embrace between French and Italian cinema, being the daughter of the immense Catherine Deneuve and Marcello Mastroianni.
A Brighter Tomorrow, screening as we speak in Italian theatres, has been widely received as a perfect example of its director’s style: it questions, it provokes, and it entertains Moretti’s fans and critics alike as the story comments the fall of big ideologies and on how the same can be therapeutic, almost providential. The other two films haven’t been publicly screened yet, still, their presence in Cannes seems almost natural, given Rohrwacher’s and Bellocchio’s ability to speak to international audiences with stories that may not be all that international, thanks to the magic of cinema.
Cannes 2023 promises to be one of the richest, most diverse editions of the last several years, starting with the presence of the brightest stars in the world of cinema: Johnny Depp, Julianne Moore, Robert De Niro, Natalie Portman, Cate Blanchett, Jude Law, Michelle Yeoh, Pedro Almodóvar, Leonardo DiCaprio, Martin Scorsese are all likely to attend. DiCaprio and Scorsese will present the upcoming Killers of the Flower Moon: inspired by David Grann’s book of the same name, the film is set in 1920s Oklahoma, and is the recount of a series of murders of Osage Native Americans after oil was discovered on their land. It seems Cannes opened their doors fully to American blockbuster, after last year’s sensation Top Gun: Maverick. This year, it will be the turn of Indiana Jones and the Dial of Destiny, the fifth film in the saga, which will premiere on May 18. Apart from Harrison Ford, the film will star Phoebe Waller-Bridge, Antonio Banderas, John Rhys-Davies, Toby Jones, and Mads Mikkelsen.
The opening movie, Jeanne du Barry (Maïwenn, Johnny Depp) is a costume drama set in eighteenth-century France. A girl of humble origins grow closer to King Louis XV, and becomes his favourite courtesan. What we are looking at is a Cannes Film Festival that, slowly but surely, revolutionizes itself into the world of pop.

È da poco uscito, edito da Minimum fax, un volume curato da Domenico Monetti e Luca Pallanch, con la collaborazione di Fabio Micolano, dal titolo Per soldi o per la gloria. Un lavoro accurato frutto di una ricerca capillare partita nel 2014 in cui, attraverso ventotto interviste a produttori italiani, viene ricostruita la storia del cinema dal Dopoguerra ad oggi e in fondo quindi, in qualche misura, la storia stessa del nostro Paese.
Troppo spesso il produttore viene cinicamente identificato come colui il quale si occupa della parte meramente economica del fare cinema, figura capace solo di contare i soldi. In questi interessanti ritratti ritroviamo invece molto di più: uomini complessi, che agiscono per forza di volontà, amore per il cinema, a volte anche solo per fortuiti scherzi del destino. Alcuni sono dei sognatori, altri si trovano coinvolti in questo mondo per necessità, ma tutti soggetti assolutamente fondamentali per la realizzazione delle opere cinematografiche.
Nel libro ritroviamo le vicende di grandi case di produzione come Lux e Titanus, racconti di produttori illuminati come, fra gli altri, Rizzoli e Cristaldi; si incontra Vittorio Cecchi Gori, ripercorrendo lo straordinario percorso, il grande successo della sua casa di produzione fino al tonfo economico causato dalle riprese de La voce della Luna, uno tra gli ultimi lavori di Federico Fellini con Roberto Benigni e Paolo Villaggio. Tantissime le testimonianze, dalla vedova di Infascelli, produttore del cult Febbre da cavallo, a Claudio Bonivento, da Fulvio Lucisano a Nicola Carraro, a Gianfranco Piccioli. Leggendo, veniamo catapultati nella storia del cinema italiano attraversando stagioni memorabili: il cinema colto, quello dei grandi registi che tutto il mondo ci invidia; riscopriamo l’epoca degli spaghetti western, dei poliziotteschi - su tutti il Tomas Milian nel ruolo de Er Monnezza ; e poi ancora il periodo delle commedie scollacciate con le innumerevoli docce di splendide dive del tempo come Gloria Giuda, Edwige Fenech, Barbara Bouchet. Si passa poi alla svolta negli anni ’80, dove la grande diffusione delle tv private mette in luce i nuovi comici televisivi protagonisti dei cinepanettoni, con successi enormi in termini di spettatori e di incassi, film ancora oggi amatissimi.
Domenico Monetti è un veneziano trasferito a Roma da molti anni. Lavora al Centro Sperimentale di Cinematografia - Cineteca Nazionale e per anni si è occupato della programmazione del Cinema Trevi, sempre a Roma. Insieme a Luca Pallanch ha curato retrospettive
alla Mostra del Cinema di Venezia ( La situazione comica. 1910-1988 ; Orizzonti. 1960-1978 ), alla Festa del Cinema di Roma ( Le notti pazze de La dolce vita ; Cinema espanso. 1962-1984; Danze macabre. Il cinema gotico italiano ) e al Torino Film Festival ( Omaggio a Giulio Questi ; Omaggio ad Augusto Tretti ; Omaggio ai fratelli Garriba ). Ha pubblicato inoltre diversi libri di cinema ( Luigi Comencini. Architetto dei sentimenti ; Tagli. Il cinema di Dario Argento; Non solo Gomorra. Tutto il cinema di Matteo Garrone ; Divi & antidivi. Il cinema di Paolo Sorrentino; Un «idolo» in controluce. Enzo Battaglia ; Se non ricordo male. Frammenti autobiografici di Giulio Questi ; Il caso Tretti ; Fabio e Mario Garriba, i gemelli terribili del cinema italiano ). Giornalista e critico cinematografico, ha collaborato con molte riviste tra cui «Segnocinema», «Cinecritica», «Blow up», «Bianco e nero».
Più volte con il collega Luca Pallanch abbiamo pensato di approfondire i cosiddetti “mestieri del cinema”, andando a conversare direttamente con i protagonisti del tempo.

Abbiamo scelto stavolta la categoria dei produttori, figure spesso bistrattate e trascurate anche da una certa critica cinematografica. In realtà il produttore, soprattutto quello da noi preso in esame, e cioè quello del Dopoguerra fino agli anni Ottanta, è una figura fondamentale della filiera cinematografica. Si potrebbe dire che senza il produttore, non senza il regista, non si fa il film.
Il libro propone una galleria interessante e completa di produttori italiani. Chi l’ha colpita di più tra quelli che ha conosciuto e incontrato?
Sono tanti i produttori che mi hanno colpito, anche perché gran parte delle interviste sono state realizzate fortunatamente “in presenza”
e quindi abbiamo potuto carpire un’espressione del viso, un tic, una particolare movenza. Mi hanno colpito sia il produttore o la produttrice indipendente che quello industriale. Non saprei davvero chi scegliere; per un motivo o per un altro mi hanno colpito tutti, soprattutto per la pienezza e la varietà delle loro vite e per questa passione viscerale che tutti hanno vissuto nel profondo chiamata cinema.
Come considera la crisi dei cinema italiani, sempre più vuoti, proprio mentre nelle case la fame di serie tv sembra non conoscere sazietà?
Il cinema non è più al centro del mondo e non solo qui da noi, purtroppo. La sala si è trasformata in una sede di eventi, in un museo, in una fabbrica di happening, con tutte le conseguenze del caso. Il cosiddetto cinema popolare è passato nelle piattaforme, nelle serie televisive, ma anche certi film autoriali sono oggi finanziati prevalentemente dalle stesse piattaforme (vedasi Netflix, Prime Video, ma anche MUBI). Il produttore ha cambiato volto e le piattaforme hanno certamente giocato un ruolo cruciale in questo stravolgimento epocale.
Questo volume inaugura Storia orale del cinema italiano, nuova collana di interviste della casa editrice Minimu Fax.

Ha già qualche nuovo progetto in cantiere?
Il prossimo progetto in cantiere è proprio un secondo volume sui produttori, che possiamo considerare già pronto. Con Minimum Fax si è deciso di dividere l’opera in due parti, proprio per la gran quantità di materiale che siamo riusciti a raccogliere.
Da veneziano, anzi lidense, è stato l’amore per il cinema a portarla a Roma? Cosa le manca di più di Venezia?
Assolutamente, è stata proprio la Mostra del Cinema di Venezia a portarmi a Roma. Negli anni Novanta ho lavorato come ufficio stampa e redattore dell’allora quotidiano del festival «Biennale News»; grazie a questo notevolissimo e fondamentale apprendistato sono finito a lavorare all’Anica prima e al Centro Sperimentale di Cinematografia poi. Di Venezia mi manca l’acqua, un certo silenzio, e il bacaro
Quali sono i tre film assolutamente imperdibili per lei?
Di sicuro Io la conoscevo bene, per capire chi e che cosa eravamo; Repulsion, perché il cinema è anche visione, follia, paura e desiderio; A Venezia un dicembre rosso shocking, perché mai il cinema ha ritratto una Venezia così vicina al vero e poi perché c’è quella che considero la mia scena d’amore preferita.
Ha collaborato con la Mostra del Cinema di Venezia e tuttora non ne perde un’edizione. Cosa rappresenta per lei?
Che atmosfera vi ritrova?
La Mostra del Cinema rappresenta il mio passato, il mio presente e il mio futuro. Il mio passato perché da ragazzino minorenne - e dunque, in quanto tale, impossibilitato ad accedervi - non mi perdevo d’animo e cercavo dei pertugi per avere delle visioni “clandestine” del proibito. Il presente perché ci torno adesso come lavoratore appassionato e ogni angolo della Mostra è un pretesto per un flashback. Tuttavia è anche l’occasione per rivedere la mia famiglia e i miei amici di un tempo. Il futuro, perché vorrei ritornarci da pensionato in buona salute per gustare con serenità dei vecchi e nuovi film. L’atmosfera che ritrovo è quella “dell’eternità in uno sguardo”, con una melanconia che si fa strada nell’istante successivo. Euforia e un pizzico di tristezza, perché anche la Mostra finisce e la si vorrebbe eterna...

Il produttore, soprattutto quello del Dopoguerra fino agli anni Ottanta, è una figura fondamentale della filiera
cinematografica. Si potrebbe dire che senza il produttore, non senza il regista, non si fa il film
«L’attesa del piacere è essa stessa piacere», recita una frase dello scrittore e filosofo tedesco Gotthold Ephraim Lessing diventata famosa e applicata a più livelli, che stavolta declineremo in chiave cinematografica.

Se l’attesa per l’ottantesima edizione della Mostra del Cinema è già a livelli più che discreti, di sicuro ingolositi dalle ultime edizioni di un happening planetario e ormai multidisciplinare, l’antipasto servito dalla Biennale in questo periodo dell’anno, vale a dire la designazione dei Presidenti di giuria e della madrina, altro non fa che stuzzicare ulteriormente i palati di addetti ai lavori e appassionati di cinema di ogni latitudine.
La consuetudine è stata pienamente rispettata: Damien Chazelle, Alice Diop, Jonas Carpignano e Caterina Murino si occuperanno rispettivamente del Concorso, della sezione dedicata alle opere prime, di Orizzonti e della conduzione delle serate di apertura e chiusura di un’edizione a cifra tonda che di sicuro metterà d’accordo tutti. Come sempre.
Damien Chazelle ha aperto con un suo film per ben due volte la Mostra Internazionale d’Arte Cinematografica, nel 2016 con La La Land e nel 2018 con First Man La La Land è stato uno dei fenomeni cinematografici planetari degli ultimi anni, ha ottenuto 14 nomination agli Oscar vincendone 6, incluso quello per il miglior regista, il più giovane di sempre a ricevere questo premio. First Man ha ottenuto 4 nomination agli Oscar, vincendone uno. La sua opera prima, Whiplash (2014), ha ricevuto 5 nomination vincendone 3, facendo vedere fin da subito di che pasta straordinaria Chazelle fosse fatto, confermata dal suo recente Babylon (2022), capace di ricevere 3 nomination agli ultimi Academy Award.

Col suo debutto nel lungometraggio di finzione, Saint Omer, Alice Diop ha vinto nel 2022 alla Mostra Internazionale d’Arte Cinematografica sia il Leone d’Argento, sia il Leone del Futuro, proprio nella sezione che la vede adesso come Presidente di giuria. Il film, candidato per la Francia agli Oscar, ha vinto in seguito numerosi riconoscimenti internazionali, fra i quali il premio César per la migliore opera prima.
Jonas Carpignano con il suo debutto A Ciambra (2017), premiato a Cannes, è stato selezionato per rappresentare l’Italia agli Oscar. Nel 2021 A Chiara ottiene sei nomination ai David e vince il premio per la migliore attrice protagonista. A Caterina Murino, infine, toccano gli onori di casa di un’edizione a cifra tonda, perfetto equilibrio di qualità e quantità. Come sempre. Davide Carbone
«L’arte ha una sua responsabilità per contribuire a una presa di coscienza individuale». In questa affermazione, resa da Francesco “Citto” Maselli due anni fa all’Omaggio di Biennale per i novant’anni del regista, si può trovare forse la sintesi più compiuta del suo cinema. Non poteva essere diversamente, in una vita precoce in tutto, nel cinema come nella politica. Diventa partigiano a 13 anni nella Roma occupata dai nazifascisti; porta pistole di ricambio ai resistenti combattenti o partecipa al volantinaggio per lo sciopero generale cittadino del 10 marzo ‘44. Inevitabile, quindi, la sua adesione al PCI, quando di anni ne ha appena 14. Ma la sua formazione intellettuale comincia ancora prima, in famiglia, a partire da quello zio di peso, Luigi Pirandello, che gli darà il nomignolo “Citto”, mai più abbandonato. Nel 1947 viene ammesso al Centro Sperimentale di Cinematografia, dove si diploma due anni dopo e comincia la carriera come aiuto-regista di Michelangelo Antonioni, Luigi Chiarini e Luchino Visconti. La sua forte inclinazione al documentario viene notata da Cesare Zavattini, in pieno Neorealismo: Citto lo assiste per l’episodio Storia di Caterina nel film collettivo L’amore in città
Ma l’esordio vero e proprio di Maselli regista avviene nel 1955 con Gli sbandati, presentato alla Mostra del Cinema di Venezia dove ottiene una menzione speciale, e primo appuntamento della rassegna che Circuito Cinema gli tributa fino al 6 giugno.
Tema che ritornerà anche nel successivo I delfini, giovani e oziosi eredi della borghesia industriale di provincia dei primi anni Sessanta, che passano le lunghe giornate indulgendo in noiosi divertimenti. Maselli porta avanti, da sinistra, la sua critica di una certa Italia decadente e senza ideali, votata a una opulenta e borghese sopravvivenza.
Moravia collaborò alla sceneggiatura, tirando così un ideale filo rosso con il successivo Gli indifferenti, tratto direttamente dal suo omonimo romanzo. Maselli cambia profondamente storia e personaggi, spostando il focus dalla critica della dittatura fascista – come gli sarebbe stato rimproverato all’epoca – a un’osservazione carica di biasimo di una società fondata sul valore capitale del denaro, che investe anche le passioni e i sentimenti. Costruendo così una sorta di trilogia dell’esistenza, dove appunto l’arte può servire da presa di coscienza e assumere forma di impegno politico, come è stata tutta la vita di Francesco “Citto” Maselli. Matteo Polo
cinema come impegno politico 16, 23, 30 maggio; 6 giugno Casa del Cinema www.comune.venezia.it


In Italia la libertà di stampa ha subìto molte limitazioni e minacce nel corso degli anni. È del 1976 la Legge sulla stampa che ha introdotto una serie di limitazioni alla libertà della stessa, tra cui la possibilità per i magistrati di sequestrare i giornali che diffondono notizie false o lesive della reputazione di una persona. Inoltre, nel corso degli anni, molti giornalisti sono stati minacciati, aggrediti o uccisi a causa delle loro attività investigative: Beppe Alfano, Peppino Impastato, Mauro Rostagno, Walter Tobagi, Enzo Baldoni sono i nomi delle vittime più conosciute. Per proteggere la libertà di stampa sono utili la creazione di organi di controllo indipendenti, la promozione di una cultura dell’apertura e della trasparenza e la protezione dei giornalisti dalle minacce e dalle aggressioni, con i cronisti stessi che devono lavorare per fornire notizie accurate e oggettive, evitando di essere influenzati dai numerosi interessi collidenti con la verità. In occasione della giornata internazionale della libertà di stampa celebrata il 3 maggio la Casa del Cinema organizza una rassegna cinematografica sulla libertà di stampa: Chiamate Nord 777 di Henry Hathaway, Prima pagina di Billy Wilder, Il caso Spotlight di Thomas McCarthy e Sbatti il mostro in prima pagina di Bellocchio si concentrano sul rapporto difficile tra stampa e potere, senza risparmiare critiche al mestiere del giornalista quando dal potere cerca legittimazione e tornaconti.
Anche in questo breve percorso cinematografico è evidente come, attraverso una stampa libera e indipendente, i cittadini possano avere accesso a tutte le informazioni di cui hanno bisogno per prendere decisioni consapevoli sulla propria esistenza e partecipare attivamente alla vita democratica del loro Paese. Paolo Dalla Mora

Sbatti la verità in prima pagina 18, 25 maggio; 1, 8 giugno Videoteca Pasinetti www.comune.venezia.it
Reduce da un felicissimo Far East Festival di fine Aprile a Udine mi interrogo: è possibile fare film di propaganda, con chiaro intento celebrativo per il regime in vigore con sceneggiatura, regia, capacità attoriali di altissimo livello? Già la classifica di incassi 2022 ha visto al top in Cina il film The battle at Lake Changjin II: Water Gate Bridge dei registi Chen Kaige, Tsui Hark e Dante Lam. Racconta dell’eroismo di un gruppo di soldati cinesi, che devono demolire un ponte per impedire l’avanzata di truppe americane durante la guerra di Corea nel 1953. Interessante anche Home coming, di Rao Xiaozhi, presentato in prima italiana a Udine. Due funzionari cinesi devono organizzare la difficile e pericolosa evacuazione dei connazionali da un Paese d’Africa dilaniato da una guerra civile, in realtà tratto da fatti reali avvenuti in Libia nel 2011. A testimonianza, direi, dell’interesse con cui la Cina sta guardando al continente africano. Ora vedo Hidden Blade, titolo italiano, ammesso che entri in distribuzione nazionale, non ancora definito. Il regista è Cheng Er. Di lui da ricordare l’emozionante e ben costruito Lethal Hostage del 2012, ove polizia e una potente banda di spacciatori di droga si impegnano in una battaglia senza quartiere, ma dove buoni e cattivi si intrecciano ovunque. È molto noto in Cina per le sue serie televisive ed anche per curare spesso direttamente sceneggiatura e montaggio delle sue produzioni. Anche Hidden Blade è un noir, che vede come nucleo del racconto una sezione speciale del Partito Comunista Cinese infiltrarsi fra il governo fantoccio cinese, le agenzie di controspionaggio giapponese e il Partito nazionalista. I colpi di scena si susseguono l’un l’altro, tali da rendere non funzionante la distinzione di Hitchcock tra ‘suspence’ e ‘surprise’. Vi è un uso molto intenso di flashback e flashforward e lo spettatore è spesso disorientato nel seguire la vicenda, ci si smarrisce anche per la velocità delle scene e per le doppie, talvolta triple identità dei personaggi, che si svelano freneticamente nello scorrere della pellicola. Il pubblico cinese avrà un problema in più, perché i dialoghi sono talvolta in mandarino, talvolta in cantonese o in dialetto di Shanghai. Ma il film è di una altissima sofisticata eleganza formale, l’intreccio avvincente e credibile, la fotografia da Oscar (se fossimo imparziali), una colonna sonora potente e che ben affianca e potenzia le immagini e sopratutto interpretazioni straordinarie, da Tony Leung Chiu-Wai all’interessante Wang Yibo, molto conosciuto in Cina per le sue attività eclettiche, da attore a pilota, da cantante a rapper.
Con una punta di malizia noto anche la rimessa in circolazione di Hong Kong 1941 del regista Po-Chih Leong, film del 1984 dove le forze inglesi sono messe in assai cattiva luce, pronte ad illudere e poi abbandonare la città ai cattivi e crudeli giapponesi invasori. A distanza di quaranta anni i luoghi comuni e gli stereotipi sono marcati, ma lo spettacolo risulta comunque apprezzabile, in particolare per la recitazione di Chow Yun-fat, capace di utilizzare diversi registri espressivi tra loro molto contrastanti. In tema di nazionalismo anche Phantom diretto da Lee Hae-young, altro regista molto presente a Udine. Stavolta però è la Corea del Sud che se la prende con il Giappone nell’invasione del 1933. Il capo della sicurezza giapponese raduna cinque potenziali sospetti di un attentato al governatore in un castello sul mare, intenzionato a scoprire chi tra loro è il Fantasma, nome in codice di un capo della resistenza. Ovvio il pensiero ad Agatha Christie. La tensione cresce e i colpi di scena si susseguono. Stupenda la recitazione, in particolare delle due interpreti femminili, Lee Ha-nee, Miss Corea e prolifica attrice e Park So-dam, che tutti noi ricordiamo come figlia del cattivo capofamiglia Kim Ki-taek nel capolavoro Parasite Loris Casadei

Ho realizzato questo progetto esattamente come se fosse un’opera d’arte: con passione, amore e divertimento, e in segno di riconoscenza verso la mia città che mi ha dato tanto

PAFF! Nome perfetto per un museo dedicato al fumetto, sembra uscito direttamente da una striscia illustrata. PAFF!, suono onomatopeico, sordo e al tempo stesso piacevole; subito immaginiamo di vedere un oggetto cadere tra le pagine del Corriere dei Piccoli o magari tra quelle di un vecchio Topolino, letto dopo la scuola.
Il PAFF!, International Museum of Comic Art, è un’importante istituzione culturale che promuove la divulgazione dell’arte e della scienza attraverso lo strumento facilitatore del fumetto, fondato nel 2018 da Giulio De Vita, attuale Presidente e Direttore Artistico. Pordenonese, classe ‘71, inizia a 16 anni come disegnatore pubblicitario, esordendo nel fumetto con Lazarus Ledd ( Star Comics, 1993) e con le copertine di supereroi per Marvel Italia. Da lì la sua carriera prende il volo, incrociando i mondi della musica, dell’animazione, del cinema, acquisendo grande fama in Francia, arrivando infine al PAFF!.

Villa Galvani, all’interno dell’omonimo parco pubblico nel cuore di Pordenone, è la sede di questo museo dell’illustrazione: la struttura originaria ottocentesca rimane evidente all’esterno, mentre all’interno l’edificio è stato radicalmente restaurato e trasformato in un composito spazio espositivo di circa 2000 mq, che ingloba anche l’ex Galleria d’Arte Moderna, con un’area accoglienza comprensiva di biglietteria, bookshop, caffetteria, guardaroba, spazi espositivi temporanei e permanenti, sala didattica, auditorium da 90 posti che si trasforma anche in cinema, il tutto fruibile in un percorso articolato e continuo che passa dal nucleo museale alle mostre capace di regalare nel suo insieme al pubblico un’esperienza attiva ed esperienziale di straordinaria suggestione.
Sostenuto dalla Regione Friuli Venezia Giulia e dal Comune di Pordenone, con il Patrocinio del Ministero della Cultura e la mediapartnership della Rai, dallo scorso marzo è diventato Museo Internazionale del Fumetto, il primo in Italia. Una realtà che nel nostro Paese mancava e che ora si affianca ad altre già affermatissime da decenni in Europa, vedi i Musei di Parigi e Bruxelles. Un riconoscimento importante per un’idea che è cresciuta e si è sviluppata in breve tempo.
L’esposizione permanente, a cura di Luca Raffaelli, storico del fumetto e giornalista, è dedicata alla storia del fumetto e vede esposte opere di grandissimi autori come Carl Barks, Milton Caniff, Giorgio Cavazzano, Will Eisner, Floyd Gottfredson, Chester Gould, Benito Jacovitti, Magnus, Milo Manara, George McManus, Andrea Pazienza, Hugo Pratt, Alex Raymond, Charles M. Schulz, Art Spiegelman. Il percorso museale, suddivisa in 20 sezioni strutturate attraverso la chiave di lettura dei formati – dalle pagine domenicali di fine ‘800 ai formati più popolari che si sono sviluppati negli anni e nelle culture del mondo, come il manga, il comic book, la bande dessinée fino al graphic novel –, si snoda in un coinvolgente percorso multimediale e interattivo che riesce ad attrarre gli esperti del settore così come emozionalmente l’attenzione di coloro che si affacciano per la prima volta a questo mondo. La proposta è vastissima: sono esposti circa 200 tavole originali e 1500 tra schizzi, pubblicazioni, sceneggiature, scenografie e filmati da tutto il mondo e persino oggetti e costumi di scena provenienti da film tratti da fumetti. Il Museo promuove anche esposizioni temporanee – come
quella straordinaria che apre il 12 maggio, Shaun the Sheep & Friends. The Art of Aardman Exhibition (vedi box p. 167) –, incontri, laboratori didattici, corsi di formazione, eventi e conferenze; a breve verrà anche arricchito da una bibliomediateca ed entro fine anno si doterà di un archivio con deposito climatizzato. Sono ospitate anche una scultura di Ivan Tranquilli e un’opera di Davide Toffolo realizzate appositamente per il PAFF!.
Prima di tutto ci dica che cosa rappresenta per lei il PAFF! Il PAFF! è per me la realizzazione di una vita di contatti e relazioni professionali stabiliti in oltre 35 anni di carriera, 20 dei quali spesi all’estero. Ma è anche il mantenimento di una promessa fatta a un amico che non c’è più, Salvatore Oliva. Con lui per tanti anni abbiamo immaginato un luogo che potesse valorizzare l’arte del fumetto, la sua influenza nella cultura contemporanea e il suo potenziale divulgativo. Il PAFF! rappresenta il punto d’incontro di competenze ed esperienze fatte in vari campi della creatività: fumetto, pubblicità, videomaking, grafica, design. Ho realizzato questo progetto esattamente come se fosse un’opera d’arte: con passione, amore e divertimento e in segno di riconoscenza verso la mia città che mi ha dato tanto. Coinvolgendo in questo progetto anche tanti concittadini con la mia stessa passione ho voluto mettere a disposizione le mie competenze per arricchire Pordenone di un luogo di altissimo profilo che incarnasse lo spirito della nostra gente: creativa, laboriosa, seria e simpatica.
A chi consiglierebbe di visitare il vostro Museo e perché? Il PAFF! nasce con l’intento di essere un gancio culturale capace di avvicinare pubblici diversi, per questo la sua proposta è multilivello. Lo consiglierei agli insegnanti, perché offre un’infinità di spunti di approfondimento didattico per quanto riguarda le lingue, la storia, la geografia, l’arte, le scienze; alle famiglie, per trascorrere del tempo libero divertendosi ma rimanendo a stretto contatto con la cultura; agli appassionati di arte in generale, per l’originalità della proposta e la sua imprevedibile trasversalità; agli appassionati di fumetto naturalmente, per la preziosità degli originali esposti; agli artisti e agli operatori culturali di qualsiasi settore, perché è un luogo di ispirazione e ritrovo.
C’è un’opera esposta di cui va particolarmente fiero?
Difficile limitarsi a una sola, perché ognuna delle 20 sezioni del museo presenta una tavola da far tremare i polsi: da Charlie Brown a l’Eternauta, da Persepolis a Maus, da Spirit a Dick Tracy, fino alle tavole di Pratt e Pazienza.
Che personaggio dei fumetti vorrebbe essere e chi era il suo personaggio preferito da bambino?
Non nascondo la mia enorme passione per Moebius, di cui abbiamo anche ospitato un’indimenticabile mostra. Vorrei essere Arzach che viaggia in mondi fantastici.


Le vendite di fumetti sono decisamente in aumento. I libri illustrati, soprattutto grazie ai manga, hanno registrato un vero e proprio boom. Che futuro vede per il settore?
La tesi che ho portato avanti nel concepire il PAFF! e la sua mostra permanente appena inaugurata è che la necessità di narrare per immagini è innata nello spirito dell’uomo. Una necessità che ha origine prima della nascita del fumetto, prima dell’invenzione della stampa e prima ancora dell’invenzione della carta e della stessa scrittura. Abbiamo voluto rappresentare chiaramente questo concetto tramite una parete magistralmente illustrata dal fumettista Davide Toffolo, ospitata nella sezione numero Zero del Museo intitolata Il Prefumetto. Sono convinto che questo bisogno esisterà finché ci sarà l’uomo, qualunque sia il futuro dell’editoria, sia esso su supporto cartaceo o digitale. Quanto al fumetto in senso stretto, cioè inteso come prodotto editoriale, penso che nel futuro diventerà sempre più un prodotto di lusso, i cui contenuti si declineranno sempre di più in media e supporti diversi e integrati come cinema, games, e-book, merchandising...
Dal disegno che vede nascere i personaggi sui taccuini, alla sperimentazione delle possibili sfumature di figure e ambienti, al lavoro di scrittura che coniuga narrazione e raffigurazione, alla scultura dei personaggi e la costruzione delle scenografie: dal 12 maggio al 24 settembre gli spazi del PAFF!, grazie a un originale impianto scenografico prodotto dal museo, diventano la casa di Wallace & Gromit, dei mitici animali della Fattoria Mossy Bottom di Shaun, vita da pecora, delle simpatiche pennute di Galline in fuga e della squinternata ciurma di Pirati – Briganti da strapazzo
The Art of Aardman Exhibition, Shaun the Sheep & Friends, curata dal PAFF! e dall’Art Ludique-Le Musée di Parigi, dopo i successi di Parigi, Francoforte, Melbourne e Seoul arriva a Pordenone per offrire ai visitatori un viaggio nell’universo creativo di Peter Lord e David Sproxton, menti e anime degli Aardman Studios, che tra nomination e statuette hanno calcato il palco dell’Academy per ben quattro volte. Un percorso espositivo spettacolare che ripercorre la storia di Peter e David dai loro lontani inizi nel 1966, quando a dodici anni creano per gioco il loro primo cartone animato, che venderanno per 15 sterline alla BBC, fino ad alcuni dei loro più iconici film in stop motion, in un viaggio che descrive tutto lo straordinario processo di realizzazione cinematografica che caratterizza i loro più riusciti lavori. Un omaggio al genio artistico di autori che, immagine per immagine, hanno dato vita a sculture in plastilina che hanno incantato – e continuano ad incantare –milioni di appassionati di ogni età in tutto il mondo.


In mostra gli arnesi scoppiettanti di Wallace, l’orto di Gromit, i set del film di Shaun the Sheep, la macchina volante di Galline in fuga, il favoloso galeone di Pirati lungo 5 metri, insieme a più di 400 disegni, studi sui personaggi e, sullo sfondo, acquerelli, storyboard e l’album da disegno di Nick Park da studente, che contiene i primi disegni di Wallace & Gromit. E poi ancora incredibili contenuti visibili dal vivo per la prima volta e solo per il PAFF!, come alcune parti tratte dallo speciale musical delle feste Un pettirosso di nome Patty (2021), nominato agli Oscar e ai BAFTA, di cui è possibile vedere alcuni disegni e il pupazzo originale, o l’anteprima nazionale della nuovissima serie CGI dello studio Lloyd of the Flies (2022) e dello spettacolo in stop motion per bambini nominato ai BAFTA, The Very Small Creatures (2021), mai distribuiti in Italia. Lo stile Aardman, definito soprattutto per l’attenzione verso alcuni temi come il paesaggio britannico e la natura, le macchine – a volte ingegnose e irrazionali –, le ambientazioni architettoniche dai dettagli fantasiosi, si rivela nel virtuosismo della realizzazione di prototipi, nella grande manualità e nel puro piacere dell’invenzione, tratti condivisi da pupazzi e creativi, entrambi spesso impegnati a costruire con le proprie mani le invenzioni più imprevedibili.


Nessuno è più esperto di Alberto Toso Fei in leggende veneziane, storie popolari, racconti misteriosi, aneddoti che seducono e stupiscono. Lo scrittore è una sorta di macchina del tempo vivente che di Venezia ha esplorato ogni angolo, ha raccontato ogni segreto, intrigo, memoria, ha preso in esame persino tutti i graffiti disseminati sui muri per tracciarne una mappa, una nuova storia della città.
È decisamente un narratore atipico; studioso documentatissimo, si muove tra storie antiche utilizzando però le più sofisticate e moderne tecnologie. Ha dato vita a una innovativa narrazione di Venezia attraverso le sue performance, che ha declinato in molteplici forme: storytelling, recital, conferenze, Tedx, incontri streaming e progetti digital; dalla sua creatività sono nati spettacoli teatrali, installazioni, cacce al tesoro, avvincenti “ghost tour”. Sul web è seguitissimo, tantissimi si sono appassionati agli episodi del suo storytelling in streaming, Venezia in un minuto, Decamerone veneziano, Viaggio nel teatro veneziano.
Toso Fei si può definire l’autentico cantastorie di Venezia, attentissimo al recupero della tradizione orale per sventare il pericolo che tante storie possano andare perdute.
Dal 2 maggio è in libreria con il suo nuovo lavoro dal titolo Il piede destro di Byron, pubblicato da Marsilio nella collana Lucciole
Il debutto è stato festeggiato il 4 maggio al Teatrino di Palazzo Grassi a Venezia, dove le voci del protagonista e del suo alter ego femminile sono state interpretate dagli attori Andrea Pennacchi e Ottavia Piccolo. Il volume verrà poi presentato a Bologna, Roma, Milano, Genova con la complicità di illustri ‘colleghi’ come Lucarelli, De Cataldo, Colaprico e Morchio.
In questo romanzo noir debutta un nuovo personaggio, il giornalista veneziano Alessandro Nicoli, figura un po’ goffa ma ricca di curiosità e di talento che ben presto si trasforma in un investigatore dalle grandi intuizioni. Durante una gita in barca vicino all’isola di San Giacomo in Paludo trova un’antica moneta d’oro; da qui viene travolto da un’indagine su due omicidi che sembrano non collegati tra di loro. Il giornalista arriva a districare la complicata trama di misteri superando una teoria di ostacoli, di criticità, incontrando personaggi strani, come un frate esorcista che forse ha inventato un marchingegno in grado di superare le barriere del tempo. Sullo sfondo c’è sempre Venezia alle prese con i problemi del presente, come il turismo di massa o le grandi navi e l’acqua alta, ma che inevitabilmente spinge il lettore verso la dimensione del sogno, del fantastico, sempre immersa com’è in leggende, segreti, enigmi.

In tutta la storia aleggia l’ombra di Byron, uno dei più noti poeti ingle -
si, dandy raffinatissimo dalle numerose avventure sentimentali che fece scandalo in tutta Europa e che viaggiò molto, soggiornò spesso in Italia e a lungo proprio a Venezia. Il poeta fu trovato nella tomba col piede destro misteriosamente tagliato. Incontriamo Alberto Toso Fei per saperne di più di questa nuova, intrigante pubblicazione.
Come è nato il nuovo personaggio di Alessandro Nicoli giornalista-investigatore?
È un investigatore per caso che non è nato per caso, perché se il personaggio si imbatte nelle sue investigazioni senza andarle veramente a cercare, la sua origine nasce invece da lontano; è come se mi avesse accompagnato nelle mie varie ricerche negli ultimi anni facendosi progressivamente strada dentro di me, finendo per suggerirmi di dedicarmi anche alla fiction. Nicoli agisce in una Venezia assolutamente contemporanea e reale, ma muove i suoi passi in vicende misteriose che nel loro sortire da una base di verità si inoltrano poi nel terreno del fantastico e dell’imprevedibile. Mi piaceva l’idea di inventare storie, dopo le mille raccolte e riprese dalla tradizione. Così mi sono infine deciso.
Per questa nuova avventura si è affidato a Marsilio, grande casa editrice veneziana. Avete già in precedenza lavorato insieme? Che ricordo ha di Cesare De Michelis?
Per Marsilio sono in libreria da anni col Ruyi, una caccia al tesoro multimediale che prevede l’utilizzo dello smartphone per poter leggere le pagine di un libro, sciogliendo uno alla volta gli enigmi disseminati in città. Marsilio rappresenta l’editoria veneziana in Italia e nel mondo: è una grandissima e meravigliosa famiglia nella quale mi trovo a mio agio in ogni momento. Un luogo dove si può anche parlare veneziano ed essere compresi, come fa Nicoli nelle sue avventure. Con Cesare De Michelis non ho avuto lunghe frequentazioni. Fummo però assieme sul podio di Mondadori per una serata su Venezia: era un’intellettuale e un imprenditore culturale lucido,
generoso e attento ai bisogni della città, alla quale ha lasciato una eredità importante raccolta nel migliore dei modi da chi ha preso in mano le redini della casa editrice oggi.
Nell’incredibile galleria di personaggi, veri o leggendari che siano, che popolano la sua rubrica sul Gazzettino dove racconta le biografie di cortigiane, soldati, dogi, politici, letterati, artisti, poetesse, quale tra tutti è quello che preferisce, quello a cui è più legato?
Non ve n’è uno solo e non potrebbe essere altrimenti: Venezia è una città che sulla collettività e la partecipazione ha costruito le sue fortune. Possiamo ricordare alcuni dogi, fra i molti che nei secoli si sono susseguiti alla guida della Serenissima, anche se non possiamo prescindere dal fatto che tutti indistintamente vennero eletti, quindi chiamati per mandato a rappresentare una comunità e non loro stessi. Posso dire che mi colpiscono in particolar modo le figure femminili: Venezia ha dato loro nel corso dei secoli delle opportunità impensabili altrove e loro se le sono prese alla grande, senza chiedere il permesso a nessuno, dando vita a una serie di primati dei quali andare fieri ogni giorno. In un mondo nel quale le vicende del passato si raccontano con un segno espressamente maschile, Venezia porta invece chiaramente evidenti le loro tracce, il loro inconfondibile esempio.
Lei riesce sempre a trasmettere il suo amore, la sua passione per questa città, ma è innegabile che Venezia viva oggi una grave e grande crisi identitaria, sempre più spopolata e al contempo affollata fino all’asfissia da masse di turisti sempre più ingenti. Cosa si potrebbe concretamente fare a suo avviso per migliorare la qualità della vita dei veneziani?
Le ricette sono sempre quelle e valgono per ogni luogo: lavoro (non necessariamente legato al turismo), residenza, servizi. A Venezia si aggiunge la disciplina di un turismo che da tempo è sempre più fuori controllo. Come trovare delle soluzioni adeguate per affrontare

queste complesse criticità è naturalmente oggetto del lavoro degli amministratori e mi rendo conto che mediare fra interessi fortissimi contrapposti non sia azione così facile. Eppure è cosa da farsi pena la scomparsa della città, se con questo termine vogliamo ancora intendere un luogo abitato da una comunità attiva e composita.
Ciò detto, resta ad ogni modo il fatto che la qualità della vita in città rimane a mio avviso molto alta: non è che altrove i problemi non esistano, solo che non hanno Venezia intorno. Non è poco.
Come valuta l’immagine di Venezia che si ha in particolar modo all’estero, nel mondo?
Qualsiasi cosa venga vissuta in questa città ne esce sempre amplificata, nel bene e nel male. In molte occasioni Venezia non viene compresa fino in fondo, ma è abbastanza normale per chi non la abita. Ciò che rimane indubitabilmente inalterato è il fascino dal quale è ammantata, che vince su tutto. Da secoli arrivano moltitudini da ogni angolo del mondo per lasciarsi stupire; e lo stupore, in fondo, può prescindere anche dalla conoscenza. Alla fine dei giochi, comunque, a dare una buona o una cattiva immagine della città siamo noi veneziani, nessun altro. Una responsabilità che non sempre viene capita e quindi ben assunta.
Lei utilizza molto le tecnologie: non la preoccupa l’evoluzione del formato libro sempre più lanciato verso una dimensione immateriale? Insomma, alla fine si salverà il libro stampato?
Certo che si salverà. Il libro di carta rimarrà sempre imprescindibile. Ogni volta che sembra vecchio e superato, basta che si scarichi la batteria di un qualsiasi dispositivo per ricordarci che le storie più belle ci aspettano pazientemente sugli scaffali di casa.
Vede già all’orizzonte altre possibili avventure per il suo Alessandro Nicoli?
Almeno una per ogni possibile mistero veneziano… Quindi sì, direi proprio di sì. Ma per il momento godiamoci questa.

Il libro di carta rimarrà sempre imprescindibile. Ogni volta che sembra vecchio e superato, basta che si scarichi la batteria di un qualsiasi dispositivo per ricordarci che le storie più belle ci aspettano pazientemente sugli scaffali di casa
Intervista Roberto Nardi di Elisabetta Gardin

Una vicenda reale, oscura e mai risolta con protagonista un piccolo dipinto custodito per oltre cinque secoli in una chiesa a Venezia e scomparso una notte di 30 anni fa. Una storia non di fantasia, una ferita ancora aperta ora affrontata dal nuovo libro di Roberto Nardi Perché io? Il mistero del furto della Madonna con Bambino di Bellini a Venezia, edito da Mazzanti Libri Meta Liber, che inaugura la Collana «Cornici» (curata dallo stesso autore). Il furto, per certi versi anomalo, è avvenuto nella notte del primo marzo 1993 nella Chiesa della Madonna dell’Orto a Cannaregio. I ladri trafugarono un quadro amatissimo dai veneziani, la Madonna con Bambino di Giovanni Bellini. La tavola, 75x50 cm., dipinta tra il 1470 e il 1480, era posta sopra l’altare nella cappella Valier. Da quel momento dell’opera si è persa ogni traccia, sparita. Nardi, appassionato d’arte ma soprattutto giornalista, per molti anni responsabile dell’Ansa per il Veneto, in questo suo nuovo lavoro vaglia più ipotesi, tra cui un possibile furto su commissione o la possibilità che il quadro sia andato distrutto forse accidentalmente.
Nel ricostruire la vicenda, che suscitò grande clamore in città, riporta le “voci” dei protagonisti del tempo, come per esempio Padre Agostino Cornale, parroco alla Madonna dell’Orto, ma questo è solo il punto di partenza. L’autore, infatti, allarga il campo e prende in esame i traffici illeciti che inquinano anche il mondo dell’arte, indagando il ruolo che in questa vicenda potrebbe aver svolto la criminalità organizzata, in particolare la mala del Brenta capeggiata da Felice Maniero, che utilizzava le opere d’arte rubate come merce di scambio per cercare di ottenere favori.
Il Perché io? del titolo richiama il volto di Gesù Bambino riportato nella copertina, raffigurato con sguardo interrogativo, quasi spaventato, la bocca aperta e la mano sinistra sul petto come a interrogare e a interrogarsi.
L’autore poi amplia il suo orizzonte affrontando anche in una prospettiva storica i saccheggi d’arte, da quelli compiuti da Napoleone alle razzie operate dai nazisti, concentrando la sua attenzione sui temi delicatissimi della tutela, della sicurezza e della cura delle opere d’arte custodite nei luoghi sacri della città.
Incontriamo Roberto Nardi per saperne di più della sua indagine.
Da dove nasce l’esigenza di scrivere questo libro?
Da un interesse personale verso un caso d’arte non risolto e da un’urgenza legata al fatto che sul furto di un capolavoro di uno dei massimi artisti veneziani, Giovanni Bellini, da tempo grava il silenzio. Un silenzio assordante. Sono passati 30 anni da quella notte del primo marzo e ho pensato che era tempo per dare un contributo, un piccolo contributo, a mantenere accesa la fiamma del ricordo su una ferita ancora aperta nel corpo culturale e sociale della città. Nasce certo anche da un impeto di speranza riguardo alla possibilità che l’opera possa tornare a colmare quella cornice lignea che i ladri hanno lasciato vuota e che è ancora lì sopra l’altare.
Contestualmente al furto del Bellini, da attento cronista descrive nel libro un intero periodo molto oscuro per Venezia, vessata da furti clamorosi e spettacolari, con la mala del Brenta a farla da padrona nel primo ruolo di protagonista di quella inquietante scena.
Nel libro ricordo varie storie, anche spettacolari nel modo in cui si sono svolte. Penso al furto di una tavola della Scuola dei Vivarini a Palazzo Ducale o alla rapina delle spoglie di Santa Lucia dalla chiesa di San Geremia. Tra i vari furti commessi in quegli anni una delle vicende che più mi ha colpito non ebbe però a che fare con la criminalità organizzata, perché si trattò di una tragica storia “semplice”. Mi riferisco a quel giovane con problemi di droga che rubò una grande tela del Tiepolo dalla Chiesa di San Stae, nel giugno 1990. Si suicidò quattro giorni dopo il recupero dell’opera da parte della Polizia di Stato.
Furono quindi molti e vari i protagonisti in campo come si vede. Ciò che mi ha fatto pensare che la sottrazione del Bellini fosse un caso anomalo è il fatto che tutti i dipinti e le reliquie di altissimo valore rubati in quegli anni sono stati presto restituiti, o per meglio dire recuperati. La Madonna con Bambino no.
Esiste ancora un reale pericolo per le opere d’arte conservate nelle chiese veneziane?
In linea teorica non esiste la sicurezza assoluta. Non ci sarebbe neanche se tutti i dipinti fossero chiusi in un unico edificio super protetto. C’è
da dire che rispetto a 30 anni fa molto si è fatto sul fronte della tutela e della messa in sicurezza anche delle chiese. All’epoca i parroci mediamente dovevano affidarsi al deterrente del portone chiuso. Poca cosa, come si è visto. Adesso c’è la video-sorveglianza diffusa in città, vi è un rapporto più attivo tra le varie realtà interessate, più controlli. Molto altro resta ancora da fare naturalmente.
La tutela e la salvaguardia dei beni artistici, anche ecclesiastici, è un processo in evoluzione, come in costante crescita, a mio avviso, dovrebbe essere nell’opinione pubblica la presa di coscienza che un’opera d’arte appartiene idealmente a tutti. È parte integrante dell’essere comunità. Bisogna averne cura. La sottrazione di un capolavoro non è solo un danno economico e culturale, è un qualcosa che incide negativamente sulla memoria e sull’identità collettive.
Il libro inaugura una nuova collana editoriale, «Cornici», voluta da Mazzanti Libri e che lei dirigerà. Ci descriva un po’ la linea editoriale che intende seguire.
È un progetto, uno spazio che intende offrire nuove opportunità a quei rami della ricerca che incrociano la cronaca, il quotidiano direi, con i più diversi campi della cultura, non unicamente legati alle arti visive. È un campo d’azione senza reali confini. Anche se il primo volume è dedicato all’incontro tra cronaca nera e storia dell’arte, sarà una collana che si svilupperà senza fretta e che ospiterà storie di persone, fatti e accadimenti sotto angolature inaspettate.
Torniamo al capolavoro di Bellini: lei nutre davvero ancora qualche speranza che possa essere ritrovato o quella cornice dorata alla Madonna dell’Orto rimarrà vuota per sempre?
La speranza è la chiave di lettura di tutto il mio lavoro attorno al furto della Madonna con Bambino. I lettori troveranno nel libro voci che vanno verso altre direzioni, che parlano di un’opera irrimediabilmente perduta. Più umilmente preferisco dare rilievo ad altri elementi che mi conducono a supporre possibilità diverse. Faccio mia, in sostanza, la speranza che don Ferruccio, parroco della Madonna dell’Orto recentemente scomparso, mi ha confidato nel corso di una conversazione: rivedere il dipinto di Bellini di nuovo nella sua cornice posta sopra l’altare della Cappella Valier.


La sottrazione di un capolavoro non è solo un danno “economico” e “artistico”, è un qualcosa che incide negativamente sulla memoria e identità collettiva
Proiezione del documentario della regista svizzero-albanese Dea Gjinovci, intervistata dall’antropologa Claudia Antonangeli. Un ritratto di famiglia di rifugiati rom kosovari in attesa di regolarizzazione in Svezia, alle prese con una strana malattia che ha colpito le due figlie adolescenti divenute, come in un sonno senza sogni, incapaci di muoversi, bere, mangiare, bisognose di totale assistenza. Racconto poetico e senza sconti, storia di un destino sospeso, di figli che traducono nell’immaginazione la fuga impossibile da un mondo inabitabile, nel corpo la minaccia della deportazione.
25 maggio h. 16.30 | M9 – Museo del ‘900-Mestre

Restituzione del laboratorio esperienziale Ma siamo matti? che ha esplorato il confine tra la normalità e la follia nell’esperienza privata e collettiva. Gli studenti e studentesse dell’Accademia di Belle Arti e dell’Università Ca’ Foscari hanno realizzato una performance che mette in scena il percorso emotivo di una matta, costretta a varcare il confine fra normalità e follia. Spirali di pregiudizi ed incomprensioni ancorano gli spettatori nella loro inconsapevolezza, che solo un passo in avanti potrà smuovere. Qual è guarigione e qual è follia? Dove si trova la follia?
26 maggio h. 16.30 | Accademia di Belle Arti
Dorsoduro 423
Giocando d’astuzia e di rovesciamenti, ci diciamo assediati da coloro che ben prima abbiamo messo sotto assedio, oppresso, razziato. Tracciamo per questo confini dilatati in terra e in mare, frontiere/prigioni che sono luoghi di sospensione delle vite sine die, fucine di un dolore che non può guarire, di violenze inenarrabili e smisurati crimini di pace. Un tema urgente, che affronta la tavola rotonda People on the move. Le vite sommerse dei prigionieri dei confini, con la presidente di Emergency
Rossella Miccio, Anna Clementi e Diego
Saccora di Lungo La Rotta Balcanica, Sandro Metz, armatore di Mare Jonio e Mediterranea Saving Human con David Yambio, attivista originario del Sud Sudan in fuga dalla guerra civile, detenuto nei campi in Libia.
«In un’epoca di pazzia, credersi immuni dalla pazzia è una forma di pazzia», scriveva il premio Nobel Saul Bellow nel suo Il re della pioggia. Un concetto piuttosto semplice eppure mai scontato, come ci ricorda ogni anno il Festival dei Matti che, giunto alla sua tredicesima edizione, torna a Venezia dal 25 al 28 maggio con il titolo Frenetica. La spirale che consuma. Cosa chiamiamo “follia” oggigiorno? Quali sono i tabù che innalzano muri invisibili quanto invalicabili? Come evitare l’esclusione, l’espulsione, il confinamento o anche il ‘semplice’ pregiudizio verso chi è considerato “matto”, quando spesso è solo “altro”, diverso da noi? Sono questi i temi e le sfide raccolte dal Festival dei Matti. «Stiamo dentro a una corsa a perdifiato, stregati dall’ebbrezza che ne viene, convinti che rallentare o fermarsi equivalga a scomparire. Ci inghiotte il mulinello del produrre, il mito della crescita iperbolica, la montatura, sempre da rifare, di “profili” che occultano quello che ci manca, l’orizzonte digitale in cui ogni fatto è doppiato e scorporato, reso innocuo dall’equivalenza e dalla rapida scomparsa», scrive la curatrice e ideatrice del Festival, Anna Poma, nel presentare questa nuova, frenetica edizione, che trova la propria ‘casa’ all’M9 – Museo del ‘900 a Mestre, e all’Accademia di Belle Arti e al Teatrino di Palazzo Grassi a Venezia, tre diverse location per quattro intense giornate-evento. Abbiamo bisogno di rallentare per noi stessi, per il nostro benessere, ma anche per trovare il tempo di accorgerci dell’altro, di vedere oltre il nostro proverbiale naso. È urgente astrarci da questa spirale, che non può e non deve dominare il nostro presente, dobbiamo farci attenti e sensibili ascoltatori della sofferenza altrui, imparare il linguaggio della solitudine per comprenderlo e farvi breccia.
È questo l’invito del Festival dei Matti che attraverso incontri, spettacoli, laboratori, reading, proiezioni indaga le grandi contraddizioni del nostro tempo, ciò che domina la scena della cosiddetta “normalità” e quello che resta sottotraccia, inavvertito, ripudiato. Tra i protagonisti dell’edizione 2023: l’Accademia della Follia, Roberto Beneduce, Massimo Cirri, Stefano Cecconi, Pierangelo Di Vittorio, Emanuele De Nicola, Antonio Esposito, Marco Ferrero, Giorgio Falco, Ilaria Gaspari, Sabrina Ragucci, Marco Rovelli, Simona Taliani, Anna Toscano, Marica Setaro, Francesco Targhetta, Gisella Trincas, Francesco Vacchiano, Mediterranea Saving Human, e l’associazione veneziana Lungo la Rotta Balcanica. Il Festival quest’anno inoltre ricorda con affetto Vitaliano Trevisan, prematuramente scomparso nel gennaio 2022, con l’anteprima del riallestimento dello spettacolo che lo scrittore vicentino aveva ideato nel 2006 nel ventennale della morte di Goffredo Parise. Note sui sillabari. Omaggio a Goffredo Parise e Vitaliano Trevisan, portato in scena dall’attrice e regista Patricia Zanco e dal pianista Marcello Tonolo, il 25 maggio alle 21 all’M9, è un intenso omaggio a due delle voci più complesse e rappresentative della letteratura italiana degli ultimi cinquant’anni. C.S.
28 maggio h. 11 | Teatrino di Palazzo Grassi XIII
In una giornata smagliante , piena di sole, con una temperatura ancora primaverile, mi veniva incontro sorridendo, convinta; con un sorriso non appena accennato, ma di quelli intensi, motivati. Mi guardava fisso. Confesso che ho avuto un momento difficile, di imbarazzo, di smarrimento. Sinceramente non riuscivo a ricordarmi chi fosse, dove l’avevo conosciuta, di chi poteva essere parente. Temevo di fare proprio la classica brutta figura, quella di uno smemorato, svampito. Poi avvicinandomi, mi sono accorto che ero totalmente fuori dal suo campo mentale (non dal suo campo visivo!). Le stavo davanti e per quella persona dal bel sorriso sincero, aperto, accattivante io… non esistevo. Ma allora quel sorriso? È bastato scostare i capelli, mostrare le orecchie, prima nascoste dagli stessi, per scoprire l’arcano: due auricolari collegati a un cellulare, riposto in chissà quale tasca. In effetti era in comunicazione con qualche fortunato interlocutore. Mi guardava, ma non mi vedeva. Così, abusivamente, ho fruito anch’io del suo accattivante sorriso. Tutto assurdo, ma… normale nei nostri tempi. Così, un piccolo episodio stradale mi ha indotto a fare qualche riflessione sul sorriso, per la verità non semplice da trattare con ordine, posto che questo possa esistere in proposito. Cominciamo, perciò, semplicemente ad analizzare in cosa consiste il sorriso. Tecnicamente si tratta di una lieve contrazione muscolare che consente alla bocca di schiudersi e assumere per lo più la forma dell’arco dentale, provocando una gamma incredibile di mutamenti dell’espressione del viso. I quali, se assai pronunciati, sconfinano nel campo della risata.
Ma questa “definizione”, per quanto forse vera, non rispecchia assolutamente, lo spirito né la sostanza del sorriso e delle sue molteplici varianti e neppure delle loro funzioni.
Spesso si sorride quando si incontra una persona che ci è (o si fa finta che ci sia) simpatica. Involontariamente (o forzatamente) si esprime questa sensazione con l’accenno più o meno marcato di un sorriso. Qualche volta, per la verità, questo sostituisce anche numerose, adeguate parole. Ma non solo. Il sorriso è un’espressione ricca di funzioni. Vediamo qualche esempio: può essere soltanto di circostanza, può confortare, incoraggiare, perdonare, dare fiducia, stimolare, togliere d’imbarazzo, approvare, essere d’intesa, semplicemente assicurare il proprio assenso, iniziare addirittura un rapporto affettivo, sostituire un opportuno silenzio, assistere amorevolmente un malato, esprimere solidarietà, manifestare un ironico dissenso, provocare altri sorrisi, utilizzando l’effetto “rimbalzo”, cioè la sua ben nota contagiosità.
Fryderyk Chopin, facendoci sorridere, ha affermato, che chi non ride mai, non è una persona seria! E, sempre un altro musicista, Ezio Bosso, ci ha fatto notare che i sorrisi avvicinano più dei passi e aprono più porte delle chiavi!
I sorrisi sono al confine tra la nostra parte materiale e quella invisibile che riguarda la nostra sensibilità. Già Platone, nell’antichità, aveva
affermato che: «La bellezza di un sorriso è mescolare in giuste proporzioni il finito e l’infinito».
Esiste anche un sorriso forzato, (ad esempio ascoltando una barzelletta inappropriata o tremendamente nota). Ma poi c’è un sorriso tenero, spontaneo, involontario, provocato per esempio dalla vista di un cucciolo, sia di animali che di esseri umani.
Inutile? Tutt’altro. È parte sostanziale di un linguaggio fortemente comunicativo, che non necessita di parole.
Un amico medico mi ha spiegato che, oltre a tutto, il sorriso e la risata sono terapeutici, non soltanto ci fanno rilassare, migliorando il nostro umore, ma vengono prodotte endorfine (e mentre, serio, lui spiegava, a me… scappava da ridere!).
Pablo Neruda, che sapeva far vibrare le nostre corde più profonde, invisibili, ha detto: «Ridere è il linguaggio dell’anima» (verrebbe quasi da pensare che allora, forse, i Grandi della Terra, non l’hanno mai letto! E non hanno mai provato l’uso della vera, sana risata. I loro muscoli della sana risata, per mancato uso, sembrano… atrofizzati).
Perfino nella Bibbia una risata è rimasta famosa: Sara, apprendendo di essere incinta, da persona anziana qual era, stupefatta, ha reagito ridendo. E ha voluto che quella sensazione gioiosa si perpetrasse, chiamando suo figlio: Isacco, Itzàk (derivato da z’chòk, in ebraico, “risata”).
Ed ora vi meritate alcune semplici, profonde riflessioni, forse di Gino Mazzetta oppure di un soggetto Anonimo (è molto incerta l’origine). Sono intitolate semplicemente: SORRISO.
Un sorriso non costa niente, ma può dare molto. Rende felice chi lo riceve, senza rendere più povero chi lo dà. Dura solo un attimo, ma entra nel cuore.
Nessuno è tanto ricco da poterne fare a meno e nessuno è tanto povero da non poterlo regalare.
Dona la felicità in casa e, tra gli amici, sicurezza e simpatia a tutti. Ti dà consolazione nella tristezza e ti rinvigorisce nella stanchezza. Quando sei scoraggiato, ti dà forza; quando hai paura ti dà coraggio.
Un sorriso non lo puoi comprare, né rubare, né prestare, però lo puoi donare.
Se qualche volta tu dovessi incontrare chi non sa sorridere, aiutalo, donandogli il tuo, perché nessuno ha tanto bisogno di un sorriso come chi non lo sa donare agli altri.
Agli economisti suggerisco una riflessione: utilizzate il sorriso! È un bene straordinario, prezioso, che non si consuma. Charlie Chaplin, il famoso comico, sempre molto saggio, ci ha ammonito: «Un giorno senza sorriso, è un giorno perso!».
Sappiatevi regolare… Ah, dimenticavo: potete cominciare anche subito!
La cucina deve spogliarsi dell’inutile per ritrovare la stessa innocenza che il bimbo ha nel raccontare il suo piccolo mondo

Da tempo avrei voluto intervistare Massimiliano Alajmo. Ogni volta che mi capitava di incontrarlo, sentirlo parlare con la sua calma riflessiva, senza eccessi di protagonismo e soprattutto capace di ascoltare, la stima e considerazione nei suoi confronti aumentava.
Ma non era la sua tecnica di cucina ciò che mi interessava principalmente, bensì il suo modo di vivere la professione di chef, assurto a soli 28 anni all’empireo dei Grandi in Cucina, con le tre stelle Michelin. Il suo essere una persona serissima, senza mai prendersi troppo sul serio, ha lasciato in Massimiliano la curiosità di un bambino affamato di conoscenza che non ha smesso comunque di giocare e divertirsi. Egli personifica l’idea che in ogni professione il talento del fuoriclasse si acquisisce sin dalla nascita, una sorta di predestinazione naturale ad essere numero uno. Come avrebbe detto Totò, «modestamente lo nacque».


Alajmo è un cuoco che definisco “presocratico”, perché come i filosofi dell’antica Grecia il suo lavoro è rivolto a indagare il fondamento ultimo e la natura essenziale del suo mondo, ricercando il principio archetipico degli elementi sin dalla loro origine ed esaltandone la funzione, ponendo al centro l’unicità dell’essere, mai replicabile nello stesso identico modo.
Finalmente un giorno la preziosa Marisa Huff, che per il Gruppo Alajmo guida la comunicazione, mi ha fissato un appuntamento alle Calandre, il sancta sanctorum della famiglia di ristoratori padovani, per un’intervista a Massimiliano e per provare il nuovo menù primaverile. Scherzando ho chiesto di poter mangiare pane e olio, scoprendo poi di essere in buona compagnia...
A differenza di molti suoi colleghi, l’approccio al suo lavoro è, o sembra essere, molto più rilassato o comunque maggiormente votato alla “leggerezza” con un filo di ironia. Forse per la consapevolezza che pur regalando felicità a chi siede alle vostre tavole, non si mutano i destini del mondo. (Ride) Sono consapevole di non cambiare i destini del mondo, al massimo gli intestini!
Il mio lavoro, che è un lavoro bellissimo, dovrebbe saper decontrarre, il che è una cosa seria. La tavola ci insegna che è possibile alleggerire le menti, lavorando un po’ di più sulle parti intime e relazionali, anche con sé stessi. È l’azione della condivisione, il partage dicono in Francia, una cosa bellissima che va al di là del gusto, è il sapore della vita, il fatto di riuscire ad accarezzare le parti più intime di noi stessi attraverso una sensorialità che consente di andare alla ricerca del sesto senso, qualcosa di estremamente più profondo, legato ai ricordi dell’infanzia. L’olfatto è in assoluto il senso più rapido che percepiamo, attraversa la parte intima di noi. Tuttavia per fare questo si deve abbattere tutto ciò che rappresenta la costruzione fin troppo seriosa di un’impostazione che nel tempo si è fortificata. La cucina in realtà è “pane e olio”, qualcosa che deve riportare l’olio alla dimensione naturale con la materia di relazione, senza intermediazioni. Perché è buono il pane e olio? Perché si mangia senza creare distanza; il pane si tocca, non si ha una posata, nulla che si possa frapporre. È come rimettere le mani nella terra, prendere coscienza che è tutto molto semplice. Si pensi a quello che sta accadendo nella società, la sovrastruttura posta in ogni azione, tutta l’artificiosità che rischia di portare. E al centro di tutto c’è un uomo che è quasi privo di senso; non solo è privo di senso in ciò che fa, ma è privo anche di sensorialità, cioè non ha più consapevolezza di sé stesso. Questo è il rischio che corriamo, ma al contempo diviene anche una grande opportunità, perché abbiamo la possibilità di confrontarci e di capire che cosa vogliamo davvero essere oggi.
Questo “sesto senso” porta ad evocare una sorta di immortalità, andando oltre le barriere del noto, cercando di relazionarsi verso qualcosa di non definito, in cui è ben presente l’idea dello stupore. Penso al Massimiliano bambino che seguiva sua madre in cucina, quasi fosse il suo personale parco giochi…
È il mio approccio alle cose. È il mondo dei bambini, del fantastico, in cui si può esplorare e precipitare, in cui continuare a perdersi, meravigliandosi sempre. Il sesto senso è intercettare la vibrazione prima ancora che nasca. Noi abbiamo cinque sensi e in cucina è meraviglioso fare esperienze sinestetiche. Ma quale è l’obiettivo? Quello di andare oltre, trovare il senso che muove gli altri cinque. È la parte animante, la parte della luce vera, quella che fa vibrare.
Domanda inevitabile e doverosa: come nascono i suoi piatti? La nostra idea di cucina è basata su ingredienti e fluidità. Tutto legato all’ascolto della materia, al fatto di non essere tanto autori, ma quasi spettatori. È come se ci infilassimo dentro ad un percorso molto naturale, per poter fluire insieme e cercare di farci trasportare dove la corrente ci può portare. Questa è la filosofia dell’ascolto, del rispetto della materia e di un percorso naturale per cui un cappero non è mai uguale ad un altro cappero. La materia è viva; mettersi in ascolto significa cogliere quello che c’è già e infine osservare delle reazioni che accadono negli ingredienti per poi indagare noi stessi. Che senso ha correre se quello che inseguiamo è proprio sotto i nostri occhi? Un monito, magari un suggerimento, ma sottovoce: il punto è meravigliarsi, perché dentro la materia c’è una bellezza di ordine superiore. Il nostro è un lavoro estremamente silenzioso, ma molto attento a quelle che possono essere delle vibrazioni assai sottili. Un lavoro profondamente legato al fatto di vivere e relazionarci con la materia in maniera molto delicata. Ci vuole veramente dedizione e volontà di immergersi, perché quella vibrazione sottile non è immediata da catturare, però è talmente bella che se si riesce a varcare quella minuscola soglia, allora lo stupore diventa meraviglia e un cappero ti può raccontare di cacao, di lavanda, di ibiscus e un altro cappero magari ti porta in un’altra dimensione ancora, completamente diversa, più acida, più erbacea, più mentolata. Scenari che spalancano ulteriori porte aperte sui ricordi, sulla memoria. Questa è una bellezza manifesta di una dimensione di ordine superiore; la visualizziamo nel cibo, ma è in qualsiasi cosa. La materia è il riflesso del macro nel micro, lì dentro riusciamo a vedere anche noi stessi. Le mutazioni che la materia può subire sono infinite, ma alla fine parlano di no. Le metamorfosi che la materia può avere sono esattamente coincidenti con quelle che possiamo noi stessi vivere nel corso della nostra esistenza. Alchimia è osservare una coagulazione, cercare di capire cosa accade nella trasformazione di un chicco di caffè, tutte queste sublimazioni assolute in cui la materia si modifica al punto quasi da non apparire più com’era allo stato originale, per poi magari, con un’operazione successiva, ritrovarla di nuovo nel suo stato originale, ma quasi priva di materialità. In un distillato si può trovare il senso della nudità, il crudo, la parte originale.
Quale futuro vede per la sua professione?
Inizio dicendo che temo maggiormente il rischio dell’aridità. Non è tanto la cucina, i mestieri che possano cambiare o sparire, ma quanto il fatto di abituarci alla velocità che nega qualsiasi tipo

di esperienza. Rischiamo di smarrire la bellezza della conquista. Siamo abituati a svolgere una ricerca ottenendo solo qualche istante dopo il risultato: si annulla l’idea del sacrificio, la fatica dell’andare a ricercare con pazienza e si annulla anche il fatto di poter gustare il risultato, oltretutto negando la possibilità di una riflessione. Ottenendo sempre cose nuove, senza mai gustarle a fondo, senza fatica, ci si abitua ad un’idea di perfezione che in realtà è vuota.
Però, senza troppo abbandonarmi al pessimismo, è anche vero che per logica di contrasto ci potrà essere una presa di coscienza e forse si potrà capire, se non sarà troppo tardi, dove risiede la vera differenza tra ciò che è bellezza vera, autentica a ciò che appare, ma non è.
Come è cambiato il pubblico che siede alle vostre tavole?
Il cibo è oggi condizionato da mode e tendenze mediatiche, oppure continua ad essere sempre viva ed autentica la curiosità per la tavola?
Ci sono sempre più tipologie di ospiti. Sicuramente si è registrato un rapido e notevole cambiamento in questi anni, dall’abbigliamento alla postura, al fatto stesso che per noi tutti è difficile sedersi a tavola senza un apparecchio che registri e sostituisca la memoria del momento. Il punto di vista, la memoria stessa è cambiata; le nuove generazioni non conoscono ciò che è stato prima. Senz’altro vi è stato un avvicinamento alla gastronomia assai più vorticoso, rapido, talvolta meno consapevole.
Essere “di moda” condiziona non poco questo lavoro, ma sono ancora in molti ad avere per fortuna conservato la memoria, andando al di là dell’aspetto legato puramente al fenomeno di costume,
legando il piacere della tavola al convivio. È davvero cambiato tutto, però le regole del gioco sono le medesime se si vogliono mantenere alti i parametri del nostro lavoro. Abbiamo tolto molto alla tavola, intesa come luogo fisico in cui si appoggia il cibo; ci eravamo resi conto che forse si era costruito troppo e si rischiava di perdere il senso della misura. Non ci sono più gli argenti, né i fiori; abbiamo lavorato sull’illuminazione, per concentrare l’attenzione verso il piatto e riscaldare, quasi accarezzare il senso del convivio. Il cameriere, poi, non deve essere più vestito troppo elegantemente, perché spesso il nostro cliente si presenta più informalmente e quindi potrebbe essere messo in soggezione. Il personale di servizio devo poi certo essere sempre ben attento e presente, ma facendosi quasi invisibile. Una dinamica comportamentale completamente diversa da quella che ho respirato quando ero ragazzino nei ristoranti in Francia. Ma è come un linguaggio che va adattato nel tempo, con la consapevolezza tuttavia del valore delle sue origini e delle sue fondamentali regole. Tutto questo rimane un esercizio sempre estremamente affascinante e stimolante, perché obbliga a rimetterti costantemente in discussione.
Come nascono le suggestioni per un menù?
Il filtro del mondo passa attraverso la curiosità nei confronti delle cose. Noi siamo immersi nel cibo, gli stimoli si colgono anche osservando le persone.
Lavoriamo moltissimo con la stagionalità, che peraltro anch’essa sta cambiando, per cui a volte si cerca di adattare o di cogliere determinati ingredienti che sono pronti prima. Poi fondamentale
risulta il dialogo e l’ascolto con gli artigiani con cui collaboriamo e a cui chiediamo cosa avrebbero piacere venisse utilizzato o che tipo di prodotto si trova in quel preciso momento. Coinvolgendoli si creano delle energie positive, dando una giusta corrispondenza alla filiera.
Quale il piatto preferito?
Dico e dirò sempre pane e olio, perché in esso emergono tutte le tracce della nostra cultura. È un modo per riappropriarsi della verità nascosta nelle cose grazie alla sua penetrazione multi-sensoriale nel gusto. C’è tutto di noi: il grano, da dove deriva, le trasformazioni, le fermentazioni, la masticazione stessa. Prima un rimbalzo, una resistenza e infine l’affondo. L’olio è la sacralità; un pane si spezza con le mani e in molte culture non andrebbe tagliato, tutto questo ha un valore che certamente si aggiunge al gusto.
Lei sembra una persona che sa gestire in maniera proficua lo stress. Corrisponde al vero?
È così stressante fare un lavoro che piace tanto e che si è scelto?
Sono io il peggior critico di me stesso, per cui ho imparato in qualche modo a gestirmi. Mi sono allenato e soprattutto ho imparato a relativizzare. Il mio mestiere è di una bellezza incredibile. Se qualcosa non viene bene o non funziona, cerco di fare tesoro di quell’esperienza, cercando di trovare il lato positivo nella faccenda. Dentro un piatto possiamo trovare tutto quello che vogliamo e spesso è il momento d’indagine più profonda di noi stessi, tra pregi e difetti. E tutto è masticabile, anche i difetti! Digerirli, invece, è altra faccenda...
Se non avesse fatto questo lavoro, cos’altro avrebbe voluto fare?
Una volta dicevo il “morto di fame”. Sempre a che fare con il cibo quindi, ma per sottrazione. Sono molte le cose che mi affascinano, credo però che avrei in ogni caso cercato il rapporto con il cibo, vivendo la tavola con una certa importanza.

Quali tra le cucine la incuriosiscono e attraggono maggiormente?
La comunanza anche del palato attraversa il genere umano. Noi ci chiudiamo nelle nostre differenze, quando invece vanno praticate aperture. Le cucine italiane sono belle e sono differenti, oltre ad essere ricchissime. Penso ad esempio alla cucina veneta e a quella campana o siciliana, in esse si trovano delle cose incredibili. Alcune culture gastronomiche sono invece ancora opacizzate; mi viene in mente la pasticceria sarda e tutte le lavorazioni non ancora manifeste al mondo. Ce ne sono una miriade, non riesco a sceglierne una a discapito di un’altra perché ognuna di queste ha una bellezza che è fatta di contaminazioni, di fatiche, di sofferenze, di conquiste e raccontano la storia delle nostre civiltà.
Noi siamo stati un Paese conquistato, subordinato a molti, però siamo riusciti come una spugna ad assorbire tutta la ricchezza di tante esperienze così differenti. La cucina vive di contaminazioni che vanno via via sedimentandosi.
Quando viaggio e assaporo con curiosità delle cose spesso le trovo distanti dalle nostre abitudini, ma ci sono sempre dei punti di congiunzione. Tra una tempura giapponese e un fritto veneziano c’è una somiglianza incredibile, entrambi realizzati con un tecnicismo pazzesco e una gestualità rituale.
Entriamo in punta di piedi e con tutto il rispetto dovuto a chi del mondo vinicolo è un aedo per descrivere con parole nostre una realtà produttiva importante, Le Monde di Prata di Pordenone, ai confini con il Veneto, i cui vini accompagnano la serata inaugurale nel Complesso dell’Ospedaletto in occasione della nuova mostra Venezia Fabrica Futura realizzata da Fabrica e Ospedaletto Contemporaneo. Le Monde, fondata nel 1970, è stata rilevata da Alex Maccan nel 2008. L’azienda friulana, posta tra i fiumi Livenza e Meduna, rappresenta una realtà del tutto a sé stante, perché dal punto di vista agronomico offre una composizione dei propri terreni del tutto diversa da quella che s’incontra, in generale, in questa parte d’Italia, con una quasi assoluta prevalenza calcareo-argillosa, mentre non è presente la componente ghiaiosa caratterizzante la pianura friulana. In questo senso, si potrebbe parlare di un vero e proprio Cru a dimensione aziendale, da cui si ottengono vini dalle caratteristiche organolettiche molto diverse da quelli che vengono prodotti in questa area. L’età media dei vigneti è di trent’anni, il che aumenta il grado di compiutezza delle etichette a marchio Le Monde. In pochi anni l’azienda è cresciuta arrivando a ben 100 ettari vitati e raggiungendo la giusta ribalta. Eleganti monovitigni con una predilezione per i bianchi, tra cui spicca il pregevole Pinot Bianco, gli intramontabili Cabernet, Merlot e Refosco e l’immancabile bollicina a completamento della gamma.

Select mantiene un legame fortissimo con Venezia, essendo nato in città nel 1920 nella distilleria dei fratelli Pilla, Vittorio e Mario, a Castello. Dal 1988 il marchio Select è entrato a far parte di Gruppo Montenegro. Il liquore dolce-amaro che sarebbe divenuto marchio indelebile dell’aperitivo alla veneziana dovrebbe il suo nome nientemeno che a Gabriele D’Annunzio, che durante una cena in occasione del Redentore trovò la bevanda così buona da elogiarne la selezione delle materie prime e la sapiente commistione, coniando per l’occasione il termine “selectus”, poi troncato in Select. In realtà dapprima l’azienda produttrice del Select si trovava a San Donà di Piave e si chiamava “Stabilimento Enologico Liquori E Cremor Tartaro”, iniziali da cui deriva il nome. Leggende a parte, alla versione autentica e originale è dedicata la prima Select Spritz Week, dal 25 al 28 maggio in cui a tutti, soprattutto ai turisti attraverso esperienze inedite e diffuse, vengono offerti insoliti spunti o anzi sorsi di conoscenza della città. Si va dalle visite ‘olfattive’ in compagnia del maestro profumiere, alla visita del Conservatorio Benedetto Marcello con degustazioni a seguire, dall’aperitivo letterario in libreria al viaggio alla scoperta dei mosaici realizzati nell’unica fornace a fuoco vivo della città, fino al concerto all’aperto sullo sfondo del Rio di Cannaregio. La Select Spritz Week punta anche a sensibilizzare sull’importanza della tutela dei mari e degli oceani, a partire dalla Laguna di Venezia, grazie alla partnership tra Select e Ocean Space. Evento clou è l’apertura ufficiale di Ca’ Select all’interno di un ex laboratorio industriale di quasi 700 mq di superficie a Cannaregio 3527. Un nuovo spazio in cui è possibile vivere un’esperienza immersiva che racconta la storia del brand e dove viene ospitato il cuore del processo di macerazione di alcune erbe e spezie che caratterizzano la ricetta di Select. F.M.

The array of deep red bitters produced in the Venetia is longer than one might expect. The bittersweet liqueur created in 1920 by the Pilla Brothers became a staple of Venetian aperitif, and acquired its name, Select, thanks to the fantasy of word coiner par excellence Gabriele D’Annunzio. The Select Spritz Week will be a May 25 to 28 event, or series of events, for us to get to know better, sip after sip, both the drink and some Venetian lore. There will be ‘olfactory’ visits with a master perfumer, a visit to the local music academy, a book club aperitivo, a visit to a mosaic tile factory, and an open-air concert. Thanks to a partnership with Ocean Space, there will also be educational programmes on the importance of protecting the well-being of our seas and oceans.

Venezia, come tutte le città d’arte, soffre di un eccesso di presenze turistiche che paradossalmente affollano più o meno sempre gli stessi luoghi. Tuttavia esiste anche una parte di città che si offre allo sguardo dei viaggiatori più curiosi e attenti che vengono premiati con angoli pieni di fascino e vuoti di turisti chiassosi.
In una fondamenta di Cannaregio silenziosa e autentica, in cui resistono ancora veri abitanti e gli ultimi grandi artigiani depositari di tecniche uniche di lavorazione, basti citare la Fornace Orsoni con i preziosi mosaici e Mario Berta Battiloro con la lavorazione di oro e argento che vengono trasformati in sottilissime foglie, adatte ad applicazioni in molteplici settori, si trova un boutique hotel, l’Heureka, che occupa un palazzo del XVI secolo sapientemente trasformato in un tranquillo rifugio con sole 10 camere. Al suo interno custodisce un giardino segreto con alberi e fiori colorati che diviene un set ideale per momenti davvero irripetibili durante la bella stagione. Qui viene offerta una delle migliori colazioni di Venezia, con un’ampia selezione di formaggi e salumi, prodotti tipici, frutta fresca e naturalmente una varietà di pasticceria per ulteriormente addolcire il tutto, non manca poi un lungo elenco di Cocktail freschi, alcolici e non, molto ben preparati. Per chi volesse trascorrere una serata speciale e unforgettable la novità è rappresentata dal ‘tavolo privato’ in cui lo chef Justus prepara per i commensali il suo menù stagionale a base di fresche primizie locali, per gustare e assaporare i migliori sapori di Venezia e della laguna in un’atmosfera magica. Marzio Fabi ENG Much like any art city, Venice suffers from overtourism. What is curious about that, is that the excessive number of visitors concentrate on the same few places in town. There are, in fact, corners of Venice that are fascinating and authentic as much as they are uncrowded. By a tranquil quay in Cannaregio, in the north side of Venice, nestled between houses where actual Venetians live and craftsmen’s shop, is a boutique hotel, the Heureka: a sixteenth-century palace renovated into a beautiful refuge of ten rooms total, plus a secret garden. Heureka offers the chance for an unforgettable, special night in town: a private table with chef Justus and a choice of seasonal food offers to taste the best Venice and its lagoon have to offer.
Palazzina Grassi è stato l’hotel che ha segnato la svolta radicale tra la Venezia prettamente turistica e di sera un po’ sonnacchiosa, e una città in grado di attrarre il pubblico internazionale che fa vera tendenza. Le feste a Palazzina che seguono le proiezioni serali al Lido sono divenute leggendarie per la qualità inarrivabile degli ospiti VIP internazionali, e anche nel periodo di vernici Biennale, sia Arte che Architettura, il pubblico dei fortunati festaioli è rappresentato dai più importanti protagonisti della scena artistica e del mondo dell’architettura. Un’autentica rivoluzione nella nightlife veneziana di cui fu artefice Emanuele Garosci, l’illuminato imprenditore prematuramente scomparso nel 2014, primo proprietario di Palazzina che ebbe l’intuizione di immaginare che gli happy few che seguono il tour culturale internazionale, di cui Venezia è una delle tappe obbligate, hanno voglia di divertirsi dopo le immersioni tra Padiglioni e mostre varie. Anche quest’anno nei giorni 18, 19 e 20 maggio, Palazzina Grassi presenta The Laboratory of Clubbing, tre serate che celebrano Biennale Architettura, che ha come tema The Laboratory of the Future, in cui viene proposto il format Palazzina The Club con cena seduti e dopocena su invito con DJ set di artisti di fama internazionale. Giovedì 18 è previsto il Dj set di Barnaba Fornasetti, figura eclettica e anima del brand Fornasetti; venerdì 19 tocca al duo di gemelle berlinesi The Geminis che portano il loro sound ricercato che unisce sonorità melodiche a un groove techno; sabato 20, invece guida la serata Elbio Bonsaglio, creativo e influencer con la passione per la musica elettronica.
ENG Palazzina G is the hotel that initiated a radical renovation of Venetian hospitality, a shakedown of an industry that used to be a bit sleepy, and turned it into a city that can attract an international, trendy clientele. The parties at Palazzina G that follow the Film Festival screenings are legendary for its VIP guests. The Biennale opening days also bring the Gotha of art and architecture to Palazzina. We owe this revolution in Venetian nightlife to Emanuele Garosci, the enlightened entrepreneur who regrettably passed, all too soon, in 2014, and who imagined a majestic, amazing home for the Venetian stop of a grand tour. This year, on May 18, 19, and 20, Palazzina G presents The Laboratory of Clubbing, three nights to celebrate the Architecture Biennale with a sit-down dinner, and an invite-only DJ-set with international producers: Barbara Fornasetti on Thursday, May 18, The Geminis on Friday, May 19, and Elbio Bonsaglio on Saturday, May 20.





ENG The AMO Restaurant at Fondaco dei Tedeschi understood perfectly the soul of the place it inhabits, a place devoted to trade and shopping and a place where one will meet people of many different countries and cultures, like an airport terminal. AMO maître d’ Michele Pozzani and executive chef Silvio Giavedoni created a journey around the world in five stages. First stop is Tokyo on May 20, then Marrakesh on June 16, Sao Paulo on July 21, Mumbai on August 18, and last Paris on September 8. The menus have been compiled by Silvio Giavedoni and Roberto Ienna to offer AMO clientele a taste of Alajmo cuisine with a generous touch of taste and ingredients from abroad. No city, better than Venice, can represent the history and the value of exchange and contamination. After all, trade and commerce are what granted Venice power and prestige. Seeing how it’s Alajmo we are talking about, it won’t surprise you that their menu is worthy of first class: a true immersion into gastronomic culture, with a touch of local. This will be a very safe journey, in excellent company!
AMO al Fondaco dei Tedeschi ha saputo da subito intercettare l’anima vera dello spazio che lo contiene, un luogo certamente vocato al commercio ed anche un luogo in cui si incontrano persone di ogni provenienza e cultura, come nella hall di un aeroporto. Questo paragone ha spinto Michele Pozzani, che di AMO è il maître, ad ideare con la complicità dell’executive chef Silvio Giavedoni un viaggio gastronomico in cinque tappe con partenza da AMO che porterà a conoscere i luoghi e le culture che hanno intrecciato legami particolari con la storia del Gruppo Alajmo. Prendendo a prestito i codici aeroportuali e con modalità simili nella grafica dei menù alle carte d’imbarco, in questo caso slacciando le cinture per ragioni di sicurezza degli abiti (!), si decolla per un world tour che arriva a Tokyo il 20 maggio, per toccare poi Marrakech il 16 giugno, San Paolo del Brasile il 21 luglio, Mumbai il 18 agosto e infine Parigi, l’8 settembre. Un viaggio attraverso i menu creati da Silvio Giavedoni e Roberto Ienna per poter assaporare i piatti frutto delle contaminazioni nate dall’incontro dello stile di cucina Alajmo con le tradizioni e gli ingredienti di ogni diversa località. E nessuna città più di Venezia può rappresentare al meglio, con la sua storia, il valore delle contaminazioni e degli scambi che ne hanno favorito la potenza e il prestigio. Trattandosi di Alajmo il menù ricorda maggiormente la varietà e la ricchezza dello stile First Class, nessuna anonima portata da classe turistica, fredda e poco invitante, ma una vera e propria immersione nella cultura gastronomica dei vari luoghi, senza temere un tocco local. È un viaggio sicuro, la compagnia aerea è tra le più affidabili e non ci saranno turbolenze o rischio di ritardi. Compiere un giro del mondo comodamente da Rialto è un’opportunità che va colta e per giunta senza code al check in. Welcome on board!



18
giovedìThursday
PRODIGY
Big beat
Gran Teatro Geox-Padova h. 21
BRUCE SPRINGSTEEN & THE E STREET BAND
Rock’n’roll
Parco Urbano Bassani-Ferrara h. 21
19
venerdì Friday
OPEN CALL + MAI MAI MAI
Musica sperimentale
“Audiomanzie“
Circolo Nadir-Padova h. 21
20
sabato Saturday
ARMANDO BATTISTON
Jazz
Laguna Libre h. 21
JAMES SENESE
Jazz
Teatro Corso-Mestre h. 21
MARCO MENGONI
Pop
Stadio Euganeo-Padova h. 21
RICCARDO GIACCONI + GIULIA RAE
Musica sperimentale
“Audiomanzie“
Circolo Nadir-Padova h. 21
PETER GABRIEL
World music
Arena di Verona h. 21
21
domenica Sunday
INTI-ILLIMANI
GIULIO WILSON
Folk
Gran Teatro Geox-Padova h. 21
ALEKSANDER KOLKOWSKI
Musica sperimentale
“Audiomanzie“
Sala dei Giganti-Padova h. 21
26
venerdì Friday
GABRIELE DE LEPORINI
DUO
Jazz
Laguna Libre h. 21
RAF
Pop
Gran Teatro Geox-Padova h. 21
mercoledìWednesday
TIZIANO FERRO
Pop
Stadio Teghil-Lignano Sabbiadoro h. 21
08
giovedìThursday
GHOSTED
Jazz psichedelico
“Centrodarte23“
Circolo Nadir-Padova h. 21
10
sabato Saturday
URI CAINE
Jazz Auditorium Squero h. 16.30
SUM 41
Punk
Palazzo del Turismo-Jesolo h. 21
14
mercoledìWednesday
POST NEBBIA
GENERIC ANIMAL
Synth rock
“Sherwood Festival“
Park Nord Stadio Euganeo-Padova h. 21
16
venerdì Friday
CARMEN CONSOLI
MARINA REI Rock
“Sherwood Festival“
Park Nord Stadio Euganeo-Padova h. 21
17
ALICE
sabato Saturday
Battiato tribute
Teatro Romano-Verona h. 21
20
martedìTuesday
PAOLO FRESU & OMAR SOSA
Jazz
“Verona Jazz Festival“
Teatro Romano-Verona h. 21
22 giovedìThursday
VERDENA VISCONTI
Rock
“Sherwood Festival“
Park Nord Stadio Euganeo-Padova h. 21
23
venerdì Friday
PAOLO BALDINI & DUB FX MELLOW MOOD
Reggae
“Sherwood Festival“
Park Nord Stadio Euganeo-Padova h. 21
24
NITRO Rap
sabato Saturday
“Sherwood Festival“
Park Nord Stadio Euganeo-Padova h. 21
TIGRAN HAMASYAN
Jazz
“Verona Jazz Festival“
Teatro Romano-Verona h. 21
25
domenica Sunday
PORCUPINE TREE
Progressive rock
Anfiteatro Camerini-Piazzola sul Brenta h. 21
27
martedìTuesday
SKA-P PUNKREAS MEGANOIDI
Punk
“Sherwood Festival“
Park Nord Stadio Euganeo-Padova h. 21
TONY HADLEY
Jazz
Teatro Romano-Verona h. 21
28
mercoledìWednesay INCOGNITO
Acid Jazz
Teatro Romano-Verona h. 21
30
venerdì Friday
LAURA PAUSINI
Pop
Piazza San Marco h. 21
INDIRIZZI
ANFITEATRO CAMERINI
Piazzola sul Brenta www.zedlive.com
ARENA DI VERONA
Piazza Bra 1-Verona www.livenation.it
AUDITORIUM SQUERO Isola di San Giorgio Maggiore www.asolomusica.com
CIRCOLO NADIR
Piazzetta Gasparotto-Padova www.centrodarte.it
GRAN TEATRO GEOX
Via Tassinari 1-Padova www.zedlive.com
LAGUNA LIBRE
Fondamenta Cannaregio www.venetojazz.com
PALAZZO DEL TURISMO
Piazza Brescia 11-Jesolo www.assomusica.org
PARCO URBANO
G. BASSANI Ferrara barleyarts.it
PARK NORD STADIO
EUGANEO
Via N. Rocco 60-Padova www.sherwoodfestival.it
PIAZZA SAN MARCO Venezia www.friendandpartners.it
SALA DEI GIGANTI
Palazzo Liviano-Padova www.centrodarte.it
STADIO EUGANEO
Via N. Rocco 60-Padova www..zedlive.com
STADIO TEGHIL
Viale Europa 144-Lignano Sabbiadoro www.livenation.it
TEATRO CORSO
Corso del Popolo 30-Mestre www.amceventi.it
TEATRO ROMANO
Regaste Redentore-Verona www.eventiverona.it
TEATRO TORRESINO
Via Torresino 2-Padova www.centrodarte.it
mercoledìWednesday
LAC - IL LAGO DEI CIGNI
Musiche di Cajkovskij
Coreografie di Maillot
Ingresso/Ticket € 143
Teatro La Fenice h. 19
18
giovedìThursday
LAC - IL LAGO DEI CIGNI
Musiche di Cajkovskij
Coreografie di Maillot
Ingresso/Ticket € 143
Teatro La Fenice h. 19
UTO UGHI violino
I VIRTUOSI ITALIANI
Musiche di Vivaldi
Ingresso/Ticket € 30
Scuola Grande di San Rocco h. 20.45
19
venerdì Friday
LAC - IL LAGO DEI CIGNI
Musiche di Cajkovskij
Coreografie di Maillot
Ingresso/Ticket € 143
Teatro La Fenice h. 19
20
sabato Saturday
LAC - IL LAGO DEI CIGNI
Musiche di Cajkovskij
Coreografie di Maillot
Ingresso/Ticket € 143
Teatro La Fenice h. 19
Musiche di Banchieri
“Festival Galuppi 2023“
Ingresso/Ticket € 30/20
Chiesa di San Rocco h. 20.30
21
domenica Sunday
MASSIMO BISSON organo
Musiche del repertorio sacro
“Echi d’organo in cantoria“
Ingresso libero/Free entry
Chiesa di San Salvador h. 16.30
LAC - IL LAGO DEI CIGNI
Musiche di Cajkovskij
Coreografie di Maillot
Ingresso/Ticket € 143
Teatro La Fenice h. 19
MARCELLO
Musiche di Hindemith, Goetz
“Sulle note del secolo“
Ingresso/Ticket € 7/5
M9 Museo del ‘900-Mestre h. 18
SONIG TCHAKERIAN violino
PIETRO TONOLO sax
ORCHESTRA REGIONALE FILARMONIA VENETA
Musiche di Vivaldi, Tonolo
“Settimane Musicali al Teatro
Olimpico“
Ingresso/Ticket € 40/10
Teatro Olimpico-Vicenza h. 20.45
24
mercoledìWednesday
MASSIMILIANO GROTTO
pianoforte
Musiche di Martucci, Fano
“Musikamera“
Ingresso/Ticket € 25/15
Teatro La Fenice h. 20
25
giovedìThursday
IL TRIONFO DEL TEMPO E DEL DISINGANNO
Musica di Georg Friedrich Händel
Regia Saburo Teshigawara
Direttore Andrea Marcon
“Stagione Lirica e Balletto 20222023“
Ingresso/Ticket € 143/55
Teatro Malibran h. 19
26
venerdì Friday
ROBERT TREVINO direttore ORCHESTRA
DEL TEATRO LA FENICE
Musiche di Beethoven, Strauss
“Stagione Sinfonica 2022-2023“
Ingresso/Ticket € 88
Teatro La Fenice h. 20
MARIO BRUNELLO violoncello
Musiche di Bach
“Settimane Musicali al Teatro
Olimpico“
Ingresso/Ticket € 40/10
Teatro Olimpico-Vicenza h. 20.45
27
sabato Saturday
NICOLÒ CAFARO pianoforte
Musiche di Scarlatti, Chopin, Brahms
“Settimane Musicali al Teatro Olimpico“
Ingresso/Ticket € 40/10
Teatro Olimpico-Vicenza h. 18
28 domenica Sunday
IL TRIONFO DEL TEMPO E DEL DISINGANNO
Musica di Georg Friedrich Händel
Regia Saburo Teshigawara
Direttore Andrea Marcon
“Stagione Lirica e Balletto 20222023“
Ingresso/Ticket € 143/55
Teatro Malibran h. 15.30
FELIX MARANGONI organo
Musiche del repertorio sacro
“Echi d’organo in cantoria“
Ingresso libero/Free entry
Chiesa di San Salvador h. 16.30
ROBERT TREVINO direttore ORCHESTRA
DEL TEATRO LA FENICE
Musiche di Beethoven, Strauss
“Stagione Sinfonica 2022-2023“
Ingresso/Ticket € 88
Teatro La Fenice h. 20
IO CATERINA SERVA E SCHIAVA DEI SERVI DI GESÙ CRISTO
Musiche di Monteverdi
“Festival Galuppi 2023“
Ingresso/Ticket € 30/20
Scuola Grande di San Rocco h. 20.30
ALUNNI DEL CONSERVATORIO MARCELLO
Musiche di Vivaldi, Malipiero
“Sulle note del secolo“
Ingresso/Ticket € 7/5
M9 Museo del ‘900-Mestre h. 18
FRANCESCO GALLIGIONI violoncello
ROBERTO LOREGGIAN clavicembalo
Musiche di Bach
“Settimane Musicali al Teatro Olimpico“
Ingresso/Ticket € 40/10
Teatro Olimpico-Vicenza h. 11
PAOLO KESSISOGLU voce recitante
SONIG TCHAKERIAN violino
LEONORA ARMELLINI
pianoforte
Musiche di Beethoven, Wagner
“Settimane Musicali al Teatro
Olimpico“
Ingresso/Ticket € 40/10
Teatro Olimpico-Vicenza h. 20.45
30
martedìTuesday
IL TRIONFO DEL TEMPO E DEL DISINGANNO
Musica di Georg Friedrich Händel
Regia Saburo Teshigawara
Direttore Andrea Marcon
“Stagione Lirica e Balletto 20222023“
Ingresso/Ticket € 143/55
Teatro Malibran h. 19
31
mercoledìWednesday
ENZO CAROLI flauto
ANNA MARTIGNON pianoforte
Musiche di Poulenc, Hindemith
“Musikamera“
Ingresso/Ticket € 25/15
Teatro La Fenice h. 20
GiuJun
01 giovedìThursday
IL TRIONFO DEL TEMPO E DEL DISINGANNO
Musica di Georg Friedrich Händel
Regia Saburo Teshigawara
Direttore Andrea Marcon
“Stagione Lirica e Balletto 20222023“
Ingresso/Ticket € 143/55
Teatro Malibran h. 19
CATERINA ENSEMBLE
Musiche di Platti
“Festival Galuppi 2023“
Ingresso/Ticket € 30/20
Chiesa di San Rocco h. 20.30
02
venerdì Friday
NICOLÒ CAFARO pianoforte
Musiche di Scarlatti, Chopin, Brahms
“Festa della Repubblica“
Ingresso su invito/Admission upon invitation
Teatro La Fenice h. 17
ANDREA LUCCHESINI pianoforte GABRIELE MIRABASSI clarinetto
Musiche di Berio, Scarlatti
“Settimane Musicali al Teatro Olimpico“
Ingresso/Ticket € 40/10
Teatro Olimpico-Vicenza h. 20.45
03 sabato Saturday
IL TRIONFO DEL TEMPO E DEL DISINGANNO
Musica di Georg Friedrich Händel
Regia Saburo Teshigawara
Direttore Andrea Marcon
“Stagione Lirica e Balletto 20222023“
Ingresso/Ticket € 143/55
Teatro Malibran h. 15.30
WAKANA MARLENE
TANAKA pianoforte
Musiche di Schubert, Beethoven
“Settimane Musicali al Teatro Olimpico“
Ingresso/Ticket € 40/10
Teatro Olimpico-Vicenza h. 18
04 domenica Sunday
DEVID PAVANATI organo CONCENTUS MUSICUS
PATAVINUS
Musiche del repertorio sacro
“Echi d’organo in cantoria“
Ingresso libero/Free entry
Chiesa di San Salvador h. 16.30
MUSICA RITROVATA
ENSEMBLE
Musiche di Vivaldi
“Festival Galuppi 2023“
Ingresso/Ticket € 30/20
Teatro La Fenice h. 20
MARIA LUISA ZALTRON
pianoforte
STEFANIA REDAELLI
pianoforte
Musiche di Debussy
“Settimane Musicali al Teatro Olimpico“
Ingresso/Ticket € 40/10
Teatro Olimpico-Vicenza h. 11
DUO IRENÉ FIORITO
pianoforte RICCARDO RONDA
pianoforte
Musiche di Brahms, Respighi
“Settimane Musicali al Teatro Olimpico“
Ingresso/Ticket € 40/10
Teatro Olimpico-Vicenza h. 18
06 martedìTuesday
THE UNORTHODOX QUARTET
Musiche di Rossini, Beethoven, Mozart
“Festival Galuppi 2023“
Ingresso/Ticket € 30/20
Teatro La Fenice h. 20
07
mercoledìWednesday
MILENA VUKOTIC voce recitante
MARIO ANCILLOTTI flauto
ALESSANDRO MARANGONI
pianoforte
Musiche di Mozart, Debussy
“Musikamera“
Ingresso/Ticket € 25/15
Teatro La Fenice h. 20
08
giovedìThursday
MILENA VUKOTIC voce
recitante
MARIO ANCILLOTTI flauto
ALESSANDRO MARANGONI
pianoforte
Musiche di Mozart, Debussy
“Musikamera“
Ingresso/Ticket € 25/15
Teatro La Fenice h. 20
09
venerdì Friday
ALPESH CHAUHAN direttore
ORCHESTRA
DEL TEATRO LA FENICE
Musiche di Beethoven, Berio
“Stagione Sinfonica 2022-2023“
Ingresso/Ticket € 99/45
Teatro Malibran h. 20
10
sabato Saturday
ALPESH CHAUHAN direttore
ORCHESTRA
DEL TEATRO LA FENICE
Musiche di Beethoven, Berio
“Stagione Sinfonica 2022-2023“
Ingresso/Ticket € 99/45
Teatro Malibran h. 17
MILO FERRAZZINI violoncello
LORENZO GUGOLE maestro
concertatore
Musiche di Tchaikovski
“Festival Galuppi 2023“
Ingresso/Ticket € 30/20
Scuola Grande di San Rocco h. 20.30
ALESSANDRO DEL GOBBO
pianoforte
Musiche di Debussy
“Settimane Musicali al Teatro
Olimpico“
Ingresso/Ticket € 40/10
Palazzo Chiericati-Vicenza h. 18
11 domenica Sunday
NICOLA LAMON organo
Musiche del repertorio sacro
“Echi d’organo in cantoria“
Ingresso libero/Free entry
Chiesa di San Salvador h. 16.30
ANGELA HEWITT pianoforte
Musiche di Bach
“Musikamera“
Ingresso/Ticket € 40/10
Teatro La Fenice h. 20
DANIELE FASANI pianoforte
Musiche di Rzewski
“Settimane Musicali al Teatro
Olimpico“
Ingresso/Ticket € 40/10
Palazzo Chiericati-Vicenza h. 11
COSTANZA LEUZZI
clavicembalo
Musiche di Händel
“Settimane Musicali al Teatro Olimpico“
Ingresso/Ticket € 40/10
Palazzo Chiericati-Vicenza h. 18
12
lunedì Monday
DOMENICO NORDIO violoncello FEDERICO LOVATO
pianoforte
Musiche di Beethoven, Schubert, Brahms
“Festival Galuppi 2023“
Ingresso/Ticket € 30/20
Teatro La Fenice h. 20
13
martedìTuesday
MARK PADMORE tenore
IMOGEN COOPER pianoforte
Musiche di Schumann, Fauré, Hahn
“Musikamera“
Ingresso/Ticket € 25/15
Teatro La Fenice h. 20
14
mercoledìWednesday
MARK PADMORE tenore
IMOGEN COOPER pianoforte
Musiche di Schumann, Fauré, Hahn
“Musikamera“
Ingresso/Ticket € 25/15
Teatro La Fenice h. 20
16 venerdì Friday
AIDA
Musica di Giuseppe Verdi
Regia Stefano Poda
Direttore Marco Armiliato
“100° Arena Opera Festival“
Ingresso/Ticket € 330/35
Arena di Verona h. 21
17 sabato Saturday
GLI ARCHI ITALIANI CORO CITTÀ DI PIAZZOLA
SUL BRENTA
Musiche di Mozart
“Festival Galuppi 2023“
Ingresso/Ticket € 30/20
Scuola Grande di San Rocco h. 20.30
AIDA
Musica di Giuseppe Verdi
Regia Stefano Poda
Direttore Marco Armiliato
“100° Arena Opera Festival“
Ingresso/Ticket € 330/35
Arena di Verona h. 21.15
18 domenica Sunday
GIOVANNI ANDREA ZANON violino
LEONORA ARMELLINI pianoforte
Musiche di Beethoven, Brahms
“Musikamera“
Ingresso/Ticket € 25/15
Teatro La Fenice h. 20
22 giovedìThursday
DER FLIEGENDE
HOLLÄNDER
Musica di Richard Wagner
Regia Marcin Lakomicki
Direttore Markus Stenz
“Stagione Lirica e Balletto 20222023“
Ingresso/Ticket € 240/154
Teatro La Fenice h. 19
23 venerdì Friday
CARMEN
Musica di Georges Bizet
Regia Franco Zeffirelli
Direttore Daniel Oren
“100° Arena Opera Festival“
Ingresso/Ticket € 270/32
Arena di Verona h. 21.15
24 sabato Saturday
CONSERVATORIO DI MUSICA DI VENEZIA FRANCESCO ERLE direttore
Musiche di Galuppi
“Festival Galuppi 2023“
Ingresso/Ticket € 30/20
Scuola Grande di San Rocco h. 20.30
IL BARBIERE DI SIVIGLIA
Musica di Gioachino Rossini
Regia Hugo de Ana
Direttore Alessandro Bonato
“100° Arena Opera Festival“
Ingresso/Ticket € 270/32
Arena di Verona h. 21.15
25 domenica Sunday
DER FLIEGENDE HOLLÄNDER
Musica di Richard Wagner
Regia Marcin Lakomicki
Direttore Markus Stenz
“Stagione Lirica e Balletto 20222023“
Ingresso/Ticket € 240/154
Teatro La Fenice h. 17
AIDA
Musica di Giuseppe Verdi
Regia Stefano Poda
Direttore Marco Armiliato
“100° Arena Opera Festival“
Ingresso/Ticket € 330/35
Arena di Verona h. 21.15
28 mercoledìWednesday
DER FLIEGENDE HOLLÄNDER
Musica di Richard Wagner
Regia Marcin Lakomicki
Direttore Markus Stenz
“Stagione Lirica e Balletto 20222023“
Ingresso/Ticket € 240/154
Teatro La Fenice h. 19
29 giovedìThursday
AIDA
Musica di Giuseppe Verdi
Regia Stefano Poda
Direttore Marco Armiliato
“100° Arena Opera Festival“
Ingresso/Ticket € 330/35
Arena di Verona h. 21.15
30 venerdì Friday
MARKUS STENZ direttore ORCHESTRA DEL TEATRO LA FENICE
Musiche di Haydn, Strauss
“Stagione Sinfonica 2022-2023“
Ingresso/Ticket € 143
Teatro La Fenice h. 20
IL BARBIERE DI SIVIGLIA
Musica di Gioachino Rossini
Regia Hugo de Ana
Direttore Alessandro Bonato
“100° Arena Opera Festival“
Ingresso/Ticket € 270/32
Arena di Verona h. 21.15
INDIRIZZI
ARENA DI VERONA
Piazza Bra 1-Verona www.arena.it
CHIESA DI SAN ROCCO San Polo 3125 www.festivalgaluppi.it
CHIESA DI SAN SALVADOR
San Marco 4835 www.lacantoriacampitelli.it
M9 MUSEO DEL ‘900
Via G. Pascoli 11-Mestre www.m9museum.it
PALAZZO CHIERICATI
Piazza Matteotti 37-Vicenza www.settimanemusicali.eu
SCUOLA GRANDE DI SAN ROCCO San Polo 3054 www.comune.venezia.it
TEATRO LA FENICE
Campo San Fantin 1965 www.teatrolafenice.it
TEATRO MALIBRAN
Campiello del Teatro 5873 www.teatrolafenice.it
TEATRO OLIMPICO
Piazza Matteotti 11-Vicenza www.settimanemusicali.eu
NATIONAL PARTICIPATIONS
AUSTRALIA
AUSTRIA
BELGIO BRASILE CANADA
Repubblica di COREA
DANIMARCA
EGITTO
FINLANDIA
(Padiglione Alvar Aalto)
FRANCIA
GERMANIA
GIAPPONE
GRAN BRETAGNA
GRECIA
ISRAELE
PAESI BASSI
PAESI NORDICI
(Finlandia, Norvegia, Svezia)
POLONIA
ROMANIA/1
SERBIA
SPAGNA
STATI UNITI D’AMERICA
SVIZZERA
UNGHERIA
URUGUAY
Repubblica Bolivariana del VENEZUELA
PADIGLIONE VENEZIA
NATIONAL PARTICIPATIONS
ALBANIA
Artiglierie
ARABIA SAUDITA
Sale d'Armi
ARGENTINA
Sale d'Armi
Regno del BAHRAIN
Artiglierie
REPUBBLICA CECA
Artiglierie
CILE
Artiglierie
CINA
Repubblica Popolare
Cinese
Magazzino delle Vergini
CROAZIA
Artiglierie
EMIRATI ARABI UNITI
Sale d'Armi
FILIPPINE
Artiglierie
Granducato di LUSSEMBURGO
Sale d'Armi
IRLANDA
Artiglierie
Repubblica del KOSOVO
Artiglierie
LETTONIA
Artiglierie
MESSICO
Sale d'Armi
PERÙ
Sale d'Armi
SINGAPORE
Sale d'Armi
Repubblica di SLOVENIA
Artiglierie
Repubblica del SUDAFRICA
Sale d'Armi
TURCHIA
Sale d'Armi
UCRAINA
Sale d'Armi
Repubblica
dell’UZBEKISTAN
Tese Cinquecentesche
PADIGLIONE ITALIA
Tese e Giardino delle Vergini
NATIONAL PARTICIPATIONS
BULGARIA
Sala del Tiziano, Centro Culturale
Don Orione Artigianelli
Dorsoduro 909/A
Repubblica di CIPRO
Associazione Culturale Spiazzi
Castello 3865
ESTONIA
Salizada Streta, Castello 96
GEORGIA
Giardino Bianco Art Space
Via G. Garibaldi, Castello 1814
GRENADA
Associazione Vela al Terzo Venezia
Fondamenta C. Giazzo, Castello 209
KUWAIT
Magazzino del Sale 5 Dorsoduro 262
LITUANIA
Campo della Tana, Castello 2125 (in front of the Arsenale entrance)
Repubblica della MACEDONIA DEL NORD
Scuola dei Laneri, Salizada San Pantalon, Santa Croce 131/A
MONTENEGRO
Palazzo Malipiero, Ramo Malipiero San Marco 3078-3079/A
NIGER
Isola di San Servolo
Repubblica di PANAMA
Tana Art Space
Castello 2109/A e 2110-2111
PORTOGALLO
Palazzo Franchetti, San Marco 2842
ROMANIA/2
Giardini and New Gallery, Istituto Romeno di Cultura e Ricerca Umanistica, Palazzo Correr Campo Santa Fosca Cannaregio 2214
SANTA SEDE
Abbazia di San Giorgio Isola di San Giorgio Maggiore
Repubblica di SAN MARINO
Fucina del Futuro Calle San Lorenzo, Castello 5063B
COLLATERAL EVENTS
DOCKS CANTIERI CUCCHINI A Fragile Correspondence. Scotland + Venice San Pietro di Castello 40
DOCKS CANTIERI CUCCHINI Catalonia in Venice. Following the Fish San Pietro di Castello 40A
IUAV Climate
Wunderkammer
Palazzo Badoer, Calle de la Laca San Polo 2468
PALAZZO DELLE PRIGIONI
Diachronic Apparatuses of Taiwan. Architecture as On-going Details Within Landscape Castello 4209 (next to Palazzo Ducale)
PALAZZO MORA
EUmies Awards.
Young Talent 2023. The Laboratory of Education
Cannaregio 3659
IUAV Radical yet Possible Future Space Solutions
25 maggio May (Ca’ Tron)
26 maggio May (Aula Magna, Tolentini) Ca’ Tron, Santa Croce 1957 Tolentini, Santa Croce 19
PALAZZO ZENOBIO
DEGLI ARMENI Students as Researchers. Creative Practice and University Education
Centro Studi e Documentazione della Cultura Armena, Dorsoduro 1602
CAMPO DELLA TANA
Transformative Hong Kong
Castello 2126 (in front of the Arsenale entrance)
CA’ ASI
Tracé Bleu. Que faire en ce lieu, à moins que l’on y songe?
Campiello Santa Maria Nova Cannaregio 6024












A PLUS A GALLERY
MONILOLA OLAYEMI ILUPEJU
Gymnasia
Fino Until 15 luglio July San Marco 3073 aplusa.it
ACP | PALAZZO FRANCHETTI/1
Building a Creative Nation
ELEMENTAL, Herzog & de Meuron, OMA, Philippe Starck, UNStudio
Fino Until 26 novembre November
Campo Santo Stefano, San Marco 2842 www.acp-palazzofranchetti.com
ACP | PALAZZO FRANCHETTI/2
KENGO KUMA
Onomatopeia Architecture
Fino Until 26 novembre November
Campo Santo Stefano, San Marco 2842 www.acp-palazzofranchetti.com
AEROPORTO MARCO POLO
BAGLIONI HOTEL LUNA
Frank&Frank
flying city leather maps
Grand Tour
20 maggio May-26 novembre November
Aeroporto Zona Arrivi (ground floor); Baglioni Hotel Luna, San Marco 1243 www.frank-frank.com
AKKA PROJECT
ALLAN KIOKO
Mangbetu People
10 giugno June -25 agosto August
Ca’ del Duca, Corte del Duca Sforza San Marco 3052 www.akkaproject.com
BEATRICE BURATI ANDERSON
EMILIO FANTIN, MARZIO ZORIO
An Unexpected Space of Freedom
Fino Until 13 agosto August Art Space & Gallery
Calle de la Madonna, San Polo 1976 www.beatriceburatianderson.com
BEL-AIR FINE ART
Untitled
Calle del Spezier, San Marco 2765 Dorsoduro 728 www.belairfineart.com
BERENGO STUDIO
SAM BARON
Sacrum Unguentum
17 maggio May-1 ottobre October Ex Farmacia, San Marco 412 www.berengo.com
CA’ PESARO/1
La donazione
Gemma De Angelis Testa
Fino Until 17 settembre September
Galleria Internazionale d’Arte Moderna (second floor), Santa Croce 2076 capesaro.visitmuve.it
CA’ PESARO/2
AFRICA 1:1
Cinque artisti africani a Ca’ Pesaro
20 maggio May-1 ottobre October
Galleria Internazionale d’Arte Moderna (ground floor and Project Room) Santa Croce 2076 capesaro.visitmuve.it
CASTELLO 925
ROB MANGO
Eterno ritorno
15 settembre September-30 novembre November
Fondamenta San Giuseppe, Castello 925 www.crosscontemporaryprojects.com
CASTELLO 2093
Parasite 2.0
Lunar per Crash Baggage
20 maggio May-30 giugno June
Calle del Forno, Fondamenta della Tana Castello 2093 www.crashbaggage.com
CATERINA TOGNON MEL DOUGLAS
Luminance
Fino Until 29 luglio July
Ca’ Nova di Palazzo Treves in Corte Barozzi, San Marco 2158 www.caterinatognon.com
COLLEZIONE PEGGY GUGGENHEIM EDMONDO BACCI
L’energia della luce
Fino Until 18 settembre September
Palazzo Venier dei Leoni, Dorsoduro 701 www.guggenheim-venice.it
COMPLESSO DELL’OSPEDALETTO
Venezia Fabrica Futura
17 maggio May-17 luglio July
30 agosto August-30 settembre September
Barbaria de le Tole, Castello 6691 www.fabrica.it
EUROPEAN CULTURAL CENTRE (ECC)
PALAZZO BEMBO, PALAZZO MORA, GIARDINI DELLA MARINARESSA
Time Space Existence
20 maggio May-26 novembre November
Palazzo Bembo, Riva del Carbon San Marco 4793
Palazzo Mora, Strada Nuova Cannaregio 3659
Giardini della Marinaressa
Riva dei Sette Martiri, Castello www.ecc-italy.eu www. timespaceexistence.com
EX CONVENTO SS. COSMA
E DAMIANO
DNA Ucraino
18 maggio May-20 giugno June
Sala del Camino, Campo San Cosmo
Giudecca 620
FONDACO DEI TEDESCHI
RADIALS
18 maggio May-10 novembre November
Calle del Fontego dei Tedeschi, Rialto www.sbagliato.net
FONDATION VALMONT
EGO
Fino Until 25 febbraio February, 2024 Palazzo Bonvicini, Calle Agnello Santa Croce 2161/A www.fondationvalmont.com
FONDATION WILMOTTE
Prix W 2023
Un toît pour tous
18 maggio May-27 novembre November Fondaco degli Angeli, Fondamenta dell’Abbazia, Cannaregio 3560 www.fondationwilmotte.com www.prixw.com
FONDAZIONE
BEVILACQUA LA MASA
PASCAL SENDER
20 maggio May-16 luglio July
Palazzetto Tito, Dorsoduro 2826
FONDAZIONE GIORGIO CINI
LUCIANO BALDESSARI
Architetture per la scena
Fino Until 26 novembre November Biblioteca Nuova Manica Lunga Isola di San Giorgio Maggiore www.cini.it
FONDAZIONE DELL’ALBERO D’ORO/1
Nicolò Manucci, il Marco Polo dell’India
Un veneziano alla corte Moghul nel XVII secolo
Fino Until 26 novembre November
Palazzo Vendramin Grimani, San Polo 2033 www.fondazionealberodoro.org
FONDAZIONE DELL’ALBERO
D’ORO/2
NIKOS ALIAGAS Regards Vénitiens
Fino Until 26 novembre November
Palazzo Vendramin Grimani, San Polo 2033 www.fondazionealberodoro.org
FONDAZIONE MARCHESANI
I Am the Earth
21 maggio May-22 luglio July
Dorsoduro 2525 e 2525/A www.fondazionemarchesani.org
FONDAZIONE PRADA
Everybody Talks About the Weather
20 maggio May-26 novembre November
Ca’ Corner della Regina, Santa Croce 2215 www.fondazioneprada.org
FONDAZIONE QUERINI
STAMPALIA
DoorScape. Lo spazio oltre
la soglia
18 maggio May-26 novembre November
Area Carlo Scarpa, Campo Santa Maria Formosa, Castello 5252 www.doorscape.eu www.querinistampalia.org
IKONA GALLERY
Mercanti e stracciaioli nel Ghetto di Venezia
Fino Until 30 agosto August Campo del Ghetto Nuovo Cannaregio 2909 www.ikonavenezia.com
IN’EI GALLERY/1
JIN HEE PARK 박진희
Bearable Lightness of Being:
Hanji Tables
17 maggio May-24 giugno June
Riva del Vin, San Polo 1100 www.in-ei.it
IN’EI GALLERY/2
ART STUDIO h220430
The Floating Realm
30 giugno June -20 agosto August
Riva del Vin, San Polo 1100 www.in-ei.it
ISOLA DI SAN SERVOLO
VID
Venice Innovation Design
1-2 luglio July Isola di San Servolo www.servizimetropolitani.ve.it
LE STANZE DEL VETRO/1
Vetro boemo: i grandi maestri
Fino Until 26 novembre November
Isola di San Giorgio Maggiore www.lestanzedelvetro.org www.cini.it
LE STANZE DEL VETRO/2
Installazioni di Venini:
Luce 1921 – 1985
Fino Until 9 luglio July
Sala Carnelutti
Isola di San Giorgio Maggiore www.lestanzedelvetro.org www.cini.it
LE STANZE DELLA FOTOGRAFIA/1
UGO MULAS
L’operazione fotografica
Fino Ultil 6 agosto August
Isola di San Giorgio Maggiore www.lestanzedellafotografia.it
LE STANZE DELLA FOTOGRAFIA/2
ALESSANDRA CHEMOLLO
Venezia alter mundus
Fino Until 6 giugno June
Isola di San Giorgio Maggiore www.lestanzedellafotografia.it
LINEADACQUA GALLERY
ANDREA AVEZZÙ
Fino Until 29 settembre September
Calle della Mandola
San Marco 3716/A e 3720/A www.lineadacqua.gallery
M9 – MUSEO del ‘900
Rivoluzione Vedova
Fino Until 26 novembre November
Via Giovanni Pascoli 11, Mestre www.m9museum.it www.fondazionevedova.org
MUSEO CORRER/1
CARLA ACCARDI
Gli anni Settanta: i lenzuoli
Fino Until 29 ottobre October
Piazza San Marco 52 correr.visitmuve.it
MUSEO CORRER/2
L’arte della Giustizia. La Giustizia nell’arte
30 maggio May-3 settembre September
Piazza San Marco 52 correr.visitmuve.it
MUSEO DEL VETRO
Cento anni di NasonMoretti
Storia di una famiglia del vetro muranese
19 maggio May
6 gennaio January, 2024
Fondamenta Marco Giustinian 8 Murano www.museovetro.visitmuve.it
NEGOZIO OLIVETTI
Massimo Micheluzzi al Negozio Olivetti
20 maggio May
24 settembre September
FAI – Fondo per l’Ambiente Italiano Piazza San Marco 101 www.fondoambiente.it
OCEAN SPACE
SIMONE FATTAL
PETRIT HALILAJ & ÁLVARO URBANO
Thus Waves Come in Pairs
Fino Until 5 novembre November
Ex Chiesa di San Lorenzo Castello 5069 www.ocean-space.org
PALAZZO CINI
L’Ospite a Palazzo: Cleopatra di Artemisia
Gentileschi
Fino Until 16 luglio July
Campo San Vio, Dorsoduro 864 www.palazzocini.it
PALAZZO CONTARINI POLIGNAC
100 progetti x 100 identità
20 maggio May
26 novembre November
Magazzino Gallery, Dorsoduro 874 www.venicedesignweek.com
PALAZZO DIEDO
BERGGRUEN ARTS & CULTURE
STERLING RUBY
A Project in Four Acts
Primavera Spring-Estate Summer Cannaregio 2386 www.berggruenarts.org
PALAZZO DUCALE
Vittore Carpaccio Dipinti e disegni
Fino Until 18 giugno June Piazzetta San Marco 1 palazzoducale.visitmuve.it
PALAZZO FORTUNY
GIOVANNI SOCCOL
Riflessioni notturne
Fino Until 1 ottobre October San Marco 3958 fortuny.visitmuve.it
PALAZZO GRASSI CHRONORAMA
Tesori fotografici del 20° secolo
Fino Until 7 gennaio Junuary, 2024 Campo San Samuele San Marco 3231 www.pinaultcollection.com
PALAZZO GRIMANI
INGE MORATH
Fotografare da Venezia in poi
Fino Until 4 giugno June Ramo Grimani, Castello 4858 ingemorathexhibition.com
PALAZZO MOCENIGO/1
MATTHIAS SCHALLER
Tessuto urbano
Fino Until 26 novembre November Centro Studi di Storia del Tessuto, del Costume e del Profumo (White Room), Santa Croce 1992 mocenigo.visitmuve.it
PALAZZO MOCENIGO/2
Tramalogie
Donazione Anna Moro-Lin
Fino Until 20 agosto August Centro Studi di Storia del Tessuto, del Costume e del Profumo Santa Croce 1992 mocenigo.visitmuve.it
PALAZZO PISANI REVEDIN
VENTRONE
Fino Until 16 luglio July San Marco 4013/A
PROCURATIE VECCHIE/1
THE HUMAN SAFETY NET
A World of Potential
Piazza San Marco 105 www.thehumansafetynet.org
PROCURATIE VECCHIE/2
THE ART STUDIO
The Hungriest Eye. The Blossoming of Potential by Arthur Duff
Fino Until 10 marzo March, 2024 Piazza San Marco 105 www.thehumansafetynet.org
PUNTA DELLA DOGANA
Icônes
Fino Until 26 novembre November Dorsoduro 2 www.pinaultcollection.com
SALONE VERDE
UMBAU. Nonstop
Transformation by gmp · von Gerkan, Marg and Partners Architects
19 maggio May 26 novembre November
Calle della Regina, Santa Croce 2258 umbau.gmp.de
SCALA DEL BOVOLO
LUIGI MANCIOCCO
Dal lato dell’immaginario
Fino Until 10 settembre September Palazzo Contarini del Bovolo San Marco 4303 www.luigimanciocco.it www.gioiellinascostidivenezia.it
SPAZIO BERLENDIS
ALDO GRAZZI
Evanescenze
20 maggio May-29 ottobre October Calle Berlendis, Cannaregio 6301 www.spazioberlendis.it
SQUERO CASTELLO
Journey over a million footpaths
18 maggio May-18 giugno June Salizada Streta, Castello 368 www.africanartindigital.com www.zueccaprojects.org
THE 2212
The Object Beyond the Object Calle de la Regina, Santa Croce 2212 www.the2212venezia.com
THE VENICE VENICE HOTEL/1
L’Utopia dell’Architettura
Libri, riviste, manifesti, fotografie, disegni e progetti 23 maggio May-19 giugno June Cannaregio 5631 www.venicevenice.com
THE VENICE VENICE HOTEL/2 Venice M’Art Cannaregio 5631 www.venicevenice.com
UNIVERSITÀ CA’ FOSCARI/1
The Cooling Solution
19 maggio May-31 luglio July
CFZ Cultural Flow Zone
Dorsoduro 1392 Università Ca’ Foscari (Cortile Grande), Dorsoduro 3246 www.unive.it
UNIVERSITÀ CA’ FOSCARI/2 Cercando il cuore
18 maggio May-30 giugno June Università Ca’ Foscari, San Sebastiano, Dorsoduro 1686 www.unive.it
VATICAN CHAPELS
Sacred Landscapes
18 maggio May
26 novembre November
Fondazione Giorgio Cini Bosco dell’Isola di San Giorgio Maggiore www.cini.it
VENICE DESIGN BIENNIAL
Auto-Exotic
19 maggio May-18 giugno June
SPUMA Space for the Arts, Fondamenta San Biagio Giudecca 800R
SPARC* – Spazio Arte Contemporanea, San Marco 2828A San Sebastiano bowls club Dorsoduro 2364
Hotel Des Bains’ Tucul (beach cabin) Lungomare Guglielmo Marconi 17 Lido di Venezia www.venicedesignbiennial.org
VENICE PHOTOGRAPHY
MICHELE ALASSIO
Casa de Retiro Espiritual Da From 18 maggio May Castello 4745 www.venicedesignweek.com
Mensile di cultura, spettacolo e tempo libero Numero 275-276 - Anno XXVII
Venezia, 1 Maggio 2023
Con il Patrocinio del Comune di Venezia
Autorizzazione del Tribunale di Venezia n. 1245 del 4/12/1996
Direzione editoriale
Massimo Bran
Direzione organizzativa
Paola Marchetti
Relazioni esterne e coordinamento editoriale
Mariachiara Marzari
Redazione
Chiara Sciascia, Davide Carbone
Speciali
Fabio Marzari
Coordinamento Newsletter e progetti digitali
Marisa Santin
Grafica
Luca Zanatta
Hanno collaborato a questo numero
Katia Amoroso, Loris Casadei, Michele Cerruti But, Elisabetta Gardin, Renato Jona, Michela Luce, Franca Lugato, Massimo Macaluso, Paolo Dalla Mora, Matteo Polo, Livia Sartori di Borgoricco, Fabio Di Spirito, Camillo Tonini
Si ringraziano
Giulia Foscari, Olga Shishko, Silvia Burini, Barbara Casavecchia, Marisa Huff, Cristiana Costanzo, Claudia Gioia, Francesca Buccaro, Emanuela Caldirola, Flavia Fossa Margutti, Alexia Boro
Traduzioni
Andrea Falco, Patrizia Bran
Foto di copertina
Naturae. La valle dell’annientamento © Stefano Vaja - Courtesy La Biennale di Venezia
lo trovi qui:
Bookshop Gallerie dell’Accademia; Qshop (c/o Querini Stampalia, Santa Maria Formosa); Alef (c/o Museo Ebraico, zona Ghetto); Mare di Carta (Fondamenta dei Tolentini); Studium (zona S. Marco); Toletta, Toletta Cube e Toletta Studio (zona Campo San Barnaba) e in tutte le edicole della città.
Direttore responsabile
Massimo Bran
Guida spirituale
“Il più grande”, Muhammad Alì
Recapito redazionale
Cannaregio 563/E - 30121Venezia tel. +39 041.2377739 redazione@venezianews.it www.venezianews.it

venezianews.magazine
venezia_news venews_magazine
Stampa
Chinchio Industria Grafica Srl
Via Pacinotti, 10/12 - 35030 Rubano (PD) - www.chinchio.it
Redazione Venezianews
La redazione non è responsabile di eventuali variazioni delle programmazioni annunciate

